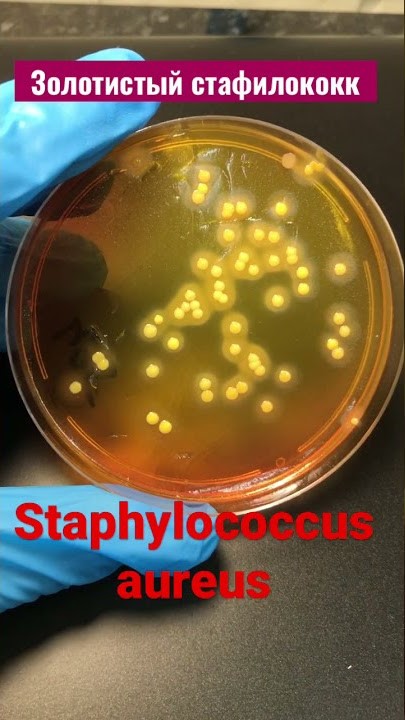

Понедельник-пятница
08.00 — 17.00
Помощник врача-гигиениста — Семенова Антонина Викторовна
7-69-12
Content missing
Специалистами Ошмянского районного центра гигиены и эпидемиология в ходе проведения мероприятий технического характера в торговом объекте была выявлена продукция не соответствующая требованиям санитарно-эпидемиологического законодательства. При проведении лабораторных исследований было уставлено наличие стафилококка в пирожных «Эклер»; превышение количества мезофильных аэробных и факультативно анаэробных микроорганизмов (далее-КМАФАНМ) и наличием бактерий группы кишечной палочки (далее-БГКП) в шашлыке из мяса цыпленка.
Пищевая продукция может содержать разнообразную микрофлору, однако отдельные виды микроорганизмов могут оказывать влияние на безопасность пищевых продуктов.
Присутствие золоти́стого стафилоко́кка (Staphylococcus aureus) в термически обработанных продуктах питания является свидетельством их вторичного загрязнения за счет рук и носоглотки работников пищевого предприятия. При нарушении сроков и условий хранения продуктов происходит размножение в них патогенных стафилококков и накопление токсинов. Самая распространенная разновидность стафилококковой инфекции – пищевой токсикоз, который возникает при употреблении продуктов, содержащих большое количество стафилококковых энтеротоксинов – продуктов жизнедеятельности микроорганизмов. Стафилококковое отравление проявляется тошнотой, многократной рвотой, реже диареей. Заболевание регистрируется в виде вспышек, которые охватывают группы лиц (семья, объект общественного питания), объединенные употреблением общих продуктов питания.
Причиной высокого уровня КМАФАнМ и наличия БКГП являются плохие гигиенические условия производства, некачественное сырье, а также отсутствие надлежащих условий хранения продукта после его изготовления. Высокое содержание КМАФАнМ свидетельствует о размножении микроорганизмов, включая патогенные, которые могут вызывать пищевые отравления с диареей, гастроэнтеритом и другими симптомами. Хотя некоторые представители БГКП в норме присутствуют в кишечнике человека, попадание их в продукты в чрезмерных количествах (выше установленных норм) опасно для здоровья, они могут вызывать желудочно-кишечные заболевания, а наихудшее осложнение — опасный для жизни гемолитико-уремический синдром (ГУС) с поражением почек.
В целях профилактики пищевого отравления необходимо соблюдать простые правила:

- при покупке продуктов обращать внимание на сроки годности товара и целостность упаковки;
- оценивайте внешний вид и запах продукта: не употреблять продукты с подозрительным видом или запахом;
- не покупать продукты в местах несанкционированной торговли;
- хранить продукты в соответствии с температурным режимом указанным на маркировке товара;
- мыть руки перед едой, использовать разные разделочные доски для сырых и готовых продуктов, держать сырые и готовые продукты отдельно;
- надевать перчатки при приготовлении пищи, если у вас есть раны на руках или запястьях;
- не готовьте пищу, если у вас диарея или рвота,
- соблюдать правила респираторного этикета: чихать и кашлять в салфетку или локтевой сгиб;
- обеспечивайте правильную термическую обработку продуктов, так как при температуре 65-75 0С многие патогенные бактерии погибают.

Государственное учреждение «Ошмянский районный ЦГЭ» информирует, об отмене с 30 сентября 2025 года временной санитарной меры по запрету ввоза и обращения на территории Республики Беларусь продукции производства ООО «СТЕПЬ-Инвестиция»» (Россия, Ростовская область, Аксайский район, х.Александровка, ул.Вишневая, 24) (далее – Общество).
Постановлением заместителя Министра здравоохранения – Главного государственного санитарного врача Республики Беларусь от 30.09.2025 № 54 вводится временная санитарная мера по проведению импортерами (поставщиками) в течение года с даты его принятия лабораторных исследований содержания кадмия каждой партии халвы подсолнечной и козинак подсолнечных в ассортименте, произведенной Обществом и предназначенной для выпуска в обращение на территории Республики Беларусь.
Санитарно-эпидемиологический отдел
Государственное учреждение «Ошмянский районный центр гигиены и эпидемиологии» информирует, что постановлениями заместителя Министра – Главного государственного санитарного врача Республики Беларусь от 09.09.2025 №35, 36, 37, 38, 39, 40, 41, 42, 43, 44, 45, 46, 47, 48, 49 с 09.09.2025 введена временная санитарная мера:
- по запрету ввоза на территорию Республики Беларусь, реализацию,
хранение, транспортировку, использование всего ассортимента пищевой продукции:
ООО «AZAMAT ESTERN TRADE» (Узбекистан, Самаркандская область, Джамбайский район, Самарканд МФИ, улица-шоссе Ташкент- Самарканд, 82) ООО «GREEN DESERT» (Узбекистан, Самаркандская область, Пайарикский район, г. Пайарик, ул. Самарканд, 52);
индивидуального предпринимателя Горбоконь Р.Ю. (Россия, Краснодарский край, г. Краснодар, ул. Карлсруэвская, 3/1-5);
крестьянского хозяйства «Береке» (Республика Казахстан. Туркестанская область, Мактааральский район, сельский округ Аязхана Калыбекова, село Ульгили, ул. Орда, 67);
АО «Нижегородский масло-жировой комбинат» (Россия, Нижегородская область, г. Нижний Новгород, шоссе Жиркомбината, 11);
ООО «Фуддрай» (Россия, г. Москва, ул. Калужское шоссе, 22-й км, здание 10);
индивидуального предпринимателя Гасымова Хазар Агли оглы (Россия, Ростовская область, Аксайский район, п. Российский, ул. Тенистая, 8/3);
ООО «СТЕПЬ-Инвестиции» (Россия, Ростовская область, г. Ростов- на-Дону, пер. Соборный, 19, офис 307а);
ООО «КДВ Воронеж» (Россия, Воронежская область, Рамонский район, д. Богданово, ул. Лесная, 31);
ООО «Кухмастер» (Россия, Самарская область, Волжский район, поселок городского типа Стройкерамика, строение 8);
ООО ПК «Слада» (Россия, Тюменская область, г. Ишим, ул. Ленина, 81, строение 5);
ООО «Цех Заморозки» (Россия, г. Москва, муниципальный округ Аэропорт, ул. Усиевича, 25, корпус 1, кв. 101; адрес производства: Россия, Московская область, г. Одинцово, Транспортный проезд, 1, лит. Б2);
Zhengzhou Yuanhao Food Со.,. Ltd (Китай, № 2, Промышленный парк Чжэнчжуан, г. Цуймяо, г. Синьян, г. Чжэнчжоу);
«HAPPY FOODS INTERNATIONAL LIMITED» (Китай, RM. 708 BUILDING A.FUTALSQUARE, 18, HONGKONG MIDDLE ROAD, QINGDAO);
LINYI LP INTERNATIONAL CO., LTD (Китай, NO 205-01018, NORTHEAST OF THE INTERSECTION OF YIHE 2ND ROAD ANDMENGSHAN 2ND ROAD, COMPREHENSIVE BONDED ZONE, LINYI CITY, SHANDONG PROVINCE, P.R.CHINA);
ООО «Слакон» (Россия, г. Москва, ул. Авиамоторная, 50, строение 2, офис 8);
- о прекращении действия на территории Республики Беларусь свидетельствао государственной регистрации RU.74.50.11.005.R.000012.05.23 от 25.05.2023 на мучные кондитерские изделия для детского питания: печенье затяжное «Буби-Юби», «Нафаня», изготовленные по ТУ 10.86.10-022-00357558-2023 «Печенье затяжное и сахарное. Для питания детей дошкольного и школьного возраста» (изготовитель: ООО «Слакон» (Россия, г. Москва, ул. Авиамоторная, 50, строение 2, офис 8; адрес производства: Россия, Курганская область, г. Шадринск, ул. Ломоносова, 2, строение 1).
Санитарно-эпидемиологический отдел
В целях обеспечения санитарно-эпидемиологического благополучия населения и недопущения к реализации продукции, представляющей потенциальную опасность для здоровья людей, информируем, что лабораторным отделом Гродненского областного ЦГЭОЗ по результатам испытаний выявлена продукция, несоответствующая санитарно-эпидемиологическим и гигиеническим требованиям:
курага (абрикос сушеный 1 сорт), изготовитель: ООО «AZAMAT ESTERN TRADE», 140400, Самаркандская область, Джамбайский район, Самарканд МФЙ, улица-шоссе Ташкент-Самарканд, дом 82, Республика Узбекистан. Упаковщик/ импортер (поставщик): частное предприятие «Шалу», Республика Беларусь, 223021, Минская область, Минский район Щомыслицкий с/с, аг.Озерцо, ул.Центральная, д.35А, пом.25. Адрес упаковывания продукции: Минская область, Пуховичский район, Руденский поселковый совет,1. Расфасовано по ТУ ВY 690269922.002, в потребительскую упаковку из полимерного материала массой нетто 1,0 кг. Дата изготовления 04.2025, дата упаковывания 03.06.2025, годен до 01.04.2026, условия хранения: хранить при температуре не выше 250С и относительной влажности не более 75%, штриховой код 4812948010360.

Продукция не соответствует требованиям ТР ТС 021/2011 «О безопасности пищевой продукции», принятого решением Комиссии Таможенного союза от 09.12.2011 №880; Гигиенического норматива «Показатели безопасности и безвредности продовольственного сырья и пищевых продуктов», утвержденному постановлением Совета Министров Республики Беларусь от 25.01.2021 №37 по микробиологическим показателям
Информацию подготовила помощник врача-гигиениста санитарно-эпидемиологического отдела Ошмянского районного ЦГЭ Семёнова Антонина Викторовна

На основании представленных ООО «Производственная компания «Акульчев» (Россия, Республика Татарстан, г.Елабуга, ул.Марджани, 16-5), доказательств, удостоверяющих перечень и эффективность проведенных корректирующих мероприятий, стабильность процессов производства, хранения, транспортировки продукции, а также действенности контроля безопасности и качества, включая результаты лабораторных исследований продукции, заместителем Министра - Главным государственным санитарным врачом Республики Беларусь с 12 августа 2025 г. отменена временная санитарная мера по запрету ввоза и обращения на территории Республики Беларусь пищевой продукции производства ООО «Производственная компания «Акульчев» (Россия, Республика Татарстан, г.Елабуга, ул.Марджани, 16-5) (постановление от 12.08.2025 № 33).

Начался сезон сбора грибов, а значит, и повышенного риска отравления грибами. Смертельный исход при отравлениях несъедобными грибами достигает 25-50% случаев, а от отравления ядом бледной поганки более 50% .
Рекомендации грибникам:
- Собирайте только те грибы, о которых вы точно знаете, что они съедобны.
- Если вы собираете для засола волнушки, чернушки, белянки, грузди, подгрузди и другие грибы, содержащие млечный сок, то обязательно перед засолом отварите или вымочите их, чтобы удалить горькие, раздражающие желудок вещества.
- Расстройство пищеварения могут вызвать и соленые грибы, поданные на стол раньше срока. Поэтому следует помнить, что сухим посолом соленые грибы можно употреблять в пищу: рыжики - через 5-6 дней хранения, грузди - через 30-35 дней, волнушки - через 40 дней, а валуи - через 50-60 дней хранения. Грибы горячей засолки употребляются через 7-8 дней. В эти сроки грибы "созревают", и горькие вещества в них разрушаются.
- Не пробуйте на вкус сырые грибы.
- Не собирайте грибы в городских парках, скверах, дворах, а также вдоль автомобильных и железных дорог, вблизи промышленных предприятий, они могут накапливать ядовитые вещества.
- Максимальный срок хранения свежих грибов после предварительного отваривания 18-24ч при температуре не выше 10 *C.
- Перед кулинарной обработкой переберите грибы, тщательно очистите их от песка, листьев.
- Перед маринованием замочите грибы на 15 минут в тёплой солёной воде, затем промойте 7-10 раз в холодной проточной воде. При приготовлении доведите до кипения, первый отвар слейте, ещё раз перемойте, а затем варите до готовности. Варка считается законченной, когда грибы осядут на дно посуды, а отвар станет светлым и прозрачным, без пены.
- Не приобретайте грибы в неустановленных местах, так как о качестве и безопасности таких продуктов ничего неизвестно.
- Во избежание заболевания ботулизмом,ни в коем случае не употребляйте консервированные грибы из банок со вздутыми крышками.
- При появлении первых симптомов отравления грибами следует немедленно обратиться за медицинской помощью.
Врач-гигиенист Ошмянского районного ЦГЭ Ирена Ерух
В целях обеспечения санитарно-эпидемиологического благополучия населения и недопущения к реализации продукции, представляющей потенциальную опасность для здоровья людей, информируем, что лабораторным отделом Ошмянского районного ЦГЭ по результатам испытаний выявлена продукция, несоответствующая санитарно-эпидемиологическим и гигиеническим требованиям:
Восточные сладости мучные «Наполеон». Изготовитель: ИП Улибегян Геворг Аршагович, юридический адрес: 352941, Россия, Краснодарский край, г Армавир, ул Заречная, д. 167; адрес производства: 352900, Россия, Краснодарский край, г Армавир, ул Тоннельная, дом 48. Дата изготовления и упаковывания 03.07.2025, срок годности 30 суток. Хранить при температуре не выше (18±3)0С и относительной влажности воздуха не более 75%.

Продукция не соответствует требованиям ТР ТС 021/2011 «О безопасности пищевой продукции», принятого решением Комиссии Таможенного союза от 09.12.2011 №880; Гигиенического норматива «Показатели безопасности и безвредности продовольственного сырья и пищевых продуктов», утвержденному постановлением Совета Министров Республики Беларусь от 25.01.2021 №37 по микробиологическим показателям
Информацию подготовила помощник врача-гигиениста санитарно-эпидемиологического отдела Ошмянского районного ЦГЭ Семёнова Антонина Викторовна

На основании представленных ООО” Азовская кондитерская фабрика”(Россия, Московская обл., г. Мытищи, 4536-й проезд, владение 8, офис 53) доказательств, удостоверяющих перечень и эффективность проведенных корректирующих мероприятий, стабильность процессов производства, хранения, транспортировки продукции, а также действительности контроля безопасности и качества, включая результаты лабораторных исследований продукции, заместителем Министра- Главным государственным санитарным врачом Республики Беларусь с 8 июля 2025 г. отмена временная санитарная мера по запрету ввоза и обращения на территории Республики Беларусь пищевой продукции производства ООО ” Азовская кондитерская фабрика””(Россия, Московская обл., г. Мытищи, 4536-й проезд, владение 8, офис 53)
В целях обеспечения санитарно-эпидемиологического благополучия населения и недопущения к реализации продукции, представляющей потенциальную опасность для здоровья людей, информируем, что лабораторным отделом Сморгонского зонального ЦГЭ по результатам испытаний выявлена продукция, несоответствующая санитарно-эпидемиологическим и гигиеническим требованиям:

Продукция: Картофель продовольственный свежий, страна происхождения: Казахстан, урожай 2025 г. Изготовитель/экспортер: ИП “Multi trade” Казахстан, г. Павлодар, Космонавтов, 1. Адрес места осуществления деятельности по изготовлению продукции: Казахстан, Павлодарский р-он, с. Черноярка, уч. 11. Импортер/поставщик: ООО «СэйлсГрин», РБ, г. Минск, ул. Мележа, д. 5, пом. 208. Дата сбора: 10.06.2025. Дата упаковывания: 10.06.2025. Срок годности и условия хранения 60 суток с даты упаковывания при температуре +40С до +60С и относительной влажности воздуха 85-90 %. Допускается реализация при температуре до +250С до потери продукцией органолептических свойств.
Продукция не соответствует требованиям ТР ТС 021/2011 «О безопасности пищевой продукции», принятого решением Комиссии Таможенного союза от 09.12.2011 №880; Гигиенического норматива «Показатели безопасности и безвредности продовольственного сырья и пищевых продуктов», утвержденному постановлением Совета Министров Республики Беларусь от 25.01.2021 №37 по содержанию нитратов: 363 мг/кг при норме 250 мг/кг.
Информацию подготовила врач-гигиенист (заведующий отделом) санитарно-эпидемиологического отдела Ошмянского районного ЦГЭ Матович Мария Валерьевна
В целях обеспечения санитарно-эпидемиологического благополучия населения и недопущения к реализации продукции, представляющей потенциальную опасность для здоровья людей, информируем, что лабораторным отделом Сморгонского зонального ЦГЭ по результатам испытаний выявлена продукция, несоответствующая санитарно-эпидемиологическим и гигиеническим требованиям:

Дыня свежая Канталупа, урожай 2025 года. Изготовитель: Manzhouli Shuangteng Economic and Trade Co., Ltd, место нахождения (адрес юридического лица): Manzhouli Economic Cooperation District Furong Village, Building 18 3-201, China Китай. Поставщик в Республику Беларусь: ООО «Евроторг», 220099, г. Минск, ул. Казинца, 52а, ком. 22. Дата сбора: май 2025. Дата упаковывания: 25.05.2025. Срок годности с даты упаковывания 60 суток. Условия хранения: хранить продукцию при температуре воздуха от +100С до +120С и относительной влажности 70%-90%. Допускается реализация в торговых объектах при температуре до +250С до потери продукцией органолептических свойств
Не соответствует требованиям ТР ТС 021/2011 «О безопасности пищевой продукции», принятого решением Комиссии Таможенного союза от 09.12.2011 №880; Гигиенического норматива «Показатели безопасности и безвредности продовольственного сырья и пищевых продуктов», утвержденному постановлением Совета Министров Республики Беларусь от 25.01.2021 №37 по содержанию нитратов: 529 мг/кг при норме не более 90 мг/кг.
Информацию подготовила врач-гигиенист (заведующий отделом) санитарно-эпидемиологического отдела Ошмянского районного ЦГЭ Матович Мария Валерьевна
В целях обеспечения санитарно-эпидемиологического благополучия населения и недопущения к реализации продукции, представляющей потенциальную опасность для здоровья людей, информируем, что лабораторным отделом Сморгонского зонального ЦГЭ по результатам испытаний выявлена продукция, несоответствующая санитарно-эпидемиологическим и гигиеническим требованиям:

Дыня Hami свежая. Страна происхождения: Китай. Изготовитель: XIAMEN GUANWEI IMPORT&EXPORT CO., LTD, место нахождения (адрес юридического лица): UNIT 01B, 6TH FLOOR, BUILDING B, FREE TRADE FINANCIAL CENTER PROJECT, №1 YUNAN FOURTH ROAD, XIAMEN AREA (BONDED ZONE), CHINA (FUJIAN) PILOT FREE TRADE ZONE, CHINA, Китай. Поставщик в Республику Беларусь: ООО «Евроторг», 220099, г. Минск, ул. Казинца, 52а, ком. 22. Дата сбора: май 2025. Дата упаковывания: 26.05.2025. Срок годности с даты упаковывания 90 суток. Условия хранения: хранить продукцию при температуре воздуха от +100С до +120С и относительной влажности 70%-90%. Допускается реализация в торговых объектах при температуре до +250С до потери продукцией органолептических свойств.
Не соответствует требованиям ТР ТС 021/2011 «О безопасности пищевой продукции», принятого решением Комиссии Таможенного союза от 09.12.2011 №880; Гигиенического норматива «Показатели безопасности и безвредности продовольственного сырья и пищевых продуктов», утвержденному постановлением Совета Министров Республики Беларусь от 25.01.2021 №37 по содержанию нитратов: 209 мг/кг при норме не более 90 мг/кг.
Информацию подготовила врач-гигиенист (заведующий отделом) санитарно-эпидемиологического отдела Ошмянского районного ЦГЭ Матович Мария Валерьевна
В целях обеспечения санитарно-эпидемиологического благополучия населения и недопущения к реализации продукции, представляющей потенциальную опасность для здоровья людей, информируем, что лабораторным отделом Гродненского областного ЦГЭОЗ по результатам испытаний выявлена продукция, несоответствующая санитарно-эпидемиологическим и гигиеническим требованиям:

Набор форм для выпечки «Kitchen», 10 штук, артикул YJ013220148; изготовитель: Union Source Co., Ltd, эт.20, №1, Билдинг Нинбо Рисеч Девелопмент Парк, 399 Цзюсянь Роуд Нэшнл Хай-Тэк Зоун, Нинбо, Китай; поставщик в РБ: ООО «Фикс Прайс Запад», г.Минск, ул.Короля, д.51, пом.13, офис 13-14.Штрих код 4610391804871.Состав: алюминий. Дата изготовления: 01.2025.
Продукция не соответствует по физико-химическим показателям- миграция марганца.
Информацию подготовила врач-гигиенист Ошмянского районного ЦГЭ Ерух Ирена Валерьевна
В целях обеспечения санитарно-эпидемиологического благополучия населения и недопущения к реализации продукции, представляющей потенциальную опасность для здоровья людей, информируем, что лабораторным отделом Гродненского областного ЦГЭОЗ по результатам испытаний выявлена продукция, несоответствующая санитарно-эпидемиологическим и гигиеническим требованиям:

Свекла столовая свежая. Страна происхождения: Республика Беларусь, изготовитель: крестьянское хозяйство Шруба Михаила Григорьевича, адрес: 247980, Республика Беларусь, Гомельская обл., г. Туров, ул. Набереждная, 2. Поставщик: крестьянское хозяйство Шруба Михаила Григорьевича, адрес производства: 247985, Республика Беларусь, Гомельская обл., Житковичский р-н, д. Хильчицы. ТУ ВУ 400050549.007-2016. Ботанический сорт: Пабло. Дата сбора урожай 2024 г. Дата упаковывания: 10.03.2025 г. Срок годности: при температуре от +4С до +15С 30 суток с даты упаковывания. Условия хранения: относительная влажность воздуха 85-90%.
Продукция не соответствует по содержанию нитратов.
Информацию подготовила врач-гигиенист (заведующий отделом) санитарно-эпидемиологического отдела Ошмянского районного ЦГЭ Матович Мария Валерьевна
31.03.2025

Государственное учреждение «Ошмянский районный ЦГЭ» информирует, информирует, что в связи с принятыми ООО «Производственная компания ЮЖ» (производство и хранение замороженной продукции), (Россия, Московская область, Ногинский район, г. Электроугли, ул. Железнодорожная, 22, этаж 2, комн. 210) дополнительными мерами по обеспечению качества и безопасности выпускаемой продукции заместителем Министра - Главным государственным санитарным врачом Республики Беларусь с 20 февраля 2025 г. отменена временная санитарная мера по запрету ввоза и обращения на территории Республики Беларусь пищевой продукции производства ООО «Производственная компания ЮЖ» (постановление от 16.10.2024 № 37).
Санитарно-эпидемиологический отдел
26.02.2025

Государственное учреждение «Ошмянский районный ЦГЭ» информирует, информирует, что в связи с принятыми Oerlemans Foods Siemiatycze Sp.Z.o.o (ул. Армии Краевой, 31, 17-300 Семятыче, Польша) дополнительными мерами по обеспечению качества и безопасности выпускаемой продукции заместителем Министра – Главным государственным санитарным врачом Республики Беларусь с 30 января 2025 г. отменена временная санитарная мера по запрету ввоза и обращения на территории Республики Беларусь пищевой продукции производства Oerlemans Foods Siemiatycze Sp.Z.o.o (постановление от 16.12.2024 № 51).
Санитарно-эпидемиологический отдел
07.02.2025

Государственное учреждение «Ошмянский районный ЦГЭ» информирует, информирует, что в связи с принятыми ООО «Русские деликатесы» (Россия, Ярославская область, Рыбинский район, поселок Майский, 101) дополнительными мерами по обеспечению качества и безопасности выпускаемой продукции заместителем Министра - Главным государственным санитарным врачом Республики Беларусь с 27 января 2025 г. отменена временная санитарная мера по запрету ввоза и обращения на территории Республики Беларусь пищевой продукции производства ООО «Русские деликатесы» (постановление от 27.01.2025 № 3).
Санитарно-эпидемиологический отдел
31.01.2025
Государственное учреждение «Ошмянский районный ЦГЭ» информирует, информирует, что заместителем Главного государственного инспектора Республики Беларусь по надзору за соблюдением технических регламентов с 20 января 2025 года разрешен ввоз и обращение на территории Республики Беларусь кукурузы лопающей «Попкорн сладкий «Микс», изготовленной ООО «Горячие крендели «Север» Российской Федерации, запрещенной предписанием от 08.09.2023 № 06-11-123/927 (разрешение от 17.01.2025 № 06-11-4/66).
Санитарно-эпидемиологический отдел
30.01.2025

Государственное учреждение «Ошмянский районный ЦГЭ» информирует, что на основании предписания Главного государственного инспектора Республики Беларусь по надзору за соблюдением технических регламентов:
с 20 января 2025 прекращен ввоз и обращение опасной продукции, прекращено действие на территории Республики Беларусь документов об оценке соответствия, об изъятии (отзыве из обращения) продукции от 13.01.2025 № 06-11-123/55:
предписания Главного государственного инспектора Республики Беларусь по надзору за соблюдением технических регламентов:
с 20 января 2025 прекратить ввоз и обращение опасной продукции, прекращении действия на территории Республики Беларусь документов об оценке соответствия, об изъятии (отзыве из обращения) продукции от 13.01.2025 № 06-11-123/55:
желе с соком манго, пастеризованное с маркировкой «Аппетиссимо», масса нетто: 150 г, дата изготовления: 07.10.2024, срок годности: 90 суток, продукция маркирована единым знаком ЕАС, изготовитель: ООО «Преображенский молочный комбинат», Российская Федерация, г. Москва, поставщик в Республику Беларусь: ООО «ТУССОН- ПЛЮС», г. Минск, по безопасности: при производстве продукции использовался незаявленный изготовителем в маркировке, недопустимый синтетический краситель тартразин (Е102) в количестве 10,5мг/кг.
Санитарно-эпидемиологический отдел
28.01.2025
В связи с принятыми ООО «Морозко» (Россия, Ленинградская область, Всеволожский район, пос. Ковалева, ул. Поперечная, 15) дополнительными мерами по обеспечению качества и безопасности выпускаемой продукции заместителем Министра - Главным государственным санитарным врачом Республики Беларусь с 27 декабря 2024 г. отменена временная санитарная мера по запрету ввоза и обращения на территории Республики Беларусь пищевой продукции производства ООО «Морозко» (постановление от 27.12.2024 № 54).
16.01.2025
Несанкционированная торговля - это продажа товара неизвестного качества и происхождения в места, не предназначенных для этого (с рук на тротуаре, вдоль автодорог, во дворах спальных районов, на входах в те же специализирующиеся по продаже аналогичных товаров рынки). Зачастую, жители мотивируют покупки в местах стихийной торговли целью «сэкономить», но при этом забывают, что таким образом подвергают себя и свою семью опасности, так как продукты, которые не прошли проверку, могут быть небезопасными.
Наиболее эпидемически «опасными» продуктами, реализуемыми в ходе «несанкционированной» торговли, являются: домашние колбасы, сало, мясо и мясные продукты (в том числе домашнего изготовления), яйца, молочные продукты, сушёная и вяленая рыба, ягоды, фрукты, овощи, грибы.
Такие продукты опасны в отношении распространения острых кишечных инфекций. Продукты питания, купленные в местах несанкционированной торговли, могут стать причиной заражения опасными инфекционными заболеваниями – бруцеллезом, туберкулезом, сальмонеллезом и другими.
Подобная торговля опасна для здоровья и даже жизни покупателей, так как ведется без соблюдения даже элементарных санитарных норм:
-отсутствуют условия для соблюдения правил личной гигиены продавцом: нет условий для мытья рук, отсутствует санитарная одежда);
-отсутствуют документы, подтверждающие происхождение, качество и безопасность реализуемой продукции, а, следовательно, продукция не исследована в лаборатории на содержание остаточных количеств нитратов, пестицидов, солей тяжелых металлов, радионуклидов, патогенных микроорганизмов, антибиотиков;
-отсутствует необходимая информация о реализуемой продукции: наименование производителя, дата производства, условиях транспортировки и хранения, сроке годности, в связи с чем возможна реализация товаров с истекшим сроком годности и сомнительного качества;
-отсутствуют личные медицинские справки у продавцов, т.е. продавцы не проходят необходимых медицинских обследований и могут являться носителями возбудителей кишечных инфекций;
-отсутствует холодильное оборудование, что ведет к нарушению температурного режима хранения товаров, подлежащих хранению в условиях холода;
-не соблюдаются правила товарного соседства, что может служить причиной перекрестного загрязнения готовых продуктов питания (молоко и молочные продукты, соленая и вяленая продукция, колбасы и др.) микроорганизмами, находящимися на поверхности сырой продукции (яиц, мяса и др.)
-не исключен риск загрязнения продуктов питания опасными микроорганизмами как в процессе производства, транспортировки, хранения и обработки, так и в местах реализации. Зачастую несанкционированная торговля ведется с использованием подручных средств - коробок, деревянных ящиков, которые, как правило, добываются из мусорных контейнеров, складных столов, часто торговля ведется прямо с земли. Молочная продукция (творог, сметана, молоко), соленья, как правило, не расфасованы, свободны для проникновения насекомых и продуктов их жизнедеятельности. Выхлопные газы проезжающих автомобилей, брызги, летящие от колес, пыль и грязь также не способствуют сохранению качества продуктов питания. Транспортные средства, с которых зачастую реализуют продукты питания, не проходят дезинфекцию и обработку моющими средствами.
При покупке некачественных продуктов в местах несанкционированной торговли их невозможно обменять на качественный товар, получить компенсацию в денежном эквиваленте, а в случае отравления - практически невозможно установить его причину.
Приобретайте продукты питания только в стационарных объектах торговли, оснащенных специальным оборудованием, где за качество и безопасность реализуемой продукции несет ответственность руководитель данного предприятия. Если вы не хотите рисковать своим здоровьем и здоровьем своих близких – откажитесь от приобретения товаров и продуктов питания в местах несанкционированной торговли!
Врач-гигиенист СЭО Ирена Ерух
27.12.2024
В целях обеспечения санитарно-эпидемиологического благополучия населения и недопущения к реализации продукции, представляющей потенциальную опасность для здоровья людей, информируем, что лабораторным отделом Гродненского областного ЦГЭОЗ по результатам испытаний выявлена продукция, несоответствующая санитарно-эпидемиологическим и гигиеническим требованиям:

Грецкий орех ядра. Изготовитель: ООО NASSAR TRADING AGRO, Саморкандская область, ПАЙАРЫКСКИЙ РАЙОН САНОАТ ДАРВИШИК МФИ, С. ДАРВИШИК, Узбекистан; адрес производства: Минская область, Минский район, Щомыслицкий с/с, 16/2, промзона ТЭЦ-4. Упаковщик: ООО «ДЕТАВИ», 2-й велосипедный переулок, 32-9. Масса нетто 500 г. Штрих код 4811028004866. Дата изготовления 25.04.2024. Упаковано 02.07.2024, годен до 02.04.2025
Продукция не соответствует по органолептическим показателям-присутствует привкус горечи и несвойственный доброкачественному продукту запах окисления, и по микробиологическим показателям – наличие плесени и БГКП (колиформы).
Информацию подготовила врач-гигиенист
Ошмянского районного ЦГЭ Ерух Ирена Валерьевна
14.10.2024

В целях обеспечения санитарно-эпидемиологического благополучия населения и недопущения к реализации продукции, представляющей потенциальную опасность для здоровья людей, информируем, что лабораторным отделом Гродненского областного ЦГЭОЗ по результатам испытаний выявлена продукция, несоответствующая санитарно-эпидемиологическим и гигиеническим требованиям:
Вафли сгущенное молоко. ГОСТ 14031-2014. Масса нетто упакованной единицы: 600 г. Изготовитель: ООО «ПК «Кундрат». Место нахождения и адрес осуществления деятельности: 346481, Российская Федерация, Ростовская область, Октябрьский район, хутор Заречный, ул. Заречная, дом 58, тел. +7(8636) 22-30-55. Изготовитель: ООО «ПК «Кундрат». Место нахождения и адрес осуществления деятельности: 346481, Российская Федерация, Ростовская область, Октябрьский район, хутор Заречный, ул. Заречная, дом 58, тел. +7(8636) 22-30-55. Импортеры/поставщики в Республике Беларусь: ООО «ЛенПродуктСервис» 220099, г. Минск, ул. Казинца, пом. 11а (офис А 506), ООО «МосПродуктСервис», г.Брест, ул.Карьерная, д.10А-10; ООО «ВитебскПродуктСервис», г.Витебск, ул. Богатырева,8А-3, 2-й этаж; ООО «ГомельПродуктСервис», г.Гомель, ул.Федюнинского, д.17, каб.4-6. Состав: мука пшеничная хлебопекарная высшего сорта, сахар, жир кондитерский (рафинированные дезодорированные масла в натуральном и модифицированном виде, эмульгатор – соевый лецитин, антиокислитель – концентрат смеси токоферов), молоко цельное сгущенное с сахаром (цельное молоко, обезжиренное молоко, сахар (сахароза, лактоза)) крахмал кукурузный высшего сорта, молоко сухое цельное, эмульгатор – лецитин соевый, масло подсолнечное рафинированное дезодорированное, ароматизатор «Сгущенное молоко», соль пищевая, разрыхлители: карбонат аммония, гидрокарбонат натрия. Штриховой код: 4610144713115. Дата изготовления: 18.07.2024. Срок годности: 8 месяцев.
Продукция не соответствует по маркировке в части предоставления достоверной информации о составе продукта: в состав продукта входит обнаруженная в результате проведенных испытаний, незаявленная изготовителем на маркировке, пищевая добавка сорбиновая кислота (Е200) и сорбат калия (Е202) в пересчете на сорбиновую кислоту.
Информацию подготовила врач-гигиенист
Ошмянского районного ЦГЭ Ерух Ирена Валерьевна
10.10.2024
Поздняя осень - это не повод убирать до весны грибные корзинки и ножи. Однако стоит помнить, что там, где растут съедобные грибы, всегда существуют их ядовитые «двойники», представляющие смертельную опасность для человека. Несмотря на хорошо известные внешние признаки ядовитых грибов ежегодно в различных странах мира происходят тяжелые, порой массовые отравления, заканчивающиеся в отдельных случаях смертельным исходом.
За 8 месяцев 2024 года в Республике Беларусь уже зарегистрировано 9 случаев отравлений грибами, из них в 1 случай в Гродненской области.
Для того чтобы избежать отравления грибами, необходимо соблюдать элементарные правила профилактики:
- Собирать только известные грибы. Не уверены – не берите!
- После сбора грибы необходимо как можно быстрее подвергать сортировке и обработке. Следует помнить, что даже самый лучший и, безусловно, съедобный гриб, если он перезрел, начал подгнивать или долго лежал без обработки, может стать ядовитым.
- Сортировкой и приготовлением грибов должны заниматься только взрослые.
- Не собирать и не покупать на рынке переросшие, дряблые, поврежденные личинками и плесенью грибы.
- Не пробовать подозрительные грибы на вкус.
- Необходимо отваривать все грибы, а отвар сливать, так как грибы обладают способностью поглощать из окружающей среды и накапливать токсичные вещества в концентрациях, в несколько раз превышающих содержание их в почве, воде, растениях. По этой же причине нельзя собирать грибы вдоль автотрасс, рядом с промышленными предприятиями, в черте города.
- Нужно заготавливать впрок только молодые грибы.
- Солить, сушить, мариновать каждый вид грибов отдельно.
- Перед отвариванием тщательно мыть грибы от частичек песка и почвы.
- Никогда не покупать на рынке и «с рук» грибные консервы, герметично закрытые крышками в домашних условиях, а также сухие грибы, грибную икру и различные салаты с грибами.
- Пластинчатые грибы необходимо осмотреть и брать только с ножками - таким образом, можно идентифицировать бледную поганку, имеющую клубневидное утолщение ножки «воротничок».
- Не пренебрегать правилами приготовления условно-съедобных грибов: их необходимо минимум дважды отваривать, каждый раз не менее 50 минут. Оба раза грибы после варки нужно промывать проточной водой.
- Родители должны помнить, что грибы должны быть исключены из рациона детей.
- Нельзя употреблять в пищу грибы людям, имеющим болезни печени и обмена веществ, лицам преклонного возраста.
При появлении первых признаков отравления, не занимайтесь самолечением – обратитесь за медицинской помощью!
Санитарно-эпидемиологический отдел
03.10.2024
В местах несанкционированной торговли реализация пищевой продукции осуществляется без холодильного оборудования, что приводит к нарушению температурных условий хранения продукции. Также торговля осуществляется в большинстве своем непосредственно с земли либо с использованием приспособленной тары, инвентаря, из транспортных средств, непригодных для перевозки и хранения пищевой продукции, что значительно увеличивает риск ее порчи и загрязнения. Если торговля идет вблизи транспортных магистралей, продукты питания дополнительно впитывают пыль и химические вещества, содержащиеся в выхлопных газах автомобилей.
После покупки пищевой продукции в местах несанкционированной торговли впоследствии какие-либо претензии предъявлять попросту некому: на товаре нет маркировки, документы на продукцию отсутствуют (где ее собирали или изготавливали, осуществлялся ли лабораторный контроль качества, в том числе исследования на радиацию, не установить). Также неясны дата изготовления и сроки годности таковой продукции. Ну и к тому же важно добавить, что данные о состоянии здоровья таковых нелегальных продавцов большая загадка. Покупая в данных местах товар вместе с ним можно приобрести весьма опасные для здоровья заболевания, которые трудно поддаются лечению и могут остаться на всю жизнь, при этом значительно ее укоротив, - трихинеллез, бруцеллез, ботулизм, не говоря уже о банальных, а иногда и нет, кишечных инфекциях.
Поэтому, стоит ли рисковать?
Информацию подготовила помощник врача-гигиениста
Ошмянского районного ЦГЭ Семенова Антонина Викторовна
03.09.2024
Государственное учреждение «Ошмянский районный ЦГЭ» информирует об отмене с 21 августа 2024 г. введенной постановлением заместителя Министра – Главного государственного санитарного врача Республики Беларусь от 23.02.2024 № 7 временной санитарной меры по запрету ввоза и обращения на территории Республики Беларусь продукции производства ООО «Тимоша» (140091, Россия, Московская область, г. Дзержинский, ул.Энергетиков, 42, ЛИТ. 1-1Б, этаж 3, комната 8) (далее – Общество) в связи с принятием на основании представленных Обществом доказательств, удостоверяющих перечень и эффективность проведенных корректирующих мероприятий, стабильность процессов производства, хранения, транспортировки продукции, а также действенности системы контроля безопасности и качества, включая результаты лабораторных исследований продукции, постановления заместителя Министра – Главного государственного санитарного врача Республики Беларусь от 21.08.2024 № 34.
Санитарно-эпидемиологический отдел
26.08.2024
На сегодняшний день подавляющее большинство заболеваний щитовидной железы излечимо, а в части случаев предотвратимо. Последнее касается заболеваний, связанных с дефицитом йода в питании. Йодный дефицит, вопреки популярным представлениям, приводит не только к увеличению размера щитовидной железы, но. воздействуя, например, на организм, беременной женщины, может привести к необратимым изменениям со стороны нервной системы плода, крайним проявлением которых является кретинизм, сопровождающихся тяжелой умственной отсталостью.
Эндемический зоб — это заболевание щитовидной железы, проявляющееся увеличением ее объема и встречающееся в географических районах с недостаточным содержанием йода, в пище, воде, воздухе. На всей территории Республики Беларусь регистрируется йодный дефицит той или иной степени выраженности. В связи с этим особо важное значение для профилактики заболеваний щитовидной железы имеет использование в пищу йодированной соли. Суточная потребность человека, в йоде составляет 180—220мкг.
Благодаря Государственной программе йодный дефицит ликвидирован в Республике Беларусь, но при прекращении или сокращении использования йодированной соли йодный дефицит возникает вновь, поскольку естественное содержание йода в почве, воде и продуктах питания незначительное, территория по прежнему остается эндемичной по дефициту йода.
С целью профилактики заболеваний, вызванных дефицитом йода, ВОЗ рекомендовало проводить обогащение пищевой соли йодом. Потребность организма в йоде может быть удовлетворена за счет поступления его в составе йодированной соли. В торговой сети йодированной соли должно быть не менее 75%.
Информацию подготовила помощник врача-гигиениста
Ошмянского районного ЦГЭ Семенова А.В.
29.07.2024

Лето – это сезон не только отпусков и каникул, солнечных пляжей, ягод, грибов и фруктов, но и время различных кишечных инфекционных заболеваний. Испорченные овощи и фрукты, несоблюдение правил личной гигиены и не правильное хранение продуктов являются основными факторами риска. В жаркое время прямо пропорционально расцвету зелени размножаются и распространяются различные возбудители кишечных инфекций. Поэтому летом вопрос профилактики таких заболеваний становится особенно актуальным.
Симптоматика кишечных инфекций: подъем температуры до фебрильных цифр, сильная слабость, боли в животе, диарея, тошнота, рвота, головная боль.
Помните: любое заболевание легче предупредить, чем лечить!
Для предупреждения кишечных инфекций, соблюдайте простые правила профилактики:
- для питья использовать только воду гарантированного качества (бутилированную или кипяченую);
- не купаться в неотведенных для этого местах;
- не покупать продукты в местах несанкционированной торговли;
- мыть руки перед едой;
- не употреблять продукты после истечения их срока годности, а также соблюдать правила хранения продуктов в домашних условиях;
- защищать пищу и посуду от грызунов и домашних животных, возможных переносчиков инфекции и вести борьбу с мухами и тараканами;
- посуду, где хранились сырые продукты, тщательно мыть с моющими средствами, ошпаривать;
- пользоваться разделочным инвентарем (ножами, разделочными досками) отдельно для сырых и готовых продуктов;
- готовить на один прием молочную смесь для детей раннего возраста;
При появлении первых симптомов кишечной инфекции не откладывайте визит к врачу, ведь чем скорее будет поставлен диагноз, тем быстрее вы сможете вернуться к привычной жизни, и продолжите наслаждаться летним сезоном.
Желаем вам крепкого здоровья и хорошего лета!
Врач-гигиенист санитарно-
эпидемиологического отдела Ирена Ерух
30.05.2024
Государственное учреждение «Ошмянский районный ЦГЭ» информирует, что заместителем Главного государственного инспектора Республики Беларусь по надзору за соблюдением технических регламентов разрешен ввоз и обращение на территории Республики Беларусь:
с 28 марта 2024 года – кетчупа высшей категории «Семилукская трапеза» Сладкого; кетчупа высшей категории «Семилукская трапеза» Томатного; кетчупа второй категории «Семилукская трапеза» Шашлычного, изготовленных ООО «Семилукский пищекомбинат», запрещенных предписаниями от 26.04.2023 № 06-11-123/379, от 07.04.2022 № 06-11-123/330, от 08.06.2023 № 06-11-13/541 (разрешение от 28.03.2024 № 06-11-4/284).
с 01 апреля 2024 года – конфет желейных «Koke» (Gummy Burst), изготовленных HEBEI XIAOXIXI FOOD SCIENCE AND TECHNOLOGI CO., LTD, Китай, запрещенных предписанием от 22.12.2023 № 06-11-123/1382 (разрешение от 29.03.2024 № 06-11-4/297).
Санитарно-эпидемиологический отдел
15.04.2024

Государственное учреждение «Ошмянский районный ЦГЭ» информирует о вступлении в силу
постановление Заместителя Министра - Главного государственного санитарного врача Республики Беларусь от 01.04.2024 № 21 «О запрете ввоза на территорию Республики Беларусь, реализации, хранения, транспортировки, использования пищевой продукции производства ООО «ОРИМИ», Россия».
Сведения об опасной продукции и прекращении действия документов о подтверждении соответствия на территории Республики Беларусь размещены на официальном сайте Государственного комитета по стандартизации Республики Беларусь (https://gosstandart.gov.by): Информационный ресурс «Опасная продукция».
Санитарно-эпидемиологический отдел
05.04.2024
Государственное учреждение «Ошмянский районный ЦГЭ» информирует о вступлении в силу постановление Заместителя Министра – Главного государственного санитарного врача Республики Беларусь от 21.03.2024 № 18 (далее – постановление).
Данным постановлением отменен запрет ввоза на территорию Республики Беларусь, реализации, хранения, транспортировки, использования пищевой продукции производства ООО «Злынковский завод новых технологий по производству вин и напитков «КАСКАД» (Россия, Брянская область, г. Злынка, ул. Советская, 97), установленный постановлением Главного государственного санитарного врача Республики Беларусь от 30.06.2023 № 17.
В соответствии с пунктом 2.1. постановления импортерам (поставщикам) в Республику Беларусь продукции ООО «Злынковский завод новых технологий по производству вин и напитков «КАСКАД» необходимо обеспечить проведение лабораторного контроля содержания красителей, объемной доли этилового спирта в аккредитованных лабораториях системы Министерства Здравоохранения Республики Беларусь каждой партии, ввезенной на территорию Республики Беларусь импортной продукции, в порядке производственного контроля в течение года с даты принятия настоящего постановления.
Санитарно-эпидемиологический отдел
04.04.2024
Государственное учреждение «Ошмянский районный ЦГЭ» информирует о вступлении в силу постановления Заместителя Главного государственного санитарного врача Республики Беларусь «О прекращении действия свидетельства о государственной регистрации» от 18.03.2024 № 5.1-15/187 и от 18.03.2024 № 5.1-15/188.
Постановлением от 18.03.2024 № 5.1-15/187 прекращено действие свидетельства о государственной регистрации № BY.70.06.01.003.Е.006032.12.19 от 06.12.2019 на продукцию: Биологически активная добавка к пище «Хела-Маг В6 Форте Шот» (вкус вишня) («Chela-Mag B6 Forte Shot» (cherry flavour)), ампулы 25 мл №20, изготовитель Olimp Laboratories Sp.z o.o., Pustynia 84F, 39-200 Debica, Польша, в связи с прекращением ввоза указанной продукции.
Постановлением от 18.03.2024 № 5.1-15/188 прекращено действие свидетельства о государственной регистрации № BY.70.06.01.003.Е.000828.02.19 от 27.02.2019 на продукцию: БАД к пище «Хела-ФЕРР Форте» / «Сhela-Ferr Forte», капсулы 380 мг №30, изготовитель Olimp Laboratories Sp.z o.o., Pustynia 84F, 39-200 Debica, Польша, в связи с прекращением ввоза указанной продукции.
Санитарно-эпидемиологический отдел
04.04.2024
Государственное учреждение «Ошмянский районный ЦГЭ» информирует об отмене с 06 мая 2024 года введенной постановлением заместителя Министра - Главного государственного санитарного врача Республики Беларусь от 23.02.2024 № 8 временной санитарной меры по запрету ввоза и обращения на территории Республики Беларусь продукции производства общества с ограниченной ответственностью «Кофе-цикорный комбинат «АРОНАП» (152151, Россия, Ярославская область, Ростовский район, г. Ростов, ул. Пролетарская, 40) (далее – Общество) в связи с принятием на основании представленных Обществом доказательств, удостоверяющих перечень и эффективность проведенных корректирующих мероприятий, стабильность процессов производства, хранения, транспортировки продукции, а также действенности системы контроля безопасности и качества, включая результаты лабораторных исследований продукции, постановления заместителя Министра – Главного государственного санитарного врача Республики Беларусь от 06.05.2024 №25.
Санитарно-эпидемиологический отдел
04.04.2024

В соответствии с положениями технического регламента Таможенного союза «О безопасности пищевой продукции»
ТР ТС 021/2011 срок годности пищевой продукции – период времени, в течение которого пищевая продукция должна полностью соответствовать предъявляемым к ней требованиям безопасности, установленным настоящим техническим регламентом и (или) техническими регламентами Таможенного союза на отдельные виды пищевой продукции, а также сохранять свои потребительские свойства, заявленные в маркировке, и по истечении которого пищевая продукция не пригодна для использования по назначению.
Технический регламент Таможенного союза «Пищевая продукция в части ее маркировки» (ТР ТС 022/2011) (далее – ТР ТС 022/2011), устанавливает на единой таможенной территории Евразийского экономического союза требования к пищевой продукции в части ее маркировки в целях предупреждения действий, вводящих в заблуждение потребителей относительно обеспечения реализации прав потребителей на достоверную информацию о пищевой продукции.
В ТР ТС 022/2011 (статья 4, часть 4.7, пункты 1-3) установлена необходимость указания срока годности в маркировке пищевой продукции с использованием следующих слов:
«годен до» с указанием часа, числа, месяца при сроке ее годности до 72 часов;
«годен до» с указанием числа, месяца, года при сроке ее годности от 72 часов до трех месяцев;
«годен до конца» с указанием месяца, года или «годен до» с указанием числа, месяца, года при сроке ее годности не менее трех месяцев.
В целях указания срока годности пищевой продукции может использоваться слово «годен» с указанием количества суток, месяцев или лет либо при сроке годности до 72 часов слово «годен» с указанием количества часов.
Важно отметить, что положения ТР ТС 022/2011 не содержат указаний к исчислению срока годности пищевой продукции.
При этом при выборе способа указания срока годности в маркировке упакованной пищевой продукции необходимо соблюдать следующие требования, установленные в ТР ТС 022/2011 (статья 4, часть 4.12, пункт 1): маркировка пищевой продукции, помещенной в потребительскую и(или) транспортную упаковку, должна быть понятной, легкочитаемой, достоверной и не вводить в заблуждение потребителей (приобретателей). При этом критерием понятности является однозначность передачи смысла информации о пищевой продукции.
Исчисление срока годности установлено статьей 443 Гражданского кодекса Республики Беларусь (далее – Кодекс), согласно которой срок годности определяется периодом времени, исчисляемым со дня (времени) изготовления товара, в течение которого он пригоден к использованию, либо датой, до наступления которой товар пригоден к использованию.
Течение срока, определенного периодом времени, начинается на следующий день после календарной даты или наступления события, которыми определено его начало (статья 192 Кодекса).
С учетом вышеизложенного, в качестве примера, приводится определение сроков годности продукции:
Пищевая продукция, со сроком годности:
12.2023 не пригодна для использования по назначению с 00.00 01.01.2024;
до 12.2023 – с 00.00.01.12.2023;
02.01.2024 – с 00.00 03.01.2024;
До 02.01.2024- с 00.00 02.01.2024.
Пищевая продукция с датой изготовления 9:50 01.10.2023 и сроком годности 5 суток не пригодна для использования по назначению с 9.50 06.10.2023.
Пищевая продукция с датой изготовления 06.10.2020 и сроком годности 3 года не пригодна для использования по назначению с 00.00 07.10.2023.
Врач-гигиенист (заведующий отделом) Мария Матович
СЭО
14.03.2024

Государственное учреждение «Ошмянский районный ЦГЭ» информирует о вступлении в силу постановления Заместителя Министра - Главного государственного санитарного врача Республики Беларусь:
от 23.02.2024 № 6 «О запрете ввоза на территорию Республики Беларусь, реализации, хранения, транспортировки, использования пищевой продукции производства ООО «Барнаульская халвичная фабрика», Россия» (далее – Постановление № 6);
от 23.02.2024 № 7 «О запрете ввоза на территорию Республики Беларусь, реализации, хранения, транспортировки, использования пищевой продукции производства ООО «Тимоша», Россия» (далее – Постановление № 7);
от 23.02.2024 № 8 «О запрете ввоза на территорию Республики Беларусь, реализации, хранения, транспортировки, использования пищевой продукции производства ООО «КЦК «АРОНАП», Российская Федерация (далее – Постановление № 8).
Сведения об опасной продукции и прекращении действия документов о подтверждении соответствия на территории Республики Беларусь размещены на официальном сайте Государственного комитета по стандартизации Республики Беларусь (https://gosstandart.gov.by): Информационный ресурс «Опасная продукция».
Санитарно-эпидемиологический отдел
12.03.2024

«Хлеб – всему голова»! Действительно, с глубокой древности хлеб был основой любого стола. Согласно рекомендации ВОЗ, хлеб должен входить в ежедневное питание человека. Не нужно бояться хлеба и тем более исключать его из рациона. До 200 граммов качественного хлеба не из белой муки и лучше с добавлением цельного зерна можно и очень полезно употреблять в пищу каждый день, считают эксперты Всемирной организация здравоохранения.
Хлеб является источником сложных или медленных углеводов, не очищенных от клетчатки (к пышным батонам и булкам из белой муки это не относится). Цельнозерновой хлеб позволяет организму дольше ощущать сытость и избегать вредных перекусов.
Один из самых больших плюсов качественного хлеба – это содержащиеся в нем аминокислоты. В хлебе их насчитывается 18 и практически каждая обладает полезным эффектом. В частности, в хлебе присутствует аминокислота триптофан, благодаря которой повышается настроение, улучшается сон, а также аминокислота цистин, активизирующая вывод токсинов и защищающая от преждевременного старения.
Кроме того, в составе хлеба есть витамины – например, витамины группы В, которые помогают работе сердца, витамин Е, укрепляющий иммунитет, а также медь, цинк, железо, калий, натрий, кальций и фосфор.
Хлеб – это простая и важная часть сбалансированного рациона. Людям без специфических заболеваний органов пищеварения можно есть любой хлеб. Но переедать не стоит никогда!
Врач-гигиенист санитарно-
эпидемиологического отдела Ирена Ерух
30.01.2024
Государственное учреждение «Ошмянский районный центр гигиены и эпидемиологии» информирует, что в соответствии со статьей 4.12 «Требования к способам доведения маркировки» технического регламента Таможенного союза ТР ТС 022/2011 «Пищевая продукция в части ее маркировки», где в пункте 5 указано, что при фасовании пищевой продукции организациями розничной торговли в отсутствии потребителя на потребительской упаковке или на прикрепленной к ней этикетке должны быть указаны наименование пищевой, дата ее изготовления, срок ее годности и условия хранения. Иные сведения, предусмотренные пунктом 1 части 4.1 и пунктом 13 части 4.4 настоящей статьи:
- состав пищевой продукции, за исключением свежих фруктов (включая ягоды) и овощей (включая картофель), которые не очищены от кожуры, не нарезаны или не обработаны подобным способом;
- уксуса, полученного из одного вида продовольственного сырья (без добавления других компонентов) и пищевой продукции, состоящей из одного компонента, при условии, что наименование пищевой продукции позволяет установить наличие этого компонента; количество пищевой продукции;
- наименование и место нахождения изготовителя и импортера (поставщика) пищевой продукции;
- рекомендации и (или) ограничения по использованию, в том числе приготовлению пищевой продукции в случае, если ее использование без данных рекомендаций или ограничений затруднено, либо может причинить вред здоровью потребителей, их имуществу, привести к снижению или утрате вкусовых свойств пищевой продукции;
- показатели пищевой ценности пищевой продукции; сведения о наличии в пищевой продукции компонентов, полученных с применением ГМО;
- единый знак обращения продукции на рынке государств – членов Таможенного союза; компоненты (пищевые добавки, ароматизаторы), биологически активные добавки, употребление которых может вызвать аллергические реакции или противопоказано при отдельных видах заболеваний) доводятся до потребителя любым способом, обеспечивающим возможность обоснованного выбора этой пищевой продукции (в том числе путем нанесения на потребительскую упаковку и (или) этикетку, и (или) на листок-вкладыш, помещаемый в каждую упаковочную единицу или прилагаемый к каждой упаковочной единице продукции.
Помощник врача-гигиениста А.В.Семёнова
26.01.2024
Основные факты:
1) Clostridium botulinum является бактерией, которая в условиях низкого содержания кислорода вырабатывает опасные токсины (ботулотоксины).
2) Ботулотоксины входят в число самых сильных из известных на сегодняшний день веществ смертельного действия.
3)Ботулотоксины блокируют нервные функции и могут приводить к дыхательному и мышечному параличу.
4) Пищевой ботулизм, вызываемый потреблением пищевых продуктов, не прошедших надлежащей обработки, является потенциально смертельной болезнью в случае, если он не диагностирован своевременно и не проведено лечение антитоксином.
5) Споры, вырабатываемые Clostridium botulinum устойчивы к высоким температурам и широко распространены в окружающей среде. При отсутствии кислорода эти споры прорастают, развиваются и начинают выделять токсины.
Симптомы пищевого ботулизма:
Симптомы обычно появляются через 12–36 часов (минимум через 4 часа и максимум через 8 дней) после принятия пищи, зараженной токсином. Течение ботулизма напоминает большинство пищевых отравлений: отмечаются рвота, боли в животе, жидкий стул. Это продолжается около суток. Затем у больного появляются слабость, сухость во рту и глотке, отмечается расстройство зрения. В дальнейшем развивается паралич мягкого неба, языка, глотки, гортани, мышц лица; нарушается язык, акты глотания и жевания. Больные ботулизмом должны быть срочно госпитализированы в инфекционное отделение. Благоприятный исход ботулизма зависит от своевременности введения противоботулической сыворотки.
Пути передачи:
- botulinum вырабатывает споры, которые широко распространены в окружающей среде, включая почву, а также речную и морскую воду.
- Консервированные или ферментированныев домашних условиях пищевые продукты являются одним из основных источников пищевого ботулизма, и при их приготовлении необходимо соблюдать особые меры предосторожности.
- Чаще всего это происходит в пищевых продуктах легкой консервации, а также в продуктах, не прошедших надлежащей обработки, консервированных или бутилированных в домашних условиях. В кислой среде (pH менее 4,6) развития C. botulinum не происходит, и поэтому в кислых продуктах токсин не вырабатывается (однако низкий уровень pH не разрушает токсинов, выработанных ранее). Для предотвращения роста бактерий и выработки токсина используются также низкие температуры хранения в сочетании с определенными уровнями содержания соли и/или кислотности.
- Ботулотоксин обнаружен в широком ряде пищевых продуктов, включая низкокислотные консервированные овощи, такие как зеленая фасоль, шпинат, грибы и свекла; рыбу, такую как консервированный тунец, ферментированная, соленая и копченая рыба; и мясные продукты, такие как ветчина и сосиски.
Профилактика
Лучшей профилактикой ботулизма является употребление консервов только промышленного приготовления.
При изготовлении консервов в домашних условиях следует соблюдать следующие несложные правила:
- — овощи, фрукты, ягоды и грибы должны быть хорошо отмыты от частиц земли;
- — недопустимо консервировать давно снятые, испорченные овощи, фрукты, ягоды и грибы;
- — рыбу после улова нужно быстро выпотрошить, промыть проточной водой и хранить в условиях холода;
- — следует строго соблюдать правила стерилизации банок, крышек и режим тепловой обработки продуктов в домашних условиях;
- — необходимо хранить домашние консервы при низких температурах, обязательно отбраковывать и уничтожать бомбажные (вздутые) банки;
- — перед употреблением в пищу консервированных продуктов их лучше прокипятить в течение 20-25 минут (за это время разлагается токсин ботулизма);
- — засолку грибов не следует производить в герметически закрытых банках, добавлять в рассол растительное масло, т.к. это создает безкислородную среду и может способствовать размножению бактерии ботулизма и накоплению токсина, особенно в емкостях с плотно утрамбованными грибами;
- — запрещается покупать на рынках (с рук) изготовленные в домашних условиях вяленую, соленую и копченую рыбу, вяленое мясо, консервированные грибы или овощи в банках с закатанными крышками.
Несмотря на то, что споры C. botulinum устойчивы к высоким температурам, токсин, вырабатываемый бактериями, которые развиваются из спор в анаэробных условиях, разрушается при кипячении (например, при температуре внутри >85 C0 в течение пяти или более минут). Поэтому тщательная обработка пищевых продуктов на всех стадиях приготовления — от мытья до термической обработки — это залог Вашей безопасности.
Врач-гигиенист санитарно-
эпидемиологического отдела Ирена Ерух
08.01.2024
Грядут новогодние праздники - самые долгожданные и любимые! Время застолья и подарков!
Как встретить новый год без вреда для здоровья? Как уберечь себя и своих близких от самых неожиданных опасных ситуаций?
Избежать пищевых отравлений и не испортить праздничное настроение себе, своим родным и близким позволят простые правила, которые необходимо соблюдать:
- откажитесь от покупки пищевых продуктов в местах несанкционированной торговли у случайных лиц;
- изучайте срок годности и условия хранения продуктов и соблюдайте их;
- не употребляйте пищевые продукты даже при малейшем сомнении относительно их доброкачественности;
- выполняйте правила личной гигиены и гигиены помещений, в которых Вы готовите праздничные блюда;
- соблюдайте правила товарного соседства при хранении пищевых продуктов – не храните на одной полке холодильника сырую и готовую продукцию;
- не пренебрегайте выполнением необходимой последовательности и продолжительности каждого этапа технологической обработки пищевых продуктов – правильный температурный режим и необходимое для готовки время при обжаривании, отваривании мяса, яиц, других ингредиентов для праздничных блюд, обработка горячей проточной водой зелени, сырых овощей, фруктов и т.д.;
- не готовьте еду впрок на несколько дней вперед, соблюдайте умеренность при употреблении пищи и алкогольных напитков, старайтесь провести праздничные дни активно на свежем воздухе.
Не маловажным для создания праздничного настроения в канун новогодних праздников является и выбор новогодних подарков, особенно для детей:
-приобретайте подарки для детей только в местах организованной торговли (магазины, супермаркеты, официальные рынки, ярмарки и др.);
- внимательно изучайте информацию на маркировке о сроках годности, условиях хранения, составе продукции при покупке сладких новогодних наборов, помните, что в состав набора для ребенка не должны входить изделия, содержащие алкогольную продукцию;
- отдавайте предпочтение мармеладу, пастиле, сухофруктам, продукции для детского питания, изделиям с низким содержанием сахара, без искусственных красителей и пищевых добавок, консервантов при самостоятельном формировании детского новогоднего подарка;
- приобретая игрушку, обратите внимание на этикетку (она должна быть обязательно!) и изучите предупредительные надписи, которые могут указывать на возможность использования игрушки только в присутствии взрослых, на ограничение использования игрушки по возрасту, а также информацию о наименовании игрушки, стране изготовления, местонахождении изготовителя и его товарном знаке, минимальном возрасте ребенка, для которого предназначена игрушка, способах ухода за игрушкой, дате изготовления, сроке службы и условиях хранения;
- откажитесь от покупки игрушки, если она имеет стойкий неприятный запах, острые выступающие части и углы, о которые ребёнок может пораниться, громкий звук, издаваемый игрушкой, который может раздражать слух и пугать ребёнка;
- перед покупкой игрушки с музыкальным сопровождением, прослушайте все мелодии, обратите внимание на громкость звука и возможность его регулировки, а при покупке музыкальных духовых игрушек обратите внимание на места для соприкосновения с губами детей — они должны быть изготовлены из материалов, не впитывающих влагу;
- приобретая электрическую игрушку, убедитесь, что ни на одной ее составной части номинальное напряжение не превышает 24В, а детали, контактирующие или способные контактировать с источником электрической энергии, а также кабели, провода изолированы и механически защищены;
-игрушка, внутри которой может поместиться ребенок и представляющая для него замкнутое пространство, должна иметь отверстие для выхода, легко открываемое изнутри, а также поверхность с вентиляционными отверстиями;
-откажитесь от покупки детям до 3-х лет игрушек из натуральных меха и кожи, древесной коры, а также игрушек, имеющих фарфоровые, стеклянные, бумажные и картонные элементы;
-выбирая ребенку набор для химических экспериментов, тщательно изучите его состав – он не должен содержать вещества или реактивы, которые могут при смешивании воспламениться, образовывать вредные пары или газы, взрывчатые смеси;
- игрушки, на которых ребенок может ездить, необходимо перед покупкой проверить на прочность и устойчивость к опрокидыванию, в игрушках с механическим или электрическим приводом – убедиться в наличии тормозных устройств, а в игрушках с цепной передачей – защитных щитков.
Врач-гигиенист
санитарно-эпидемиологического отдела Ирена Ерух
05.12.2023
Африканская чума свиней (АЧС) – особо опасная высококонтагиозная вирусная болезнь домашних и диких свиней, характеризующаяся быстрым распространением, высокой степенью смертности.
Погибает до 100 % заболевших свиней.
Африканская чума свиней не представляет опасности для здоровья людей
Лекарственные средства для профилактики и лечения АЧС отсутствуют.
Источником болезни являются больные свиньи, выделяющие вирус с мочой, калом, истечениями из носа и другими выделениями.
Передача заболевания здоровым животным может осуществляться через зараженные вирусом корма, подстилку, навоз, трупы и продукты убоя животных (мясо, мясопродукты, кровь).
Клинические признаки заболевания. От заражения до появления клинических признаков проходит 5-10 дней. У животных повышается температура тела до 42оС, появляются отдышка, кашель, пропадает аппетит, усиливается жажда, отмечаются приступы рвоты и паралича задних конечностей, на коже внутренней поверхности бедер, на животе, шее, у основания ушей, на пятачке и хвосте становятся заметны красно-фиолетовые пятна.
Смерть наступает на 1-5 день, реже позднее.
Во избежание возникновения и распространения африканской чумы свиней необходимо соблюдать следующие меры:
проводить ежедневный осмотр свиней с целью своевременного выявления возможного заболевания животных;
не скармливать свиньям пищевые отходы и отходы, полученные после забоя свиней, производить утилизацию отходов в установленных местах;
не приобретать корма и кормовые добавки неизвестного происхождения в неустановленных торговых местах (обязательны наличие документов, подтверждающих происхождение и безопасность кормов, наличие разрешения на торговлю и т.д.);
не приобретать живых свиней, мясо и мясопродукты в неустановленных торговых точках, без ветеринарных сопроводительных документов;
не допускать посещения личных подворий посторонними лицами;
постоянно вести борьбу с грызунами;
не завозить свиней без согласования с Государственной ветеринарной службой района из других регионов;
при выявлении признаков заболевания, падежа, вынужденного убоя животных на территории города срочно информировать государственную ветеринарную службу города Ошмяны.
Санитарно-эпидемиологический отдел
02.11.2023
Государственное учреждение «Ошмянский районный ЦГЭ» информирует о вступлении в силу Постановления заместителя Министра - Главного государственного санитарного врача Республики Беларусь от 04.09.2023 № 20. Данным постановлением запрещен ввоз на территорию Республики Беларусь, реализация, хранение, транспортировка, использование салфеток бумажных «GRATIAS» дизайн «Сердце из роз», «Цветущие пионы», ГОСТ Р-52354-2005, производства ООО «ТишьюПром», Российская Федерация, 141201, Московская область, Пушкинский муниципальный район, г. Пушкино, мкр-он Междуречье, ул.Словянская, д.2, ком.73; адрес производства: Московскаая область, Сергиево-Посадский муниципальный район, городское поселение Сергеев Посад, г. Сергиев Посад, ул. Строительная, д.11Б.
Сведения об опасной продукции и прекращении действия документов о подтверждении соответствия на территории Республики Беларусь размещены на официальном сайте Государственного комитета по стандартизации Республики Беларусь (https://gosstandart.gov.by): Информационный ресурс «Опасная продукция».
Санитарно-эпидемиологический отдел
11.09.2023
Государственное учреждение «Ошмянский районный ЦГЭ» информирует о выступлении в силу
Постановления заместителя Министра - Главного государственного санитарного врача Республики Беларусь от 28.08.2023 № 19 «О запрете ввоза на территорию Республики Беларусь, реализации, хранения, транспортировки, использования продукции производства ООО «Ярцевский комбинат алкогольных и безалкогольных напитков», Россия».
Продукция ООО «Ярцевский комбинат алкогольных и безалкогольных напитков» не соответствует требованиям технического регламента Таможенного союза «О безопасности пищевой продукции» (ТР ТС 021/2011), технического регламента Таможенного союза «Пищевая продукция в части ее маркировки» (ТР ТС 022/2011) в части предоставления достоверной информации о составе продукции: сокосодержащий напиток из смеси фруктов и ягод «Фруктово-ягодная поляна» торговой марки «Yesta» для питания детей дошкольного и школьного возраста (с 3-х лет); сокосодержащий напиток из яблок, вишни, черноплодной рябины «Спелая Вишня» торговой марки «Yesta» для питания детей дошкольного и школьного возраста (с 3-х лет), в которой по результатам лабораторных испытаний выявлены синтетические красители азорубин (Е122) в количестве от 2,1 ±0,3 мг/кг до 5,0±0,3 мг/кг, понсо 4 R (Е124) в количестве от 1,1 ±0,2 мг/кг до 2,5±0,1 мг/кг (протоколы испытаний государственного учреждения «Брестский областной центр гигиены, эпидемиологии и общественного здоровья» от 29.06.2023 № Б-4010, от 06.07.2023 № Б-4244, государственного учреждения «Минский областной центр гигиены, эпидемиологии и общественного здоровья» от 11.08.2023 № 241-гн, от 17.08.2023 № 275-гн), что указывает на признаки фальсификации данной пищевой продукции для питания детей дошкольного и школьного возраста (партии продукции, ввезенные на территорию Республики Беларусь, сопровождались свидетельствами о государственной регистрации №BY.70.06.01.005.E.001121.03.19 от 22.03.2019, действие которых не распространяется на продукцию с содержанием красителей).
Сведения об опасной продукции и прекращении действия документов о подтверждении соответствия на территории Республики Беларусь размещены на официальном сайте Государственного комитета по стандартизации Республики Беларусь (https://gosstandart.gov.by): Информационный ресурс «Опасная продукция».
Санитарно-эпидемиологический отдел
06.09.2023
Государственное учреждение «Гродненский областной центр гигиены, эпидемиологии и общественного питания» информирует, что Постановлением заместителя Министра - Главного государственного санитарного врача Республики Беларусь от 16.08.2023 № 18 запрещен ввоз на территорию Республики Беларусь, реализация, хранение, транспортировка, использование пищевой продукции, содержащей мухоморы (белый, поганковидный, желто-зелёный, порфировый, пантерный, красный) Amanita virosa Seer. A. citrina S.F Gray (A. Mappa Lasch Quel) A. pantherina (Fr.) Secr. A. muscaria (Fr.) Hooker). Данные виды грибов включены в список ядовитых и несъедобных грибов.
ОБРАЩАЕМ ВАШЕ ВНИМАНИЕ, ЧТО НА СЕГОДНЯШНИЙ ДЕНЬ НЕТ НИ ОДНОГО НАУЧНОГО ДОКАЗАТЕЛЬСТВА О ПОЛОЖИТЕЛЬНОМ ВЛИЯНИИ МУХОМОРОВ, ВКЛЮЧАЯ МИКРОДОЗЫ, НА ОРГАНИЗМ ЧЕЛОВЕКА!
Напротив, вещества, содержащиеся в мухоморах, являются психоактивными и ведут к появлению у человека изменённых состояний сознания; при длительном употреблении токсичное вещество гриба накапливается в организме человека и может негативно сказаться на работе сердца и вызвать проблемы с дыханием, а также повлиять на репродуктивную функцию и генетику; не исключены угнетение сознания до уровня комы или наступление летального исхода.
Факты предложений к реализации данной продукции встречаются в сети Интернет, где продукция, содержащая ядовитые грибы, представляется как биологически активная добавка к пище.
Обращение биологически активных добавок к пище на территории нашей страны осуществляется исключительно при наличии свидетельства о государственной регистрации, оформленного по Единой форме, подтверждающего безопасность продукции (товаров) и разрешающее свободное обращение продукции.
Сведения о продукции, прошедшей государственную регистрацию, включаются в единый реестр свидетельств о государственной регистрации и находятся в свободном доступе на официальном сайте Евразийской экономической комиссии.
Будьте внимательными и при покупке подобной продукции, особенно в сети Интернет, учитывайте данную информацию.
При обнаружении указанной продукции в реализации информируйте территориальные органы государственного санитарного надзора и (или) Гродненский областной центр гигиены, эпидемиологии и общественного здоровья.
Все изображения носят иллюстративный характер.
Санитарно-эпидемиологический отдел
17.08.2023
В целях обеспечения санитарно-эпидемиологического благополучия населения и недопущения к реализации продукции, представляющей потенциальную опасность для здоровья людей, информируем, что лабораторным отделом Гродненского областного ЦГЭОЗ по результатам испытаний контрольного образца выявлена пищевая продукция, несоответствующая санитарно-эпидемиологическим и гигиеническим требованиям:
Творог «DANKE», с массовой долей жира 9%.

Изготовитель: ООО «Актанышский молочный комбинат», Росийская федерация, Республика Татарстан, Актанышский район, п.Совхоза им.Кирова, 3-д СОМ ул., д.14, оф.1, адрес производства: Росийская федерация, Республика Татарстан, Актанышский район, п.Совхоза им.Кирова, 3-д СОМ ул., д.14. Дата изготовления 20.06.2023, годен до 30.07.2013, при температуре 4+0С, масса нетто 650 грамм; продукция не соответствует по микробиологическим показателям: обнаружены дрожжи более 1,5•104 КОЕ/г, при норме не более 100 КОЕ/г; плесени 4,2•102 КОЕ/г, при норме не более 50 КОЕ/г
Информацию подготовила врач-гигиенист Ошмянского районного ЦГЭ Ерух Ирена Валерьевна
03.08.2023
В целях обеспечения санитарно-эпидемиологического благополучия населения и недопущения к реализации продукции, представляющей потенциальную опасность для здоровья людей, информируем, что лабораторным отделом Гродненского областного ЦГЭОЗ по результатам испытаний контрольного образца выявлена пищевая продукция, несоответствующая санитарно-эпидемиологическим и гигиеническим требованиям:
Арахис бланшированный (сырой) (SPLIT).

Изготовитель: AGROTECNOLOGIA Y SERVICIOS S.A., Аргентина, BELGRANO NO 58 – ADELIA MARIA 5843 – CORDOBA – ARGENTINA, Аргентина. Импортер в Беларуси: ЧП "Шалу", Беларусь, Минская область, Минский район, агрогородок Озерцо, ул. Центральная, д: 35А-25. Дата изготовления 31.05.2022, годен до 31.05.2024, хранить при температуре не выше 250С и относительной влажности не более 75 %, масса нетто 5,0 кг; продукция не соответствует по микробиологическим показателям: обнаружены плесени в количестве 2,7 х103 КОЕ/г, при норме не более 1 х 103 КОЕ/г.
Информацию подготовила врач-гигиенист Ошмянского районного ЦГЭ Ерух Ирена Валерьевна
05.07.2023
Значение овощей, фруктов и ягод в питании человека общеизвестно. Они вкусны, питательны, полезны для здоровья. Овощи и фрукты не обладают большой энергетической ценностью, но являются поставщиками важнейших нутриентов (пищевых веществ, необходимых для нормального осуществления обмена веществ), от которых напрямую зависит здоровье человека, они богаты витаминами, минералами, пищевыми волокнами.
Овощи и фрукты – действительно кладезь таких минералов, как кальций, магний, железо, цинк и витаминов А, С, Е и К.
Витамины являются биокатализаторами многих биохимических реакций, протекающих в организме.
- При нехваткевитамина А страдает зрение, иммунитет, ухудшается состояние кожи, ногтей и волос.
- Ретинолнеобходим для синтеза гормоново, роста костей, образования хрящевой ткани и коллагена.
- Витамин В1активно участвует в процессах энергетического и пластического обмена, поддерживает нормальное функционирование нервной и пищеварительной систем
- Витамин В2необходим полноценной работы нервной системы, обеспечения функции зрения, поддержания здоровья кожи и слизистых оболочек, выработки гормонов и созревания эритроцитов.
- Витамин Сзадействован более в чем 300 биологических процессах. Наиболее известна аскорбиновая кислота своей способностью укреплять иммунитет.
Овощи и фрукты являются основными поставщиками пищевых волокон, которые не перевариваются и не усваиваются в желудочно-кишечном тракте, но перерабатываются полезной микрофлорой кишечника. Пищевые волокна имеют свойство, словно губка, впитывать вредные соединения (токсины, яды, соли тяжелых металлов, радионуклиды) и выводить их за пределы внутренней среды тела человека. Они улучшают перистальтику кишечника, помогает данному органу своевременно избавляться от продуктов распада. Клетчатка принимает активное участие в восстановлении кишечной микрофлоры. Благодаря пищевым волокнам реально значительно снизить уровень в крови глюкозы и «плохого» холестерина. Иными словами, клетчатка противодействует атеросклерозу, сахарному диабету, гипертонии. Пищевые волокна очищают организм не только от опасных для здоровья и жизни человека накоплений, но также и от избыточного количества липидов и сахаров. Тем самым клетчатка помогает снизить вес. Пищевые волокна играют роль своеобразной пищи для ряда кишечных микроорганизмов, которые синтезируют витамины, ферменты, аминокислоты, иммуноглобулины.
Мало кто знает что, помимо витаминов, минеральных веществ и клетчатки, полезные фрукты и овощи содержат еще и минорные компоненты, которые служат защитой организма от вредного воздействия окружающей среды. И хотя в пище их совсем немного, они выполняют важнейшие функции: регулируют метаболизм.
Дефицит этих пищевых веществ и биологически активных компонентов приводит к снижению устойчивости организма к неблагоприятным факторам окружающей среды, формированию иммунодефицитных состояний, хронизации болезней, снижению качества жизни.
В организме эти полезные вещества не синтезируются, и получить их можно из продуктов растительного происхождения.
К числу природных минорных компонентов относятся следующие соединения: флавоноиды, пищевые индолы, органические кислоты.
- Флавоноиды участвуют в укреплении стенок капилляров, предупреждают кровотечения и снижают артериальное давление, защищая от гипертонии, снижают уровень холестерина крови и риск развития сердечно-сосудистых заболеваний. Кроме того, они помогают организму в борьбе с аллергией и опухолевыми процессами, защищают от воздействия свободных радикалов, нейтрализуют токсины.
- Пищевые индолы способны регулировать и стабилизировать иммунную систему человека и защищать от токсичных соединений. Индолы являются мощными антиканцерогенными соединениями, которые помогают предотвратить рак молочной железы и других органов.
- Органические кислоты(янтарная, яблочная, лимонная и др) придают продуктам приятный вкус, утоляют жажду, улучшают деятельность пищеварительного тракта, нормализуя кислотно-щелочной баланс (pH среды) и способствуя тем самым изменению состава микрофлоры в благоприятную сторону (уменьшают гниение), активизируют перистальтику кишечника, способствуя снижению риска развития многих желудочно-кишечных и других заболеваний. Органические кислоты, содержащиеся в клюкве, и бруснике обладают антисептическим действием.
Именно сочетанием и синергизмом всех компонентов обусловлено эффективное оздоравливающее действие овощей и фруктов для организма, поэтому необходимо регулярно употреблять их в пищу.
Рекомендуется потреблять не менее 400 граммов овощей и фруктов ежедневно. Но поскольку овощи и фрукты неравноценны по содержанию различных питательных веществ, желательно составлять недельное меню таким образом, чтобы ежедневно на столе присутствовало широкое разнообразие растительных продуктов. Причем полезны не только свежие овощи и фрукты, а также замороженные и сушеные, которые сохраняют свои уникальные свойства.
Все изображения носят иллюстративный характер.
Врач-гигиенист Ирена Валерьевна Ерух
23.06.2023
В целях обеспечения санитарно-эпидемиологического благополучия населения и недопущения к реализации продукции, представляющей потенциальную опасность для здоровья людей, информируем, что лабораторным отделом Ошмянского районного ЦГЭ по результатам испытаний контрольного образца выявлена пищевая продукция, несоответствующая санитарно-эпидемиологическим и гигиеническим требованиям:
Картофель ранний свежий. Страна происхождения: Пакистан.

Изготовитель: NATIONAL FRUIT PROCESSING FACTORY 5km Ajnala Road Bhalwal, Pakistan (40410). Импортер в Республику Беларусь: ООО «Евроторг», 220099, г.Минск, ул.Казинца,52А-22, тел +375 29 888880. Рекомендуемые условия хранения: при температуре воздуха от +40С до +60С и относительной влажности воздуха 90%-95%. Дата сбора и упаковки: 10 февраля 2023. Срок годности с даты упаковывания 120 суток. - не соответствует по санитарно-химическим показателям (обнаружены нитраты в количестве 468 мг/кг, при нормируемом значении не более 250 мг/кг)
Капуста белокочанная свежая. Страна происхождения: Узбекистан.

Изготовитель: МТПФ «НАМ-СИБ». Место нахождения: Наманганская область, город Наманган, Элобод МФЙ, улица Туракурган, дом 70, Республика Узбекистан. Импортер в Республику Беларусь: ООО «Артиус-16», 223054, Минская область, Минский район, д.Околица, Садовая, дом№3, офис 2. Условия хранения: при температуре от 0оС до +10 С и относительной влажности воздуха 85%-100% - не соответствует по санитарно-химическим показателям (обнаружены нитраты в количестве 1605 мг/кг, при нормируемом значении не более 900 мг/кг).
Информацию подготовил врач-гигиенист (заведующий отдела) санитарно-эпидемиологического отдела Ошмянского районного ЦГЭ Матович Мария Валерьевна
10.05.2023
В целях обеспечения санитарно-эпидемиологического благополучия населения и недопущения к реализации продукции, представляющей потенциальную опасность для здоровья людей информируем, что Ошмянским районным ЦГЭ по результатам испытаний лабораторного отдела Ошмянского районного ЦГЭ выявлена пищевая продукция, несоответствующая санитарно-эпидемиологическим и гигиеническим требованиям:
Быстрозамороженные овощи для жарки «по-беларуски».
- Дата изготовления 12.11.2022. Годен до 12.05.2024. Хранить при температуре не выше минус 180С;
- Изготовитель: Oerlemans Foods Siemiatycze Sp.z.o.o. ул.Армии Краевой 31 17-300 Семятыче, Польша. Импортер и организация уполномоченная на принятие претензий в Республике Беларусь: СП Санта Импекс». Состав: картофель обжаренный (картофель, растительное масло) капуста брокколи, шампиньоны резаные, морковь, лук-порей, перец меланж. Продукт может содержать следы сельдерея. Штрихкод 4812787004456. Масса нетто одной потребительской единицы 400 г.
- не соответствует требованиям Технического регламента Таможенного союза «О безопасности пищевой продукции» (ТР ТС 021/2011); Гигиенического норматива «Показатели безопасности и безвредности для человека продовольственного сырья и пищевых продуктов», утвержденного постановлением Министерства здравоохранения Республики Беларусь от 25.01.2021 №37 по микробиологическим показателям: в 0,1 г обнаружены БГКП (коли-формы).

05.05.2023
В целях обеспечения санитарно-эпидемиологического благополучия населения и недопущения к реализации продукции, представляющей потенциальную опасность для здоровья людей, информируем, что лабораторным отделом Ошмянского районного ЦГЭ по результатам испытаний контрольного образца выявлена пищевая продукция, несоответствующая санитарно-эпидемиологическим и гигиеническим требованиям:
Изюм коричневый (без косточки «Офтоби»)

Изготовитель: СП ООО «ЕСО ORIENT GROUP», Узбекистан, Республика Узбекистан, Самаркандская обл., город Самарканд, поселок Фархад, Промышленная зона. Страна происхождения: Узбекистан. Импортер в Республику Беларусь: ООО «Фрутреал, 211401, Витебская обл., Полоцк, ул. Октябрьская, 25/1-6, ком. 17. Состав: виноград сушеный коричневый, растительное масло, диоксид серы Е220. Дата изготовления 20.12.2022, срок годности 20.12.2023, хранить при температуре от 5 0С до 20 0С и относительной влажности воздуха от 60% до 70%, масса нетто в картонном коробе 10 кг; продукция не соответствует по микробиологическим показателям: обнаружены плесени в количестве 3,0•103 КОЕ/г, при норме не более 5•102 КОЕ/г.
Информацию подготовила помощник врача-гигиениста Ошмянского районного ЦГЭ Семенова Антонина Викторовна
13.04.2023
За 1 квартал 2023 года по надзору за объектами торговли и общественного питания специалистами Ошмянского районного ЦГЭ проведено 15 мониторингов и 7 мероприятий технического, технологического (поверочного) характера (далее- МТТХ) в отношении 7 объектов 7 субъектов хозяйствования: отбор проб и образцов продукции на всех этапах ее обращения для проведения исследований в лабораториях системы Министерства здравоохранения, аккредитованных в порядке, установленном законодательством; изучение и оценка факторов среды обитания человека, в том числе с проведением лабораторных исследований. Надзорными мероприятиями охвачено 58 объектов, нарушения выявлены на 56 (принятые меры: выдано 2 предписания о приостановлении услуг; 17 предписаний о приостановлении (запрете) реализации товаров, работ (услуг); 17 предписаний об изъятии из обращения товаров; 7 предписаний об устранении нарушений; 30 рекомендаций об устранении нарушений, изъято 162,973 кг недоброкачественной продукции, 47 единиц и 42 пары непродовольственных товаров). За прошедший период к административной ответственности, привлечено 8 лиц, в том числе 1 юридическое.
Информацию подготовила помощник врача-гигиениста Ошмянского районного ЦГЭ Семенова Антонина Викторовна
12.04.2023
В целях обеспечения санитарно-эпидемиологического благополучия населения и недопущения к реализации пищевой продукции, представляющей потенциальную опасность для здоровья людей информируем:
Виноград сушеный (изюм) светлый

дата изготовления 29.11.2022, срок годности 29.11.2023, штриховой код 2000070001769, условия хранения – хранить при температуре от 5°С до +20°С и относительной влажности не более 70 %. Изготовитель: СП ООО «ECO ORIENT GROUP», Республика Узбекистан, Самаркандская область, г. Самарканд, посёлок Фархад, Промышленная зона. Импортёр в Республику Беларусь: ООО «Фрутреал», г. Полоцк, ул. Октябрьская, 25/1-6, комн. 17.
Не соответствует требованиям ТР ТС 021/2011, принятого Решением Комиссии Таможенного союза от 09.12.2011 № 880; ГН, утвержденного постановлением Совета Министров Республики Беларусь от 25.01.2021 № 37; Санитарных норм и правил, ГН, утвержденных Постановлением Министерства здравоохранения Республики Беларусь от 21.06.2013 № 52 по микробиологическому показателю.
Специи. Паприка сладкая молотая «Gurmina»

масса нетто 20 г, дата изготовления 03.2023 срок годности до 02.2025, штриховой код 4815477001056. Изготовитель: ООО «Гурмина-ПРО», Минская область, Дзержинский район, г. Фаниполь, ул. Брестская, д. 7, оф. 138, пом. 3. Место осуществления деятельности: Минская область, Дзержинский район, г. Фаниполь, ул. Заводская, д. 25.
Не соответствует требованиям ГН, утвержденного постановлением Совета Министров Республики Беларусь от 25.01.2021 № 37; Санитарных норм и правил,
ГН, утвержденных Постановлением Министерства здравоохранения Республики Беларусь от 21.06.2013 № 52 по микробиологическому показателю.
«Овощи для жарки с рисом и шампиньонами» быстрозамороженная торговой марки «RIKO» овощи быстрозамороженные и их смеси

дата изготовления 05.10.2022, годен до 04.10.2024, штриховой код 4680037273200, условия хранения – хранить при температуре не выше -18°С, при относительной влажности 95%. Изготовитель: ООО «ТрейдСервис», Россия, Московская область, Щелковский район, г. Щелково, ул. Заречная, д. 117. Поставщик в Республику Беларусь:ООО «Евроторг», г. Минск, 220099, ул. Казинца, 52А-22.
Не соответствует требованиям ТР ТС 021/2011, принятого Решением Комиссии Таможенного союза от 09.12.2011 № 880; ГН, утвержденного постановлением Совета Министров Республики Беларусь от 25.01.2021 № 37; Санитарных норм и правил, ГН, утвержденных Постановлением Министерства здравоохранения Республики Беларусь от 21.06.2013 № 52 по микробиологическому показателю.
Крупа рисовая «Рис круглозерный шлифованный» «Вясковы падворак», первый сорт

штриховой код 4812656001173, дата изготовления 14.04.2022, дата упаковки 14.01.2023, срок годности 12 месяцев от даты изготовления. Изготовитель: Полное товарищество «Абзал и Компания», Республика Казахстан, 120014, Кызылординская область, г. Кызылорда, ул. Марал Ишан, строение, 41. Поставщик в Республику Беларусь: ООО «Энерджи Групп», Минская область, 222730, Дзержинский район, Фанипольский с/с, 23-12. Упаковщик: Сервисное унитарное предприятие «ПакХаус», 220019, Минский район, Щомыслицкий с/с, ТЭЦ-4, каб. 212.
Не соответствует требованиям ГН, утвержденного постановлением Совета Министров Республики Беларусь от 25.01.2021 № 37 по органолептическим показателям.
Чай черный байховый индийский «Гита» в пакетиках для разовой заварки

ГОСТ 32573-2013, в потребительской упаковке, картонная коробка с защитной пленкой, масса нетто 60 г (30×2г), дата изготовления 09.2022, годен до 08.2025 М 15 24 124724, штриховой код 4605246003110. Изготовитель/упаковщик: ООО «ОРИМИ», Россия, 188682, Ленинградская область, Всеволожский район, г.п. им. Свердлова, мкр. 1-й, уч-к 15/4. Поставщики в Республику Беларусь: ООО «Тибетрэй», г. Минск, ул. Уручская, д. 11а, оф. 43; ООО «Альфа -Дистрибьюция», г. Минск, ул. Матусевича, д.20, пом. 12/1; УП КМА ПРОД-ТРЕЙД, г. Витебск, пер. 4-й Великолукский 18-1; ООО «Евроторг», г. Минск, 220099, ул. Казинца, 52А-22.
Не соответствует требованиям ТР ТС 021/2011, принятого Решением Комиссии Таможенного союза от 09.12.2011 № 880; ГН, утвержденного постановлением Совета Министров Республики Беларусь от 25.01.2021№ 37; ГН, утвержденных Постановлением Министерства здравоохранения Республики Беларусь от 21.06.2013 № 52 по микробиологическому показателю.
Кумкват обезвоженный консервированный с сахаром

дата изготовления 23.08.2021, годен до 23.08.2023. Изготовитель/ «Jinjiang Shijiang Foodstuffs Co., Ltd», No. 7 Jinyuan Road Wuli Industrial Area Jinjiang Fujian, Китайская Народная Республика. Импортёр в Республику Беларусь: ООО «Караван ХХI», Минский район, д. Королёв Стан, ул. Заречная, 14а, комн. 5.
Не соответствует требованиям ГН, утвержденного постановлением Совета Министров Республики Беларусь от 25.01.2021 № 37; ТР ТС 029/2012, принятого Решением Совета Евразийской экономической комиссии от 20.07.2012 № 58; ТР ТС 022/2011, утвержденного решением комиссии Таможенного союза от 09.12.2011 г № 881по маркировке
Информацию подготовила помощник врача-гигиениста Ошмянского районного ЦГЭ Михайлова Анна Сергеевна
11.04.2023
В ходе проведения надзорных мероприятий на объектах торговли, общественного питания специалисты центра гигиены и эпидемиологии продолжают выявлять нарушения санитарно-эпидемиологического законодательства.
Так, за первый квартал 2023 года мониторингом охвачено 32 объекта различной формы собственности. Нарушения установлены на всех обследованных объектах.
Основными нарушениями явились:
- обращение (реализация) пищевой продукции без наличия маркировки (с неполной маркировкой);
- неудовлетворительное санитарное состояние торгового, технологического, холодильного оборудования;
- обращение (реализация) продукции с истекшим сроком годности;
- не содержание в чистоте помещений;
- нарушение условий хранения и реализации пищевой продукции, обеспечивающих предотвращение ее порчи и защиту от загрязняющих веществ
Государственное учреждение «Ошмянский районный центр гигиены и эпидемиологии» в очередной раз доводит до сведения, что в соответствии со статьей 4.12 «Требования к способам доведения маркировки» технического регламента Таможенного союза ТР ТС 022/2011 «Пищевая продукция в части ее маркировки», где в пункте 5 указано, что при фасовании пищевой продукции организациями розничной торговли в отсутствии потребителя на потребительской упаковке или на прикрепленной к ней этикетке должны быть указаны наименование пищевой, дата ее изготовления, срок ее годности и условия хранения. Иные сведения, предусмотренные пунктом 1 части 4.1 и пунктом 13 части 4.4 настоящей статьи
Информацию подготовила помощник врача-гигиениста Ошмянского районного ЦГЭ Семенова Антонина Викторовна
07.04.2023
Сельскохозяйственные предприятия Ошмянщины активно готовятся к весенне-полевым работам, а именно положено начало в подготовке посадочного материала: начато протравливание семян, идет вывозка и внесение органических удобрений. Не остались в стороне и объекты, которые будут задействованы в питании лиц, занятых на сельскохозяйственных работах.
Помощник врача-гигиениста санитарно-эпидемиологического отдела Терешко Мария Станиславовна и помощник врача-гигиенста санитарно-эпидемиологического отдела Семенова Антонина Викторовна провели обучающий семинар для работников агропромышленного комплекса на котором особое
внимание было уделено контролю вопросов организации и качества питания участников весенних полевых работ, создания надлежащих условий для приема пищи, выполнению требований инструкции по охране труда при работе с пестицидами, минеральными удобрениями и консервантами.
Акцент был сделан на профилактике острых респираторных инфекций, острых кишечных инфекций, алкоголизма, увеличение в рационе питания овощей и фруктов.
В целях обеспечения санитарно-эпидемиологического благополучия населения и недопущения к реализации пищевой продукции, представляющей потенциальную опасность для здоровья людей информируем:
Манго сушеные ломтики (цукаты) с маркировкой «Белый пеликан»

масса нетто 500 г, в потребительской упаковкеиз полимерных материалов, изготовленный по ТУ РБ 100523831.001, дата изготовления 16.12.2021, упаковано 23.08.2022, годен до 23.05.2023, штриховой код 4811028004767, условия хранения – хранить при температуре не выше 30°С и относительной влажности не более 75%. Изготовитель: «JUNAN GUANGYUAN IMPORT AND EXPORT CO., LTD», INDUSTRY DEVELOPMENT ZONE, JUNAN SHANDONG,Китай. Адрес производства Минский район, Щомыслицкий с/с, строение 16/2. Импортёр/упаковщик в Республику Беларусь: ООО «Детави», 2-й Велосипедный пер., 32.
Не соответствует требованиям ТР ТС 021/2011, принятого Решением Комиссии Таможенного союза от 09.12.2011 № 880; ТР ТС 022/2011, утвержденного решением комиссии Таможенного союза от 09.12.2011 г № 881; ТР ТС 029/2012, принятого Решением Совета Евразийской экономической комиссии от 20.07.2012 № 58
по маркировке: в связи с отсутствием сведений на маркировке продукции о наличии в составе консерванта сорбиновая кислота, фактическое значение показателя «сорбиновая кислота» по результатам испытаний составляет 0,2776 г/кг.
Приправа хмели-сунели

масса нетто 30 г, дата изготовления 13.08.2022. годен до 09.2024, штриховой код 5900288171179, условия хранения – хранить в сухом прохладном месте. Изготовитель: Цикория С.А., Верхославицы, 15 Польша. Импортёр в Республику Беларусь: ООО «Авалонторг», г. Минск, пер. Липковский, 34, изолированное помещение № 2, комн. 52.
Не соответствует требованиям ГН, утвержденного постановлением Совета Министров Республики Беларусь от 25.01.2021 № 37 по микробиологическому показателю: обнаружено содержание плесени фактическое содержание плесени составило 2,5×103 КОЕ/г рои нормативе не более 2×102 КОЕ/г.
Рыбный кулинарный полуфабрикат в комплексной панировке (смесь сухой и жидкой панировок) обжаренный замороженныйхек Челийско - Перуанская мерлуза. Филе в панировке торговой марки 7 морей

изготовленный по СТО 88854483-002-2017, изготовлено и упаковано 15.06.2022, годен до 15.06.2023, смена № 4, штриховой код 4670012697107. Изготовитель: ООО «ПОЛАР СИФУД РАША», Российская Федерация, 249185, Калужская область, Жуковский район, г. Кременки, ул. Старые Кременки, д. 90. Поставщик в Республику БеларусьООО «Евроторг», г. Минск, 220099, ул. Казинца, 52А-22.
Не соответствует требованиям ГН, утвержденного постановлением Совета Министров Республики Беларусь от 25.01.2021 № 37 по микробиологическому показателю: обнаружены БГКП (колиформы): в 1,0 г, при нормируемом значении не допускается в 1,0 г.
Мексиканская смесь быстрозамороженная торговой марки GUSTO

дата изготовления 11.01.2023 17:01, годен до 11.01.2025, штриховой код 4813494022719. Изготовитель: OerlemansFoodsSiemiatyczeSp.z.o.o, ul. ArmiiKrajowej 31, 17-300Siemiatycze, Польша. Импортёр в Республику Беларусь:ООО «Евроторг», г. Минск, 220099, ул. Казинца, 52А-22.
Не соответствует требованиям ГН, утвержденного постановлением Совета Министров Республики Беларусь от 25.01.2021 № 37 по микробиологическому показателю: обнаружены БГКП (колиформы): в 0,1 г, при нормируемом значении не допускается в 0,1 г.
Виноград сушеный (изюм)

упакован по ТИ ВУ 690605560.006, дата изготовления 19.12.2022, дата упаковывания 08.02.2023, срок годности 19.12.2023, штриховой код 4813635006004. Изготовитель: ООО «SAMARKAND EXPORT FRUITS», Республика Узбекистан, Самаркандская область, Самаркандский район, село Даштисухта. Импортёр в Республику Беларусь:ООО «Евроторг»,г. Минск, 220099, ул. Казинца, 52А-22. Упаковщик: ООО «МАРКЕТ МАСТЕР», Минская область, г. Смолевичи, ул. Промышленная, д. 3, каб. 21.
Не соответствует требованиям ГН, утвержденного постановлением Совета Министров Республики Беларусь от 25.01.2021 № 37 по микробиологическому показателю: обнаружена плесень фактическое значение 3,5×103 КОЕ/г, при нормируемом значении не более 5×102 КОЕ/г; фактическое значение 4,0×103 КОЕ/г, при нормируемом значении не более 5×102 КОЕ/г.
Информацию подготовила помощник врача-гигиениста Ошмянского районного ЦГЭ Михайлова Анна Сергеевна
06.04.2023

Пищевая моль – вредитель продуктовых запасов, обитающий там, где есть свободный доступ к еде: крупам, хлебу, сухофруктам и т. д. Насекомое отличается устойчивостью ко многим инсектицидам и быстро размножается, поэтому борьба с ним может носить длительный характер.
Развитие яиц происходит от 4 дней до 3 недель – в зависимости от температуры воздуха. При комнатной температуре оно обычно составляет неделю. Гусеницы ведут скрытый образ жизни. В зависимости от вида они строят из паутинной нити, остатков пищи и экскрементов «портативные» чехлики или стационарные коконы; прокладывают ходы в питательном субстрате или на его поверхности. Перед линькой гусеницы перестают питаться, становятся очень активными и ищут укромные места, часто расползаясь на непищевые субстраты, стенки шкафов и т.п. Линяют личинки молей 6-8 раз за жизнь. Продолжительность развития одного поколения молей в условиях квартиры составляет от 40 до 300 суток – в зависимости от вида бабочки, количества и питательности пищи.
На складах и в предприятиях торговли с пищевой молью борются при помощи феромонных ловушек, заряженных аналогом веществ, выделяемых бабочкой для привлечения противоположного пола. При обнаружении в этих ловушках даже единичных особей, надо бить тревогу – ведь молодая моль приступает к размножению через несколько дней после выхода на свет. Такие ловушки разработаны для всех наиболее массовых видов пищевой моли – ведь убытки от этих вредителей могут быть огромны, от зерна и отрубей до шоколада и кофе – моль всеядна, прожорлива, в теплых помещениях размножается круглый год. Из выживших после дезинфицирующей обработки личинок моли выходят взрослые особи, которые откладывают яйца в новых местах.
Профилактические методы против пищевой моли

Информацию подготовила помощник врача-гигиениста Ошмянского районного ЦГЭ Михайлова Анна Сергеевна
01.04.2023
Санитарно-эпидемиологической службой Республики Беларусь осуществляется контроль (надзор) за деятельностью предприятий, осуществляющих реализацию пищевой продукции на соответствие установленным требованиям законодательства.
В ходе контрольных (надзорных) мероприятий выявлены нарушения требований санитарно-эпидемиологического законодательства, в том числе нарушения условий хранения и сроков годности пищевой продукции; отсутствие маркировочных ярлыков изготовителей, обеспечивающих прослеживаемость пищевой продукции; реализация продукции, не соответствующей требованиям технических регламентов.
Лабораториями центров гигиены и эпидемиологии в 2023 году исследовано более 1436 проб пищевой продукции. Несоответствие установленным требованиям выявлено
в 12,8 % проб – по микробиологическим показателям, 3,3 % – по санитарно-химическим и 26%– по другим показателям.
По результатам надзора не соответствующая установленным требованиям пищевая продукция изъята из оборота общей массой свыше 16 тонн, в том числе 2,3 тонны по причине отсутствия (несоответствия установленным требованиям) маркировки пищевой продукции, 7,6 тонны продукции с истекшим сроком годности. Следует отметить, что 2,5% от всех запрещенных небезопасных продуктов составили кондитерская, хлебобулочная и кулинарная продукция торговых объектов собственного производства. В 2022 году санитарно-эпидемиологической службой была запрещена реализация 762 тонны пищевой продукции, из которых более 4 тонн – это продукция собственного производства.
За выявленные нарушения по результатам надзорных мероприятий виновные лица привлечены к административной ответственности в соответствии с Кодексом РБ об административных правонарушениях.
Надзор за качеством и безопасностью пищевой продукцией, реализуемой предприятиями торговли, продолжается.
Санитарно-эпидемиологическая служба информирует: при приобретении пищевых продуктов, необходимо обращать внимание на ряд важных моментов, имеющих значение при покупке того или иного товара.
Изготовитель (продавец) обязан своевременно предоставить потребителю необходимую и достоверную информацию о пищевых продуктах для того, чтобы потребитель сделал правильный выбор.
Выбирая в магазине продукты питания необходимо обращать внимание на внешний вид продукта, срок его годности, условия хранения.
Упаковка является важной и неотъемлемой частью готовой продукции, обеспечивающей сохранность качества и безопасности пищевых продуктов. Если упаковка повреждена, невозможно определить дату изготовления и срок годности продукта, существует большая вероятность того, что Вы приобретете некачественный продукт, поэтому лучше его не покупать.
Особое внимание при покупке продуктов питания необходимо обращать на сроки их годности и условия хранения, указанные изготовителем на маркировке. Продажа товаров, срок годности которых истек, запрещается. Такие продукты признаются некачественными и опасными, не подлежат реализации, и должны быть утилизированы.
Государственное учреждение «Республиканский центр гигиены, эпидемиологии и общественного здоровья»
31.03.2023
В целях обеспечения санитарно-эпидемиологического благополучия населения и недопущения к реализации продукции, представляющей потенциальную опасность для здоровья людей информируем, что Ошмянским районным ЦГЭ по результатам испытаний лабораторного отдела Гродненского областного ЦГЭОЗ выявлена пищевая продукция, несоответствующая санитарно-эпидемиологическим и гигиеническим требованиям:
халва подсолнечная с какао

- дата изготовления 05.12.2022, срок годности 5 месяцев. Хранить при температуре не более (18 ± 3) 0С и относительной влажности воздуха не более 70%.
- Изготовитель: ООО «АгроПетро». Юридический адрес: 352102, Россия, Краснодарский край, Тихорецкий район, станица Терновская, ул. Западная, дом 53. Фактический адрес (адрес производства): 352102, Россия, Краснодарский край, Тихорецкий район, станица Терновская, ул. Западная, дом 53. Поставщик/ грузоотправитель: ООО «ОрионСвит», Республика Беларусь, 220073, г. Минск, ул.Бирюзова, д.10А, офис 703. Состав: ядро подсолнечника протертое, патока, сахар-песок, какао- порошок, экстракт мыльного корня, лимонная кислота, ванилин. ГОСТ 6502-2014, штрих код 46070413318208, масса нетто в упаковке 5 кг.
- Не соответствует требованиям технического регламента Таможенного союза 021/2011 «О безопасности пищевой продукции», утвержденного Решением Комиссии Таможенного союза от 09.12.2011 № 880; гигиеническому нормативу «Показатели безопасности и безвредности продовольственного сырья и пищевых продуктов», утвержденных постановлением Совета Министров Республики Беларусь от 25.01.2021 № 37 по микробиологическим показателям (обнаружены БГКП (колиформы) в 0,01 г.).

Информацию подготовила помощник врача-гигиениста Ошмянского районного ЦГЭ Михайлова Анна Сергеевна
01.03.2023

Главное правило, от которого зависит хорошее самочувствие зимой – это сбалансированное питание. В ежедневном меню обязательно должны присутствовать белки, жиры, углеводы, витамины, минералы и клетчатка, чтобы укрепить иммунную систему и противостоять вирусам и инфекциям.


В ежедневном меню обязательно должны присутствовать белки, жиры, углеводы, витамины, минералы и клетчатка, поэтому правильное питание зимой предполагает увеличение калорийности потребляемой пищи, но достигать этого необходимо за счет увеличения потребления блюд из рыбы, птицы, мяса. Необходимо помнить о полиненасыщенных жирных кислотах омега-3 и омега-6 присутствующих в орехах, жирной рыбе, растительном масле. Рыбу рекомендуется есть не менее двух-трёх раз в неделю. Помимо прочего, именно жирные сорта рыбы помогут восполнить дефицит витамина D. Нельзя забывать про молочные белки. Пусть кефир, ряженка, творог, молоко появляются чаще на вашем столе.
Зимой принципиальным вопросом является не только разнообразное и правильное питание, но и достаточного потребления жидкости. Конечно, в сравнении с летним сезоном, объемы потребляемой жидкости резко уменьшаются. Тем не менее суточная норма должна составлять минимум 1,5 литра питьевой воды.
Нельзя говорить о полноценном питании без включения в рацион овощей. Зимой выбирать их тоже нужно осмотрительно, с учётом основных потребностей организма.

- Чеснок — считается природным антибиотиком. Он не только снижает восприимчивость организма к различным инфекциям, но и помогает справиться с уже развившимся заболеванием.
- Лук — не только помогает бороться с болезнями, но и повышает сопротивляемость организма к простудным заболеваниям, а также способствует улучшению работы пищеварительного тракта. Зимой этот овощ обязательно должен входить в ваш рацион.
- Капуста — зимой её лучше употреблять в квашеном виде. Такое блюдо может заменить поливитаминный комплекс: в нём содержатся витамины А, С, К и группы В, а также рутин. К тому же, квашеная капуста содержит молочнокислые бактерии, необходимые для правильной работы кишечника.

- Чёрная редька — так же как и чеснок, она содержит фитонциды — вещества с противогрибковым и антибактериальным действием. Зимой её рекомендуется употреблять для укрепления иммунитета и повышения сопротивляемости организма инфекциям.

- Свёкла — помогает бороться с авитаминозом. Этот овощ также способствует увеличению в крови эритроцитов и улучшает общее состояние крови.
- Красный болгарский перец — содержит больше витамина С, чем любой другой овощ. Станет полезным и вкусным дополнением свежего салата.
Выбирая фрукты, следует обращать внимание на те, в которых содержится большое количество витамина С, способствующего укреплению защитных сил организма
- Цитрусовые (апельсины, мандарины) — доступный источник аскорбинки, хоть и не рекордсмен по её содержанию. Помимо этого, апельсины рекомендуют употреблять для нормализации работы кишечника и очищения печени.

- Авокадо — кроме витамина С, в этом фрукте содержатся ненасыщенные жирные кислоты. Приятный бонус: если вы будете есть авокадо, то заметите, что кожа зимой сохнет намного меньше.
- Айва — богата не только витаминами, но и многими микроэлементами. При регулярном употреблении этого фрукта можно не бояться зимнего авитаминоза.
- Гранат — содержит большое количество витамина С и фруктовых кислот. Основные полезные свойства — укрепление иммунитета, нормализация обмена веществ, укрепление стенок сосудов.
- Банан — в его состав входят витамины группы В, углеводы, калий, каротин. Этот очень калорийный фрукт полезен в период восстановления после болезни.

Специи и зелень помогут разнообразить вкус привычного блюда. Более того, эти ингредиенты надежные помощники в укреплении иммунитета и защитных сил организма, ведь они являются кладезем витаминов и полезных веществ. Перец, имбирь, кориандр, лук, чеснок, свежая зелень (петрушка, укроп, зеленый лук и различные виды салатов) богаты фитонцидами, которые помогают организму бороться с инфекциями. Поэтому зимой включайте их в меню.

Конечно, не стоит забывать и о других секретах здоровья в зимнее время. Хороший сон и физические нагрузки также должны войти в вашу жизнь, если вы хотите всегда оставаться бодрыми и здоровыми.
Санитарно- эпидемиологический отдел
07.02.2023
В целях обеспечения санитарно-эпидемиологического благополучия населения и недопущения к реализации пищевой продукции, представляющей потенциальную опасность для здоровья людей информируем:
- Чай чёрный байховый с ароматом тропических фруктов и растительными компонентами «ТЭСС ПЛЭЖА», дата изготовления 11.2022, годен до 10.2024, штриховой код 4605246005886, изготовитель ООО «ОРИМИ», Россия, Ленинградская область, Всеволожский район, пос. им. Свердллова, 1 мкр., уч-к 15/4, не соответствует по микробиологическому показателю (обнаружено содержание плесени).

- Изюм коричневый, упакован в картонный короб, масса нетто 10 кг, партия № 1, дата изготовления 05.09.2022, срок годности 12 месяцев с даты изготовления, изготовитель ООО «NASSAR TRADING AGRO», Республика Узбекистан, Самаркандская область, Пайарыкский район, Саноат, Дарвишик МФЙ, с. Дарвишик, не соответствует по микробиологическому показателю (обнаружено содержание плесени).

- Рыбные консервы — паштеты тонкоизмельченные стерилизованные из печени рыб. Печень трески атлантической по – мурмански, изготовленная по ТУ 22738723-001-2019, потребительская упаковка – металлическая банка, масса нетто 185 г, произведено из мороженого сырья, дата изготовления 16.12.2021, срок годности 24 месяца с даты изготовления, А33 Л32 1Р, штриховой код 4627201565013, изготовитель ООО «Владимирский консервный завод», Российская Федерация, 601240, Владимирская область, Собинский район, г. Лакинск, пр-т Ленина, дом 71, офис 10, не соответствует по органолептическим показателям (присутствует запах окислившегося жира и привкус горечи, несвойственные доброкачественному продукту).

- Вафли с жировой начинкой неглазированные со вкусом шоколада, массой 500 г, дата изготовления 18.12.2022, срок годности до 18.08.2023, изготовитель ООО «Сладонеж», Россия, 644105, г. Омск, ул. 22 Партсъезда, д. 51, не соответствуют по микробиологическому показателю (обнаружены дрожжи).

Информацию подготовила помощник врача-гигиениста Ошмянского районного ЦГЭ Михайлова Анна Сергеевна
07.02.2023
В целях обеспечения санитарно-эпидемиологического благополучия населения и недопущения к реализации продукции, представляющей потенциальную опасность для здоровья людей информируем, что Ошмянским районным ЦГЭ по результатам испытаний лабораторного отдела Сморгонского зонального ЦГЭ выявлена пищевая продукция, несоответствующая санитарно-эпидемиологическим требованиям:
Соль поваренная пищевая самосадочная йодированная. Первый сорт с маркировкой «Ассоль»

- СТ РК ГОСТ Р51574-2003
- Производитель: ТОО «Алтын Орда», 120005, Республика Казахстан, г. Казылорда, ул. Бейбитшилик, №58.
- Поставщик в Республику Беларусь/организация, принимающая претензии по качеству: ООО «БерталСервис», Республика Беларусь, 220013, г. Минск, ул. Сурганова, д.43, пом. 40-1, каб. т 902; ООО «Альфа Бакалея», Республика Беларусь, 222203, Минская обл., г. Смолевичи, ул. Социалистическая, д. 32-6, каб. 74.
- Штриховой код 4870007640013. Условия хранения: хранить в сухом, темном месте. Избегайте попадания прямых солнечных лучей.
- Дата изготовления 31.05.2022, срок годности 12 месяцев. Масса нетто 1 кг. в упаковке;
- не соответствует требованиям Гигиенических нормативов «Показатели безопасности и безвредности для человека продовольственного сырья и пищевых продуктов», утвержденные постановлением Министерства здравоохранения Республики Беларусь от 25.01.2021 №37, по содержанию йода (фактическое значение показателя составило менее 0,02 мг/г при нормируемом значении показателя по ТНПА 0,04±0,015 мг/г).
Информацию подготовила помощник врача-гигиениста Ошмянского районного ЦГЭ Михайлова Анна Сергеевна
25.01.2023

Санитарно-эпидемиологической службой продолжаются надзорные мероприятия по недопущению поступления некачественной и небезопасной пищевой продукции на внутренний рынок страны. По результатам испытаний выявлена пищевая продукция, несоответствующая санитарно-эпидемиологическим требованиям:
Консервы рыбные в томатном соусе
- изготовлено по ТУ 10.20.25.-001-00101652-2019
- масса нетто 240 г
- упаковка потребительская — жестяная банка, дата изготовления 10.03.2022
- срок годности не более 24 месяцев с даты изготовления
- штриховой код 4612729498394
- изготовитель ООО «Фортуна Крым», Россия, 295000, Республика Крым, г. Симферополь, ул. Карла Маркса, д. 14/9, лит. Ц, пом. 81
- не соответствует по маркировке (в результате проведенных испытаний в составе рыбных консервов обнаружен незаявленный изготовителем на маркировке консервант: бензойная кислота).
Информацию подготовила помощник врача-гигиениста Ошмянского районного ЦГЭ Михайлова Анна Сергеевна
12.01.2023
В целях обеспечения санитарно-эпидемиологического благополучия населения и недопущения к реализации продукции, представляющей потенциальную опасность для здоровья людей Ошмянский районный ЦГЭ информирует, что лабораторным отделом Гродненского областного ЦГЭОЗ по результатам испытаний контрольного образца выявлена пищевая продукция, несоответствующая санитарно-эпидемиологическим и гигиеническим требованиям:
Арахис в кокосовой глазури

Изготовитель: ООО "БЕСТФУД", 117405, Россия, г. Москва, ул.Дорожная, дом 60Б, офис 305. Производство расположено по адресу: 249962, Россия, Калужская обл, Медынский р-н, с Кременское, дом 125. Импортеры/ поставщики в РБ: ООО «ЛенПродуктСервис», 220099, г. Минск, ул. Казинца, 11а, оф. А 506;ООО «МосПродуктСервис», 224022, г.Брест, ул.Карьерная, д.12, корп.1В; ООО «ВитебскПродуктСервис», 210015, г. Витебск, ул. проспект Московский, дом 53, пом. №4; ООО «ГомельПродуктСервис», 246007, г. Гомель, ул. Федюнинского, д.17, каб. 4-6. Штрих код 4630035655638, ТУ 9122 – 004 - 87521549 – 2015. Состав: арахис, сахар, мука пшеничная, масло растительное, ароматизатор кокоса, краситель пищевой тартразин. Дата изготовления 16.10.2022 срок годности 12 месяцев с даты изготовления. Хранить при температуре не более + 18 0С и относительной влажности воздуха не более 70%, масса нетто в упаковке 1000 г. - не соответствует по маркировке в части предоставления достоверной информации о составе продукта: в состав арахиса «кокосовой» глазури, входит, обнаруженная в результате проведенных испытаний, незаявленная изготовителем на маркировке, пищевая добавка краситель «Солнечный закат» FCF (Е110).
Информацию подготовила помощник врача-гигиениста Ошмянского районного ЦГЭ Михайлова Анна Сергеевна
02.12.2022
В целях обеспечения санитарно-эпидемиологического благополучия населения и недопущения к реализации пищевой продукции, представляющей потенциальную опасность для здоровья людей информируем:
Пресервы: сельдь атлантическая филе слабосоленая в масле с укропом

в потребительской упаковке, СТО 15167786-004-2017, масса нетто 250 г, дата изготовления 17.08.2022, годен до 17.12.2022, условия хранения – хранить при температуре от минус 2°С до +4С штриховой код 4607010731434. Изготовитель: ООО «ТД «БАЛТИЙСКИЙ БЕРЕГ», Россия, 195009, г. Санкт-Петербург, ул. Минеральная, д. 29, корп. 2, литер А. Поставщик в Республику Беларусь: ЗАО «Юнифуд», г. Минск, 220136, ул. Притыцкого, 93, 4 этаж, офис 11. Не соответствует требованиям ГН, утв. постановлением Совета Министров Республики Беларусь от 25.01.2021 № 37;ТР ТС 021/2011, принятого Решением Комиссии Таможенного союза от 09.12.2011 № 880; ТР ЕАЭС 040/2016, принятого Решением Совета Евразийской экономической комиссии от 18.10.2016 № 162 по микробиологическим показателям.
Грузинские специи. Приправа «Хмели сунели»

в полимерном пакете массой по 30 г, дата изготовления 12.01.2022, срок годности 2 года, условия хранения: хранить при температуре не выше 20°С и относительной влажности не более 75 %. Изготовитель: Республика Грузия «Georgian Export Group» LTD, Цхалтубский район, д. Квитири. Импортёр в Республику Беларусь: ООО «ПрофОптСнаб», г. Минск, 220100, ул. Сурганова, д. 57 Б офис 155. Не соответствуют требованиям ГН, утв. постановлением Совета Министров Республики Беларусь от 25.01.2021 № 37; СанПин, ГН, утвержденных Постановлением Министерства здравоохранения Республики Беларусь от 21.06.2013 № 52; ТР ТС 021/2011, принятого Решением Комиссии Таможенного союза от 09.12.2011 № 880 по микробиологическим показателям.
Папайя сушеная Olmish Premium

дата изготовления 01.03.2022, срок годности 12 месяцев, штриховой код 8938533410077, условия хранения – хранить при температуре от 0°С до +21°С и относительной влажности не более 75 %, открытую упаковку хранить в холодильнике в течении 10 дней. Изготовитель: OLMISH ASIA FOOD COMPAN Y LIMITED, Въетнам КханьХоа провинция, г. Нячанг Фыонг Шай район, ул. Ерсин, д. 62. Импортёр в Республику Беларусь: ООО «ФортунаЛогистик»г. Гомель, пр-т Победы, 5А-1. Не соответствуют требованиям СанПин, ГН, утвержденных Постановлением Министерства здравоохранения Республики Беларусь от 21.06.2013 № 52; ТР ТС 022/2011, утвержденного решением комиссии Таможенного союза от 09.12.2011 г № 881; ТР ТС 029/2012, утвержденного решением Совета Евразийской экономической комиссии от 20.07.2012 г № 58; СанПин ГН, утв. постановлением Министерства здравоохранения Республики Беларусь 12.12.2012 № 195 по маркировке.
Информацию подготовила помощник врача-гигиениста Ошмянского районного ЦГЭ Михайлова Анна Сергеевна
22.11.2022
В целях обеспечения санитарно-эпидемиологического благополучия населения и недопущения к реализации пищевой продукции, представляющей потенциальную опасность для здоровья людей информируем:
Фисташки жареные солёные массой 300 г, с маркировкой «КОПЕЕЧКА»

Изготовлено по СТО 99180786-002-2014, дата изготовления 03.07.2022г, упаковано (расфасовано) 16.08.2022г., срок годности 12 месяцев, условия хранения: хранить при температуре не выше 250С и относительной влажности не более 75%, штриховой код 4815800004617. Изготовитель: ООО «Деловое партнерство», Российская Федерация, 142153, Московская область, Городской округ Подольск, д. Матвеевское, ул. Оборонная, д.6. Поставщик в Республику Беларусь: ЗАО «Доброном», г. Минск, 220112, ул. Янки Лучины, 5. Не соответствуют требованиям ГН, утв. постановлением Совета Министров Республики Беларусь от 25.01.2021 № 37; СанПин, ГН, утвержденных Постановлением Министерства здравоохранения Республики Беларусь от 21.06.2013 № 52; ТР ТС 021/2011, принятого Решением Комиссии Таможенного союза от 09.12.2011 № 880 по микробиологическому показателю.
Ананас (кубики микс 6-12 мм)

Плоды и съедобные части растений, приготовленные (подсушенные) методом осмотического обезвоживания с содержанием сахара (цукаты) весовые, упакованные в пакеты из полимерных материалов, дата изготовления 08.2021, годен до: 02.2023, хранить в закрытых, вентилируемых и обеззараженных помещениях, с соблюдением санитарных норм и правил, при температуре не выше +25°С и относительной влажности воздуха не более 75%. Изготовитель: GCF International Co., LTD., 222/1 Soi Thana Tower, Jarunsanitwong Rd., Bangyikhan, Bangplad, Bangkok, 10700, Thailand, Таиланд. Импортер в Республику Беларусь: ООО «МАСТЕРФУД», Российская Федерация, 117587, г. Москва, ул. Днепропетровская, д.2, этаж 3, пом. XVII, комн. № 42. Не соответствуют требованиям ТР ТС 029/2012, утвержденного решением Совета Евразийской экономической комиссии от 20.07.2012 г № 58 по физико-химическому показателю.
Сливы сушеные без косточки (чернослив)

масса нетто 10,0 кг, масса брутто 10.45 кг, дата производства 28.07.2022, срок годности 28.07.2023, условия хранения - хранить в чистых сухих, без постороннего запаха, не зараженных вредителями хлебных запасов хранилищах в соответствии санитарных правил и порядка хранения. Хранить при температуре от 50С до 200С и относительной влажности воздуха не более 70% на складах с соблюдением санитарных правил. Изготовитель: ООО «SAMARKAND EXPORT FRUITS», Республика Узбекистан, Самаркандская область, Самаркандский район, село Дашти сухта. Импортер в Республику Беларусь: ООО «ЕВРОТОРГ», г. Минск, 220099, ул. Казинца 52А-22. Не соответствуют требованиям ТР ТС 029/2012, утвержденного решением Совета Евразийской экономической комиссии от 20.07.2012 г № 58; СанПин ГН, утв. постановлением Министерства здравоохранения Республики Беларусь 12.12.2012 № 195; ГН, утв. постановлением Совета Министров Республики Беларусь от 25.01.2021 № 37 по маркировке.
Информацию подготовила помощник врача-гигиениста Ошмянского районного ЦГЭ Михайлова Анна Сергеевна
18.11.2022
В целях обеспечения санитарно-эпидемиологического благополучия населения и недопущения к реализации пищевой продукции, представляющей потенциальную опасность для здоровья людей информируем:
Курага индустриальная

изготовлено по ТУ ВУ 690269922.002, масса нетто 200 г, дата изготовления 01.2022, дата упаковывания 09.02.2022, годен до 01.01.2023, штриховой код 4810948007322, изготовитель ООО «СУБХИВАТАН», Республика Таджикистан, Согдийская область, 735920, г. Исфара, ул. Хонобад, не соответствует по показателю «сернистая кислота».
Ананасы цукаты (кубики Микс 8-10 мм)

торговой марки «Добрая ежа», упаковка – пакет из полипропилена, масса нетто 0,5 кг, дата изготовления 02.2022, дата фасования 11.07.2022, срок годности 18 месяцев с даты изготовления, штриховой код 4813299000066, изготовитель «GCF-International Co., LTD 222/1 Sol Thana Tower Jarunsanitwong Rd Bangykhan Bangpiad, Bangkok», 10700, Таиланд, не соответствует по показателю диоксид серы.
Пищевая рыбная продукция холодного копчения. Скумбрия атлантическая кусочки холодного копчения «БАРСКАЯ»

изготовлена по ТУ ВY 691435866, масса нетто 300 г, дата изготовления 03.10.2022, срок годности 60 суток. Не соответствует требованиям ГН, утвержденного постановлением Совета Министров Республики Беларусь от 25.01.2021 № 37; СанПин и ГН, утв. постановлением Министерства здравоохранения Республики Беларусь от 21.06.2013 № 52; ТР ТС 040/2016, принятого Решением Совета Евразийской экономической комиссии от 18.10.2016 № 162 по органолептическим показателям.
Виноград сушеный коричневый

упакован в картонную коробку массой 11 кг, дата изготовления 04.2022, годен до 04.2023, условия хранения – хранить при температуре не выше + 20°С и относительной влажности не более 70 % в местах, защищенных от прямых солнечных лучей, в чистых и хорошо вентилируемых складских помещениях. Изготовитель: СП ООО «SIROJIDDIN AGRO FRUITS», Республика Узбекистан, Самаркандская область, Ургутский район, село Карабулак. Импортер в Республику Беларусь ООО «Ореховград», г. Минск, 220138, ул. Карвата, д. 69, каб. 11. Не соответствует требованиям ГН, утвержденного постановлением Совета Министров Республики Беларусь от 25.01.2021№ 37; ГН, утв. постановлением Министерства здравоохранения Республики Беларусь от 21.06.2013 № 52; ТР ТС 021/2011, принятого Решением Комиссии Таможенного союза от 09.12.2011 № 880 по микробиологическому показателю.
Приправа пряный Хмели - сунели. Приправы сухие

изготовлен по ТУ ВY 192340348.001-2017, дата изготовления 06.2022, годен до конца 04.2024, штриховой код 4815477005641, условия хранения: хранить при температуре не выше 20°С и относительной влажности не более 75 %. Изготовитель: ООО «Гурмина -ПРО», Республика Минская область, 222750, Дзержинский район, г. Фаниполь, ул. Брестская, д. 7, оф. 138, адрес производства Минская область, 222750, Дзержинский район, г. Фаниполь, ул. Заводская, 25. Не соответствует требованиям ГН, утвержденного постановлением Совета Министров Республики Беларусь от 25.01.2021 № 37; СанПин и ГН, утв. постановлением Министерства здравоохранения Республики Беларусь от 21.06.2013 № 52 по микробиологическим показателям.
Полуфабрикат рубленый из мяса цыплят-бройлеров Фарш Элитный из филе» замороженный

изготовлено по ТУ ВY 100039571.030, дата изготовления и упаковывания 28.09.2022, годен до 27.03.2023, срок годности с даты изготовления при соблюдении условий хранения при температуре не выше минус 18°С в течение 180 суток, штриховой код 4811319012303. Изготовитель: ООО «Витконпродукт», г. Витебск, 210026, ул. Горовца, 6, к. 1, адрес производства ООО «Витконпродукт», цех убоя птицы «Шумилино», Витебская область, 211259, Витебская область, г.п. Шумилино, ул. Ленинская, 76. Не соответствует требованиям СанПин и ГН утвержденных постановлением Министерства здравоохранения Республики Беларусь от 21.06.2012 № 52;ГН, утвержденного постановлением Совета Министров Республики Беларусь от 25.01.2021 № 37; ТР ТС 021/2011, принятого Решением Комиссии Таможенного союза от 09.12.2011 № 880 по микробиологическому
показателю.
Полуфабрикат из мяса цыплят-бройлеров замороженный «Стейк Любительский люкс»

изготовлено по ТУ ВY 100039571.018, дата изготовления и упаковывания 14.10.2022, срок годности с даты изготовления при соблюдении условий транспортирования и хранения: при температуре не выше минус 12°С в течение 3 месяцев. Изготовитель: ООО «Витконпродукт», г. Витебск, 210026, ул. Горовца, 6, к. 1, адрес производства ООО «Витконпродукт», цех убоя птицы «Шумилино», Витебская область, 211259, Витебская область, г.п. Шумилино, ул. Ленинская, 76. Не соответствует требованиям СанПин и ГН утвержденных постановлением Министерства здравоохранения Республики Беларусь от 21.06.2012 № 52; ГН, утвержденного постановлением Совета Министров Республики Беларусь от 25.01.2021 № 37; ТР ТС 021/2011, принятого Решением Комиссии Таможенного союза от 09.12.2011 № 880 микробиологическому показателю
Информацию подготовила помощник врача-гигиениста Ошмянского районного ЦГЭ Михайлова Анна Сергеевна
09.11.2022
В целях обеспечения санитарно-эпидемиологического благополучия населения и недопущения к реализации пищевой продукции, представляющей потенциальную опасность для здоровья людей информируем:
Финики с косточкой «Мазафати» торговой марки KARIM

дата изготовления 24.02.2022, срок годности 24.02.2024, хранить при температуре от 0°С до +10°С при относительной влажности до 75 % . Изготовитель: «Толиди Базаргани Белок Теджарат Тав», Иран, г. Тегеран, Аббасаббад, ул. Делара, ул. Шахид Роохоллад Ебади, дом 15, эт. 2, кв. 4. Импортер в Республику Беларусь: ООО «Удача и успех плюс», г. Минск, 220140, ул. Лещинского, д. 31/1, пом. 83а, к. 7. Не соответствует требованиям СанПин и ГН утвержденных постановлением Министерства здравоохранения Республики Беларусь от 21.06.2012 № 52; ГН, утвержденного постановлением Совета Министров Республики Беларусь от 25.01.2021 № 37;ТР ТС 021/2011, принятого Решением Комиссии Таможенного союза от 09.12.2011 № 880 по микробиологическому показателю.
Печень трески по – мурмански. Атлантической(тонкоизмель-чённая)

Акватория, в потребительской упаковке – жестяная банка, на которой имеется бумажная этикетка «Владкон», Российская Федерация, Владимирская область, Собинский район, г. Лакинск, пр-т Ленина, д. 71, офис 10. Поставщик в Республику Беларусь: ООО «Дисконт фиш», Минская область, 222161, г. Жодино, ул. Кузнечная, д. 16, комн. 4/7. Не соответствует требованиям ТР ЕАЭС 040/2016, принятого Решением Совета Евразийской экономической комиссии от 18.10.2016 № 162 по органолептическим показателям.
Полуфабрикат рубленый из мяса цыплят – бройлеров формованный колбаса «Смачная» охлаждённый

изготовлено по ТУ ВУ 192819069.001-2020,дата изготовления 21.10.2022 18:00, срок годности 28.10.2022 18:00. Изготовитель: ЗАО «Доброном», кулинарный цех № 554, г. Марьина Горка, ул. Новая заря, 34. Не соответствует требованиям СанПин и ГН утвержденных постановлением Министерства здравоохранения Республики Беларусь от 21.06.2012 № 52; ГН, утвержденного постановлением Совета Министров Республики Беларусь от 25.01.2021 № 37; по органолептическим показателям.
Зефир «Eco Botanica» с кусочками брусники

растительным экстрактом и витаминами, в потребительской заводской упаковке, масса нетто 250 г, штриховой код 4605516020113, дата изготовления 27.05.2022, годен до 23.11.2022, условия хранения -хранить при температуре от 15 до 21℃ и относительной влажности не более 75%. Изготовитель: ОАО «РотФронт», Россия, г. Москва, 115184, 2-й Новокузнецкий пер., д. 13/15. Импортер в Республику Беларусь: ООО «Евроторг», г. Минск, 220099, ул. Казинца, 52а-22. Не соответствует требованиям ТР ТС 029/2012, утвержденного решением Совета Евразийской экономической комиссии от 20.07.2012 г № 58; ГН, утв. постановлением Совета Министров Республики Беларусь от 25.01.2021 № 37; Санитарных норм и правил, ГН, утв. постановлением Министерства здравоохранения Республики Беларусь 12.12.2012 № 195 по маркировке.
Приправа пряный Хмели-сунели

изготовлено ТУ ВУ 192340348.001-2017, дата изготовления 06.2022, годен до 04.2024, штриховой код 4815477005641, условия хранения – хранить при температуре не выше 20°С и относительной влажности не более 75 %. Изготовитель: ООО «Гурмина-ПРО», Минская область, 222750, Дзержинский район, г. Фаниполь, ул. Брестская, д. 7, оф. 13, адрес производства Минская область, Дзержинский район, г. Фаниполь, ул. Заводская, 25. Не соответствует требованиям СанПин и ГН утвержденных постановлением Министерства здравоохранения Республики Беларусь от 21.06.2012 № 52; ГН, утвержденного постановлением Совета Министров Республики Беларусь от 25.01.2021 № 37 по микробиологическим показателям.
Информацию подготовила помощник врача-гигиениста Ошмянского районного ЦГЭ Михайлова Анна Сергеевна
02.11.2022
В целях обеспечения санитарно-эпидемиологического благополучия населения и недопущения к реализации пищевой продукции, представляющей потенциальную опасность для здоровья людей информируем:
Полуфабрикат в тесте с мясосодержащей начинкой категории «Г» замороженный, манты «Восточные»

дата изготовления 24.06.2022, срок годности 6 месяцев, годен до 24.12.2022, штриховой код 4812787011119, номер партии 5689; продукт до и после вскрытия упаковки хранить при температуре не выше минус 18°С, размороженный продукт повторно не замораживать. Изготовитель:
ООО ПЭП «ЭЛИКА», Россия, 142530, Московская область, г. Электрогорск, пр. Мечникова, д. 2. Импортёр в Республику Беларусь СП «Санта Импэкс Брест» ООО, Брест, 224004, ул. Катин Бор, 106. Не соответствует требованиям ГН, утв. постановлением Совета Министров Республики Беларусь от 25.01.2021 № 37; ТР ТС 021/2011, принятого Решением Комиссии Таможенного союза от 09.12.2011 № 880 по микробиологическому показателю.
Рыбные консервы. Килька черноморская неразделанная в томатном соусе стерилизованная

изготовлена по ТУ 10.20.25-001-00101652-2019, масса нетто 240 г, дата изготовления 04.04.2022, срок годности и хранения 24 месяца с даты изготовления, штриховой код 4612756511998, условия хранения – хранить при температуре от 0°С до 20°С и относительной влажности воздуха не более 75%. После вскрытия банки продукт хранить в холодильнике не более 24 часов. Изготовитель: ООО «Фортуна Крым», Россия, 295000, Республика Крым, г. Симферополь, ул. Карла Маркса, 14/9, лит. «Ц», пом. 81, адрес производства Россия, 297570, Республика Крым, Симферопольский район, с. Фонтаны, ул. Озенбашская, д. 4. Поставщик в Республику Беларусь ООО «Фудлогистик», г. Минск, 4-й пер. Кольцова А.В., д. 53, пом. 1, каб. 30. Не соответствует требованиям
ТР ТС 021/2011, принятого Решением Комиссии Таможенного союза от 09.12.2011 № 880; ТР ТС 022/2011, утвержденного решением комиссии Таможенного союза от 09.12.2011 г № 881 по маркировке.
Информацию подготовила помощник врача-гигиениста Ошмянского районного ЦГЭ Михайлова Анна Сергеевна
25.10.2022
В целях обеспечения санитарно-эпидемиологического благополучия населения и недопущения к реализации пищевой продукции, представляющей потенциальную опасность для здоровья людей информируем:
Манго сушеное «Olmish» Premium, урожай 2021 года

дата изготовления 01.03.2022, срок годности до 01.03.2023, штриховой код 8938533410138, условия хранения – хранить при температуре от 0°С до 20°С и относительной влажности не более 75 %, открытую упаковку хранить в холодильнике в течении 10 дней. Изготовитель: OLMISHA SIA FOOD COMPANY LIMITED, Въетнам, провинция Кханьхоа, г. Нячанг Фыонг Шай, район ул. Ерсин, д. 62. Импортер в Республику Беларусь ООО «ФортунаЛогистик», г. Гомель, пр-т Победы, 5А-1. Не соответствует требованиям ТР ТС 029/2012, утвержденного решением Совета Евразийской экономической комиссии от 20.07.2012 г № 58; Санитарных норм и правил, ГН, утв. постановлением Министерства здравоохранения Республики Беларусь 12.12.2012 № 195 по маркировке
Дыня свежая сорт «Торпеда»

урожай 2022, дата упаковывания 15.09.2022, срок годности с даты упаковывания 30 суток, условия хранения - хранить при температуре от 4°С до 6°С и относительной влажности 85-95%. Изготовитель: ТОО «Азия грин фудс трейд», Республика Казахстан, 160900, Туркестанская область, Сарыагашский р-н, г. Сарыагаш, ул. Т. Токтарова, 5, КБе 17. Импортер в Республику Беларусь: ООО "Фрутреал", 211401, г. Полоцк, ул. Октябрьская, 25\1-6. Не соответствует требованиям ТР ТС 021/2011, принятого Решением Комиссии Таможенного союза от 09.12.2011 № 880; ГН, утвержденного постановлением Совета Министров Республики Беларусь от 25.01.2021 № 37 по физико-химическому показателю «содержание нитратов
Изюм (виноград сушёный желтый)

масса 200 г, штриховой код 4810948007308, изготовлено по ТУ ВУ 690269922.002, дата изготовления 07.2022, дата упаковывания 19.08.2022, годен до 01.07.2023. Условия хранения: хранить при температуре не выше + 25 С, относительной влажности не более 75% Ургутский район, село Кара Булок, Импортер в Республику Беларусь/ поставщик (упаковщик): ЧПТУП «Шалу» 223021, Минская область, Минский район, Щомыслицкий с/с, аг. Озерцо, ул. Центральная, д. 35А, пом.25. Адрес места осуществления деятельности по упаковыванию продукции: 222850, Минская область, Пуховичский район, Руденский поселковый Совет,1. Не соответствует требованиям СанПин и ГН утвержденных постановлением Министерства здравоохранения Республики Беларусь от 21.06.2012 № 52; ГН, утвержденного постановлением Совета Министров Республики Беларусь от 25.01.2021 № 37 по по микробиологическим показателям:
Кабачки свежие

ГОСТ 31822-2012, урожай 2022 г., дата упаковывания 29.09.2022, срок годности 15 суток с даты упаковывания, температура хранения от +8 °C до +10 °C, относительная влажность воздуха 90-95 % Изготовитель: ООО «Бахчевод», 403459, Волгоградская обл., Серафимовичский район, хутор Клетско-Почтовский, Россия. Продавец: ООО Агро 24, 214004, Смоленская обл., г. Смоленск, 1-й Пригородный переулок, дом 4, оф. 18, Россия. Импортер в Республику Беларусь: ООО "Фрутреал", 211401, г. Полоцк, ул. Октябрьская, 25\1-6. Не соответствует требованиям СанПин и ГН утвержденных постановлением Министерства здравоохранения Республики Беларусь от 21.06.2012 № 52; ГН, утвержденного постановлением Совета Министров Республики Беларусь от 25.01.2021 № 37; ТР ТС 021/2011, принятого Решением Комиссии Таможенного союза от 09.12.2011 № 880 по физико-химическому показателю «содержание нитратов»
Рыбные консервы стерилизованные. Консервы из печени трески по-Мурмански от Иваныча

масса 230 г, изготовлено по ГОСТ 13272-2009, дата изготовления 09.11.2021, срок годности 24 месяца, штриховой код 4612756511363объем 18,9 л, дата розлива 19.09.2022, срок годности до 19.09.2023, срок годности после вскрытия до 24.09.2022, номер партии № 137/22. Изготовитель: унитарное предприятие «ОВВИ ГО» (юридический адрес: Республика Беларусь, Минская область, г. Дзержинск, ул. Лермонтова, 10а). Не соответствует требованиям СанПин и ГН, утвержденным постановлением Министерства здравоохранения Республики Беларусь от 15.12.2015 № 123 по микробиологическим показателям. Изготовитель: ООО «Дэма», Российская Федерация, г. Мурманск, ул. Промышленная, 10 г. Поставщик в Республику Беларусь: ООО «РольфТрэйд», г. Могилёв, ул. Мовчанского, д. 53, офис 1. Не соответствует требованиям СанПин и ГН утвержденных постановлением Министерства здравоохранения Республики Беларусь от 21.06.2012 № 52; ТР ЕАЭС 040/2016, принятого Решением Совета Евразийской экономической комиссии от 18.10.2016 № 162 по органолептическим показателям
Информацию подготовила помощник врача-гигиениста Ошмянского районного ЦГЭ Михайлова Анна Сергеевна
21.10.2022
В целях обеспечения санитарно-эпидемиологического благополучия населения и недопущения к реализации пищевой продукции, представляющей потенциальную опасность для здоровья людей информируем:
Смесь пряностей без соли «Хмели-сунели», торговой марки «Готовим вместе»
изготовлена по ТУ РБ 192340348.001-2017, масса нетто 25 г, дата изготовления 09.2022, годен до конца 08.2024,штриховой код 4815477003258. Изготовитель: ООО «Гурмина –ПРО», Минская область, 222750, Дзержинский район, г. Фаниполь, ул. Брестская, д. 7,оф. 138, пом. 3,адрес производства Минская область, 222750, Дзержинский район, г. Фаниполь, ул. Заводская, 25.
Не соответствует требованиямГН, утв. постановлением Совета Министров Республики Беларусь от 25.01.2021 № 37;СанПин и ГН, утв. постановлением Министерства здравоохранения Республики Беларусь от 21.06.2013 № 52;ТР ТС 021/2011, принятого Решением Комиссии Таможенного союза от 09.12.2011 № 880 по микробиологическому показателю:
Свекла свежая

урожай 2022 г. дата упаковывания: 01.09.2022, срок годности: 5 мес. с даты упаковывания, условия хранения: от 00С до +10С и относительной влажности воздуха от 90% до 95%. Изготовитель: КФХ «ВикторияАгроОвощ», Республика Беларусь, Гродненская обл., Берестовицкий район, аг. Олекшицы. Не соответствует требованиям ТР ТС 021/2011, принятого Решением Комиссии Таможенного союза от 09.12.2011 № 880 по физико-химическому показателю.
Соленая пищевая рыбная продукция.
Форель радужная филе-кусок с кожей слабосоленая «Классическая» охлажденная
изготовлено по ТУ BY 101267807.022, партия номер 236/03/09, дата изготовления 03.09.2022, годен до 02.11.2022, штриховой код 4811527001915, масса нетто 150 г, хранить при температуре от минус 2ºС до плюс 5ºС. Изготовитель Общество с ограниченной ответственностью «Белвнешрыбторг» Минская обл.., Минский район, аг. Новоселье, ул. Промысловая, 5. Не соответствует требованиям СанПин, ГН, утвержденных Постановлением Министерства здравоохранения Республики Беларусь от 21.06.2013 № 52; ГН, утв. постановлением Совета Министров Республики Беларусь от 25.01.2021 № 37; ТР ЕАЭС 040/2016, принятого Решением Совета Евразийской экономической комиссии от 18.10.2016 № 162; ТР ТС 021/2011, принятого Решением Комиссии Таможенного союза от 09.12.2011 № 880 по микробиологическому показателю.
Вода питьевая негазированная «Графская лайт»
объем 18,9 л, дата розлива 19.09.2022, срок годности до 19.09.2023, срок годности после вскрытия до 24.09.2022, номер партии № 137/22. Изготовитель: унитарное предприятие «ОВВИ ГО» (юридический адрес: Республика Беларусь, Минская область, г. Дзержинск, ул. Лермонтова, 10а). Не соответствует требованиям СанПин и ГН, утвержденным постановлением Министерства здравоохранения Республики Беларусь от 15.12.2015 № 123 по микробиологическим показателям.
Арахис в хрустящей корочке «Light»
(«МиксLight» со вкусами: васаби, креветки, четыре сыра, шашлыка, холодца с хреном), изготовлено по ТУ РФ 10.39.23-002-06289042-2017, дата изготовления 12.08.2022, дата упаковывания 12.08.2022, годен до 12.02.2023, штриховой код 4607186159162. Условия хранения: хранить при температуре не выше 18+3 Со, относительной влажности не выше 75 %. Изготовитель: ООО «ЮСК», 350075, Российская Федерация, г. Краснодар, ул. имени Стасова, д. 178, пом. 209. (адрес производства: 353183, Россия, Краснодарский край, г. Кореновск, ул. Маяковского, д. 66). Упаковано для ООО «ВедаПром», Республика Беларусь, г. Воложин, ул. Набережная, 14, комн.3-16. Поставщик в Республику Беларусь: ООО «ВедаПром», г. Воложин, ул. Набережная, 14,комн.3-16.
Финик сушёный (с косточкой),
дата изготовления 08.2022, дата упаковывания 26.08.2022, годен до 01.08.2024, в полипропилено-вой упаковке массой 1000г, штриховой код 4810948006592, изготовлено по ТУ BY69269922.002, условия хранения при температуре не выше +250С и относительной влажности воздуха не более 75%. Изготовитель: ООО KOUROSHDRIEDFRUITSANDLEGUMESINDUSTRY», Исламская Республика Иран. Упаковщик/ импортер (поставщик) в Республику Беларусь: ЧПТУП «Шалу», Минская область, Минский район, Щомыслицкий с/с, аг. Озерцо, ул. Центральная, д. 35А, пом.25 (адрес места осуществления деятельности по упаковыванию продукции: Минская область, Пуховичский район, Руденский поселковый Совет,1). Не соответствует требованиям СанПин и ГН утвержденных постановлением Министерства здравоохранения Республики Беларусь от 21.06.2012 № 52; ГН, утвержденного постановлением Совета Министров Республики Беларусь от 25.01.2021 № 37 по микробиологическим показателям.
Пирожное песочное «Шоколатта»
дата изготовления 28.09.2022, срок годности при температуре 18±2ºС и относительной влажности воздуха 75% - 15 суток с даты изготовления. Изготовитель: ООО «Капризная Королева», Российская Федерация, Ленинградская обл., Всеволожский район, д. Порошкино, ул. Дорога на Мендсары, дом 10, пом. 1, оф.3-С. Импортер в Республику Беларусь СООО «Регион-продукт», Могилевская обл., г. Бобруйск, ул. Нахимова, д. 1, к. 37. Не соответствует требованиям СанПин и ГН утвержденных постановлением Министерства здравоохранения Республики Беларусь от 21.06.2012 № 52; ГН, утвержденного постановлением Совета Министров Республики Беларусь от 25.01.2021 № 37; ТР ТС 021/2011, принятого Решением Комиссии Таможенного союза от 09.12.2011 № 880 по микробиологическим показателям.
Информацию подготовила помощник врача-гигиениста Ошмянского районного ЦГЭ Михайлова Анна Сергеевна
18.10.2022
В целях обеспечения санитарно-эпидемиологического благополучия населения и недопущения к реализации пищевой продукции, представляющей потенциальную опасность для здоровья людей информируем:
Арахис в хрустящей корочке «DOCKER`S» (MIX)

масса нетто 500 г, изготовлено по ТУ 10.39.23-001-38038407-2016, штриховой код 4627074012317, изготовлено и упаковано 11.07.2022, годен до 10.05.2023. Изготовитель: ООО «ЭкоПродПак», Россия, 199178, г. Санкт-Петербург, 17-я линия В.О., д. 54, корпус 7.Поставщик в Республику Беларусь: ООО «Евроторг», г. Минск, 220099, ул. Казинца, д. 52а, ком. 22. Не соответствует требованиям ТР ТС 021/2011, принятого Решением Комиссии Таможенного союза от 09.12.2011 № 880; ТР ТС 022/2011, утвержденного решением комиссии Таможенного союза от 09.12.2011 г № 881; ТР ТС 029/2012, принятого Решением Совета Евразийской экономической комиссии от 20.07.2012 № 58; ГН, утвержденного постановлением Совета Министров Республики Беларусь от 25.01.2021 № 37; СанПин и ГН утвержденных постановлением Министерства здравоохранения Республики Беларусь от 12.12.2012 № 195, по маркировке в части предоставления достоверной информации о составе продукта.
Ядра подсолнечника жареные

изготовлено по ТУ BY 1917788.002-2020, дата изготовления 14.06.2022, годен до 14.12.2022, штриховой код 481580005331, хранить при температуре не выше 25º и относительной влажности воздуха не более 75%. изготовлено по ТУ BY 1917788.002-2020, дата изготовления 14.06.2022, годен до 14.12.2022, штриховой код 481580005331, хранить при температуре не выше 25º и относительной влажности воздуха не более 75%. Изготовитель ЧП «МБС-ТоргСервис», место нахождения: Минская обл., Минский район, Боровлянский с/с, д. Копище, ул. Лопатина 7А, пом. 804. Место изготовления продукции: Минская обл., Минский район, Сеницкий с/с, 39, район д. Леонтьевичи. Не соответствует требованиям ГН, утвержденного постановлением Министерства здравоохранения Республики Беларусь 21.06.2013 № 52 по органолептическому показателю.
Мармелад (изделия кондитерские сахаристые «Гигантские крокодилы»)

продукция упакована в потребительскую упаковку – заводской полиэтиленовый пакет массой нетто 1 кг, дата изготовления 27.05.2021, годен до 27.05.2023. Изготовитель: «VidalGolosinasSA» AvenidaGutierrezMellado 30500 MolinadeSegura (Murcia), Испания. Импортер в Республику Беларусь: ООО «Мармеладлэнд», Росийская Федерация, г. Москва, ул. Нижние Поля, д.27А, строение 2, пом. 1, комн.2. Не соответствует требованиям ГН, утв. постановлением Совета Министров Республики Беларус от 25.01.2021 № 37; СанПин и ГН, утв. постановлением Министерства здравоохранения Республики Беларусь от 21.06.2013 № 52 по микробиологическому показателю БГКП.
Соленая пищевая рыбная продукция «Кусочки лосося атлантического (семга)» малосоленые специального посола

в полиэтиленовой таре массой нетто 0,365 кг (масса рыбы 0,2 кг), изготовлено по ТУ ВУ 690292673.005-2016, дата изготовления 15.08.2022, срок годности 2 месяца с даты изготовления, штриховой код 4811634002041. Изготовитель: ЧТПУП «Райчонок», Минская область, 223113, Логойский район, аг. Острошицы, ул. Красная Зорька, 24 (юридический адрес: Минская область, 223034, Минский район, г. Заславль, ул. Пионерская, 12/1). Не соответствует требованиям ГН, утв. постановлением Совета Министров Республики Беларусь от 25.01.2021 № 37; СанПина, ГН, утв. постановлением Министерства здравоохранения Республики Беларусь от 21.06.2013 № 52 по микробиологическому показателю: обнаружены бактерии рода Proteus.
Полоска песочная с повидлом

изготовлена по СТБ 927-2008, дата изготовления 12.09.2022г 15:30, срок годности 15 суток, масса нетто 1 кг, штриховой код 2500000592249, Изготовитель: Кондитерский цех Любанского районного потребительского общества Минская область, г. Любань, ул. Боровика, д. 42. Не соответствует требованиям ТР ТС 029/2012, утвержденного решением Совета Евразийской экономической комиссии от 20.07.2012 г № 58; ГН, утв. постановлением Совета Министров Республики Беларусь от 25.01.2021 № 37; Санитарных норм и правил, ГН, утв. постановлением Министерства здравоохранения Республики Беларусь 12.12.2012 № 195 по маркировке.
Информацию подготовила помощник врача-гигиениста Ошмянского районного ЦГЭ Михайлова Анна Сергеевна
11.10.2022
В целях обеспечения санитарно-эпидемиологического благополучия населения и недопущения к реализации пищевой продукции, представляющей потенциальную опасность для здоровья людей информируем:
Полуфабрикат в тесте с мясосодержащей начинкой категории «Г» замороженный, Манты «Восточный»

дата изготовления 13.06.2022, срок годности 6 месяцев, штриховой код 4812787011119, номер партии 5352. Изготовитель: ООО ПЭП «ЭЛИКА», Россия, 142530, Московская область, г. Электрогорск, пр. Мечникова, 2. Импортёр в Республику Беларусь СП «Санта Импэкс Брест» ООО, Брест, 224004, ул. Катин Бор, 106А. Не соответствует требованиям ГН, утв. постановлением Совета Министров Республики Беларусь от 25.01.2021 № 37; ТР ТС 021/2011, принятого Решением Комиссии Таможенного союза от 09.12.2011 № 880; ТР ТС 034/2013, принятого Решением Совета Евразийской экономичекой комиссии от 09.10.2013 № 68 по микробиологическим показателям: обнаружены Salmonella Enteritidis.
Приправа «Хмели-сунели», приправы сухие

изготовлена по ТУ ВY 192340348.001-2017, масса нетто 30 г, дата изготовления 07.2022, годен до 05.2024, штриховой код 4815477004408. Изготовитель: ООО «Гурмина –ПРО», Минская область, 222750, Дзержинский район, г. Фаниполь, ул. Брестская, д. 7, оф. 138, пом. 3, адрес производства Минская область, 222750, Дзержинский район, г. Фаниполь, ул. Заводская, 25. Не соответствует требованиям ГН, утв. постановлением Совета Министров Республики Беларусь от 25.01.2021 № 37; СанПин и ГН, утв. постановлением Министерства здравоохранения Республики Беларусь от 21.06.2013 № 52; ТР ТС 021/2011, принятого Решением Комиссии Таможенного союза от 09.12.2011 № 880 по микробиологическому показателю: обнаружены БГКП.
Изюм. Виноград сушеный светло-коричневый

масса нетто 400 гр., дата изготовления 15.03.2022г., дата упаковки 06.04.2022г., годен до 14.03.2023г., упакован по ТУ 690269922.002, штриховой код: 4810948008589. Изготовитель: СП ООО «SIROJIDDIN AGRO FRUITS», Республика Узбекистан, Самаркандская область, Ургутский район, село Карабулак. Импортёр в Республику Беларусь/упаковщик: ЧП «Шалу», Минская область, 223021, Минский район, Щомыслицкий с/с, аг.Озерцо, ул.Центральная, д.35А, пом.25, адрес места упаковывания продукции Минская область, 22285, Пуховичский район, Руденский поселковый совет, 1. Не соответствует требованиям ГН, утв. постановлением Совета Министров Республики Беларусь от 25.01.2021 № 37; ГН, утв. постановлением Министерства здравоохранения Республики Беларусь от 21.06.2013 № 52 по микробиологическому показателю.
Мясо птицы. Голень цыплёнка-бройлера, охлаждённая

изготовлена по СТБ 1945, ТИ ВУ 300064950.207, дата изготовления 25.09.2022, срок годности 8 суток, при температуре хранения от 0°С до +2°С. Изготовитель: ОАО «Витебская бройлерная птицефабрика», Витебский район, Витебская область, Мазоловский с/с, д. Тригубцы, д. 1 А. Не соответствует требованиям СанПин и ГН, утв. постановлением Министерства здравоохранения Республики Беларусь от 21.06.2013 № 52 по органолептическому показателю: запах не свойственный доброкачественному мясу птицы.
Информацию подготовила помощник врача-гигиениста Ошмянского районного ЦГЭ Михайлова Анна Сергеевна
11.10.2022
В целях обеспечения санитарно-эпидемиологического благополучия населения и недопущения к реализации пищевой продукции, представляющей потенциальную опасность для здоровья людей информируем:
Халва подсолнечная торговый знак Liberty Orchards

изготовлено и упаковано 31.05.2022, годен до 31.10.2022, штриховой код 4620017458074, изготовитель ООО «КДВ Воронеж», Россия, 396039, Воронежская область, Рамонский район, д. Богданово, ул. Лесная, д. 31, не соответствует по содержанию кадмия.
Мороженная пищевая рыбная продукция «Креветки красные аргентинские в панцире без головы фасованные глазированные»

изготовленные по ТУ ВУ 100921458 016, массовая доля глазури 7 %, дата изготовления 06.10.2021, срок годности до 06.04.2023, упаковано 15.11.2021; Мороженная пищевая рыбная продукция «Креветки красные аргентинские в панцире без головы фасованные глазированные», дата изготовления 27.11.2021, срок годности до 27.05.2023, упаковано 08.02.2022, ООО «Вичюнай-Русь», Россия, не соответствуют по органолептическим показателям (креветки заморожены поштучно, чистые, целые, без значительной деформации, часть экземпляров смёрзшиеся между собой, глазурью покрыты неравномерно, с наличием участков налипания снега, кусков льда разного размера).
Абрикос сушеный без косточки (курага) индустриальная

дата изготовления 03.2022, срок годности 03.2023, изготовитель ООО «Субхи Ватан», Таджикистан, 735920, г. Исфара, ул. Хонобод, не соответствует по микробиологическому показателю (обнаружены БГКП (колиформы)).
Виноград сушеный (изюм) коричневый

дата изготовления 20.04.2022, срок годности 20.04.2023, изготовитель СП ООО «ECO ORIENT GROUP», Республика Узбекистан, Самаркандская область, г. Самарканд, посёлок Фархад, Промышленная зона, не соответствует по микробиологическому показателю (обнаружено содержание плесени).
Информацию подготовила помощник врача-гигиениста Ошмянского районного ЦГЭ Михайлова Анна Сергеевна
28.09.2022
В целях обеспечения санитарно-эпидемиологического благополучия населения и недопущения к реализации пищевой продукции, представляющей потенциальную опасность для здоровья людей информируем:
Арбуз свежий

урожай 2022, дата упаковывания 24.08.2022, срок годности с даты упаковывания 30 суток, изготовитель ООО «Авангард», Россия, 614032, Пермский край, г. Пермь, ул. Ямпольская, д. 11.
Дыня свежая

дата сбора август 2022, дата упаковывания 22.08.2022, срок годности с даты упаковывания 60 суток, изготовитель ИП «Азия Фрукт», Республика Казахстан, Туркестанская область, Мактааральский район, село Н. Есентаев, улица Жастар, дом б.н.
Пищевая продукция, не соответствует санитарно -эпидемиологическим требованиям по показателю нитраты (обнаружено превышение допустимого содержания нитратов).
Информацию подготовила помощник врача-гигиениста Ошмянского районного ЦГЭ Михайлова Анна Сергеевна
28.09.2022
В целях обеспечения санитарно-эпидемиологического благополучия населения и недопущения к реализации пищевой продукции, представляющей потенциальную опасность для здоровья людей информируем:
Консервы из печени рыбы. Печень трески атлантической (куски) натуральная

изготовлено по ГОСТ 13272-2009, упаковка: металлическая банка из лакированной жести, штамп на дне банки Р010BY05-10-38, масса нетто 240 г., дата изготовления: 15.09.2021г., срок годности 24 месяца с даты изготовления, штриховой код 4814531000943, хранить при температуре от 0°С до 20°С, относительной влажности воздуха не более 75%. Изготовитель: ОАО «Рыбокомбинат Любань», Минская область, 223812, г. Любань, ул. Боровика 6/1, не соответствует требованиям ГН, утв. постановлением Совета Министров Республики Беларусь от 25.01.2021 № 37; СанПина, ГН, утв. постановлением Министерства здравоохранения Республики Беларусь от 21.06.2013 № 52; ТР ТС 040/2016, принятого Решением Совета Евразийской экономической комиссии от 18.10.2016 № 162 по органолептическому показателю.
Дыня свежая «Торпеда»

урожай 2022, дата упаковывания 18.08.2022, срок годности с даты упаковывания 30 суток, условия хранения - хранить при температуре от 6°С до 12°С и относительной влажности от 85% до 90%. Изготовитель: ТОО «Азия грин фудс трейд», Республика Казахстан, 160900, Туркестанская область, Сарыагашский р-н,г. Сарыагаш, ул. Исмаилова б/н. Импортер в Республику Беларусь: ООО «Фрутреал», Витебская область, 211401, г. Полоцк, ул. Октябрьская, 25/1-6, комн. 17. Не соответствует требованиям ГН, утв. постановлением Совета Министров Республики Беларусь от 25.01.2021 № 37 по показателю нитраты.
Мясо птицы тушка куриная замороженная потрошенная упакованная 2-го сорта

Изготовлена по СТБ 1945-2010, датой изготовления 02.08.2022, срок годности 12 месяцев, штриховой код 4811106001572, условия хранения - хранить при температуре не выше 18°С. Изготовитель: ОАО «Солигорская птицефабрика», Солигорский район, аг. Краснодворцы. Не соответствует требованиям ГН, утв. постановлением Министерства здравоохранения Республики Беларусь от 21.06.2013 № 52; ГН, утв. постановлением Совета Министров Республики Беларусь от 25.01.2021 № 37 по микробиологическому показателю.
Информацию подготовила помощник врача-гигиениста Ошмянского районного ЦГЭ Михайлова Анна Сергеевна
19.09.2022
В целях обеспечения санитарно-эпидемиологического благополучия населения и недопущения к реализации пищевой продукции, представляющей потенциальную опасность для здоровья людей информируем:
По результатам испытаний выявлена пищевая продукция, несоответствующая санитарно-эпидемиологическим требованиям:
Дыня свежая, урожай 2022 года

дата сбора и упаковывания 09.08.2022, срок годности 60 суток с даты упаковывания, изготовитель К/Х «КАМАЛ КАРАХАН», Республика Казахстан, Туркестанская область, Жетысайский район, С.О., Атаконыс, ул. Думан, 2, не соответствует по содержанию нитратов (обнаружено превышение допустимого содержания нитратов).
Арбуз свежий продовольственный

урожай 2022 года, дата упаковывания 15.08.2022, срок годности с даты упаковывания 30 суток, изготовитель ИП Гаджиев Ибарат, Россия, 404066, Волгоградская область, Быковский район, с. Кислово, не соответствует по органолептическому показателю (внешний вид – мякоть не зрелая).
Чернослив сушеный (без косточки)

1/200 г, изготовлен по ТУ ВУ 690269922.002, дата изготовления 01.2022, дата упаковывания 02.03.2022, годен до 01.01.2023, штриховой код 481094848007162, изготовитель OOO «BulungurGoklFruits», Республика Узбекистан, Самаркандская область, Булунгуровский район, село Кульчабий, не соответствует по маркировке (отсутствие сведений на маркировке продукции о наличии в составе консерванта сорбиновой кислоты).
Информацию подготовила помощник врача-гигиениста Ошмянского районного ЦГЭ Михайлова Анна Сергеевна
16.09.2022
В целях обеспечения санитарно-эпидемиологического благополучия населения и недопущения к реализации продукции, представляющей потенциальную опасность для здоровья людей информируем, что лабораторным отделом Ошмянского районного ЦГЭ по результатам испытаний контрольного образца выявлена пищевая продукция, несоответствующая санитарно-эпидемиологическим и гигиеническим требованиям:
Компотная смесь из сухофруктов «Пад Сонейкам»


Изготовитель: Совместное предприятие общество с ограниченной ответственностью «SIROJIDDIN AGRO FRUITS», Самаркандская обл., Ургутский район, село Кара булок, Республика Узбекистан. Импортер в Республику Беларусь/ упаковано по заказу: общество с ограниченной ответственностью «Белквентаинвест, 220004, Республика Беларусь, г. Минск, пр. Победителей, д.7а, оф.38, пом.5. Упаковщик (фасовщик): Частное предприятие "МБС-ТоргСервис", 220081, Республика Беларусь, Минская область, Минский р-н, Боровлянский с/с, д. Копище, ул. Лопатина, д. 7А, пом. 804. Адрес упаковывания: 223011, Республика Беларусь, Минская область, Минский район, Сеницкий с/с, 39, район д. Леонтьевичи. Штрих код 4812756000373. Расфасовано по ТУ BY 191778882.001-2018. Дата изготовления 10.06.2022. Дата упаковывания 29.06.2022. Срок годности 10.06.2023. хранить при температуре не выше 25 0С и относительной влажности воздуха не более 75%. Состав: виноград сушеный, яблоко сушеное, слива сушеная абрикос сушеный, алыча сушеная, груша сушеная. Масса нетто в упаковке 500 г.; продукция не соответствует по микробиологическим показателям: обнаружены плесени в количестве 1,6•103 КОЕ/г, при норме не более 5•102 КОЕ/г.
Информацию подготовила помощник врача-гигиениста Ошмянского районного ЦГЭ Михайлова Анна Сергеевна
12.09.2022
В целях обеспечения санитарно-эпидемиологического благополучия населения и недопущения к реализации пищевой продукции, представляющей потенциальную опасность для здоровья людей информируем:
Дыня свежая «Гуляби»

урожай 2022 года, дата сбора и упаковывания 02.08.2022, срок годности с даты упаковывания 30 суток, изготовитель ТОО «Дельта НС», Республика Казахстан, 010000, г. Нур-Султан, ул. Куйши Дина, д. 17, не соответствует по содержанию нитратов (обнаружено превышение допустимого содержания нитратов).
Дыня свежая сорт Торпеда

ГОСТ 7178-2015, урожай 2022, дата сбора и упаковывания 08.08.2022, срок годности 60 суток с даты упаковывания, изготовитель К/Х «КАМАЛ КАРАХАН», Республика Казахстан, Туркестанская область, Жетысайский район, Жанааульский С.О., Ата-коныс, ул. Думан, 2, не соответствует по содержанию нитратов (обнаружено превышение допустимого содержания нитратов).
Арбуз «Сахарный малыш» (тёмный)

дата сбора июль 2022, дата упаковки 16.07.2022, срок годности с даты упаковки 60 суток, изготовитель Degirmenciler Zirai Urun Isleme Paketleme Pazarlama Ve Tasimacilik Tic. Ve San.Ltd. Sti; Kulak Mh. 7102 Sk. № 1/A Akdeniz, Mersin, Turkey, Турецкая Республика, не соответствует по органолептическим показателям (с признаками прокисания; плод твёрдый, мякоть кашицеобразная, с ослизнением, ярко-красного цвета, с наличием семян кремового цвета).
Полуфабрикат замороженный «Блинчики с творогом»

изготовлено по ТУ 10.72.19- 005-70458226-2018, дата производства 07.04.2022, годен до 07.10.2022, штриховой код 4610092090504, изготовитель ООО ПЗП «ЭЛИКА», Российская Федерация, Московская область, 142530, г. Электрогорск, проезд Мечникова, д. 2, не соответствует по микробиологическому показателю (обнаружены БГКП).
Информацию подготовила помощник врача-гигиениста Ошмянского районного ЦГЭ Михайлова Анна Сергеевна
07.09.2022
В целях обеспечения санитарно-эпидемиологического благополучия населения и недопущения к реализации пищевой продукции, представляющей потенциальную опасность для здоровья людей информируем:
Дыня свежая Торпеда
урожай 2022 года, дата упаковывания 20.07.2022, срок годности с даты упаковывания 90 суток (объём партии 16 кг), изготовитель OOO «AMIRJAN GOLD FRUITS», Республика Узбекистан, Appt, 6 H 147 A Rudakiy st. Samarqand, не соответствует по показателю нитраты (обнаружено превышение допустимого содержания нитратов).
Блины быстрозамороженные сладкие с творожной начинкой «Сытый папа»

изготовлено по СТО 57397431-001-2008, штриховой код 4630073800083, изготовлено и упаковано 25.02.2022, годен до 24.08.2022, изготовитель ООО «Лина», Россия, Рязанская область, г. Рязань, 390026, ул. 14-я Линия, д. 2, не соответствуют по микробиологическим показателям (обнаружено содержание БГКП (колиформы), КМАФАиМ).
Изделия кондитерские сахаристые. Зефир жевательный «Пухлый кролик»

MARSHMALLOWS BBO с ароматом пломбира, дата изготовления 18.04.2022, годен до 18.07.2023, штриховой код 465139150167, изготовитель OOO «ТД Алтей», Россия, 623733, Свердловская область, Режевский район, село Останино, ул. Центральная, д. 10, не соответствуют по микробиологическим показателям (обнаружено содержание плесени).
Виноград сушеный (изюм)

в потребительской упаковке, изготовлено по ТУ 9164-004-01370354-2016, масса нетто 180г, изготовлено и упаковано 16.05.2022, срок годности 8 месяцев, штриховой код: 46601162695847 (партия в количестве 10 упаковок), изготовитель ООО «НИКА», Россия, Московская область, 143345, г. Наро-Фоминск, р.п. Селятино, ул. Госпитальная, дом 2, не соответствует по микробиологическим показателям (обнаружено содержание плесени).
Арахис в хрустящей корочке «DOCKER`S» (MIX)

масса нетто 500 г, изготовлено по ТУ 10.39.23-001-38038407-2016, штриховой код 4627074012317, изготовлено и упаковано 28.05.2022, годен до 27.03.2023 (объём партии 8 упаковок по 500 г), изготовитель ООО «ЭкоПродПак», Россия, 199178, г. Санкт-Петербург, 17-я линия В.О., д. 54, корпус 7, не соответствует по маркировке (выявлены синтетические красители, не указанные на маркировке продукции: тартразин, блестящий синий FCF).
Информацию подготовила помощник врача-гигиениста Ошмянского районного ЦГЭ Михайлова Анна Сергеевна
29.08.2022
В целях обеспечения санитарно-эпидемиологического благополучия населения и недопущения к реализации пищевой продукции, представляющей потенциальную опасность для здоровья людей информируем:
Перец черный молотый «Спецаромат»

масса нетто 50 г, дата изготовления 17.05.2022, срок годности 24 месяца, изготовитель ООО «Славянский пищекомбинат», Россия, 123154, г. Москва, бульвар Генерала Карбышева, д. 5, корп. 2, пом. 1, этаж 1, офис 3/8 В, не соответствует по микробиологическому показателю (обнаружено превышение допустимого содержания плесени, БГКП (колиформ));
Финики сушенные сушеные с косточкой

продукция упакована в картонную коробку с полиэтиленовым вкладышем, массой нетто 10 кг, дата изготовления 07.12.2021, годен до 07.12.2023, штриховой код 00003316, изготовитель «ALI ASLABI CO» Astra, Jandas str., office 23, Иран, не соответствует по микробиологическому показателю (обнаружено превышение допустимого содержания плесени).
Арбуз свежий
урожай 2022, срок годности 30 суток с даты упаковывания, дата упаковывания 28.07.2022, условия хранения – хранить при температуре от 8°С до 10° и относительной влажности от 65 % до 70 %. Изготовитель: ООО «АВАНГАРД», Россия, Первомайский край, г. Пермь, ул. Ямпольская, д. 11, Волгоградская область, Быковский район, с Победа. Импортер в Республику Беларусь ООО «Фрутреал», Витебская область, г. Полоцк, ул. Октябрьская, 25/1-6, ком. 17. Не соответствует требованиям ГН, утв. постановлением Совета Министров Республики Беларусь от 25.01.2021 № 37; ГН, утвержденных Постановлением Министерства здравоохранения Республики Беларусь от 21.06.2013 № 52 по показателю «нитраты».
Арбуз свежий продовольственный

срок годности 30 суток с даты упаковывания, дата упаковывания 05.08.2022. Изготовитель: ИП Гаджиев Ибара, Россия, Волгоградская область, Быковский район, с Кислово. Импортер в Республику Беларусь ООО «Фрутреал», Витебская область, г. Полоцк, ул. Октябрьская, 25/1-6, ком. 17. Не соответствует требованиям ГН, утв. постановлением Совета Министров Республики Беларусь от 25.01.2021 № 37; ГН, утвержденных Постановлением Министерства здравоохранения Республики Беларусь от 21.06.2013 № 52 по показателю «нитраты».
Информацию подготовила помощник врача-гигиениста Ошмянского районного ЦГЭ Михайлова Анна Сергеевна
22.08.2022
О выявлении продукции, не соответствующей гигиеническим требованиям
В целях защиты внутреннего рынка от небезопасной и некачественной продукции санитарно-эпидемиологической службой Республики Беларусь продолжаются мероприятия технического (технологического, поверочного) характера по отбору проб и образцов пищевой продукции, находящейся в реализации.
По результатам испытаний выявлена пищевая продукция, несоответствующая санитарно-эпидемиологическим требованиям: по показателю нитраты (обнаружено превышение допустимого содержания нитратов):
Дыня свежая урожай 2022 года, дата упаковывания 13.07.2022, срок годности 60 суток с даты упаковывания (объем партии 39,8 кг), изготовитель Республика Казахстан, К/Х «КАМАЛ КАРАХАН», Туркестанская область, 160525, Жетысайский район, Жанааульский с.о., Ата-коныс, ул. Думан, 2.
Дыня свежая, урожай 2022, дата упаковывания 18.07.2022, срок годности 60 суток с даты упаковывания (объем партии 43,0 кг), изготовитель/упаковщик ИП «Азия Фрукт», Республика Казахстан, Туркестанская область, Мактааральский район, село Несентаев, ул. Жастер, дом б.и.

Свекла, урожай 2022, дата сбора 13.07.2022, дата упаковывания 13.07.2022, срок годности 30 суток с даты упаковывания (объем партии 15 кг), изготовитель ИП Ганжела Юлия Леонидовна, Российская Федерация, Аксайский район, п. Ковалевка, ул. Центральная, д. 30.
Все изображения носят иллюстративный характер.
Помощник врача-гигиениста А.В.Семёнова
17.08.2022

Санитарно-эпидемиологической службой Республики Беларусь продолжаются надзорные мероприятия по недопущению поступления некачественной и небезопасной пищевой продукции на внутренний рынок страны.
По результатам испытаний выявлена пищевая продукция, несоответствующая санитарно-эпидемиологическим требованиям:

Курага индустриальная, дата изготовления 02.2022, годен до 01.02.2023, изготовитель ООО «СУБХИ ВАТАН», Республика Таджикистан, Согдийская область, 735920, г. Исфара, ул. Хонобод (объем партии, от которой осуществлён отбор проб – 10,0 кг), не соответствует установленным требованиям по показателю «массовая доля сернистой кислоты (диоксид серы) и её солей (в пересчете на диоксид серы)».

Дыня свежая «Торпеда», урожай 2022 г., дата упаковывания 12.07.2022, срок годности 30 суток, изготовитель ТОО «Азия грин фудс трейд», Казахстан, 160900, Туркестанская область, Сарыагашский район, Сарыагаш, ул. Исмаилова, б/н, не соответствует установленным требованиям (в связи с обнаружением превышения предельно допустимого содержания нитратов).

Чай черный байховый цейлонский с ароматом черной смородины и измельченной чёрной смородиной «ПРИНЦЕССА КАНДИ ЧЕРНАЯ СМОРОДИНА» в пакетиках для разовой заварки (25×1,5 г), штриховой код 4605246006869, дата изготовления 04.2022, годен до 09.2023, изготовитель ООО «ОРИМИ», Россия, 188682, Ленинградская область, Всеволожский район, пос. им. Свердлова, 1 мкр., уч-к 15/4 (объём партии от которой осуществлён отбор проб – 18 упаковок), не соответствует установленным требованиям по микробиологическому показателю (обнаружено превышение допустимого содержания плесени).

Виноград сушеный (изюм) коричневый, дата изготовления 09.06.2022, срок годности 09.06.2023, изготовитель СП ООО «ЕСО ORIENT GROUP», Республика Узбекистан, Самаркандская область, г. Самарканд, посёлок Фархад Промышленная зона, не соответствует установленным требованиям по микробиологическому показателю (обнаружено превышение допустимого содержания плесени).

«Хэйлис английский зелёный чай». Чай зелёный байховый китайский мелкий, в пакетах для разовой заварки по 2 г; в потребительской упаковке, масса нетто 50 г (25×2), дата изготовления 24.10.2021, годен до 21.10.2024, штриховой код 4607807010445 (объем партии 6 штук), изготовитель ООО «ПЭТРОН», г. Москва, 115477, ул. Кантемировская, д. 59А, не соответствует установленным требованиям по микробиологическому показателю (обнаружено превышение допустимого содержания плесени).
Все изображения носят иллюстративный характер.
Помощник врача-гигиениста Семёнова А.В.
11.08.2022
В целях обеспечения санитарно-эпидемиологического благополучия населения и недопущения к реализации пищевой продукции, представляющей потенциальную опасность для здоровья людей информируем:
Дыня свежая
урожай 2022, дата сбора 09.06.2022, дата упаковывания, 09.06.2022, срок годности с даты упаковывания 60 суток (партия 100 кг), изготовитель ИП «БЕРКАТ», Республика Казахстан, Туркестанская область, Жетысайский район, Жетысай, ул. Хусанова, 5а, не соответствует по показателю нитраты (обнаружено превышение допустимого содержания нитратов).
Приправа для шашлыка и гриля

в полимерных упаковках по 15 г, дата изготовления 26.04.2022, срок годности 24 месяца, штриховой код 4780048900161 (партия 27 штук), изготовитель ООО «SPICE EXPERT», Россия, г. Ташкент, ул. Богишамол, 160, не соответствует по микробиологическому показателю (обнаружены БГКП (колиформы)).
Приправа для креветок «Вкус мастера»

изготовлено по ТУ 9199-009-4877850-02, упакована в потребительскую упаковку из ламинированной бумаги массой нетто 15 г, дата изготовления 02.02.2022, срок годности 24 месяца, штриховой код 4607018296553, (партия 41 штука), изготовитель ООО «Русская бакалейная компания», Россия, 141100, Московская область, г. Щелково, ул. Краснознаменская, 6, не соответствует по микробиологическому показателю (обнаружены БГКП (колиформы)).
Вино виноградное натуральное красное полусухое MEZOK (МЕЗЁК)

с защищенным географическим указанием из района между Дунаем и Тиссой, в стеклянных бутылках объёмом 750 мл, урожай 2020 года, дата розлива 05.08.2021,срок годности 3 года, спирт 11%, штриховой код 5999885432134 (размер партии 6 бутылок), изготовитель «Winegarden» KFT, 6230, Soltvadkert, Szentharomsagu, 110, Венгрия, не соответствует по маркировке (в составе продукта обнаружена незаявленная изготовителем на маркировке пищевая добавка сорбиновая кислота (Е200), ее соли сорбаты (Е201, Е202, Е203) в пересчете на сорбиновую кислоту).
Киви (цукаты) плоды и съедобные части растений приготовленные (подсушенные) методом осмотического обезвоживания с содержанием сахара
дата изготовления 01.2022, годен до 01. 01.2023 (отбор проб произведен от партии 5,071 кг), изготовитель SHLHAZHU ANGEVER GREAT TRADING CO., LTD., адрес производства/адрес экспортера No. 915 9th floor, Zhon gynan building, No, 368 North Yonyi Street, Shijiazhuang, Hebei, Китай, не соответствует по маркировке (в связи с отсутствием сведений на маркировке продукций о наличий в составе консерванта — сорбиновой кислоты).
Колбаса вареная «Мортаделла». Продукт охлажденный

изготовлено по ТУ 10.89.19-007-18573788-2020, масса нетто 500 г, дата изготовления штамп 01.06.2022, срок годности не более 90 суток при температуре от +2°С до 6°С, штриховой код 4627107454664, изготовитель ООО «Вего», Россия, г. Москва, ул. Электродная, 10, стр. 2, не соответствует по маркировке (наличие в составе продукта незаявленных изготовителем в маркировке пищевых добавок бензойной и сорбиновой кислот).
Информацию подготовила помощник врача-гигиениста Ошмянского районного ЦГЭ Михайлова Анна Сергеевна
05.08.2022
В целях обеспечения санитарно-эпидемиологического благополучия населения и недопущения к реализации пищевой продукции, представляющей потенциальную опасность для здоровья людей информируем:
Свекла столовая

- урожай 2022, дата упаковывания 24.06.2022, срок годности 60 суток с даты изготовления, условия хранения –хранить при температуре от 4°С до 5°С и относительной влажности воздуха от 85 % до 95 %.
- Изготовитель:ТОО «Кампания ШИК», Республика Казахстан, Туркестанская область, Жетысайский район, Каракайскийс.о., с. Каракайское,.Импортер в Республику Беларусь ООО «Санта Ритейл», г. Брест, ул.Советской Конституции, 26/1.
- Не соответствует требованиям ТР ТС 021/2011, принятого Решением Комиссии Таможенного союза от 09.12.2011 № 880; ГН, утв. постановлением Совета Министров Республики Беларусь от 25.01.2021 № 37; Санитарных норм и правил, ГН, утвержденных Постановлением Министерства здравоохранения Республики Беларусь от 21.06.2013 № 52 по содержанию нитратов.
Халва подсолнечная LibertyOrchards

- изготовлено и упаковано 24.05.2022, годен до 24.10.2022, штриховой код 4620017458074,
- Изготовитель: ООО «КДВ Воронеж», Россия, 396039, Воронежская область, Рамонский район, д. Богданово, ул. Лесная, д. 31.
- Импортер в Республику Беларусь: ИТУП «КДВ БЕЛ», г. Минск, 220038, пер. Липковский, д. 12, офис 205.
- Не соответствует требованиям ТР ТС 021/2011, принятого Решением Комиссии Таможенного союза от 12.2011 № 880;ГН, утв. постановлением Совета Министров Республики Беларусь от 25.01.2021 № 37;ГН, утвержденных Постановлением Министерства здравоохранения Республики Беларусь от 21.06.2013 № 52 по содержанию кадмия
По домашнему «Блинчики с мясом». Блинчики с начинкой замороженные

- изготовленные по ТУ 9119-042-54899698-09, дата изготовления 15.03.2022,
- штриховой код 24660040282004, срок годности при температуре - 18°С - 180 суток
- Изготовитель: ООО «Кубанский бекон», Россия, 352430, Краснодарский край, г. Курганинск, ул. Карла Маркса, ул. Лермонтова, 122.Импортер в Республику Беларусь: ООО «Арнипак», г. Могилев, 212011, ул. Калужская, 35-2.
- Не соответствует требованиямТР ТС 021/2011, принятого Решением Комиссии Таможенного союза от 09.12.2011 № 880;ГН, утв. постановлением Совета Министров Республики Беларусь от 25.01.2021 № 37;СанПин, ГН, утвержденных Постановлением Министерства здравоохранения Республики Беларусь от 21.06.2013 № 52по микробиологическому показателю:обнаружены КМАФАнМ
Консервы рыбные. Хамса черноморская неразделанная в томатном соусе стерилизованная, торговой марки «Фаворит»

- произведено из мороженного сырья, изготовлено по ТУ 10.20.25-001-00101652-2019, масса нетто 240 г,
- дата изготовления 14.03.2022, срок хранения и годности 24 месяца от даты изготовления,
- штриховой код 4610018300229,
- Изготовитель: ООО «Фортуна Крым», Россия, 243600, Республика Крым, г. Симферополь, ул. Карла Маркса, д. 14/9, стр 81 Ц, адрес производстваРыбоконсервный завод ООО «Фортуна Крым», Россия, 295570, Республика Крым, г. Симферопольский район, с. Фонтаны, ул. Озенбашская, д. 4.Поставщик в Республику Беларусь: ООО «Ирмол», Минский район, 223050, аг. Колодищи, ул. Ушестинская, д. 8-2.
Дыня свежая «Торпеда»

- урожай 2022, дата сбора 03.07.2022, дата упаковывания 03.07.2022, срок годности 30 суток с даты упаковывания, условия хранения –хранить при температуре от 4°С до 6°С, относительной влажности воздуха 85% - 90 %.
- Изготовитель: ООО «Lunagro», Республика Узбекистан, г. Ташкент, Яшнабадский район, ул. Бешарик, 3-й подъезд, д. 19 А. Импортер в Республику Беларусь ООО «Санта Ритейл», г. Брест, ул. Советской Конституции, 26/1.
- Не соответствует требованиям ТР ТС 021/2011, принятого Решением Комиссии Таможенного союза от 09.12.2011 № 880; ГН, утв. постановлением Совета Министров Республики Беларусь от 25.01.2021 № 37; Санитарных норм и правил, ГН, утвержденных Постановлением Министерства здравоохранения Республики Беларусь от 21.06.2013 № 52 по содержанию нитратов.
Информацию подготовила помощник врача-гигиениста Ошмянского районного ЦГЭ Михайлова Анна Сергеевна
03.08.2022
В целях обеспечения санитарно-эпидемиологического благополучия населения и недопущения к реализации пищевой продукции, представляющей потенциальную опасность для здоровья людей информируем:
Абрикос сушеный

масса нетто 12,5 кг, дата изготовления 22.12.2021, срок годности до 22.12.2022, условия хранения – хранить в чистых, сухих и прохладных помещениях. Изготовитель: Guzel Can Gida Tarim Urunleri Insaat. Turizm Sanayive Ticaret Limited Sirketi. SariciogluMah. BuharaCad. No 142\ ABattalgaziMalatya\ Turkey, Турция. Импортер в Республику Беларусь: ООО «Детави», г. Минск, 2-ой Велосипедный пер, д.32, пом.9.
Не соответствует требованиям ГН, утв. постановлением Совета Министров Республики Беларусь от 25.01.2021 № 37; Санитарных норм и правил, ГН, утвержденных Постановлением Министерства здравоохранения Республики Беларусь от 21.06.2013 № 52 по органолептическим показателям.
Чай черный байховый индийский «Гита»

в пакетах, для разовой заварки 60 г (30×2г), изготовлено по ГОСТ 32573-2013, дата изготовления 05/2022, срок годности 04/2025, штриховой код 4605246003110. Изготовитель: ООО «Оримии», Россия, 188682, Ленинградская область, Всеволожский район, пос. им. Свердлова, 1, мкр. участок 15/4. Поставщики в Республику Беларусь: ООО «Тибитрэй», г. Минск, ул. Уручская, д. 11а, оф. 43; ООО «Альфа-Дистрибъюция», г. Минск, ул. Матусевича, д. 20, пом. 12/1.
Не соответствует требованиям ГН, утв. постановлением Совета Министров Республики Беларусь от 25.01.2021 № 37; ГН, утвержденных Постановлением Министерства здравоохранения Республики Беларусь от 21.06.2013 № 52 ТР ТС 021/2011, принятого Решением Комиссии Таможенного союза от 09.12.2011 № 880 по микробиологическому показателю.
Сидр фруктовый ароматизирован-ный, фильтрованный сладкий газированный «Вишневый».

в бутылке ПЭТ по 1,45 литра сифон, алк. 6,0 %, ГОСТ Р 59170-2020, дата розлива 04.05.2022, срок годности 12 месяцев с даты розлива (до 04.05.2023), штриховой код 4612728201643, условия хранения - хранить при температуре от 50С до 200С и относительной влажности 85 %. Изготовитель: ООО «Злынковский завод новых технологий по производству вин и напитков» «Каскад», Россия, 243600, Брянская область, г. Злынка. Импортер в Республику Беларусь: ООО «ВарницаТрейд», г. Могилев, 212013, Славгородское шоссе, 30к.
Не соответствует требованиям ТР ТС 029/2012, утвержденного решением Совета Евразийской экономической комиссии от 20.07.2012 г № 58; ТР ТС 022/2011, утвержденного решением комиссии Таможенного союза от 09.12.2011 г № 881; ГН, утв. постановлением Совета Министров Республики Беларусь от 25.01.2021 № 37; Санитарных норм и правил, ГН, утв. постановлением Министерства здравоохранения Республики Беларусь 12.12.2012 № 195 по маркировке.
Информацию подготовила помощник врача-гигиениста Ошмянского районного ЦГЭ Михайлова Анна Сергеевна
21.07.2022
В целях обеспечения санитарно-эпидемиологического благополучия населения и недопущения к реализации пищевой продукции, представляющей потенциальную опасность для здоровья людей информируем:
Дыня свежая

урожай 2022, дата сбора 22.06.2022, дата упаковывания 22.06.2022, срок годности с даты упаковывания 2 месяца, условия хранения - хранить при температуре от 2°С до 6°С и относительной влажности не более 95%. Изготовитель: ТОО «Азия грин фудс трейд», Республика Казахстан, 160900, Туркестанская область, Сарыагашский р-н, г. Сарыагаш, ул. Исмаилова б/н. Импортер в Республику Беларусь ОДО Виталюр», 223010, Минский район, 9-ый км Московское шоссе, АБК, к.1.
Не соответствует требованиям ТР ТС 021/2011, принятого Решением Комиссии Таможенного союза от 09.12.2011 № 880 по показателю «нитраты».
Слива сушенная 1 сорт

в полипропиленовом пакете массой по 0,4 кг, дата изготовления 27.01.2022, дата фасования 10.03.2022, срок годности 6 месяцев с даты изготовления,
штриховой код 4813991000364, условия хранения – хранить в чистых, сухих, без постороннего запаха и вредителей складских помещениях, при температуре не выше 25°С и относительной влажности не более 75 %. Изготовитель:ЧП «Umar Kishmish Servis», Республика Узбекистан, Самарркандская область, Паярикский район, г. Челек, ССГ Кумчук, ул. Истиклал.Импортер в Республику Беларусь/ фасовщик
ООО «Грасп», г. Могилев, 212012, пер. Гаражный, 29, место фасовки г. Могилев, пер. Гаражный, 17.
Не соответствует требованиям ГН, утв. постановлением Совета Министров Республики Беларусь от 25.01.2021 № 37; ТР ТС 021/2011, принятого Решением Комиссии Таможенного союза от 09.12.2011 № 880 по микробиологическому показателю.
Приправа сухая «Для фарша», торговой марки «Пряный Дом»

в потребительской ПЭТ упаковке массой 50 г, изготовлено по СТБ 905, дата изготовления 31.03.2022, годен до 31.03.2024, штриховой код 4814957001821, изготовитель производственно – торговое ЧУП «Пряный Дом», г. Борисов, 222518, ул. Демина, 23 Б..
Не соответствует требованиям санитарно-эпидемиологическим и гигиеническим требованиям по микробиологическим показателям.
Информацию подготовила помощник врача-гигиениста Ошмянского районного ЦГЭ Михайлова Анна Сергеевна
18.07.2022
В целях обеспечения санитарно-эпидемиологического благополучия населения и недопущения к реализации пищевой продукции, представляющей потенциальную опасность для здоровья людей информируем:
Свекла столовая свежая
Урожай 2022, дата упаковывания 10.06.2022г, срок годности 60 суток с даты упаковывания. рекомендуемые условия хранения - хранить при температуре от 4°С до 5°С и относительной влажности воздуха от 85% до 95%. Изготовитель: - ТОО «Кампания ШиК», Республика Казахстан,
160500, Туркестанская область, Жетысайский район, Каракайский с.о., с.Каракайской, ул.И.Балабеков, д. 15. Поставщик в Республику Беларусь ООО «Санта Ритейл», г.Брест, 224032, ул.Советской Конституции, 26/1.
Не соответствует требованиям
ГН, утв. постановлением Совета Министров Республики Беларусь от 25.01.2021 № 37;ГН, утв. постановлением Министерства здравоохранения Республики Беларусь от 21.06.2013 № 52; ТР ТС 021/2011, принятого Решением Комиссии Таможенного союза от 09.12.2011 № 880
по показателю «нитраты»
Дыня «Торпеда» свежая

урожай 2022г, дата упаковывания 20.06.2022; срок годности с даты упаковывания 90 суток, условия хранения – хранить при температуре от 4°С до 10°С и относительной влажности 90-95%. Изготовитель:
ИП «БЕРКАТ», Республика Казахстан, 160500, Туркестанская область, Жетысайский р-н, г.Жетысай, ул.Хусайнова, 5А.Поставщик в Республику ООО «Артиус-16», Минская область, 223054, Минский р-н, д. Околица, Садовая, дом № 3, офис 2.
Не соответствует требованиям
ГН, утв. постановлением Совета Министров Республики Беларусь от 25.01.2021 № 37;ГН, утв. постановлением Министерства здравоохранения Республики Беларусь от 21.06.2013 № 52; ТР ТС 021/2011, принятого Решением Комиссии Таможенного союза от 09.12.2011 № 880
по показателю «массовая доля нитратов».
Бальзамический соус-крем

служит изысканной заправкой салатов из овощей и зелени, рыбы и мяса, мороженого и десертов, дата розлива 26.05.2022, срок годности 18 месяцев, объем 220 мл. Изготовитель: ООО «СП Мирный», Россия, г. Москва, Щелковское шоссе, 77. Импортер в Республику Беларусь ЧТПУП «Белвитапродукт» г. Минск, 220045, ул. Наполеона Орды, д. 23, адм. помещение 329, ком. 1.
Не соответствует требованиям
ТР ТС 029/2012, принятого Решением Совета Евразийской экономической комиссии от 20.07.2012 № 58 по маркировке: на этикетке отсутствует информация о наличии в составе сорбиновой и бензойной кислот.
Морковь столовая ранняя, весовая, урожай 2022г.

дата упаковки 26.06.2022, срок годности 60 суток с даты упаковки, условия хранения – хранить при температуре не выше от +1°С до 3°С и относительной влажности воздуха не более 85-95%. Изготовитель: ТОО «Garden - Fruit», Казахстан, Туркестанская область, Мактааральский район, п. Атакент, ул. Ташкентская, 66. Импортер в Республику Беларусь ООО «Фрешлинкс», г. Минск, ул. Чорного, д. 5а, оф. 15а.
Не соответствует требованиям
ГН, утв. постановлением Совета Министров Республики Беларусь от 25.01.2021 № 37;ТР ТС 021/2011, принятого Решением Комиссии Таможенного союза от 09.12.2011 № 880 по показателю нитраты.
Грецкий орех, очищенный светлый ½ (ядро грецкого ореха), весовой

упакован в транспортную упаковку (картонная коробка), дата изготовления 10.2021, годен до 01.10.2022, условия хранения – хранить при температуре до +25°С партия № 21-050/10с-1. Изготовитель:
Фермерское хозяйство «СИЁБ-ШАВКАТ-ОРЗУ», Республика Узбекистан, Самаркандская область, Тайлякский район, село Курганча. Импортер в Республику Беларусь ООО «Продхимснаб»,г. Минск, Промышленная, 6Б/2, ком. 12.
Не соответствует требованиям
СанПина, ГН, утв. постановлением Министерства здравоохранения Республики Беларусь от 21.06.2013 № 52; ГН, утв. постановлением Совета Министров Республики Беларусь от 25.01.2021 № 37;ТР ТС 021/2011, принятого Решением Комиссии Таможенного союза от 09.12.2011 № 880 по содержанию афлатоксина В1.
Сыр мягкий «Городокский» с массовой долей жира в сухом веществе 45%

изготовлено по ТУ ВY 391005778.001-2020, срок годности – 9 суток с даты изготовления, упаковано под вакуумом, штриховой код 4812118000010, условия хранения - хранить (в том числе после вскрытия упаковки) при температуре воздуха от + 2º до + 6ºС и относительно влажности воздуха от 75 - 85% . Изготовитель: ЧТПУП «ЭЛЬРОСТ», Витебская область, Городокский район, д. Смоловка, ул. Совхозная, 9; адрес производства: Республика Беларусь, Витебская область, г. Городок, ул. Бурлыги, 11В.
Не соответствует требованиям ТР ТС 022/2011 по маркировке.
Информацию подготовила помощник врача-гигиениста Ошмянского районного ЦГЭ Михайлова Анна Сергеевна
13.07.2022
Дыня «Киркагач»

дата сбора май 2022, дата упаковки 21.05.2022, срок годности 60 суток с даты упаковывания, изготовитель EREN TARIM URUNLERI SANAYI VE TK LTD. STI SARIBRAHIMLI MAH. KIZIL YAKA MEVKI NO: AKDENIZ MERSIN, Турция, не соответствует по показателю нитраты (обнаружено превышение допустимого содержания нитратов);
Дыня Киркагик свежая весовая
урожай 2022 г, дата упаковывания 04.06.2022, срок годности 60 суток с даты упаковывания, изготовитель Biberciler Ic Dis Gida Maddeleri Pazarlama Ticaret Limited Sirketi Kulak Mahallesi 7101 Sokak № 2/А, Mersin/Akdeniz, Turkey, 33115, Турция, не соответствует по показателю нитраты (обнаружено превышение допустимого содержания нитратов);
Свекла столовая свежая

урожай 2022, дата упаковывания 11.06.2022, срок годности 60 суток с даты упаковывания, изготовитель ТOO «GARDEN—FRUIT», Республика Казахстан, Туркестанская область, Мактааральский район, поселок Атакент, ул. Ташкентская, д. 66, не соответствует по показателю нитраты (обнаружено превышение допустимого содержания нитратов);
Свекла столовая свежая
урожай 2022, дата упаковывания 08.06.2022, срок годности 60 суток с даты упаковывания, изготовитель OOO «YANGIQO`RG` ON NEW GRAN INVEST», Республика Узбекистан, Ферганская область, Бувайдинский район, г. Хонобод, ул. Шафоат, 79, не соответствует по показателю нитраты (обнаружено превышение допустимого содержания нитратов);
Сливы сушеные без косточки (чернослив)

масса нетто 500 г, дата изготовления 18.02.2022, дата упаковывания 21.03.2022, срок годности 18.02.2023, штриховой код 4813635006028, номер партии 21.03.2022, изготовитель ООО «SAMARKAND EXPORT FRUITS», Республика Узбекистан, Самаркандская область, Самаркандский район, с. Дашти сухта, не соответствуют по микробиологическому показателю (превышен гигиенический норматив по показателю дрожжей);
Овощи сушеные зелень укропа Spezzo

дата изготовления и упаковывания 14.04.2022, срок годности 36 месяцев, штриховой код 4813494054871, изготовитель ООО «Аллегро-Специи», Россия, г. Саратов, ул. Арбатская, 28, не соответствуют по микробиологическому показателю (превышен гигиенический норматив по показателю плесени);
Манговый соус на основе винного уксуса

100 % натуральный продукт, изготовлено по СТО 18278150-002-2015, объем 220 мл, дата розлива 22.03.2021, срок годности 18 месяцев, штриховой код 4606447001790, фасован в бутылки из полимерного материала, изготовитель OOO «СП Мирный», Россия, г. Москва, Щелковское шоссе, 77, не соответствует по маркировке (на маркировке пищевой продукции в составе отсутствует информация о применении консервантов сорбиновой кислоты Е200, бензойной кислоты Е210, обнаруженных в пределах допустимых значений в ходе проведения лабораторных исследований образца).
Информацию подготовила помощник врача-гигиениста Ошмянского районного ЦГЭ Михайлова Анна Сергеевна
11.07.2022
В целях обеспечения санитарно-эпидемиологического благополучия населения и недопущения к реализации пищевой продукции, представляющей потенциальную опасность для здоровья людей информируем:
Чай зеленый байховый китайский «ПРИНЦЕССА ЯВА ТРАДИЦИОННЫЙ»

в пакетиках для разовой заварки, изготовлена по ТУ 9191-001-39420178-97, масса нетто 50 г (2 г ×25 шт), продукция упакована в картонную упаковку, сверху обтянута пленкой из полимерных материалов, запаяна термошвом (объем партии 36 шт.), изготовитель ООО «ОРИМИ», Россия, 188682, Ленинградская область, Всеволожский район, пос. им. Свердлова, 1, мкр., уч-к 15/4, не соответствовал по микробиологическому показателю (обнаружено содержание плесени).
Грецкий орех ядра торговой марки «Белый пеликан»

в полимерной упаковке массой 70 г, изготовлен по ТУ РБ 100523831.001, дата изготовления 08.09.2021, дата упаковывания 15.12.2021, годен до 08.09.2022, штриховой код 4811028000103, изготовитель ООО «НАТСИ», Украина, 89422, с. Минай, ул. Можайского, 12, не соответствовал по микробиологическому показателю (обнаружены БГКП (колиформы)).
Лук репчатый свежий, урожай 2022 года

дата упаковывания 08.05.2022, срок годности с даты упаковывания 60 суток (объем партии 162 кг), изготовитель «SAMARQAND AGRO TRADE LEADER», Республика Узбекистан, Самаркандская область, Самаркандский район, Кульбапоян КФИ, Шурбоимахалля (обнаружено превышение допустимого содержания нитратов).
Изделия хлебобулочные сдобные «Маффин ванильный» с начинкой «Клубничная»

дата изготовления 13.04.2022, годен 4 месяца, штриховой код 4603770017122, массой нетто 450 г., (партия 6 шт), изготовитель ООО «Континент – Сервис», Россия, 634527, Томская область, Томский район, с. Лучанова, ул. Совхозная, 3, не соответствовали по показателю «бензойная кислота» (в составе продукции содержится консервант бензойная кислота, не предусмотренный к применению в хлебобулочных изделиях).
Дыня свежая «Киркагик», урожай 2022 года

дата упаковывания 28.05.2022, штриховой код 2060338035943 (размер партии 23,0 кг), изготовитель УЧАК КАРДЕШЛЕР ГЫДА СЕРАДЖЫЛЫК УЛУСЛАРАРА, НАКЛИЙЕ ПЛАСТИК САНАЙИ ВЕ ТИДЖАРЕТ ЛИМИТЕД ШИРКЕТИ, Республика Турция, Измир, Саферихисар, пр-т Кушадасы, кв-л Теледжик № 79 (обнаружено превышение содержания «нитратов»).
Полуфабрикат замороженный «Блинчики с творогом»

изготовлено по ТУ 10.71.19-005-70458226-2018, дата изготовления 01.02.2022, годен до 01.08.2022, штриховой код 4650057075160, номер партии 0875 (отобрано от партии 6,0 кг), изготовитель ООО ПЗП «Элика», Россия, Московская область, г. Электрогорск, пр-т Мечникова, д. 2, не соответствовал по микробиологическому показателю (обнаружены БГКП).
Информацию подготовила помощник врача-гигиениста Ошмянского районного ЦГЭ Михайлова Анна Сергеевна
04.07.2022

Государственное учреждение «Ошмянский районный ЦГЭ» информирует, Главным государственным инспектором Республики Беларусь по надзору за соблюдением технических регламентов с 24.05.2022:
1) запрещен ввоз и обращение опасной продукции, прекращены действия на территории Республики Беларусь документов об оценке соответствия:
жевательный зефир «ЗефиркиШоу» (завитушка), в картонном коробе обтянутом полимерной пленкой, масса нетто 1,5 кг, дата изготовления 10.12.2021, срок годности 6 месяцев, СТО 27152904-002-2017, изготовитель ООО «Кондитерская фабрика «Азовчанка», Российская Федерация, Ростовская область, г. Азов (поставщик в Республику Беларусь ИП Ходосевич Н.Г., г. Кричев); прекращено действие на территории Республики Беларусь декларации о соответствии ЕАЭС N RU Д–RU.РА01.В.69299/21).
2) прекращены действия на территории Республики Беларусь документов об оценке соответствия:
декларация о соответствии ЕАЭС N RU Д–RU.PA02.B.16851/21, сопровождающая пирожное «Нутелла», в картонном коробе обтянутом полимерной пленкой, масса нетто 2,0 кг, дата изготовления 12.03.2022, срок хранения 20 суток, ТУ 9134-001-17390784-2013, изготовитель ООО «Сладкая Мечта», Российская Федерация, Московская область, г. Солнечногорск (поставщик в Республику Беларусь ИП Ходосевич Н.Г., г. Кричев).
Информацию подготовила помощник врача-гигиениста Ошмянского районного ЦГЭ Михайлова Анна Сергеевна
08.06.2022
В целях обеспечения санитарно-эпидемиологического благополучия населения и недопущения к реализации пищевой продукции, представляющей потенциальную опасность для здоровья людей информируем:
Изюм виноград сушеный коричневый «Копеечка», 2 сорт

в полиэтиленовой упаковке, масса нетто 400 г, штриховой код 4810948008589, дата изготовления 02.2022, дата упаковывания 24.03.2022, срок годности до 01.02.2023, хранить при температуре не выше +25°С и относительной влажности воздуха не более 75% (отобран от партии 4,4 кг), изготовитель фермерское хозяйство «SIROJIDDIN AGRO FRUITS», Республика Узбекистан, Самаркадская область, Ургутский район, село Карабулак, не соответствует установленным требованиям по микробиологическим показателям (обнаружены КМАФАН, плесени).
Мороженая пищевая рыбная продукция «Пангасиус стейк глазированный мороженный»

(стейк пангасиуса с кожей 80-120 гр/шт)/ Pangasius Steak, в картоном коробе, масса нетто 10 кг, дата выработки 01.06.2021, хранить при температуре не выше минус 18ºС, срок годности не более 24 месяцев с даты выработки (информация о размере партии отсутствует), изготовитель Hiep Thanh Seafood Joint Stock Co, Вьетнам, National highway 91, Thoi An area, Thuan An commune , Thot Not district, Can Tho city, не соответствует установленным требованиям по микробиологическим показателям (обнаружены КМАФАН).
Чай зеленый байховый китайский «Принцесса Ява традиционный»

в пакетах для разовой заварки, масса нетто 50 г (25 фильтр пакетов по 2 г, упакованы в картонную коробку с защитной пленкой), штриховой код 4605246002229, дата изготовления 12.2021, годен до 11.2024 (отобран от партии 12 упаковок), изготовитель ООО «ОРИМИ», Россия, Ленинградская область, Всеволожский район, пос. им.Свердлова, 1, мкр, уч-к 15/4, не соответствует установленным требованиям по микробиологическим показателям (обнаружены плесени).
Мясосодержащие полуфабрикаты в тесте замороженные с мясосодержащей начинкой категории В «Хинкали «Кавказские»

в картонной таре с полиэтиленовым вкладышем весом 5 кг, штриховой код 4607048470831, дата изготовления 18.03.2022, срок годности 6 месяцев при температуре не выше минус 18°С, номер партии 0009 (отобрано от партии 5,0 кг), изготовитель ИП Кузнецова Татьяна Васильевна, Россия, Нижегородская обл., г. Дзержинск, ул. Бутлерова, д. 36, кв. 15 (адрес производства: Россия, Нижегородская обл, г. Дзержинск, ул. Водозаборная, 10), не соответствует установленным требованиям по микробиологическим показателям (обнаружена Salmonella enteritidis).
Пирожное заварное «Эклерчик» со сливками

в картонной упаковке массой нетто 2,0 кг, штриховой код 4623721718458, номер партии 478784, дата изготовления 26.04.2022, срок годности 10 суток, условия хранения — при температуре 5-18°С и относительной влажности не более 75% (отобрано от партии 2,0 кг), изготовитель ООО «Солнечная Долина», Россия, Московская область, г. Балашиха, мкр. Саввино, ул. Промышленная, дом 51, не соответствует установленным требованиям по микробиологическим показателям (обнаружен S.aureus).
Информацию подготовила помощник врача-гигиениста Ошмянского районного ЦГЭ Михайлова Анна Сергеевна
02.06.2022
В целях обеспечения санитарно-эпидемиологического благополучия населения и недопущения к реализации пищевой продукции, представляющей потенциальную опасность для здоровья людей информируем:
Изделие мучное кондитерское торт «Тирамису»

штриховой код 4601787008355, масса нетто 430 г, дата изготовления 16.01.2022, годен до 16.06.2022, хранить при температуре от +20°С до +25°С и относительной влажности воздуха не более 85% (отобрано от партии 40 упаковок), изготовитель АО «КБК «Черемушки», Россия, г. Москва, не соответствует установленным требованиям по содержанию бензойной кислоты в составе продукта.
Печенье-сэндвич «Кот Федот» с какао с ванильно-сливочным вкусом и ароматом

штриховой код 4603657015395, дата изготовления 16.02.2022, срок годности 6 месяцев (отобрано от партии 1,8 кг), изготовитель ООО «Услада», Россия, Самарская обл., г.Жигулевск, ул. Морквашинская, 36, не соответствует установленным требованиям в связи с отсутствием сведений на маркировке продукции о наличии в составе синтетических красителей Жёлтый «Солнечный закат» Е110, Тартразин Е102, Азорубин Е122.
Свекла ранняя свежая

урожай 2022 года, дата упаковывания 09.04.2022, срок годности 90 суток с даты упаковывания, хранить при температуре от +2°С до +3°С и относительной влажности воздуха от 90% до 95% (отобрано от партии 24,5 кг), изготовитель и упаковщик ООО«Musaevs Exim Consulting», Республика Узбекистан, г. Ташкент, ул. Буюк Турон, д. 42, оф.1615, не соответствует установленным требованиям по содержанию нитратов.
Грецкий орех ядра торговой марки «Белый пеликан»

в термоспаянной полимерной упаковке, масса нетто 70 г, штриховой код 4811028000103, дата изготовления 18.05.2021, дата упаковывания 23.08.2021, срок годности до 18.05.2022 (отобрано от партии 8,4 кг), изготовитель ООО «НАТСИ», Украина, 89422, с. Минай, ул. Можайского, 12, не соответствует установленным требованиям по микробиологическим показателям (обнаружены БГКП (колиформы)).
Полуфабрикат мясосодержащий рубленый фаршированный категории «В» замороженный «Голубцы «По-домашнему»

в ящиках из гофрированного картона массой нетто по 5,0 кг, штриховой код 4812787010990, номер партии 2844, дата изготовления 30.03.2022, годен до 30.09.2022, продукт до и после вскрытия упаковки хранить при температуре не выше (-18)°С (отобрано от партии 7,52 кг), ООО «ПЗП «ЭЛИКА»», Россия, Московская область, г. Электрогорск, проезд Мечникова, д. 2, не соответствует установленным требованиям по микробиологическим показателям (обнаружена L.monocytogenes).
Йогурт фруктовый со вкусом «Ягодное мороженое» торговой марки «Мое любимое Чудо»

массовая доля жира 2,4%, масса нетто 270 г, дата изготовления 24.03.2022, годен до 03.05.2022, штриховой код 4690228033001, хранить при температуре от +2ºС до +6ºС до и после вскрытия (отобрано от партии 6 штук), изготовитель АО «ВБД», Россия, г. Москва, Дмитровское ш., д. 108, не соответствует установленным требованиям по микробиологическим показателям (обнаружены дрожжи).
Информацию подготовила помощник врача-гигиениста Ошмянского районного ЦГЭ Михайлова Анна Сергеевна
02.06.2022
В целях защиты внутреннего рынка от небезопасной и некачественной продукции санитарно-эпидемиологической службой Республики Беларусь продолжаются мероприятия технического (технологического, поверочного) характера по отбору проб и образцов пищевой продукции, находящейся в реализации.
По результатам испытаний выявлена пищевая продукция, несоответствующая санитарно-эпидемиологическим требованиям:
Каша сухая молочная быстрорастворимая овсяная с грушей и бананом, с бифидобактериями, обогащенная витаминами и минеральными веществами для питания детей раннего возраста с 6 месяцев «NESTLE», СТО 96436727-031-2019, продукт упакован в модифицированной атмосфере с азотом, в пакете Дой-Пак, масса нетто 220 г, дата изготовления 11.02.2022 03:50, годен до 07.05.2023, штриховой код 4600680005249, номер партии 2042167811, изготовитель ООО «Нестле Россия», Россия, г. Москва, Павелецкая пл., д. 2, стр. 1 (филиал в Вологде: Россия, 160010, Вологда, ул. Михаила Поповича, д. 4а), не соответствует установленным требованиям по микробиологическому показателю (обнаружены КМАФАнМ).
Виноград сушеный коричневый 2-ой сорт, масса нетто 10,00 кг, дата изготовления 02.2022, срок годности 02.2023, партия № 28/2022 (отобрано от партии 60 кг), изготовитель ИП ООО «SAMRIN TRADE», Республика Узбекистан, Самаркандская область, Самаркандский район, село Дашти сухта, не соответствует установленным требованиям по микробиологическому показателю (обнаружены «плесени», КМАФАнМ).
Свекла свежая столовая, в полипропиленовом мешке, урожай 2021 г, дата упаковывания 13.04.2022, срок годности 90 суток с даты упаковывания, условия хранения – хранить при температуре от 0°С до 1°С и относительной влажности от 90%, до 95 % (отбор проб произведен от партии 924,2 кг), изготовитель ООО «ABU-BAKIR-GOLD», Республика Узбекистан, Сурхондарё вилояти, Кизирик тумани, Богбонлар юрти махалласи, не соответствует установленным требованиям по содержанию нитратов.
Свекла ранняя столовая свежая, урожай 2022, дата упаковывания 09.04.2022, срок годности 90 суток с даты упаковывания, условия хранения - от +2°С до +3°С и относительной влажности воздуха от 90% до 95% (отобрано от партии 26 кг), изготовитель ООО «MARJONA DIYOR TEKSTIL»», Республика Узбекистан, Самаркандская область, Самаркандский район, Куштамгали КФИ, не соответствует установленным требованиям по содержанию нитратов.
Курага индустриальная, в полимерной (полипропиленовой) запаянной упаковке, масса нетто 200 г, штриховой код 4810948007322, дата изготовления 01.2022 г., дата упаковывания 09.02.2022 г., годен до 01.01.2023 г., упаковано по ТУ BY 690269922.002, хранить при температуре не выше 25°С и относительной влажности воздуха не более 75 % (партия в количестве 30 шт. (упаковок) по 200 г общей массой 6,0 кг), изготовитель ООО «СУБХИ ВАТАН», Республика Таджикистан, Согдийская область, г. Исфара, ул. Хонобод, не соответствует установленным требованиям по показателю «массовая доля сернистой кислоты (диоксид серы) и её солей (в пересчете на диоксид серы).
В целях обеспечения санитарно-эпидемиологического благополучия населения и недопущения к реализации пищевой продукции, представляющей потенциальную опасность для здоровья людей информируем:
Картофель фри волнистый «По-домашнему» замороженный

- в пакете из полимерных материалов массой нетто 10 кг, дата изготовления 09.12.2021, годен до 09.12.2023, штриховой код 901828007620, № партии L4 343 1B.
- Изготовитель Przedsiebiorstwo Przemyslu Chlodniczego «FRITAR», S.A., 33-102, Tarnow, ul. Sadowa 29, Республика Польша. Импортер в Республику Беларусь СП «Санта Импэкс Брест» ООО, Республика Беларусь, 224004, г. Брест, ул. Катин Бор, 106А.
- Не соответствует требованиям ГН, утвержденного постановлением Министерства здравоохранения Республики Беларусь 21.06.2013 № 52, ГН, утвержденного постановлением Совета Министров Республики Беларусь от 25.01.2021 № 37, ТР ТС 021/2011, утвержденного Решением Комиссии Таможенного союза от 09.12.2011 № 880 по физико - химическому показателю.
Зернистая икра. Икра Горбуши «Совьет»

- в жестяной банке массой нетто 95 г, дата изготовления 06.12.2021, годен до 04.06.2022,
- Не соответствует требованиям ГН, утвержденного постановлением Министерства здравоохранения Республики Беларусь 21.06.2013 № 52,
- ГН, утвержденного постановлением Совета Министров Республики Беларусь от 25.01.2021 № 37, ТР ТС 021/2011, утвержденного Решением Комиссии Таможенного союза от 09.12.2011 № 880 по микробиологическим показателям.
Морковь столовая, сорт –мананта
- ГОСТ 33540-2015, Дата расфасовки 08.04.2022, урожай 2021, упаковано в овощную сетку,
- Изготовитель Крестьянское хозяйство «Мирковский Петра Генриховича Минская область, Смолевичский район», 222220, п. Октябрьский, ул. Центральная, 25,
- Не соответствует требованиям Санитарных норм и правил, ГН, утвержденных постановлением Министерства здравоохранения Республики Беларусь 21.06.2013 № 52, ТР ТС 021/2011, утвержденного Решением Комиссии Таможенного союза от 09.12.2011 № 880 по показателю нитраты.
Информацию подготовила помощник врача-гигиениста Ошмянского районного ЦГЭ Михайлова Анна Сергеевна
26.04.2022

Государственное учреждение «Ошмянский районный ЦГЭ» информирует, что Главным государственным инспектором Республики Беларусь по надзору за соблюдением технических регламентов:
1) запрещен ввоз и обращение опасной продукции, прекращены действия на территории Республики Беларусь документов об оценке соответствия:
Мороженое двухслойное мраморное с заменителем молочного жира с ароматом ванили и шоколадное с вишневым джемом «Вишня в шоколаде» с маркировкой «Бодрая корова», в упаковке из полимерных материалов масса нетто 185 г, массовая доля жира: с ароматом ванили – 8 %, в том числе растительного жира 4 %; шоколадное – 8 %, СТО 01444041-002-2008, дата изготовления 30.09.2021, срок годности 15 месяцев; мороженое с заменителем молочного жира с джемом киви – «Киви» с маркировкой «Бодрая Корова», в упаковке из полимерных материалов, масса нетто 185 г, массовая доля жира 3,5 % в том числе растительного жира 1,75%, СТО 01444041-002-2008, дата изготовления 10.08.2021, срок годности 15 месяцев; мороженое с заменителем молочного жира с черносмородиновым наполнителем в вафельном стаканчике – «Вертушка» с маркировкой «Бодрая Корова», в упаковке из полимерных материалов, масса нетто 100 г, массовая доля жира 8 %, в том числе растительного жира 4 %, СТО 01444041-002-2008, дата изготовления 14.10.2021, срок годности 15 месяцев, изготовитель АО «Белгородский хладокомбинат», Российская Федерация, Белгородская область, г. Белгород (импортер в Республику Беларусь ООО «Нордар», г. Борисоов) - не соответствуют ТР ТС 021/2011, ТР ТС 022/2011, ТР ТС 033/2013 по физико-химическому показателю: фактически, по результатам испытаний, массовая доля молочного жира от общего содержания жира составила: 5,5 % для мороженого двухслойного мраморного с заменителем молочного жира с ароматом ванили и шоколадного с вишневым джемом - «Вишня в шоколаде», что свидетельствует о замещении молочного жира его заменителем в количестве 94,5%, при норме замещения не более 50 %; 2,3 % для мороженого с заменителем молочного жира с джемом - «Киви», что свидетельствует о замещении молочного жира его заменителем в количестве 97,7 %; 5,2 % для мороженого с заменителем молочного жира с черносмородиновым наполнителем в вафельном стаканчике - «Вертушка», что свидетельствует о замещении молочного жира его заменителем в количестве 94,8 %; заниженное значение показателя «массовая доля молочного жира в жировой фазе продукта» не позволяет идентифицировать мороженое с заменителем молочного жира как молокосодержащий продукт с заменителем молочного жира, вводит потребителя в заблуждение относительно вида пищевой продукции, которой изготовитель умышленно придал внешний вид и отдельные свойства молокосодержащего продукта с заменителем молочного жира, но при этом она не может быть идентифицирована как продукция, за которую выдается (предписание о запрете ввоза и обращения опасной продукции, прекращении действия на территории Республики Беларусь документов об оценке соответствия, об изъятии (отзыве из обращения) продукции от 13.04.2022 № 06-11-123/363; прекращено действие на территории Республики Беларусь декларации о соответствии ЕАЭС N RU Д– RU.РА01.В.63861/20) - с 20.04.2022.
Конфеты Turkish MEVLANA CANDY со вкусом лесные ягоды торговой марки «SAVALAN», в упаковке из полимерных материалов, масса нетто 180 г, дата изготовления 28.10.2021, годен до 28.10.2022, изготовитель ООО «Ставропольский сахарный завод», Российская Федерация, г. Ставрополь (поставщик в Республику Беларусь ООО «Оптифудбел», г. Гомель) - не соответствуют ТР ТС 021/2011, ТР ТС 022/2011, ТР ТС 029/2012 по безопасности и маркировке: в части предоставления достоверной информации о составе продукта и отсутствию предупреждающей надписи красителей, влияющих на активность и внимание детей; фактически в состав продукта входят, обнаруженные в результате проведенных испытаний, незаявленные изготовителем в маркировке, синтетические красители: поннсо 4R (E124) в количестве 49,2 мг/кг, желтый «Солнечный закат» FCF (E110) в количестве 26,7 мг/кг, тартразин (Е102) в количестве 100,9 мг/кг; в маркировке продукции отсутствует предупреждающая надпись «Содержит красители, которые могут оказывать отрицательное влияние на активность и внимание детей» (предписание о запрете ввоза и обращения опасной продукции, прекращении действия на территории Республики Беларусь документов об оценке соответствия, об изъятии (отзыве из обращения) продукции от 13.04.2022 № 06-11-123/365; прекращено действие на территории Республики Беларусь декларации о соответствии ЕАЭС N RU Д– RU.НВ45.В.02314/20) - с 20.04.2022.
2) прекращены действия на территории Республики Беларусь документов об оценке соответствия:
Пряники заварные с начинкой глазированные «Со вкусом банана», дата изготовления 13.01.2022, срок годности 60 суток, изготовитель ИП Манукян А.М., Российская Федерация (поставщик в Республику Беларусь ООО «Вельми смачна», г. Минск) - не соответствуют ТР ТС 021/2011, ТР ТС 022/2011, ТР ТС 029/2012 по безопасности и маркировке (предписание о прекращении действия на территории Республики Беларусь документов об оценке соответствия от 13.04.2022 № 06-11-2/364; прекращено действие на территории Республики Беларусь декларации о соответствии ЕАЭС N RU Д– RU.РА02.B.69373/21) - с 20.04.2022.
Информацию подготовила помощник врача-гигиениста Ошмянского районного ЦГЭ Михайлова Анна Сергеевна
26.04.2022
В целях обеспечения санитарно-эпидемиологического благополучия населения и недопущения к реализации пищевой продукции, представляющей потенциальную опасность для здоровья людей информируем:
Грецкий орех ядра, торговой марки «Белый пеликан»

- ТУ РБ 100523831.001-2003,
- масса нетто 70 г, дата изготовления 08.09.2021, дата упаковки 05.10.2021, годен до 05.07.2022,
- штриховой код 4811028000103, продукция упакована в полимерную упаковку, запаяна термошвом,
- Изготовитель ООО «НАТСИ», Украина, село Минай, 89422, ул. Можайского, 12. Упаковщик ООО «Детави», г. Минск, 220138, пер. 2-й Велосипедный, д. 32 офис 9, адрес производства Минская область,223049, Минский район, Щомыслицкий сельский совет, строение 16/2,. промзона ТЭЦ-4.
- Не соответствует требованиям ГН, утвержденных постановлением Совета Министров Республики Беларусь от 25.01.2021 № 37, ГН, утвержденной постановлением Министерства здравоохранения Республики Беларусь 21.06.2013 № 52, ТР ТС 021/2011, утвержденного Решением Комиссии Таможенного союза от 09.12.2011 № 880 по микробиологическому показателю.
Приправа сухая «Хмели - сунели»

- масса 50 г, дата изготовления 25.08.2021, годен до 25.08.2023, штриховой код 4814957002149,
- Изготовитель ЧУП «Пряный Дом»,Минская область, 222518, Борисовский район, г. Борисов, ул. Демина, 23Б.
- Не соответствует требованиям ГН, утвержденной постановлением Совета Министров Республики Беларусь от 25.01.2021 № 37, ГН, утвержденного постановлением Министерства здравоохранения Республики Беларусь 21.06.2013 № 52,
- ТР ТС 021/2011, утвержденного Решением Комиссии Таможенного союза от 09.12.2011 № 880 по микробиологическому показателю.
Информацию подготовила помощник врача-гигиениста Ошмянского районного ЦГЭ Михайлова Анна Сергеевна
22.04.2022
В целях обеспечения санитарно-эпидемиологического благополучия населения и недопущения к реализации пищевой продукции, представляющей потенциальную опасность для здоровья людей информируем:
Свекла столовая свежая

- урожай 2022, дата упаковывания 17.03.2022 г, срок годности 60 суток с даты упаковывания,
- Изготовитель OОO «MAVERAN GARDEN», Узбекистан, 100020, г. Ташкент, Алмазарский район, ул. Беруний 83. Импортер ООО «ЭплТИР», Республика Беларусь, г. Минск, ул. Прушинских, 31А-58.
- Не соответствует требованиям ГН, утвержденного постановлением Министерства здравоохранения Республики Беларусь 21.06.2013 № 52, ГН, утвержденного постановлением Совета Министров Республики Беларусь от 25.01.2021 № 37, ТР ТС 021/2011, утвержденного Решением Комиссии Таможенного союза от 09.12.2011 № 880 по показателю «массовая доля нитратов».
Икорное рыбное изделие. Икра сельди тихоокеанской «Икра деликатесная» в крем соусе с ароматом копчения. Непастеризованная.

- ТУ 10.20.26-010-26180181-2018, в стеклянной банке, масса нетто 170 г,
- штриховой код 4640057671240, дата изготовления 19.11.2021, срок годности 19.05.2022.
- Изготовитель ООО «Лунское море», Российская Федерация, 684010, Камчатский край, Елизовский район, пос. Нагорный, тер. Птицефабрика Восточная,Адрес производстваРоссийская Федерация, Нижегородская область, г. Нижний Новгород, ул. Кима, 337.Поставщик в Республику БеларусьООО «Белое море», г. Минск, ул. Аэродромная, д. 125, 29А.
- Не соответствует требованиям Санитарных норм и правил, ГН, утвержденных постановлением Министерства здравоохранения Республики Беларусь от 12.12.2012 № 195, ТР ТС 029/2012, принятого Решением Совета Евразийской экономической комиссии от 20.07.2012 № 58 по показателю «сорбиновая кислота в комбинации с бензойной кислотой».
Конфеты из молочного шоколада с молочно-ореховой начинкой Kinder Schoko - Bons, торговой марки «Kinder»

- масса нетто 125 г, дата изготовления 10.2021, годен до 09.06.2022, штриховой код 5413548280189, номер партии L285R03---/110A, DM 75242812,
- Изготовитель Ferrero Ardennes S.A, rue Pietro Ferrero, 5, B-6700 Arlon, Бельгия. Поставщик в Республику Беларусь ООО «Альфа-Дистрибьюция», г. Минск, 220082, ул. Матусевича, д. 20, пом. 12/1.
- Не соответствует требованиям ГН, утв. постановлением Совета Министров Республики Беларусь от 25.01.2021 № 37, ТР ТС 021/2011, утвержденного Решением Комиссии Таможенного союза от 09.12.2011 № 880 по микробиологическому показателю.
Информацию подготовила помощник врача-гигиениста Ошмянского районного ЦГЭ Михайлова Анна Сергеевна
22.04.2022
В целях обеспечения санитарно-эпидемиологического благополучия населения и недопущения к реализации пищевой продукции, представляющей потенциальную опасность для здоровья людей информируем:
Рыбный кулинарный полуфабрикат: палочки из фарша рыбного в панировке обжаренные, замороженные VICI, дата изготовления 12.01.2022, годен до 12.01.2024, штриховой код 4770190036627, изготовитель ООО «Вичюнай — Русь», Российская Федерация, Калининградская область, г. Советск, ул. Маяковского, 1; поставщик в Республику Беларусь иностранное унитарное предприятие ООО «ЭкоФорт», Минская область, Минский р-н, Михановичский с/с 58 — не соответствует требованиям по микробиологическим показателям (обнаружена Listeria monocytogenes).
Смесь компотная пятикомпонентная новая, ТУ ВУ 690605560.003-2012, упакована в полимерную (полипропиленовую) упаковку, дата изготовления 25.01.2022, срок годности 18.10.2022, изготовитель ООО «МАРКЕТ МАСТЕР», Минская область, 222201, г. Смолевичи, ул. Промышленная, д. 3, каб. 21; изготовлено по заказу ООО «АНДИВАЛ ГРУПП», г. Молодечно, 222310, ул. Либаво-Роменская, 54, каб. 24-25 — не соответствует требованиям (обнаружены плесень, КМАФАнМ).
Приправа весенняя – сушеная смесь специй «Avokado», масса нетто 160 г, дата изготовления 20.10.2021, годен до 20.10.2024, штриховой код 8595012061085, изготовитель Примат ООО/Prymat sp.zo.o/Примат ТзОВ, ul. Chlebowa 14, 44-337 Jastrzebie-Zdroj, Польша; импортер в Республику Беларусь ООО «АРШСОЛЬ», г. Минск, ул. П. Мстиславца, 13-275 — не соответствует требованиям по микробиологическим показателям (обнаружены БГКП).
Информацию подготовила помощник врача-гигиениста Ошмянского районного ЦГЭ Михайлова Анна Сергеевна
20.04.2022
В целях обеспечения санитарно-эпидемиологического благополучия населения и недопущения к реализации пищевой продукции, представляющей потенциальную опасность для здоровья людей информируем:
Медовуха «Double Tree» («Дабл Три») гранат.

- Изготовитель ООО «ФОЛЬКСБРАУ РУС», Российская Федерация Московская область, г. Химки, Вашутинское шоссе, влад. 4Б, пом. 002.
- Поставщик в Республику Беларусь ООО «ПТЛК», г. Минск, пер. Липковский, д. 34, каб. 162, изолированное помещение 6.
- Не соответствует требованиям Санитарных норм и правил от 12.12.2012 № 195, ТР ТС 029/2012, по маркировке.
Щука обыкновенная «Каспийская» соломка. Вяленая пищевая рыбная продукция

- масса нетто 500 г, партия масса нетто 500 г,
- дата изготовления 27.01.2022, годен до 27.07.2022,
- штриховой код 4607148873761, партия 091011.
- Изготовитель ООО «Синтез-Ресурс», Российская Федерация, г. Санкт Петербург, ул. Садовая, д. 12, лит А, пом. 30-н, часть офиса 9, адрес места осуществления деятельности по изготовлению продукции Российская Федерация, Ленинградская область, Гатчинский район, п. Пудость, ул. Новая, д. 49.
- Поставщик в Республику Беларусь: ООО «Аниксторг», г. Минск, ул. Лазо, д. 14, каб. 2-9.
- Не соответствует требованиям Санитарных норм и правил от 12.12.2012 № 195, ТР ТС 029/2012, по массовой доле бензойной кислоты.
Курага Индустриальная «Shalu»

- ТУ ВУ 690269922.002, упаковка –полимерный пакет по 500 г,
- штриховый код 4810948009173, дата изготовления 11.2021,
- дата упаковывания 15.12.2021, годен до 01.01.2023.
- Изготовитель ООО «СУБХИ ВАТАН», Республика Таджикистан, Согдийская область, г. Исфара, ул. Хонобод.
- Поставщик в Республику Беларусь ЧП «Шалу», Минская область, 223053, Минский район, Щомыслицкий с/с, аг. Озерцо, ул. Центральная, д.35А, пом. 25.
Информацию подготовила помощник врача-гигиениста Ошмянского районного ЦГЭ Михайлова Анна Сергеевна
20.04.2022

Ошмянский районный ЦГЭ сообщает о прекращении действия свидетельств о государственной регистрации.
Комитетом санитарно-эпидемиологического контроля Министерства Здравоохранения Республики Казахстан от 30.03.2022 № 24-02-24/518-и прекращены действия свидетельств о государственной регистрации:
№ KZ.16.01.79.005.E.004908.09.15 от 18.09.2015 – детское питание: Низколактозная сухая молочная смесь с пребиотиками «HUMANA HN». Изготовитель: «Humana GmbH», г. Херфорд, Билефельдер штрассе, 66;
№ KZ.16.01.98.003.E.000884.10.19 от 11.10.2019 – биологически активная добавка к пище SACCHAROMYCES BOULARDII (Балк-продукт). Изготовитель: Hedelab S.A. Route de Wallonie, nº138, B-7011 Ghlin, Belgium, Бельгия;
№ KZ.16.01.98.003.E.000381.05.20 от 29.05.2020 – биологически активная добавка к пище SACCHAROMYCES BOULARDII (Балк-продукт). Изготовитель: Hedelab S.A. Route de Wallonie, nº138/140, B-7011 Ghlin, Belgium, Бельгия;
№ KZ.16.01.98.003.E.000467.06.20 от 22.06.2020 – биологически активная добавка к пище БИО-Сорб БУЛАРДИ MSP®, капсулы, №30. Изготовитель: Hedelab S.A. Route de Wallonie, nº138/140, B-7011 Ghlin, Belgium, Бельгия; упаковщик: ТОО «КФК МЕДСЕРВИС ПЛЮС», 050004, г. Алматы, Алмалинский район, ул. Маметовой, д. 54.
Информацию подготовила помощник врача-гигиениста Ошмянского районного ЦГЭ Михайлова Анна Сергеевна
21.04.2022
В целях обеспечения санитарно-эпидемиологического благополучия населения и недопущения к реализации пищевой продукции, представляющей потенциальную опасность для здоровья людей информируем:
Манго сушеное

-
дата изготовления 01.01.2022, срок годности 01.01.2023.
-
Изготовитель «99 Gold Data Processing Traiding Company Limited», Социалистическая Республика Въетнам.
-
Импортер в Республику Беларусь ООО «Караван ХХІ век», Минский район, д. Королев Стан, ул. Заречная, 14а, каб. 5.
-
Не соответствует требованиям Санитарных норм и правил, ГН, утвержденного постановлением Министерства здравоохранения Республики Беларусь от 12.12.2012 № 195, ТР ТС 029/2012, принятого Решением Совета Евразийской экономической комиссии от 20.07.2012 № 58 по маркировке.
Сушеное манго с маркировкой Asia Fruit

-
дата изготовления 30.11.2021, срок годности 12 месяцев,
-
Изготовитель «RICHFARM ASIA CO., LTD», N68, ST. Borey Premier Land, Village Bayab, Sangkat Phnom Penh Thmey, Khan Sensok, Phnom Penh, Камбоджа.
-
Импортер в Республику Беларусь «Дубай орехи и сухофрукты», г. Минск, ул. Восточная, 133, пом. 5Н-3.,
-
Не соответствует требованиям Санитарных норм и правил, ГН, утвержденного постановлением Министерства здравоохранения Республики Беларусь от 12.12.2012 № 195, ТР ТС 029/2012, принятого Решением Совета Евразийской экономической комиссии от 20.07.2012 № 58 по маркировке.
Икорное рыбное изделие. Икра сельди тихоокеанской «Икра деликатесная» в крем соусе с ароматом копчения. Непастеризованная

-
ТУ 10.20.26-010-26180181-2018,
-
в стеклянной банке с металлической крышкой, масса нетто 170 г, штриховой код 4640057671240,
-
дата изготовления 11.12.2021, срок годности 11.06.2022, условия хранения – хранить при температуре от -2°С до 4°С
-
Изготовитель ООО «Лунское море», Российская Федерация, 684010, Камчатский край, Елизовский район, пос. Нагорный, тер. Птицефабрика Восточная, Адрес производства Российская Федерация, Нижегородская область, г. Нижний Новгород, ул. Кима, 337. Поставщик в Республику Беларусь ООО «Белое море», г. Минск, ул. Аэродромная, д. 125, пом. 29А.
-
Не соответствует требованиям ГН, утвержденного постановлением Министерства здравоохранения Республики Беларусь от 12.12.2012 № 195, ГН, утвержденного постановлением Совета Министров Республики Беларусь от 25.01.2021 № 37, ТР ТС 029/2012, принятого Решением Совета Евразийской экономической комиссии от 20.07.2012 № 58 по массовой доле сорбиновой и бензойной кислот и их солей при их комбинированном применении
Свекла столовая свежая

-
урожай 2021 года, дата упаковывания 05.03.2022, срок годности 90 суток с даты упаковывания, номер партии 48343,
-
Изготовитель ООО «ABU-BAKIR-GOLD», Узбекистан, Сурхондарё вилояти, Кизирик тумани,Богбонлар юрти махалласи, Узбекистан. Импортер в Республику Беларусь ООО «Фрутреал», Витебская область, г. Полоцк, ул. Октябрьская, 25/1-6, ком. 17,
-
Не соответствует требованиям ГН, утвержденного постановлением Совета Министров Республики Беларусь от 25.01.2021 № 37, ГН утвержденного постановлением Министерства здравоохранения Республики Беларусь 21.06.2013 № 52, ТР ТС 021/2011, утв. Решением Комиссии Таможенного союза от 09.12.2011 № 880 по массовой доле нитратов.
Рыбные консервы из печени рыб стерилизованные: «Печень трески атлантической по-мурмански» (тонкоизмельченная)

-
Масса нетто 0,240 кг, дата изготовления 19.05.2021, срок годности 24 месяца,
-
ГОСТ 13272-2009, штриховой код 4650056310330,
-
Изготовитель ООО «Владимирский консервный завод» (ООО «Владкон»), Российская Федерация, Владимирская область, Собинский район, г. Лакинск, проспект Ленина, 71. Поставщик в Республику Беларусь ООО «Дисконт фиш», Минская область, г. Жодино, ул. Кузнечная, 16, комн.4/7.
-
Не соответствует требованиям Санитарных норм и правил, ГН утв. постановлением Министерства здравоохранения Республики Беларусь за 21.06.2013 № 52, ГН, утв. постановлением Совета Министров Республики Беларусь от 25.01.2021 № 37, ТР ЕАЭС 040/2016, принятого Решением Совета Евразийской экономической комиссии от 18.10.2016 № 162 по органолептическим показателям: запах – с неприятным запахом.
Информацию подготовила помощник врача-гигиениста Ошмянского районного ЦГЭ Михайлова Анна Сергеевна
13.04.2022
В целях обеспечения санитарно-эпидемиологического благополучия населения и недопущения к реализации пищевой продукции, представляющей потенциальную опасность для здоровья людей информируем:
Бразильский орех очищенный

-
Дата изготовления 08.2020, годен до 08.2022, упакованный в картонную коробку, массой нетто 20 кг.
-
Изготовитель Corporaction Agroindustrial Amazonas S.A., Avenida Heroes Del Chaco No. 488 Barrio 25 de Marzo, Riberalta, Beni, Боливия, Многонациональное Государство.
-
Импортер в Республику Беларусь ООО «Евроторг», 220099, г. Минск, ул. Казинца, 52-А-22.
-
Не соответствует требованиям ГН, утвержденных Постановлением Министерства здравоохранения Республики Беларусь от 21.06.2013 № 52, ГН, утвержденного постановлением Совета Министров Республики Беларусь от 25.01.2022 № 37, ТР ТС 021/2011, утвержденного Решением Комиссии Таможенного союза от 09.12.2011 № 880 по микробиологическому показателю.
Чернослив сушеный «Венгерка» без косточки торговой марки «Царские»

-
В потребительской упаковке массой нетто 90 г, штриховой код 4813635001788, дата изготовления 27.10.2021, дата упаковывания 11.01.2022, срок годности 27.10.2022, хранить при температуре от +5°С до +20°С и относительной влажности воздуха не более 70%, номером партии является дата упаковывания.
-
Изготовитель ООО «BULUNG UR GOLD FRUITS», Республика Узбекистан Самаркандская область, Булунгурский район, село Кулчабий, ул. Кунгирот.
-
Импортер в Республику Беларусь ООО «Фрутреал», Витебская область, г. Полоцк, ул. Октябрьская, д.25/1-6, комн. 17.
-
Не соответствует требованиям ГН, утвержденных Постановлением Министерства здравоохранения Республики Беларусь от 21.06.2013 № 52, ГН, утвержденного постановлением Совета Министров Республики Беларусь от 25.01.2021 № 37, ТР ТС 021/2011, утвержденного Решением Комиссии Таможенного союза от 09.12.2011 № 880 по микробиологическим показателям.
Рыбные консервы из печени рыб стерилизованные: «Печень трески атлантическая по-мурмански»

-
ГОСТ 13272-2009, масса 0,240 кг,
-
дата изготовления 11.05.2021, срок годности 24 месяца, штриховой код 4650056310330.
-
Изготовитель Л-32 ООО «Владимирский консервный завод», Российская Федерация, Владимирская область, Собинский район, г. Лакинск, пр. Ленина, 71, оф. 10.Изготовлено по заказу ООО «ВАТЕРВЕЙС», Российская Федерация, г. Москва, ул. Зюзинская, 6/2, пом. XV, ком. 25.
-
Поставщик в Республику Беларусь ЧП «Мастерфуд», Минская область, Логойский р-н, г. Логойск, ул. Победы, 86, корпус 4.
-
Не соответствует требованиям Санитарных норм и правил, ГН, утвержденных Постановлением Министерства здравоохранения Республики Беларусь от 21.06.2013 № 52, ТР ЕАЭС 040/2016, утвержденного Решением Совета Евразийской экономической комиссии от 18.10.2016 № 162 по органолептическим показателям.
Приправа для курицы «SPICE EXPERT»

-
TS 25098431-01:2016, упакована в потребительскую упаковку бумажную,
-
дата изготовления 21.02.2021, срок годности 24 месяца масса нетто 15 г,штриховой код 4780048900208.
-
Изготовитель ООО «SPICE EXPERT», Узбекистан, г. Ташкент, ул. Богишамол, 160.
-
Импортер в Республику Беларусь ООО «Первая торгово- логистическая компания», Минская область, Минский р-н, Боровлянский с/с, 81-1в, каб. 14, р-н д. Дроздово.
-
Не соответствует требованиям ГН, утвержденных Постановлением Министерства здравоохранения Республики Беларусь от 21.06.2013 № 52, ГН, утвержденного постановлением Совета Министров Республики Беларусь от 25.01.2021 № 37, ТР ТС 021/2011, утвержденного Решением Комиссии Таможенного союза от 09.12.2011 № 880 по микробиологическим показателям.
Свекла столовая свежая

-
ГОСТ 32285-2013, ГОСТ 1722-85, урожай 2021 г, условия хранения и срок годности – хранить при температуре от 0°С до +1°С и относительной влажности 90% -95% 6-8 месяцев, хранившаяся в деревянных коробах .
-
Изготовитель КУП «Минская овощная фабрика», Минская область, Минский район, п.о Тростенец. Упаковщик/отправитель ООО ПК «Садком», г. Старые дороги, ул. Кирова, 149 ООО «Производственная компания «Садком» расположенный по адресу: г. Старые Дороги, ул. Кирова, 149 (юридический адрес: 222932, г. Старые Дороги, ул. Кирова, 149).
-
Не соответствует требованиям Санитарных норм и правил, ГН, утвержденных Постановлением Министерства здравоохранения Республики Беларусь от 21.06.2013 № 52 по содержанию нитратов.
Икорное рыбное изделие. Икра сельди тихоокеанской «Икра деликатесная в крем-соусе с ароматом креветки. Непастеризованная

-
ТУ 10.20.26-010-261801812018, в стеклянной банке с металлической крышкой, масса нетто 170 г, дата изготовления 12.12.2021, годен до 12.06.2022, штриховой код 4640057671233, условия хранения – хранить при температуре от -2°С до +4°С.
-
Изготовитель: ООО «Лунское море», Российская Федерация, 684010, Камчатский край, Елизовский район, пос. Нагорный, тер. Птицефабрика Восточная, адрес производства Российская Федерация, 603038, Нижегородская область, г. Нижний Новгород, ул. Кима, 337.
-
Поставщик в Республику Беларусь ООО «Белое море», г. Минск, ул. Аэродромная, д. 125, пом. 29А).
-
Не соответствует требованиям ГН утвержденных постановлением Министерства здравоохранения Республики Беларусь от 12.12.2012 № 195, ГН, утвержденных постановлением Совета Министров Республики Беларусь от 25.01.2021 №37, ТР ТС 029/2012, утвержденного решением Совета Евразийской экономической комиссии от 20.07.2012 г № 58 по массовой доле сорбиновой и бензойной кислот и их солей при их комбинированном применении.
Информацию подготовила помощник врача-гигиениста Ошмянского районного ЦГЭ Михайлова Анна Сергеевна
11.04.2022
В целях обеспечения санитарно-эпидемиологического благополучия населения и недопущения к реализации пищевой продукции, представляющей потенциальную опасность для здоровья людей информируем:
Полуфабрикаты рубленные из мяса птицы. Котлеты «По-домашнему» замороженные

-
СТО 52902019-005-2013, штриховой код (01)4607145772012(17)220430,
-
дата изготовления 22.11.2021, дата упаковывания 22.11.2021, срок годности при температуре минус 12°С до 3 месяцев,
-
изготовитель ООО «МПК Обнинский», Российская Федерация, Калужская обл., г. Обнинск, Киевское шоссе, д.33. Импортер в Республику Беларусь частное торговое унитарное предприятие «Желатофуд» (далее –ЧТУП «Желатофуд»), г. Могилев, пер. Гаражный, 4, офис 10.
-
Не соответствует требованиям Санитарных норм и правил, ГН утвержденных постановлением Министерства здравоохранения Республики Беларусь за 21.06.2013 № 52; ГН, утвержденного постановлением Совета Министров Республики Беларусь от 25.01.2021 № 37; ТР ТС 021/2011 утвержденного Решением Комиссии Таможенного союза 09.12.2011 № 880 по микробиологическому показателю: обнаружена Salmonella spp.
САМСА ЖАРЕНАЯ мясные кулинарные изделия рубленые в тесте замороженные

-
самса «Городецкая ферма», весовая, масса нетто 3,5 кг, в транспортной упаковке – картонной коробке,
-
ТУ10.13.14-019-83980784-2018,
-
дата выработки (изготовления) 13.01.2022, срок хранения (годности) при температуре при температуре не выше минус 18°С - 6 месяцев,
-
Изготовитель индивидуальный предприниматель Фуфина Наталья Викторовна, Российская Федерация, Нижегородская обл., Балахинский район, п. Большое Козино, в/ч 28274, д.5, кв.5; фактический адрес: Нижегородская обл., Городецкий район, г. Заволжье, ул. Лесозаводская, 7а. Импортер в Республику Беларусь ООО «ФрэшАйс», г. Минск, ул. Переходная, 66,пом.2, ком.1.
-
Не соответствует требованиям ГН, утвержденного постановлением Совета Министров Республики Беларусь от 25.01.2021 № 37 по микробиологическим показателям: фактическое содержание КМАФАнМ.
Чай зеленый байховый китайский «Принцесса Ява традиционный» в пакетах для разовой заварки

-
масса нетто 50 г (25 фильтр пакетов по 2 г упакованы в картонную коробку с защитной пленкой), дата изготовления 07.2021,
-
годен до конца 06.2024, штриховой код 4605246002229, ТУ 9191-001-39420178-97,
-
Изготовитель ООО «ОРИМИ», Российская Федерация, Ленинградская область, Всеволожский район, пос. им. Свердлова, 1, мкр, уч-к 15/4. Импортеры в Республику Беларусь: ООО «Тибетрэйд», г. Минск, ул. Уручская, д. 11а, оф.43; ООО «Альфа -Дистрибьюция», г. Минск, ул. Матусевича, д. 20, пом. 12/1;ООО «Евроторг», г. Минск, ул. Казинца, 52а-22.
-
Не соответствует требованиям ТР ТС 021/2011, утвержденного Решением Комиссии Таможенного союза 09.12.2011 № 880; ГН, утвержденных Постановлением Министерства здравоохранения Республики Беларусь от 21.06.2013 № 52; ГН, утвержденных постановлением Совета Министров Республики Беларусь от 25.01.2021 №37, по микробиологическому показателю: обнаружена «плесень».
Зефир «Сокол» с фруктовой начинкой с ароматом малины

-
масса нетто 3,5 кг, масса брутто 4,8 кг,
-
изготовлено и упаковано 16.01.2022, срок годности 3 месяца, штриховой код 14603513008216,
-
ТУ 9128-001-66080644-11, ГОСТ 64441-2014,
-
Изготовитель ООО «Кондитерская фабрика «Сокол», Российская Федерация, Московская обл., г. Дмитров, ул. Внуковская, 42, пом.3. Поставщик в Республику Беларусь ООО «Витрум плюс», Минская обл., Червенский р-н, Смиловичский с/с, аг. Заполье, ул. Садовая, 10, каб.17.
-
Не соответствует требованиям Санитарных норм и правил, ГН, утвержденных постановлением Министерства здравоохранения Республики Беларусь от 12.12.2012 № 195, ТР ТС 029/2012, принятого Решением Совета Евразийской экономической комиссии от 20.07.2012 № 58: отсутствует достоверная информация о составе на маркировке.
Арахис жареный солёный, классический «BEERka»

-
в полимерной потребительской упаковке массой нетто 30 г, ТУ 10.39.23-002-74955571-2005,
-
изготовлено и упаковано 08.01.2022, годен до 08.07.2022, номер смены (партии) 3Е, штриховой код 4607120854177,
-
изготовитель ЗАО «КДВ Павловский посад», 142505, Московская область, г.Павловский Посад, Мишутинское шоссе, д.4Б. Импортер в Республику Беларусь и грузоотправитель: ИТУП «КДВ БЕЛ», 220138, г. Минск, пер. Липковский, д.12, оф.205,
-
Не соответствует требованиям ТР ТС 021/2011 утвержденного Решением Комиссии Таможенного союза 09.12.2011 № 880;ГН утвержденного постановлением Министерства здравоохранения Республики Беларусь за 21.06.2013 № 52;ГН, утвержденного постановлением Совета Министров Республики Беларусь от 25.01.2021 № 37 по микробиологическому показателю: в 0,1 г обнаружены «БГКП».
Информацию подготовила помощник врача-гигиениста Ошмянского районного ЦГЭ Михайлова Анна Сергеевна
31.03.2022
В целях защиты внутреннего рынка от небезопасной и некачественной продукции санитарно-эпидемиологической службой Республики Беларусь продолжаются мероприятия технического (технологического, поверочного) характера по отбору проб и образцов пищевой продукции, находящейся в реализации.
По результатам испытаний выявлена пищевая продукция, несоответствующая санитарно-эпидемиологическим требованиям:
Мясосодержащие полуфабрикаты в тесте замороженные с мясосодержащей начинкой категории В хинкали «Кавказские», ТУ 9214-339- 01597945-03, упакованы в потребительскую упаковку массой нетто 700 г, штриховой код 4607048470626, дата изготовления 13.10.21, срок годности 6 месяцев при температуре не выше минус 18°С, изготовитель ИП Кузнецова Татьяна Васильевна, Российская Федерация, Нижегородская область, г. Дзержинск, ул. Бутлерова, д. 36, кв. 15; поставщик в Республику Беларусь ОДО «АЙСКИНГ», г. Минск, ул. П. Бровки, 30-29 - не соответствуют требованиям по микробиологическому показателю (обнаружены БГКП).
Смесь сухофруктовая компотная, весовая, упакована в мешок из полимерного материала, масса нетто 20 кг, дата изготовления 25.10.2021, срок годности до 25.10.2022 при температуре хранения от +50С до +200С и относительной влажности воздуха не более 70%, изготовитель ФЛП Владыка Елена Григорьевна, Украина, г. Одесса, ул. Космонавтов, 36, оф. 511; импортер в Республику Беларусь ООО «Фрутреал», Витебская область, г. Полоцк, ул. Октябрьская, д. 25/1-6, комната 17 - не соответствуют требованиям по микробиологическому показателю (обнаружено содержание плесени).
Чай черный байховый среднелистовой с мятой, торговая марка «Танай» («Танай-эко»), ТУ/ТШ 10.83.13-025-53137213-17, масса нетто 200 г., штриховой код 4032489109529, дата изготовления 28.10.2021, срок годности 24 месяца с даты изготовления, изготовитель ООО «Императорский чай», Российская Федерация, Московская область, г. Красногорск, р.п. Нахабино, ул. Вокзальная, д. 7; импортер в Республику Беларусь ООО «ВитебскПродукт Сервис», г. Витебск, пр-т Московский, д. 53, пом. № 4 - не соответствует требованиям по микробиологическим показателям (обнаружено содержание плесени).
Пряники мини «ALTERINI» с начинкой со вкусом сгущенного молока, масса нетто 0,38 кг, дата изготовления 16.08.2021, срок годности до 16.08.2022, изготовитель ИП Сажина Любовь Павловна, Российская Федерация, Воронежская область, г. Воронеж, ул. Октябрьская, д. 175; импортер в Республику Беларусь ООО «Альтерини», Минская область, Молодечненский район, около г.п. Радошковичи, здание с инв. № 630/С-42503, пом. № 2-7 - не соответствуют требованиям по микробиологическим показателям (обнаружены «БГКП»).
Чай черный «Daily Jov» - чабрец и мята, дата изготовления 11.12.2021, срок годности 24 месяца, штриховой код 4627151900162, изготовитель ООО «Микс Трейд», Российская Федерация, г. Москва, ул. Масловка Верхняя, д.23, кв. 41; поставщик на территорию в Республики Беларусь ООО «Бэст Прайс Экспорт», Российская Федерация, г. Москва, д. Шарапово, вблизи деревни складской корпус № 6 - не соответствует требованиям по микробиологическому показателю (обнаружено содержание плесени).
Манго сушеное (цукаты) Kong, в полимерной упаковке, масса нетто 500 г, дата изготовления 03.10.2021, срок годности 18 месяцев, штриховой код 4810948008558, изготовитель «Jinan Happy Forest со., ltd», N0.36 EAST UPPER DAPENG MARKET, NO 42 KING GUAN ZHUANG, SHIZHONG DIS-TRICT. JINAN CITY, SHANDONG PROVINCE, Китай; импортер ООО «Севафрукт», Минская область, Минский район, аг. Хотежино, ул. Центральная, дом 18 Б/1, к. 33 - не соответствует требованиям по содержанию «сернистой кислоты» (диоксид серы (Е220).
Помощник врача-гигиениста Ошмянского районного ЦГЭ Михайлова Анна Сергеевна
31.03.2022
В целях обеспечения санитарно-эпидемиологического благополучия населения и недопущения к реализации пищевой продукции, представляющей потенциальную опасность для здоровья людей:
Рыбные консервы натуральные стерилизованные сайра и сардина (иваси) тихоокеанские (куски), натуральные торговой марки «7 Морей.

-
ТУ 10.20.25-003-22738723 - 2019, штриховой код 4627201565051,
-
дата изготовления 23.08.2021 НАТ Л32 1Р, срок годности 24 месяца с даты изготовления,
-
Изготовитель ООО «Владимирский консервный завод», Российская Федерация, 601240, Владимирская область, Собинский район, г. Лакинск, пр-т Ленина, д. 71, офис 10, адрес места осуществления деятельности Российская Федерация, 601240, Владимирская область, Собинский район, г. Лакинск, пр-т Ленина, д. 7.
-
Поставщик в Республику Беларусь ООО «Евроторг», г.Минск, 220099, ул. Казинца, д. 52а, комн. 22.
-
Не соответствует требованиям Санитарных норм и правил, ГН утвержденных постановлением Министерства здравоохранения Республики Беларусь за 21.06.2013 № 52; ГН, утвержденного постановлением Совета Министров Республики Беларусь от 25.01.2021 № 37 по органолептическим показателям.
Грецкий орех ядра торговой марки «Белый пеликан» в термоспаянной полипропиленовой упаковке

-
масса нетто 70 г, дата изготовления 08.09.2021,дата упаковывания 06.12.2021, срок годности до 06.09.2022,
-
штриховой код 4811028000103,
-
Изготовитель ООО «НАТСИ», Украина, 89422, с. Минтай, ул. Можайского, 12.
-
Импортер/поставщик в Республику Беларусь и упаковщик: ООО «Детави», г. Минск, 2-й Велосипедный переулок, 32-9. Адрес производства: Минская обл., Минский р-н, Щомыслинский сельский совет, 16/2, промзона ТЭЦ 4.
-
Не соответствует требованиям ТР ТС 021/2011 утвержденного Решением Комиссии Таможенного союза 09.12.2011 № 880; ГН утвержденного постановлением Министерства здравоохранения Республики Беларусь за 21.06.2013 № 52; ГН, утвержденного постановлением Совета Министров Республики Беларусь от 25.01.2021 № 37 по микробиологическому показателю «плесени».
Детокс. Напиток чайный торговой марки «MILFORD»

-
в картонной коробке, обтянутой пленкой, 20х2,0г, масса нетто 40 г, дата изготовления 22.10.2019, срок годности до 22.10.2022,
-
партия номер 700492951, штриховой код 4002221026155.
-
Изготовитель ООО «Универсальные пищевые технологии», Россия, Московская обл., г. Серпухов, Северное шоссе, д.14.
-
Импортер/поставщик в Республику Беларусь: УП «Здоровый продукт», Минская обл., Минский р-н, военный городок, 137а, Семков городок, здание бывшего штаба, к.1.
-
Не соответствует требованиям ТР ТС 021/2011 утвержденного Решением Комиссии Таможенного союза 09.12.2011 № 880; ГН утвержденного постановлением Министерства здравоохранения Республики Беларусь за 21.06.2013 № 52; ГН, утвержденного постановлением Совета Министров Республики Беларусь от 25.01.2021 № 37 по микробиологическому показателю «плесени».
Консервы стерилизованные. Икра из кабачков обжаренных Alio premium. Сорт высший

- масса нетто 450 г, ГОСТ 2654-2017,
- дата изготовления 10.08.2021, срок годности 36 месяцев, условия хранения : хранить при температуре от 0°С до 25°С и относительной влажность воздуха не более 75 %,
- изготовитель: ООО «Белгородский консервный комбинат», Россия, Белгород, ул. Коммунальная, 1-А,
- импортеры в Республику Беларусь ООО «Белинтерпродукт», г. Минск, ул. Кижеватова, д.72, корп. 1, комната 3, ООО «Санта Ритейл», г. Брест, ул. Советской Конституции, 26/1
- Не соответствует требованиям ТР ТС 021/2011 утвержденного Решением Комиссии Таможенного союза 09.12.2011 № 880; ГН утвержденного постановлением Министерства здравоохранения Республики Беларусь за 21.06.2013 № 52; ГН, утвержденного постановлением Совета Министров Республики Беларусь от 25.01.2021 № 37 не соответствует требованиям по содержанию нитратов.
Информацию подготовила помощник врача-гигиениста Ошмянского районного ЦГЭ Михайлова Анна Сергеевна
28.03.2022
В целях обеспечения санитарно-эпидемиологического благополучия населения и недопущения к реализации пищевой продукции, представляющей потенциальную опасность для здоровья людей:
Морковь свежая сорт «Балтимор»

- урожай 2021, дата фасовки 15.03.2022,
- срок годности с даты фасовки/упаковки не более 30 суток,
- Изготовитель Фермерское хозяйство «Гричинское», Республика Беларусь, 225681, Брестская область, Лунинецкий район, д. Межлесье, ул. Леменская, 6.
- Не соответствует требованиям Санитарных норм и правил, ТР ТС 021/2011, утвержденного Решением Комиссии Таможенного союза от 09.12.2011 № 880, ГН утвержденных постановлением Министерства здравоохранения Республики Беларусь за 21.06.2013 № 52 по показателю «нитраты».
Ядро грецкого ореха, полистирольная упаковка

- масса нетто 0,2 кг, дата изготовления 15.12.2021, дата фасовки 11.02.2022,
- срок годности 12 месяцев с даты изготовления,
- Изготовитель ЧП «Umar Kishmish Servis», Республика Узбекистан, Самаркандская область, Паярикский район, г.Челек, ССГ Кумчук, ул. Истиклал. Импортер в Республику Беларусь/фасовщик ООО «Грасп», г. Могилев, пер Гаражный, 29.
- Не соответствует требованиям ТР ТС 021/2011, ГН утвержденных постановлением Министерства здравоохранения Республики Беларусь за 21.06.2013 № 52, ГН, утвержденных постановлением Совета Министров Республики Беларусь от 25.01.2021 № 37 по микробиологическому показателю.
Зернистая икра «ИКРА ГОРБУШИ «ЧИНГАЙ»

- ТУ ВУ 200656098.097-2018, масса нетто: 130 г,
- штриховой код: 4810168036126.
- Изготовитель СП «Санта Бремор» ООО. Республика Беларусь, 224025, г. Брест, ул. Катин Бор, 106.
- Не соответствует требованиям Санитарных норм и правил, ГН утв. постановлением Министерства здравоохранения Республики Беларусь за 21.06.2013 № 52, ГН, утв. постановлением Совета Министров Республики Беларусь от 25.01.2021 № 37, ТР ЕАЭС 040/2016, принятого Решением Совета Евразийской экономической комиссии от 18.10.2016 № 162 по органолептическим показателям.
Информацию подготовила помощник врача-гигиениста Ошмянского районного ЦГЭ Михайлова Анна Сергеевна
23.03.2022
В целях обеспечения санитарно-эпидемиологического благополучия населения и недопущения к реализации пищевой продукции, представляющей потенциальную опасность для здоровья людей информируем:
Приправа без соли для плова «SPICE EXPERT»

- (состав: зира, перец красный сладкий, перец черный),
- дата изготовления Е.16 12.02.2021, срок годности 24 месяца,
- штриховой код 4780048900147, упаковка – бумажные пакеты, масса нетто 15гобнаружен запах окислившегося жира,
- Изготовитель ООО «SPICE EXPERT», Узбекистан, г. Ташкент, ул. Богишамол, 160. Импортер в Республику Беларусь ООО «Первая торгово-логистическая компания», Минская область, Минский район, Боровлянский сельский совет, 81-1в, ааб. 14, район д. Дроздово.
- Не соответствует требованиям ГН, утвержденных Постановлением Министерства здравоохранения Республики Беларусь от 21.06.2013 № 52, ГН, утвержденных постановлением Совета Министров Республики Беларусь от 25.01.2021 №37, ТР ТС 021/2011, утвержденного Решением Комиссии Таможенного союза от 09.12.2011 № 880 по микробиологическому показателю «плесени».
Морковь свежая

- ГОСТ 32284-2013, сорт «Боливар, урожай 2021 г.,
- дата фасовки 25.02.2022, условия хранения и срок годности: ТУ BY100286955.002-2014; ТУ BY100286955.003-2014: при температуре от +40С до +120С и относительной влажности от 85% до 90% не более 30 суток,
- Изготовитель/поставщик: крестьянское (фермерское) хозяйство «Яворово», Республика Беларусь, Брестская обл., Ганцевичский район, аг. Чудин. Отправитель: УП «Партизанское», г. Минск, ул. Стебенева, 2 (цех № 1 Колядичи, п/у Колядичи, ул. Бабушкина, 78, партия 221121, бригада № 2).
- Не соответствует требованиям ГН, утвержденных Постановлением Министерства здравоохранения Республики Беларусь от 21.06.2013 № 52 по содержанию «нитратов»: фактическое значение составило 654,0 мг/кг, при норме по ТНПА – 250,0 мг/кг (протокол испытания проб пищевых продуктов Минского городского ЦГЭ от 04.03.2022 № 57-20/00118-00118).
Манго сушеное (цукаты) Kong,

- состав: натуральный манго сушеный, сахар, консервант Е220, краситель Е 102;
- дата изготовления 03.10.2021, срок годности 18 месяцев, штриховой код 48109480085558,
- Изготовитель: «Jinan Happy Forest со., ltd», N0.36 EAST UPPER DAPENG MARKET, NO 42 KING GUAN ZHUANG, SHIZHONG DIS-TRICT. JINANCITY, SHANDONGPROVINCE, CHINA (Китай). Импортер ООО «Севафрукт», Минская область.Минский район, аг. Хотежино, ул. Центральная, дом 18 Б/1,к.33. Поставщик: ООО «ЮнионАгро», Минская область. Минский район, Щомыслинский сльский совет, д.16, пом.12.
- Не соответствует требованиям ТР ТС 029/2012 принятого Решением Совета ЕЭК от 20.07.2012 № 58, ГН, утв. постановлением Совета Министров Республики Беларусь от 25.01.2021 № 37, ГН, утв. постановлением Министерства здравоохранения Республики Беларусь от 12.12.2012 № 195, Санитарных норм и правил и ГН, утв. постановлением Министерства Здравоохранения Республики Беларусь от 2.06.2013 № 52 по содержанию «сернистой кислоты».
Виноград сушеный (изюм)

- штриховой код 4660116269584, изготовлено и упаковано 27.08.2021, срок годности 8 месяцев,
- упаковка: из полимерных комбинированных материалов; условия хранения: хранить при температуре не выше +20 ,
- Изготовитель: ООО «НИКА», Российская Федерация, Московская обл., г. Наро-Фоминск, р.п. Селятино, ул. Госпитальная д.2. Поставщик в Республику Беларусь: ЗАО «Юнифуд», г. Минск, ул. Притыцкого, дом 93,4-й этаж, офис 11,
- Не соответствует Санитарным нормам и правилам, ГН, утв. постановлением Министерством здравоохранения Республики Беларусь от 21.06.2013 № 52; ТР ТС 021/2011, утв. Решением Комиссии Таможенного союза 09.12.2011 № 880, ГН, утв. постановлением Совета Министров Республики Беларусь 25.01.2021 №37 по микробиологическому показателю: обнаружены плесени.
Консервы из печени рыб стерилизованные Печень трески по-мурмански. Атлантическая (тонкоизмельчен-ная)

- Масса нетто 0,240 кг, дата изготовления 12.01.2022, срок годности 24 месяца,
- ГОСТ 13272-2009, штриховой код 4650056310330,
- Изготовитель ООО «Владимирский консервный завод» (ООО «Владкон»), Российская Федерация, Владимирская область, Собинский район, г. Лакинск, проспект Ленина, 71. Поставщик в Республику Беларусь ООО «Дисконт фиш», Минская область, г. Жодино, ул. Кузнечная, 16, комн.4/7.
- Не соответствует требованиям Санитарных норм и правил, ГН утв. постановлением Министерства здравоохранения Республики Беларусь за 21.06.2013 № 52, ГН, утв. постановлением Совета Министров Республики Беларусь от 25.01.2021 № 37, ТР ЕАЭС 040/2016, принятого Решением Совета Евразийской экономической комиссии от 18.10.2016 № 162 по органолептическим показателям: запах – с неприятным запахом.
Информацию подготовила помощник врача-гигиениста Ошмянского районного ЦГЭ Михайлова Анна Сергеевна
15.03.2022
В целях обеспечения санитарно-эпидемиологического благополучия населения и недопущения к реализации пищевой продукции, представляющей потенциальную опасность для здоровья людей информируем:
Изделия мучные кондитерские длительного хранения Пирожное «Карамельное»

- в потребительской картонной упаковке, упакованной в целлофан, массой нетто 1000 г,
- дата выработки 27.11.2021, срок годности 4 месяца,
- Изготовитель ООО «Раконфи», 140108, Россия, Московская область, Раменский район, г. Раменское, ул. Новая, д. 6. Изготовлено по заказу ООО «Разевай», Россия, г. Москва, ул. Садовая-Триумфальная, д.16 стр.3. Импортер в Республике Беларусь ООО «МосПродуктСервис», 224022 г. Брест, ул. Карьерная, д. 12, корп. 1В,
- Не соответствует требованиям Санитарных норм и правил, ГН, утвержденный постановлением Совета Министров Республики Беларусь от 25.01.2021 № 37, ГН утвержденных постановлением Министерства здравоохранения Республики Беларусь от 12.12.2012 № 195, ТР ТС 029/2012, принятого Решением Совета Евразийской экономической комиссии от 20.07.2012 № 58 по содержанию бензойной кислоты.
Изделие кондитерское сахаристое торговой марки «Bella» «Халва Узбекская молочная «Барфи»

- дата изготовления 22.12.2021, срок годности 3 месяца,
- Изготовитель ООО «Бизнес Торг», Россия, г. Москва, Ступинский проезд, дом 1 А, строение 2, помещение 1, комната 25; адрес осуществления деятельности: Московская область, Чеховский район, г. Чехов, ул. Комсомольская, владение 25. Импортер в Республику Беларусь: ООО «Дубай орехи и сухофрукты», г. Минск, ул. Восточная, 133, пом. 503/4,
- Не соответствует требованиям Санитарных норм и правил, ГН, утвержденный постановлением Совета Министров Республики Беларусь от 25.01.2021 № 37, ГН утвержденных постановлением Министерства здравоохранения Республики Беларусь от 12.12.2012 № 195, ТР ТС 029/2012, принятого Решением Совета Евразийской экономической комиссии от 20.07.2012 № 58: наличие в составе продукта незаявленной изготовителем в маркировке пищевой добавки сорбиновой кислоты.
Икорное рыбное изделие. Икра сельди тихоокеанской. «Икра деликатесная» в крем соусе с ароматом креветки.

- непастеризованная, масса нетто 170 г в стеклянной банке, ш.к. 4640057671233,
- дата изготовления 12.12.2021, срок годности 12.06.2022,
- Изготовитель ООО «Лунское море», Российская Федерация, Камчатский край, Елизовский район, пос. Нагорный, территория Птицефабрика Восточная, адрес производства: Российская Федерация, Нижегородская обл., г. Нижний Новгород, ул. Кима, 337.Импортер в Республику Беларусь:«Белое море», Республика Беларусь, г. Минск, ул. Аэродромная, 125, пом. 29а,
- Не соответствует требованиям Санитарных норм и правил, ГН, утвержденный постановлением Совета Министров Республики Беларусь от 25.01.2021 № 37, ГН утвержденных постановлением Министерства здравоохранения Республики Беларусь от 12.12.2012 № 195, ТР ТС 029/2012, принятого Решением Совета Евразийской экономической комиссии от 20.07.2012 № 58: по показателю «сорбиновая кислота» в комбинации с бензойной кислотой.
Полуфабрикаты рубленные из мяса птицы. Котлеты «По-домашнему» замороженные.

- СТО 52902019-005-2013, ш.к. (01)4607145772012(17)220430,
- дата изготовления 31.10.2021, дата упаковывания 31.10.2021, срок годности при температуре -12°C до 3 месяцев, при температуре -14°C до 4 месяцев, при температуре 18°C до 6 месяцев.
- Изготовитель ООО «МПК «Обнинский», Российская Федерация, Калужская область, г. Обнинск, Киевское шоссе, 33. Импортер в Республику Беларусь: ЧТУП «Желатофуд», г. Могилев, пер. Гаражный, 4, оф. 10.
- Не соответствует требованиям ТР ТС 021/2011, принятого Решением Совета Евразийской экономической комиссии от 09.12.2011 № 880: Санитарных норм и правил, ГН, утвержденный постановлением Совета Министров Республики Беларусь от 21.06.2023 № 52 по микробиологическому показателю – обнаружена Salmonella spp в 25,0 г.
VICI. Рыбный кулинарный полуфабрикат: палочки из фарша рыбного в панировке обжаренные, замороженные

- штриховой код 4770190 036627, артикул. Ашан – 102570, дата изготовления 12.01.2022, годен до 12.01.2024, номер партии 22012.
- Изготовитель ООО «Вичюнай -Русь», юридический адрес: Российская Федерация, 236758, Калининградская обл., г. Советск, ул. Маяковского, ЗБ. Адрес производства: Россия, 238758, Калининградская обл., г. Советск, ул. Маяковского, 1. Дистрибьютор: ООО «БалтКо», 109428, Россия, г. Москва, Рязанский проспект, д.24, корп. 2. Поставщик в Республику Беларусь: Иностранное унитарное предприятие «ЭкоФорт», Республика. Беларусь, Минский р-н, Хатежинский с/с южное н.п. Хатежино, склад-морозильник, АБК, офис № 1, 223039, Минская обл.
- Не соответствует требованиям Санитарных норм и правил, ГН, утвержденного постановлением Совета Министров Республики Беларусь от 25.01.2021 № 37, Санитарных норм и правил, ГН, утвержденного постановлением Совета Министров Республики Беларусь от 21.06.2013 № 52, ТР ТС 021/2011, ТР ЕАЭС 040/2016 по микробиологическом показателю: обнаружена Listeria monocytogenes в 25,0 г, при нормирующем показателе - не допускается в 25,0 г.
Информацию подготовила помощник врача-гигиениста Ошмянского районного ЦГЭ Михайлова Анна Сергеевна
16.03.2022
В целях обеспечения санитарно-эпидемиологического благополучия населения и недопущения к реализации пищевой продукции, представляющей потенциальную опасность для здоровья людей информируем:
Рыбные консервы натуральные стерилизованные сайра и сардина (иваси) тихоокеанские (куски), натуральные с добавлением масла

-
ТУ 10.20.25-003-22738723 - 2019,
-
дата изготовления 21.11.2021, срок годности 24 месяца с даты изготовления,
-
штриховой код 4627201565044,
-
Изготовитель ООО «Владимирский консервный завод», Российская Федерация, 601240, Владимирская область, Собинский район, г. Лакинск, пр-т Ленина, д. 71, офис 10, адрес места осуществления деятельности Российская Федерация, 601240, Владимирская область, Собинский район, г. Лакинск, пр-т Ленина, д. 71.
-
Поставщик в Республику Беларусь ООО «Евроторг», г.Минск, 220099, ул. Казинца, д. 52а, комн. 22,
-
не соответствует требованиям Санитарных норм и правил, ГН утвержденных постановлением Министерства здравоохранения Республики Беларусь за 21.06.2013 № 52 по органолептическим показателям.
Ананас обезвоженный консервированный с сахаром кубики микс (цукат) (Candied pineapple core dice mix)

-
дата изготовления 19.06.2021, срок годности 19.06.2022,
-
Изготовитель PRANBURI FRUIT INDUSTRIAL (2005) CO.LTD», 179/10 M.11, T.Nhongtam. A. Pranburi, Prachuapkfairikhan Province, 77120, Тайланд.
-
Импортер в Республику Беларусь ООО «Караван ХХI век», Минская область Минский район, д. Королев Стан, ул. Заречная, д.14а, к.5,
-
Не соответствует требованиям
-
ГН, утвержденному постановлением Совета Министров Республики Беларусь от 25.01.2021 № 37,
-
ТР ТС 029/2012, принятого Решением Совета Евразийской экономической комиссии от 20.07.2012 № 58 по маркировке в части предоставления достоверной информации о составе продукта: выявлен не указанный на маркировке продукции синтетический краситель красный очаровательный АС (Е129).
Свекла столовая свежая

-
ГОСТ 1722-85 урожай 2021,
-
дата упаковки 10.03.2022, срок годности – хранить при температуре от +4°С до +12°С и относительной влажности воздуха 85%-90% не более 30 суток с даты упаковки,
-
Изготовитель ООО «ПК «Садком», Республика Беларусь, Минская область, г. Старые Дороги, ул. Кирова, д.149,
-
Не соответствует требованиям Санитарных норм и правил, ГН утвержденных постановлением Министерства здравоохранения Республики Беларусь за 21.06.2013 № 52,по показателю «нитраты».
Чай черный байховый

-
ТУ 10.83.13-003-88336328-2012, масса нетто 500 г,
-
дата изготовления 20.11.2021, срок годности 24 месяца,
-
штриховой код 4032489109444,
-
Изготовитель ООО «Интер-трейд-юнион», Российская Федерация, г. Москва,. Энтузиастов, 56, стр. 32 пом.501,
-
адрес производства Российская Федерация, г. Москва, ш. Энтузиастов, 56, стр. 34.
-
Импортер в Республику Беларусь ООО «ЛенПродуктСервис», Республика Беларусь, г. Минск, ул. Казинца, 11А, оф. 506А; ООО «МосПродуктСервис», Республика Беларусь, г. Брест, ул. Карьерная, 12, корп.1В; ООО «ВитебскПродуктСервис», Республика Беларусь, г. Витебск, ул. пр-т Московский, 53, пом. № 4; ООО «ГомельПродуктСервис», Республика Беларусь, г. Гомель, ул. Федюнинского, 17, каб. 4-6.
-
Не соответствует требованиям Санитарных норм и правил, ГН утвержденных постановлением Министерства здравоохранения Республики Беларусь за 21.06.2013 № 52,ТР ТС 021/2011, утвержденного Решением Комиссии Таможенного союза от 09.12.2011 № 880 по микробиологическому показателю «плесени».
Икорное рыбное изделие. Икра сельди тихоокеанской. «Икра деликатесная» в крем соусе с ароматом креветки.

-
Не пастеризованная, масса нетто 170 г в стеклянной банке, ш.к. 4640057671233,
-
Изготовитель ООО «Лунское море», Российская Федерация, Камчатский край, Елизовский район, пос. Нагорный, территория Птицефабрика Восточная, адрес производства: Российская Федерация, Нижегородская обл., г. Нижний Новгород, ул. Кима, 337.Импортер в Республику Беларусь:«Белое море», Республика Беларусь, г. Минск, ул. Аэродромная, 125, пом. 29а,
-
Не соответствует требованиям Санитарных норм и правил, ГН, утвержденный постановлением Совета Министров Республики Беларусь от 25.01.2021 № 37, ГН утвержденных постановлением Министерства здравоохранения Республики Беларусь от 12.12.2012 № 195, ТР ТС 029/2012, принятого Решением Совета Евразийской экономической комиссии от 20.07.2012 № 58: по показателю «сорбиновая кислота» в комбинации с бензойной кислотой.
Изделие мучное кондитерское песочное торт «Персидская ночь»

-
-
изготовлен 23.01.22, годен до 5 23.04.22, в картонной упаковке массой нетто 400 г, штриховой код 4601787001226,
-
Изготовитель АО «КБК «Черемушки», адрес юридического лица: Россия, 109377, г. Москва, ул. Академика Скрябина, д. 9, корп. 2, стр. 3; адрес производства: Россия, 109377, г. Москва, ул. Академика Скрябина, д. 9, корп. 2, стр. 1
-
Поставщик в Республику Беларусь ООО «БКС-Экспо», Минская обл., Молодеченский р-н, г. Молодечно, ул. 8 Марта, д. 2,
-
Не соответствует требованиям ТР ТС 021/2011, ТР ТС 022/2011 по маркировке в части предоставления достоверной информации о составе продукта: в состав входит обнаруженный в результате проведения испытаний, незаявленный изготовителем по маркировке консервант сорбиновая кислота; значение показателя «сорбиновая кислота».
-
Информацию подготовила помощник врача-гигиениста Ошмянского районного ЦГЭ Михайлова Анна Сергеевна
22.03.2022
В целях защиты потребительского рынка от небезопасной и некачественной продукции санитарно-эпидемиологической службой Республики Беларусь продолжаются мероприятия технического (технологического, поверочного) характера по отбору проб и образцов пищевой продукции, находящейся в реализации.
По результатам испытаний выявлена пищевая продукция, несоответствующая санитарно-эпидемиологическим требованиям:
Ананасы сушеные (цукаты) микс в картонных коробках с полипропиленовыми вкладышами массой по 20,0 кг, дата изготовления 10.05.2020, годен до 10.05.2022, хранить при температуре не выше 25°С и относительной влажности воздуха не более 75 %, изготовитель «Jinan Happy Forest со., ltd», Китай, импортер в Республику Беларусь ЧП «Шалу» — в состав продукта входит, обнаруженная в результате проведенных испытаний, незаявленная изготовителем на маркировке, пищевая добавка бензойная кислота (Е210).
Изделия мучные кондитерские длительного хранения Пирожное «Карамельное», массой нетто 1000 г, штриховой код 4650070953261, дата изготовления 13.12.2021, срок годности 4 месяца, хранить при температуре (18±3)°C и относительной влажности воздуха не более 75 %, изготовитель ООО «Раконфи», Россия, импортеры в Республике Беларусь ООО «ЛенПродуктСервис», ООО «МосПродуктСервис», ООО «ВитебскПродуктСервис», ООО «ГомельПродуктСервис» — в составе продукции содержится пищевая добавка консервант бензойная кислота, не допустимая при изготовлении мучных кондитерских изделий.
Ароматизированный чайный напиток «Мятный сюрприз», дата изготовления 03.02.2021, срок годности до 03.02.2023, массой нетто 500 г, хранить при температуре не более 200С и относительной влажности воздуха не более 75%, изготовитель ООО «ПЧК-про», Россия, импортер в Республику Беларусь ЧТУП «Ипостась» — обнаружена плесень.
Уважаемые покупатели!
В целях недопущения употребления в пищу недоброкачественных пищевых продуктов обращайте внимание на условия хранения пищевой продукции, внимательно читайте информацию на этикетке (маркировке), просите продавца предоставить документы, подтверждающие качество и безопасность!
Информацию подготовила помощник врача-гигиениста Ошмянского районного ЦГЭ Михайлова Анна Сергеевна
10.03.2020
В целях обеспечения санитарно-эпидемиологического благополучия населения и недопущения к реализации пищевой продукции, представляющей потенциальную опасность для здоровья людей, по результатам испытаний выявлена пищевая продукция, несоответствующая санитарно-эпидемиологическим требованиям:
Вино виноградное натуральное красное полусухое «MEZOK», штриховой код 5999885432134, дата изготовления 29.09.2021, срок годности 3 года, страна изготовления – Венгрия, импортер в Республику Беларусь ОАО «Минский завод игристых вин», г. Минск, ул. Радиальная, 50 — в состав продукта входят, обнаруженные в результате испытаний, незаявленные изготовителем в маркировке, консерванты сорбиновая и бензойная кислоты.
Консервы из печени рыб, стерилизованные «Печень минтая по-мурмански» торговоймарки «Примрыбснаб», штриховой код 4680009030305, массой нетто 240 г, дата изготовления 09.09.2020, смена 2, срок годности 24 месяца, хранить при температуре от 0°С до 20°С и относительной влажности воздуха не более 75 %, изготовитель АО «Южморрыбфлот», Россия, Приморский край, г. Находка, мкр. Ливадия, ул.Заводская, 16 завод № 13, импортер в Республику Беларусь ООО «Белое Море», г. Минск, ул. Аэродромная, 125, пом.29А — на маркировке продукции отсутствуют сведения о наличии в составе консерванта сорбиновой кислоты.
Мороженая пищевая рыбная продукция «Минтай без голов 25+», фасованная, дата изготовления 24.09.2021, дата фасовки 01.12.2021, срок хранения 18 месяцев с даты изготовления, хранить при температуре не выше минус 18°С, изготовитель ООО ПКФ «Южно-Курильский рыбокомбинат», Россия, Сахалинская область, фасовщик ОДО «Высокая волна», аг. Мышковичи, Кировский район, Могилевская область, импортер в Республику Беларусь ООО «Белое Море», г. Минск, ул. Аэродромная, 125, пом.29А – консистенция продукции после размораживания ослабевшая, после размораживания и пробной варки присутствует посторонний запах.
Приправа для салатов торговой марки «Волшебное дерево», масса нетто 30 г, штриховой код 4607003763930, дата изготовления 23.06.2021, годен до 23.06.2023, изготовитель ООО «Проммикс», Россия, г. Москва, ул. Красносельская Нижняя, д. 35, стр.9, помещение 505, импортер в Республику Беларусь ТЧУП «РегионСервис», г. Минск, пр-т Независимости, д.143, корп.2, офис 1а – не соответствует требованиям гигиенических нормативов по микробиологическим показателям (обнаружены КМАФАнМ, плесени).
Кумкват обезвоженный консервированный с сахаром (состав: кумкват, сахар, антиокислитель Е220, регулятор кислотности Е330), упакованный в картонную коробку с полимерным вкладышем массой нетто 2,5 кг, дата изготовления 02.06.2021, годен до 02.06.2023, хранить в сухом прохладном месте, изготовитель «JinjlangShijiang-FoodstuffsCo.,Ltd», Китай, No, 7 Jinytian Road Wuli Industrial Area Jinliang Fujian, импортер в Республику Беларусь ООО «Караван ХХI век», Минская область, Минский р-н, д. Королев Стан, ул. Заречная, 14а, каб. 5 — маркировка не содержит сведений о наличии в составе продукта пищевой добавки краситель понсо 4R E124.
Ананас обезвоженный консервированный с сахаром листики микс (цукат) весовой (состав: ананас, сахар, консервант диоксид серы Е220, регулятор кислотности лимонная кислота Е330, пищевые красители Е102, Е110, Е102+Е133, Е124+Е122), упакованный в картонную коробку с полимерным вкладышем массой нетто 5 кг, дата изготовления 03.07.2021, годен до 03.07.2022, хранить в сухом прохладном месте, изготовитель «PRANBURI FRUIT INDUSTRIAL (2005) CO. LTD», Тайланд, 179/10 М. 11, Т.Nhongtatam, A. Pranburi, Prachuapkhirikhan Province 77120, импортер в Республику Беларусь ООО «Караван ХХI век», Минская область, Минский р-н, д. Королев Стан, ул. Заречная, 14а, каб. 5 — маркировка не содержит сведений о наличии в составе продукта пищевой добавки краситель красный очаровательный Е129.
Чернослив высший сорт весовой (состав: слива сушеная, антиокислитель диоксид серы Е220), масса нетто 10 кг, партия № 20/2021, дата изготовления 09.2021, годен до 09.2022, хранить при температуре до 20ºС, относительной влажности воздуха не более 70%, изготовитель ООО «Samrin Trade», Республика Узбекистан, Самарканская область, Самарканский район, село Дашти сухта, импортер в Республику Беларусь ООО «Чайно-кофейная компания», г. Брест, ул. Дубровская, 36 — в состав продукта входит, обнаруженный в результате испытаний, незаявленный изготовителем в маркировке, консервант сорбиновая кислота.
Икра зернистая соленая лососевая (горбуша) торговой маки «Рыбпромпродукт», ТУ 10.20.26-00153894718-2018, сорт 1, дата изготовления 17.12.2021, сроки годности: при температуре от 6°С до -4°С не более 12 месяцев, при температуре +5°С до 0°С не более 10 месяцев, штриховой код 4607038062718, изготовитель ООО «Русский рыбный мир», Российская Федерация, г. Москва, пос. Щаповское, пос. Курилово, ул. Центральная, д.15, пом. 1; импортер в Республику Беларусь ООО «Евроторг», г. Минск, ул. Казинца, 52А-22 — не соответствует требованиям по массовой доле сорбиновой и бензойной кислот, и их солей.
Папайя цукаты кубики 8-10 мм (микс), в полимерной упаковке массой нетто 5 кг, дата изготовления 20.07.2021, годен до 20.10.2022, изготовитель SHANDONG WEIFANG IMPORT AND EXPORT CO., LTD 236 SHENGLI EAST STR, Китай; импортер в Республику Беларусь ООО «Фрутреал», Витебская область, г. Полоцк, ул. Октябрьская, 25/1-6, ком. 17 — не соответствует требованиям по маркировке: в части предоставления достоверной информации о составе продукта (в состав входит пищевая добавка, незаявленная на маркировке: консервант бензойная кислота).
Информацию подготовила помощник врача-гигиениста Ошмянского районного ЦГЭ Михайлова Анна Сергеевна
02.03.2022
В целях обеспечения санитарно-эпидемиологического благополучия населения и недопущения к реализации продукции, представляющей потенциальную опасность для здоровья людей информируем, что Ошмянским районным ЦГЭ по результатам испытаний лабораторного отдела Гродненского областного ЦГЭОЗ выявлена пищевая продукция, несоответствующая санитарно-эпидемиологическим требованиям:
Консервы стерилизованные. Икра из кабачков обжаренных Alio premium. Сорт высший

масса нетто 450 г, ГОСТ 2654-2017, дата изготовления 05.11.2021, срок годности 36 месяцев, условия хранения : хранить при температуре от 0°С до 25°С и относительной влажность воздуха не более 75 %, изготовитель: ООО «Белгородский консервный комбинат», Россия, Белгород, ул. Коммунальная, 1-А, импортеры в Республику Беларусь ООО «Белинтерпродукт», г. Минск, ул. Кижеватова, д.72, корп. 1, комната 3, ООО «Санта Ритейл», г. Брест, ул. Советской Конституции, 26/1 – не соответствует требованиям по содержанию нитратов.
Информацию подготовила помощник врача-гигиениста Ошмянского районного ЦГЭ Михайлова Анна Сергеевна
23.02.2022
В целях обеспечения санитарно-эпидемиологического благополучия населения и недопущения к реализации пищевой продукции, представляющей потенциальную опасность для здоровья людей информируем:
PERGALE SPRING FLOWЕRS DESSERT COLLECTION

-
набор конфет
-
конфеты с начинкой: начинка со вкусом малиново-сырного пирога 11 %; начинка со вкусом лимонного пирога 11%; начинка со вкусом крем-брюле 11%; начинка со вкусом терамису 11%
-
масса нетто 125 г.
-
дата изготовления 15.12.2020
-
годен до 14.02.2022
-
штриховой код 4770179121054
-
изготовитель AB «Vilniaus Pergale», V.A. Сraiciűno g. 26 LT -02241 Vilnius, Lithuana, Литва
-
импортер в Республику Беларусь ООО «Желенторг», г. Минск, ул. Ольшевского, д.10, комн. 300 Л; поставщик по территории Беларусь ООО «ОрионСвит», Минский р-н, п/у Колядичи, ул. Бабушкина, 90, офис 304
-
не соответствует требованиям по микробиологическим показателям (обнаружены «дрожжи»).
«COLUMB»

-
соус соевый классический стерилизованный
-
дата изготовления 20.09.2021
-
срок годности 20.09.2023
-
упаковка (потребительская) – полиэтиленовая бутылка
-
штриховой код 4814067004187
-
изготовитель «VIETNAMLOTUS.,JSC» ROOM 401, HOUSEN2D, LEVANLUONGSTR.,THANHXUANDIST., HANOI, Вьетнам
-
импортер в Республику Беларусь ООО «Добрада», г. Минск, ул. Городецкая, д.64, к.3
-
не соответствует требованиям пищевой добавки (сорбиновая кислота и сорбаты в комбинации с бензойной кислотой и бензоатами).
Абрикос сушеный (курага)

-
1 сорт
-
дата изготовления 09.2021
-
дата упаковывания 11.11.2021
-
годен до 01.09.2022
-
масса нетто 500 г
-
штриховой код 4810948009173
-
изготовитель Фермерское хозяйство (СП ООО) «SIROJIDDIN AGRO FRUITS», Республика Узбекистан, Самаркандская область, Ургутский район, село Карабулок
-
импортер в Республику Беларусь ЧП «Шалу», Минская область, Минский район, Щомыслицкий с/с, аг. Озерцо, ул. Центральная, д.35 А, пом.25
-
не соответствует требованиям по показателю «диоксид серы».
Папайя цукаты

-
кубики 8-10 мм (микс)
-
в полимерной упаковке массой нетто 5 кг
-
дата изготовления 20.07.2021
-
годен до 20.10.2022
-
изготовитель SHANDONG WEIFANG IMPORT AND EXPORT CO., LTD 236 SHENGLI EAST STR., Китай
-
импортер в Республику Беларусь ООО «Фрутреал», Витебская область, г. Полоцк, ул. Октябрьская, 25/1 — 6, ком.17
-
не соответствуют требованиям по маркировке (отсутствует достоверная информация в части сведений о составе продукта; фактически в состав продукта входят не заявленные на маркировке пищевые добавки: консервант бензойная кислота, синтетический краситель Понсо 4 R (Е124)).
Информацию подготовила помощник врача-гигиениста Ошмянского районного ЦГЭ Михайлова Анна Сергеевна
15.02.2022
Государственное учреждение «Ошмянский районный центр гигиены и эпидемиологии» информирует о пищевой продукции, которая по результатам лабораторного контроля, проводимого в рамках осуществления мероприятий технического (технологического, поверочного) характера, не соответствовала требованиям санитарно-эпидемиологического законодательства:
котлеты «Пожарские»

-
замороженные полуфабрикаты мясные рубленные формованные панированные категории «Б»,
-
ТУ 9214-002-84035535-02, штриховой код 4607048473641, масса нетто 5 кг,
-
дата изготовления 29.11.2021, срок годности 6 месяцев,
-
изготовитель/упаковщик ИП Кузнецова Т.В, Российская Федерация, Нижегородская область, г. Дзержинск, ул. Бутлерова, д. 36, кв.15, поставщик в Республику Беларусь ОДО «Айскинг», Республика Беларусь, г. Минск, ул. Минск, ул. П.Бровки, 30-29 (уведомление Дрибинского районного ЦГЭ от 31.01.2022 № 6-4/247);
курага ЕВРОСОРТ (абрикос сушеный без косточки)
-
ГОСТ 32896 -2014, весовой в картонной коробке с вкладышем,
-
дата изготовления 07.2021, годен до 07.2022,
-
изготовитель ООО «ФРУТЛАЙН», Российская Федерация, г. Москва, Перовское шоссе, дом 21, строение 3, импортер в Республику Беларусь ООО «Детави», г. Минск, 2-ой Велосипедный переулок, 32, пом. 9 упаковано в потребительскую упаковку массой нетто 160 г
абрикос сушеный (курага) 1 сорт

-
упакован в полимерную (полипропиленовую) запаянную упаковку объемом по 500 г,
-
дата изготовления 09.2021, дата упаковывания 25.11.2021, годен до 01.09.2022, штриховой код 4810948009173,
-
изготовитель Фермерское хозяйство (СП ООО) «SIROJIDDIN AGRO FRUITS», Республика Узбекистан, Самаркандская область, Ургутский район, село Карабулак, упаковщик/импортер в Республику Беларусь ЧПТУ предприятие «Шалу», Республика Беларусь, Минская область, Минский р-н, Щомыслицкий с/с, аг. Озерцо, ул. Центральная, 35А, пом. 25.
полуфабрикаты из мяса птицы рубленные в тесте замороженные пельмени «Белобоки с куриным филе»

- ТУ 9214-001-84035535-02, штриховой код 4607048470817, масса нетто 5 кг,
- дата изготовления 28.11.2021, срок годности 6 месяцев,
- изготовитель/упаковщик ИП Кузнецова Т.В, Российская Федерация, Нижегородская область, г. Дзержинск, ул. Бутлерова, д. 36, кв.15, поставщик в Республику Беларусь ОДО «Айскинг», 220013, Республика Беларусь, г. Минск, ул. П.Бровки, 30-29.
Пирожное «Нектар» шоколадный бисквит с кремом из растительных сливок и фруктовым наполнителем

- ТУ У 15.8-2633717196-001-2003, штриховой код 2000000000077, в потребительс-кой полимерной упаковке, масса нетто 240г,
- дата изготовления 20.00 24.01.2022, годен до 20.00 29.01.2022,
- Изготовитель ООО «КД Вацак», 24000, Украина, Винницкая область, г. Могилев-Подольский, ул. Армянская, д. 12, адрес производственных мощностей: 24000, Украина, Винницкая область, г. Могилев-Подольский, ул. Армянская, д. 4.Импортер в Республику БеларусьООО «КД Вацак»,г. Пинск, ул. Ленина, д. 2-19.
Соус соевый классический «GUSTO», пастеризованный

- объем 200 мл., штриховой код 8936098649000,
- дата изготовления: 24.09.2021, годен до 24.09.2023.
- Изготовитель: «A Vi Viet Joint Stok Company, Van La Village, Hong Van Commune, Thuong Tin District, Hanoi City, Vietnam», Вьетнам. Импортер в Республику Беларусь: общество с ограниченной ответствен-ностью «Евроторг», г. Минск, ул. Казинца, 52А-22
Уважаемые покупатели!
В целях недопущения употребления в пищу недоброкачественных пищевых продуктов обращайте внимание на условия хранения пищевой продукции, внимательно читайте информацию на этикетке (маркировке), просите продавца предоставить документы, подтверждающие качество и безопасность!
Информацию подготовила помощник врача-гигиениста Ошмянского районного ЦГЭ Михайлова Анна Сергеевна
14.02.2022
В целях обеспечения санитарно-эпидемиологического благополучия населения и недопущения к реализации продукции, представляющей потенциальную опасность для здоровья людей информируем:
Чеснок сушеный кусочками

-
1 сорта, дата изготовления 25.07.2021, годен до 25.07.2022,
-
штриховой код 4814957002613, ГОСТ 32065,
-
Изготовитель ПТЧУП «ПРЯНЫЙ ДОМ», Республика Беларусь, Минская область, Борисовский р-н, 222518, г. Борисов, ул. Демина, 23Б,
-
Не соответствует требованиям ГН, утвержденного постановлением Совета Министров Республики Беларусь от 25.01.2021 № 37 по микробиологическому показателю.
Чернослив, торговый знак «AGRO FOOD»

-
дата изготовления ноябрь 2021 г., дата упаковки 02.11.2021 г., годен до 02.05.2022 г.,
-
штриховой код 4780086400135,
-
Изготовитель ООО «AGRO-FOOD PARTNER», 120100, Республика Узбекистан, Скрдарьинская область, Мирзаабадский район, Т.Ахмедов СИУ дом 1. Импортёр в Республику Беларусь ООО «Асгир», Республика Беларусь, 220124, г. Минск, ул. М. Лынькова, д.125, пом.13, к. №48.
-
Не соответствует требованиям ГН, утвержденных Постановлением Министерства здравоохранения Республики Беларусь от 21.06.2013 № 52, ГН, утвержденных постановлением Совета Министров Республики Беларусь от 25.01.2021 №37, ТР ТС 021/2011, утвержденного Решением Комиссии Таможенного союза от 09.12.2011 № 880 по микробиологическому показателю
Арахис бланшированный (сырой)

-
дата изготовления 01.05.2021, дата упаковывания 06.08.2021, срок годности 01.05.2023,
-
штриховой код 4810948 009098,
-
Изготовитель MAYUR INTERPRAISE; NEAR AGARBATI FACTORY. PLOT № 13&14, SARAGYADA, JUNAGADH, GU.IARAT 362037, Индия. Упаковщик/импортёр (поставщик) в Республику Беларусь: ЧТПУП «Шалу», Республика Беларусь, 223021, Минская обл., Минский р-н, Щомыслицкий сельский совет, аг. Озерцо, ул. Центральная, д.35А, пом.25.
-
Не соответствует требованиям ГН, утвержденных Постановлением Министерства здравоохранения Республики Беларусь от 21.06.2013 № 52, ГН, утвержденных постановлением Совета Министров Республики Беларусь от 25.01.2021 №37, ТР ТС 021/2011, утвержденного Решением Комиссии Таможенного союза от 09.12.2011 № 880 по микробиологическому показателю.
Чай Принцесса Канди крепкий характер

- штриховой код 4605246016301,
- дата изготовления 10.2021, срок годности до 09.2024,
- Изготовитель ООО «ОРИМИ», Российская Федерация, Ленинградская область, Всеволожский район, пос. им. Свердлова, 1, мкр, уч-к 15/4. Импортер в Республику Беларусь ООО «Альфа -Дистрибьюция», г. Минск, ул. Матусевича, д. 20, пом. 12/1.
- Не соответствует требованиям ГН, утвержденных Постановлением Министерства здравоохранения Республики Беларусь от 21.06.2013 № 52, ГН, утвержденных постановлением Совета Министров Республики Беларусь от 25.01.2021 №37, по микробиологическому показателю.
Абрикос сушеный (курага) 1 сорт с маркировкой «Shalu»

- штриховой код 4810948009173,
- дата изготовления 09.2021, дата упаковывания 26.11.2021, срок годности 01.09.2022,
- Изготовитель Фермерское хозяйство (СП ООО) «SIROJIDDINAGROFRUITS», Республика Узбекистан, Самаркандская область, Ургутский район, село Карабулак. Упаковщик/ импортер в Республику Беларусь – ЧП «Шалу», Республика Беларусь, 223021, Минская область, Минский р-н, Щомыслицкий с/с, аг. Озерцо, ул. Центральная, д. 35 А, пом. 25.
- Не соответствует требованиям ГН, утвержденных постановлением Совета Министров Республики Беларусь от 25.01.2021 №37, ГН, утвержденному постановлением Министерства здравоохранения Республики Беларусь от 12.12.2012 №195, ТР ТС 029/2012 по содержанию пищевых добавок.
Ананасы сушеные (цукаты) микс

- дата изготовления 10.05.2020, годен до 10.05.2022,
- Изготовитель «Jinan Happy Forest Food Co., Ltd»;
- NO.36 EAST UPPER DAPENG MARKET. NO, 42 KING GUAN ZHUANG, SHIZHONG DISTRICT, JINAN CITY, SHANDONG PROVINCE, Китай. Поставщик в Республику Беларусь ЧП «Шалу», Республика Беларусь, 223021, Минская область, Минский р-н, Щомыслицкий с/с, аг. Озерцо, ул. Центральная, д. 35 А, пом. 25.
- Не соответствует требованиям ТР ТС 021/2011,ТР ТС 022/2011по маркировке: в части предоставления достоверной информации о составе продукта (в состав входит обнаруженный в результате проведенных испытаний, незаявленный изготовителем на маркировке консервант сорбиновая кислота (Е200).
Манго (листики оранжевые)

- дата изготовления 10.2021, годен до 04.2023,
- Изготовитель
- GCF International Co., LTD, 222/1 So1 Thana Tower, Jarunsanitwong Rd., Bangyikhan, Bangplad, Bangkok 10700, Тайланд. Поставщик в Республику Беларусь ООО «МАСТЕРФУД», Россия, 117587, г. Москва, ул. Днепропетровская, д.2, эт. 3, пом.17, комн. № 42,
- Не соответствует требованиям ТР ТС 021/2011, ТР ТС 022/2011, ТР ТС 029/2012 по маркировке: в части предоставления достоверной информации о составе продукта (в состав входит обнаруженный в результате проведенных испытаний синтетический краситель тартразин, незаявленный изготовителем на маркировке.
Уважаемые покупатели!
При покупке пищевой продукции обращайте внимание на соблюдение условий хранения пищевой продукции, в том числе на температурный режим, внимательно читайте информацию на этикетке (маркировке)!
Информацию подготовила помощник врача-гигиениста Ошмянского районного ЦГЭ Михайлова Анна Сергеевна
02.02.2022
В целях обеспечения санитарно-эпидемиологического благополучия населения и недопущения к реализации продукции, представляющей потенциальную опасность для здоровья людей информируем:
Киви приготовленный (подсушенный) методом осмотического обезвоживания с содержанием сахара

- дата изготовления 07.2021,срок годности 12 месяцев,
- Изготовитель LUONG GIA FOOD TECHNOLOGY CORPORATION, No 17, street 12, Chu Van An Residence, ward 26, Binh Thanh distriet, Ho Chi Minh City, Вьетнам. Импортер в Республику Беларусь ООО «Дубай орехи и сухофрукты», г. Минск, ул. Восточная, 133, пом. 503/4.
- Торговый объект ООО «Дубай орехи и сухофрукты» (юридический адрес: г. Минск, ул. Восточная, 133, пом. 503/4), расположенный по адресу: г. Минск, пр-т Партизанский,150А.
- Не соответствует требованиям Санитарных норм и правил, ГН утвержденных постановлением Министерства здравоохранения Республики Беларусь от 12.12.2012 № 195, ТР ТС 029/2012, принятого Решением Совета Евразийской экономической комиссии от 20.07.2012 № 58 по содержанию консервантов: массовая доля общего диоксида серы и сульфитов (сернистой кислоты) составила 655,9 мг/кг, 661,7 мг/кг (контрольный образец); установлено наличие в составе продукта незаявленной изготовителем в маркировке пищевой добавки сорбиновая кислота, обнаруженной в результате испытаний в количестве 178,9 мг/кг и 128,0 мг/кг.
Продукция пищевая рыбная холодного копчения. Сардина дальневосточная (иваси) холодного копчения обезглавленная потрошеная

- 1 сорт, дата изготовления 07.11.2021, срок годности до 05.02.2022,
- штриховой код 4810213012433,
- Изготовитель СП «Леор Пластик», г. Новогрудок, ул. Свердлова, 38а,
- Не соответствует требованиям Санитарных норм и правил, Гигиенического норматива, утвержденных постановлением МЗ РБ от 21.06.2013, ТР ЕАЭС 040/2016, ТР ТС 029/2012, по маркировке: на этикетке отсутствуют данные о содержании в составе бензокислого натрия.
Изделия мучные кондитерские длительного хранения Пирожное «Карамельное»

- В потребительской картонной упаковке массой нетто 1000 г,
- ТУ 10.72.12-006-73061268-2017, штриховой код 4650070953261, дата выработки 20.11.2021, срок годности 4 месяца, условия хранения - при температуре (18±3) °C и относительной влажности воздуха не более 75 %.
- Изготовитель ООО «Раконфи», 140108, Россия, Московская область, Раменский район, г. Раменское, ул. Новая, д. 6. Импортер в Республике Беларусь ООО «ЛенПродуктСервис» 220099, г. Минск, ул. Казинца, 11А, оф. 506 А; ОО «МосПродуктСервис», 224022 г, Брест, ул. Карьерная, д. 12, корп. 1В; «ВитебскПродукт Сервис», 210015 г. Витебск, ул. Проспект Московский, д. 53, пом. № 4; ООО «ГомельПродукт Сервис», 246007, г. Гомель, ул. Федюнинского, д. 17, каб. 4-6.
- Не соответствует требованиям Санитарных норм и правил, ГН, утвержденный постановлением Совета Министров Республики Беларусь от 25.01.2021 № 37, ГН утвержденных постановлением Министерства здравоохранения Республики Беларусь от 12.12.2012 № 195, ТР ТС 029/2012, принятого Решением Совета Евразийской экономической комиссии от 20.07.2012 № 58: при производстве пищевой продукции применялась пищевая добавка бензоат натрия (Е 211), не допустимая при изготовлении мучных кондитерских изделий.
Икра зернистая соленая лососевая

- масса нетто 95 г, дата изготовления 17.12.2021, срок годности не более 12 месяцев с даты изготовления при температуре от минус 6 °С до минус 4 °С, не более 10 месяцев при температуре от плюс 5 °С до 0 °С.,
- Изготовитель ООО «Русский рыбный мир», 142138. Россия, г. Москва, поселение Щаповское, пос. Курилово, ул. Центральная, д. 15, пом. 1. Поставщик в Республику Беларусь ООО «Евроторг», 220099, г, Минск, ул. Казинца 52А – 22.
- Не соответствует требованиям Санитарных норм и правил, ГН, утвержденных Постановлением Министерства здравоохранения Республики Беларусь от 21.06.2013 № 52, ГН, утвержденных постановлением Министерства здравоохранения Республики Беларусь от 12.12.2012 № 195, ТР ТС 029/2012 по показателям безопасности: содержание бензойной кислоты составило 1750,5 мг/кг, сорбиновой - 2032.5 мг/кг, при максимально допустимом суммарном содержании сорбиновой и бензойной кислот не более 2000,0 мг/кг.
Уважаемые покупатели!
При покупке пищевой продукции обращайте внимание на соблюдение условий хранения пищевой продукции, в том числе на температурный режим, внимательно читайте информацию на этикетке (маркировке)!
Информацию подготовила помощник врача-гигиениста Ошмянского районного ЦГЭ Михайлова Анна Сергеевна
26.01.2022

Ошмянский районный ЦГЭ сообщает, что Главным государственным инспектором Республики Беларусь по надзору за соблюдением технических регламентов:
запрещен ввоз и обращение опасной продукции, на территории Республики Беларусь:
мясные ветчинные стерилизованные консервы из мяса птицы «Ветчина нежная из мяса птицы», масса нетто 300 г, дата изготовления 15.07.2020, срок годности не более 2-х лет, изготовитель ООО «Сохраним традиции», Российская Федерация, г. Калининград; консервы мясные стерилизованные фаршевые из мяса цыпленка «Сытные», масса нетто 325 г, дата изготовления 02.07.2021, срок годности 2 года, изготовитель ООО «Курганский мясокомбинат «Стандарт», Российская Федерация, г. Москва (поставщик в Республику Беларусь ООО «Винкс-Плюс», г. Минск) - не соответствует ТР ТС 021/2011, ТР ТС 022/2011 по маркировке: наименование, задекларированное изготовителем в маркировке потребительской упаковки, вводит потребителя в заблуждение относительно содержимого упаковки, недостоверно характеризует пищевой продукт и не позволяет идентифицировать его по наименованию. По результатам испытаний установлено, что изготовитель умышленно придал внешний вид и отдельные свойства продукции, но при этом она не может быть идентифицирована как продукция, за которую выдается и является опасной продукцией (предписание о запрете ввоза и обращения опасной продукции, прекращении действия на территории Республики Беларусь документов об оценке соответствия, об изъятии (отзыве из обращения) продукции от 29.12.2021 № 16-18-123/1663); прекращено действие на территории Республики Беларусь деклараций о соответствии ЕАЭС N RU Д - RU. АЕ34.В.06393/19, ЕАЭС N RU Д - RU. РА01.В.34047/20 с 02.01.2022;
консервы рыбные стерилизованные. Сайра тихоокеанская натуральная с добавлением масла торговой марки «Фаворит», масса нетто 250 г (жестебанка), дата изготовления 12.08.2021, срок годности 24 месяца с даты изготовления, ГОСТ 13865-2000, изготовитель ООО «Фортуна Крым», Республика Крым, г. Симферополь (импортер в Республику Беларусь ООО «Белое море», г. Минск) - не соответствуют ТР ЕАЭС 040/2016, ТР ТС 021/2011, ТР ТС 022/2011, ГОСТ 13865-2000 по безопасности, органолептическим показателям и маркировке: в части введения потребителя в заблуждение относительно вида рыбы, указанного в наименовании продукции, фактически: использована сельдь, при заявленной в маркировке потребительской упаковки сайре; вкус - не свойственный консервам данного вида с посторонним привкусом и горечью; запах - не свойственный консервам данного вида с посторонним запахом; состояние рыбы-куски сельди, вместо сайры; цвет мяса рыбы – не свойственный варенному мясу сельди; цвет бульона - темный, мутный, при норме светлый с незначительным помутнением от взвешенных частиц белка; порядок укладывания – высота кусков сельди ниже внутренней высоты банки на 8-10 мм, при нормируемом не более 4-5 мм (предписание о запрете ввоза и обращения опасной продукции, прекращении действия на территории Республики Беларусь документов об оценке соответствия, об изъятии (отзыве из обращения) продукции от 03.01.2022 № 16-18-123/2); прекращено действие на территории Республики Беларусь декларации о соответствии ЕАЭС N RU Д - RU. НА87.В.04142/20 с 07.01.2022;
печенье с черным предсказанием торговой марки «Chokocat», масса нетто 24 г, дата изготовления сентябрь 2021, годен до сентября 2022; печенье с предсказанием торговой марки «Chokocat» «Птичка», масса нетто 12 г, дата изготовления сентябрь 2021, годен до сентября 2022; печенье с предсказанием торговой марки «Chokocat» «Скелетик», масса нетто 12 г, дата изготовления сентябрь 2021, годен до сентября 2022, изготовитель ООО «Вкусные подарки», Российская Федерация, г. Ижевск (поставщик в Республику Беларусь ООО «Хитзона плюс», г. Витебск) - не соответствует ТР ТС 021/2011, ТР ТС 029/2012, ТР ТС 022/2011, ТР ТС 005/2011 по безопасности и маркировке: в состав печенья, энергетическая ценность которого не снижена, входит сахар и подсластитель сорбит (Е 420), недопустимый для применения при производстве продукции с добавленными сахарами или не со сниженной калорийностью; в маркировке продукции отсутствует надпись «Содержит подсластитель. При чрезмерном употреблении может оказать слабительное действие»; в маркировке потребительской упаковке в составе продукта не указан состав многокомпонентного ингредиента «маргарин, кондитерский», не указан функциональный класс пищевой добавки сорбит (Е 420); отсутствует сведения об энергетической ценности продукции в джоулях; в маркировке печенья с черным предсказанием, масса нетто 24 г, отсутствуют сведения о материале, из которого изготовлена упаковка (предписание о запрете ввоза и обращения опасной продукции, прекращении действия на территории Республики Беларусь документов об оценке соответствия, об изъятии (отзыве из обращения) продукции от 03.01.2022 №06-18-123/3; прекращено действие на территории Республики Беларусь декларации о соответствии ЕАЭС N RU Д - RU. НА81.В.05971/19 с 07.01.2022;
пищевая рыбная продукция (водные беспозвоночные) – сушено-вяленная разделанная (стружка): кальмар, зоологическое наименование кальмар гигантский (DOSIDICUS GIGAS), весовой, масса нетто 1 кг, изготовитель «LONGKOU DAY AND FOOD CO., LTD.», Китай; кальмар (Гигас) паутинка «Огненная» стандарт, сушено-вяленная пищевая рыбная продукция, весовая, масса нетто 1 кг, изготовитель ООО «Синтез Ресурс», Российская Федерация, г. Санкт-Петербург - не соответствует ТР ЕАЭС 040/2016, ТР ТС 021/2011, ТР ТС 029/2012 по безопасности: при производстве продукции использовались заявленные в маркировке, недопустимые для использования при производстве сушено-вяленой пищевой рыбной продукции, пищевые добавки: влагоудерживающий агент (подсластитель) сорбит, консервант сорбат калия – (стружка) кальмар, зоологическое наименование кальмар гигантский (DOSIDICUS GIGAS); бензоат натрия, сорбат калия - кальмар (Гигас) паутинка «Огненная» стандарт (предписание о запрете ввоза и обращения опасной продукции, прекращении действия на территории Республики Беларусь документов об оценке соответствия, об изъятии (отзыве из обращения) продукции от 28.12.2021 №06-18-123/1657; прекращено действие на территории Республики Беларусь деклараций о соответствии ЕАЭС N RU Д - CN. АД11.В.13343/20, ЕАЭС N RU Д - RU. HB25.В.05190/19 с 01.01.2022;
джем клубничный нестерилизованный, в полипропиленовом ведре, масса нетто 700 г, дата изготовления 18.05.2021, срок годности 1 год, изготовитель ИП Агеева Э.А, Российская Федерация, г. Санкт-Петербург, адрес производства Российская Федерация, Новгородская область, Батецкий р-н (импортер в Республику Беларусь ООО «ПВ - Запад», г. Минск) не соответствует ТР ТС 021/2011, ТР ТС 022/2011, ТР ТС 029/2012 по безопасности и маркировке: в части предоставления достоверной информации о составе продукта и отсутствию предупреждающей надписи о наличии красителей, влияющих на активность и внимание детей; фактически в состав продукта входит, обнаруженный в результате проведенный испытаний, незаявленный изготовителем в маркировке синтетический краситель понсо 4R (Е 124) в количестве 57,2 мг/кг; в маркировке отсутствует предупреждающая надпись «Содержит красители, которые могут оказывать отрицательное влияние на активность и внимание детей» (предписание о запрете ввоза и обращения опасной продукции, прекращении действия на территории Республики Беларусь документов об оценке соответствия, об изъятии (отзыве из обращения) продукции от 29.12.2021 №06-18-123/1664; прекращено действие на территории Республики Беларусь декларации о соответствии ЕАЭС N RU Д - RU. СП30.В.07732/20 с 02.01.2022;
сазан - соломка рыбная солено-сушеная; щука - соломка рыбная солено-сушеная; вобла - соломка рыбная солено-сушеная, изготовитель ООО «Южно-Волжская Компания», Российская Федерация, г. Астрахань (импортер в Республику Беларусь ООО «АЭКС», г. Минск) - не соответствует ТР ТС 021/2011, ТР ТС 029/2012, ТР ЕАЭС 040/2016 по безопасности: при производстве продукции применялась, заявленная изготовителем в маркировке, пищевая добавка-консервант сорбат калия (Е 202), недопустимая для использования при производстве солено-сушеной пищевой рыбной продукции (предписание о запрете ввоза и обращения опасной продукции, об изъятии (отзыве из обращения) продукции от 28.12.2021 №06-18-13/1658) с 01.01.2022;
карамель с шипучей начинкой «ЖИ-ШИ» микс со вкусом яблока, со вкусом апельсина, со вкусом клубники в индивидуальной упаковке из полимерных материалов, в групповой упаковке, масса нетто 1000 г, изготовлено и упаковано 20.08.2021, годен до 20.08.2022, изготовитель ООО «Невский кондитер Белинский», Российская Федерация, Пензенская область, Белинский район, г. Белинский (импортер в Республику Беларусь ООО «ВитаПродСервис», Гродненская область, г. Лида) - не соответствует ТР ТС 021/2011, ТР ТС 022/2011, ТР ТС 029/2012 по безопасности и маркировке: в части предоставления достоверной информации о составе продукта и отсутствию предупреждающей надписи о наличии красителей, влияющих на активность и внимание детей: фактически в состав продукции входит, обнаруженный в результате проведенных испытаний, незаявленный изготовителем в маркировке синтетический краситель тартразин (Е 102) в количестве 10,2 мг/кг; в маркировке отсутствует предупреждающая надпись «Содержит красители, которые могут оказывать отрицательное влияние на активность и внимание детей» (предписание о запрете ввоза и обращения опасной продукции, об изъятии (отзыве из обращения) продукции от 27.12.2021 №06-18-13/1640 с 31.12.2022;
манго сушеное с маркировкой «GLOBAL NUTS», дата изготовления 04.06.2021, годен до 04.06.2022, упакован в полимерную упаковку, масса нетто 500 г, изготовитель «JINAN HAPPY FOREST FOOD CO., LTD», Китай (импортер в Республику Беларусь ЧП «Шалу», Минская область) - не соответствует ТР ТС 021/2011, ТР ТС 029/2012 по безопасности: в состав пищевого продукта входит заявленный изготовителем в маркировке синтетический краситель тартразин (Е102), обнаруженный в результате проведенных испытаний в количестве 404,2 мг/кг, что недопустимо при производстве данного вида продукции (предписание о запрете ввоза и обращения опасной продукции, об изъятии (отзыве из обращения) продукции от 27.12.2021 №06-18-13/1641 с 31.12.2021;
печенье сдобное с начинкой «Красный бархат» со вкусом пломбира, весовое, масса нетто 1,7 кг, дата изготовления 30.08.2021, срок годности 120 суток, изготовитель ООО «Волшебная мозайка», Украина, г. Харьков (импортер в Республику Беларусь ООО «Витрум плюс», Минская область) - не соответствует ТР ТС 021/2011, ТР ТС 029/2012, ТР ТС 022/2011 по безопасности и маркировке: в результате проведенный испытаний в составе продукта обнаружена незаявленная изготовителем в маркировке пищевая добавка - синтетический краситель понсо 4R (Е 124) в количестве 108,2 мг/кг при норме не более 50 мг/кг (превышено в 2,16 раз); в маркировке продукции отсутствует предупреждающая надпись «Содержит красители, которые могут оказывать отрицательное влияние на активность и внимание детей» (предписание о запрете ввоза и обращения опасной продукции, об изъятии (отзыве из обращения) продукции от 27.12.2021 №06-18-13/1642 с 31.12.2021;
палочки острые с кунжутом, вяленые, масса нетто 500 г, дата изготовления 28.06.2021, срок годности 10 месяцев, изготовитель ООО «Витязь», Владимирская область, Ковровский р-н, д. Шевинская (поставщик в Республику Беларусь ООО «Бирштад Трейд», Витебский район) - не соответствует ТР ЕАЭС 040/2016, ТР ТС 022/2011, ТР ТС 021/2011, ТР ТС 029/2012 в части предоставления достоверных сведений о составе продукции: в результате проведенных испытаний в составе продукции обнаружен, незаявленный изготовителем в маркировке, краситель желтый «солнечный закат» FCF (E 110) в количестве 200,5 мг/кг, недопустимый для использования при производстве данного вида вяленой рыбной продукции; в маркировке продукции отсутствует страна нахождения изготовителя (предписание о запрете ввоза и обращения опасной продукции, об изъятии (отзыве из обращения) продукции от 27.12.2021 №06-18-13/1643 с 31.12.2021;
2) прекращены действия на территории Республики Беларусь документов об оценке соответствия:
масло сливочное «Традиционное» несоленое, массовая доля жира 82,5%, изготовитель ООО «Альянс», Российская Федерация, Республика Татарстан, г. Нурлат (поставщик в Республику Беларусь ИП Сухих Ж.В., г. Новополоцк) - предписание о прекращении действия на территории Республики Беларусь документов об оценке соответствия) от 03.01.2022 №06-18-2/1; прекращено действие на территории Республики Беларусь декларации о соответствии ЕАЭС N RU Д - RU. РА01.В.08895/21 с 07.01.2022;
рыбный кулинарный полуфабрикат: палочки из фарша рыбного в панировке, обжаренные, замороженные торговой марки «ESVA», масса нетто 500 г, дата изготовления 13.08.2021, годен до 13.08.2023, изготовитель ООО «Вичюнай-Русь», Российская Федерация (поставщик в Республику Беларусь УК «ЭкоФорт», Минский райн, н.п. Хатежино, СООО «Морозпродукт», Минская область, г. Марьина Горка) - предписание о прекращении действия на территории Республики Беларусь документов об оценке соответствия) от 27.12.2021 №06-18-2/1644; прекращено действие на территории Республики Беларусь декларации о соответствии (ЕАЭС N RU Д - RU.АЕ34.В.04055/19 с 31.12.2021;
блинчики с курицей (трубочка) Домашние с маркировкой «Добрый повар», замороженные, масса нетто 540 г, дата изготовления 01.11.2021, срок годности 180 суток, ТУ 9119-042-54899698-09, изготовитель ООО «Кубанский бекон», Российская Федерация, Краснодарский край, г. Курганинск (импортер в Республику Беларусь ООО «Формат логистик», Минский район») - не соответствует ТР ТС 021/2011 по микробиологическим показателям: завышенному количеству мезофильных аэробных и факультативно – анаэробных микроорганизмов (КМАФАнМ) и недопустимому наличию бактерий группы кишечной палочки; фактическое значение КМАФАнМ составило 1,2×102 КОЕ/г при допустимом уровне не более 1×103 КОЕ/г (превышено в 120 раз); обнаружены бактерии группы кишечных палочек (колиформы) в 1 г продукта (предписание о прекращении действия на территории Республики Беларусь документов об оценке соответствия) от 29.12.2021 №06-18-2/1665; прекращено действие на территории Республики Беларусь декларации о соответствии ЕАЭС N RU Д - RU.НВ56.В.04694/20 с 02.01.2022;
Информацию подготовила помощник врача-гигиениста Ошмянского районного ЦГЭ Михайлова Анна Сергеевна
19.01.2022
В целях обеспечения санитарно-эпидемиологического благополучия населения и недопущения к реализации продукции, представляющей потенциальную опасность для здоровья людей информируем:
Приправа для плова

-
дата изготовления 17.02.2021, срок годности 24 месяца,
-
расфасована в бумажные пакеты, масса нетто 15 г,
-
штриховой код 4780048900147; условия хранения - хранить в сухом прохладном месте при температуре не выше 200 С и относительной влажности не более 75%,
-
Изготовитель ООО «SPICEEXPERT», Узбекистан. г. Ташкент, ул. Богишамол, 160.
-
Импортер в Республику Беларусь ООО «Первая торгово-логистическая компания», Минская область, Минский район, Боровлянский с/с, 81-1в, каб.14, район д. Дроздово,
-
не соответствует требованиям требованиям ГН, утвержденных постановлением Совета Министров Республики Беларусь от 25.01.2021 № 37, ГН, утвержденных постановлением Министерства здравоохранения Республики Беларусь от 21.06.2013 № 52, ТР ТС 021/2011 по микробиологическим показателям: обнаружен рост БГКП в 0,01г продукта, при норме не допускается в 0,01г продукта и плесени 1,0×104 КОЕ/г, при норме не более 1,0×103 КОЕ/г.
Крекер соленый классический «CRACKERS»
-
термоспаянная полимерная упаковка,
-
дата изготовления 09.09.2021, срок годности 09.09.2022,
-
масса нетто 360 г, штриховой код 8606106808216
-
Изготовитель DELICIOSFOODBOGDANAPOPOVIKA, Республика Сербия, 21000, NOVICAD,12.
-
Импортер в Республику Беларусь ООО «Санта Ритейл», Брестская область, г. Брест, ул. Комсомольская, д. 25/7
-
не соответствует требованиям ТР ТС 029/2012, утвержденных Решением Совета Евразийской экономической Комиссии от 20.07.2012 № 58 по санитарно - химическим показателям: на упаковке отсутствует информация о наличии в составе общей сернистой кислоты (массовая доля общей сернистой кислоты 0,0046%)
Уважаемые покупатели!
При покупке пищевой продукции обращайте внимание на соблюдение условий хранения пищевой продукции, в том числе на температурный режим, внимательно читайте информацию на этикетке (маркировке)!
Информацию подготовила помощник врача-гигиениста Ошмянского районного ЦГЭ Михайлова Анна Сергеевна
19.01.2022
Государственное учреждение «Ошмянский районный центр гигиены и эпидемиологии » информирует об установленных фактах реализации на территории Республики Беларусь импортированной алкогольной продукции, несоответствующей обязательным требованиям технических регламентов Таможенного союза по маркировке потребительской упаковки и Закона Республики Беларусь «О рекламе».
В результате проведения физико-химических испытаний выявлено несоответствие образцов продукции:
- вино виноградное натуральное выдержанное полусладкое красное «METAFORICO TEMPRANILLO VINO TINTO SEMIDULCE», изготовитель VINOS&BODEGASS.A.,Ctra.De las Mesas, Km 1, 1360, Испания; импортер в Республику Беларусь ОАО «Протовары», 224005, г. Брест, ул. Комсомольская, 34;

- вино игристое белое полусладкое «КРИКОВА», изготовитель АО Комбинат по производству вин «Крикова», МД — 2084, Республика Молдова, мун. Кишинэу, г. Крикова, ул. Унгуряну 1; импортер в Республику Беларусь ООО Торговый дом «Крикова», г. Минск, ул. Петра Мстиславца, д. 5, пом. 210, офис 3, требованиям ТР ТС 022/2011 по маркировке (заявленные показатели массовой концентрации сахаров на маркировке не соответствуют фактическим).

Информацию подготовила помощник врача-гигиениста Ошмянского районного ЦГЭ Михайлова Анна Сергеевна
17.01.2022
В целях обеспечения санитарно-эпидемиологического благополучия населения и недопущения к реализации пищевой продукции, представляющей потенциальную опасность для здоровья людей информируем:
Свекла столовая

- урожай 2021, ГОСТ 32285-2013, ГОСТ 1722-85;
- Изготовитель ООО «Комбинат «Восток» Республика Беларусь (юридический адрес: Гомельская область, Гомельский р-н, н.п. Урицкое);
- Не соответствует требованиям ГН, утвержденных постановлением Министерства здравоохранения Республики Беларусь от 21.06.2013 № 52, ГН, утвержденных постановлением Совета Министров Республики Беларусь от 25.01.2021 № 37, ТР ТС 021/2011 по физико - химическому показателю: безопасности «нитраты»: фактическое значение нитратов составило 2349 мг/кг, при допустимом уровне - 1400 мг/кг.
Абрикос сушеный (курага) 1сорт.

- дата изготовления сентябрь 2021, дата упаковывания 08.11.2021, годен до 01.09.2022,
- штриховой код 4810948009173 штриховой код 4813494062081.
- Изготовитель Фермерское хозяйство (СП ООО) «SIROJIDDIN AGRO FRUITS», Республика Узбекистан, Самаркандская область. Ургутский р-н, село Карабулок. Импортер в Республику Беларусь/упаковщик: ЧП «Шалу», Республика Беларусь, 223021, Минская область, Минский р-н, Щомыслицкий с/с, аг. Озерцо, ул. Центральная, д. 35А, пом. 25.
- Не соответствует требованиям Санитарных норм и правил, ГН утвержденных постановлением Министерства здравоохранения Республики Беларусь от 12.12.2012 № 195, ГН, утвержденных постановлением Совета Министров Республики Беларусь от 25.01.2021 № 37, ТР ТС 021/2011, ТР ТС 029/2012 По содержанию сернистой кислоты: обнаружено: 3.49±0,0349 г/кг и 3,44±0,0344 г/кг (контрольная проба) при нормируемом значении – не более 2.0 г/кг.
Смесь «Гламурный коктейль » (сухофрукты)

- дата изготовления 25.11.2021, годен до 25.05.2022,
- Изготовитель ООО «ГРИСАК», 223045, Республика Беларусь, Минская область, Минский р-н, Юзуфовский с/с, р-н д. Юзуфово здание с инвент. № 600/с-128519, адрес производства Республика Беларусь, 220075, г. Минск, ул. Промышленная, 15,
- Не соответствует требованиям ТР ТС 029/2012, утвержденного решением Совета Евразийской экономической комиссии от 20.07.2012 г № 58 по содержанию красителей: краситель тартразин Е 102 фактическое значение 1,8±0,3 мг/кг и 1,4±0,2мг/кг - контрольная проба, при нормируемом значении показателя - не допускается наличие красителя тартразин Е102, краситель желтый «солнечный закат» FCF E110 фактическое значение 0,9±0,1мг/кг и 0,9±0,1мг - контрольная проба.
Резинка жевательная «Бомбер»

- дата изготовления 27.05.2021, срок годности до 27.05.2023,
- штриховой код 4820212962202, номер партии L147.
- Изготовитель ООО «СААДЕТ УКРАИНА»,Украина, г. Черновцы.Импортер в Республику Беларусь ООО «Вельми смачна».
- Не соответствует требованиям Санитарных норм и правил, ГН утвержденных постановлением Министерства здравоохранения Республики Беларусь от 12.12.2012 № 195, ГН, утвержденных Постановлением Министерства здравоохранения Республики Беларусь от 21.06.2013 № 52, ТР ТС 029/2012 по содержанию красителей: обнаружен краситель красный очаровательный Е 129, не заявленный на этикетке.
Информацию подготовила помощник врача-гигиениста Ошмянского районного ЦГЭ Михайлова Анна Сергеевна
13.01.2022
В целях обеспечения санитарно-эпидемиологического благополучия населения и недопущения к реализации продукции, представляющей потенциальную опасность для здоровья людей информируем:
Конфеты глазированные «Волшебный гостинец» с арахисом

-
дата изготовления 13.12.2021, срок годности 6 месяцев.
-
штриховой год 4813135000731,
-
изготовленные по СТБ 2422-2015, упакованные в картонные короба с пленкой термоусадочной ПОФ массой нетто 2,5 кг.
-
Изготовитель Общество с ограниченной ответственностью «Белпищеснаб» (юридический адрес: 223012, Минский район, г.п. Мачулищи, ул. Центральная, д.1А, пом.9; адрес осуществления деятельности: Минская область, 222160, г. Жодино, 2-ой Сухорядский проезд, 3).
-
не соответствует требованиям ТР ТС 021/2011, утвержденного Решением Комиссии Таможенного союза от 09.12.2011 №880, Санитарных норм и правил, ГН, утвержденных постановлением Министерства здравоохранения Республики Беларусь от 21.06.2013 № 52, ГН, утвержденного постановлением Совета Министров Республики Беларусь от 25.01.2021 № 37, по микробиологическим показателям: обнаружено превышение содержания дрожжей.
Конфеты глазированные «ШокоСан арахис»

-
дата изготовления 13.12.2021, срок годности 6 месяцев.
-
штриховой год 4813135000625.
-
изготовленные по СТБ 2422-2015, упакованные в картонные короба с пленкой термоусадочной ПОФ массой нетто 2,5 кг.
-
Изготовитель Общество с ограниченной ответственностью «Белпищеснаб» (юридический адрес: 223012, Минский район, г.п. Мачулищи, ул. Центральная, д.1А, пом.9; адрес осуществления деятельности: Минская область, 222160, г. Жодино, 2-ой Сухорядский проезд, 3).
-
не соответствует требованиям ТР ТС 021/2011, утвержденного Решением Комиссии Таможенного союза от 09.12.2011 №880, Санитарных норм и правил, ГН, утвержденных постановлением Министерства здравоохранения Республики Беларусь от 21.06.2013 № 52, ГН, утвержденного постановлением Совета Министров Республики Беларусь от 25.01.2021 № 37, по микробиологическим показателям: обнаружено превышение содержания дрожжей.
Вафли «Восточные» с курагой

-
дата изготовления 13.12.2021 срок годности 6 месяцев
-
штриховой год 4813135000458.
-
Изготовитель Общество с ограниченной ответственностью «Белпищеснаб» (юридический адрес: 223012, Минский район,г.п. Мачулищи, ул. Центральная, д.1А, пом.9; адрес осуществления деятельности: Минская область, 222160, г. Жодино, 2-ой Сухорядский проезд, 3).
-
не соответствует требованиям РЦ BY 101362548.067-2021 по физико-химическим показателям: массовая доля влаги, массовая доля сахара, массовая доля жира.
Мясо птицы. Бедро цыпленка-бройлера охлажденное торговой марки «Петруха»

-
дата изготовления 10.12.2021, годен до 20.12.2021 в упакованном виде с даты изготовления при температуре от 0 до +20 С.
-
штриховой код 4811969004321.
-
изготовитель: Закрытое акционерное общество «Серволюкс Агро», Могилевская область, Могилевский район, Дашковский сельский совет, аг. Межисетки, ул. Фабричная, 14.
-
не соответствует требованиям Санитарных норм и правил и ГН, утвержденных постановлением Министерства здравоохранения Республики Беларусь 21.06.2013 № 52, утвержденного Решением Комиссии Таможенного союза от 09.12.2011 №880 по микробиологическому показателю: L.monocytogenes обнаружена в 25,0 г продукта, при нормируемом показателе - не допускаются 25,0 г.
Изюм виноград сушеный коричневый без косточек, тип А торговой марки «Копеечка»

-
дата изготовления 01.03.2021, дата упаковки 27.03.2021, годен до 01.03.2022
-
штриховой код 4810948008589
-
Изготовитель:Фермерское хозяйство «СИЕБ-ШАВКАТ-ОРЗУ», Республика Узбекистан, Самарканская область, Тайлякский район, с. Курганча.
-
Импортер в Республике Беларусь:ООО «Продхимснаб», г. Минск, ул. Промышленная, д. 6Б/2, комната12. Упаковщик Частное предприятие«Шалу», Республика Беларусь,Минская область,Минский район,Щомыслицкий с/с, аг. Озерцо, ул. Центральная, д.35А, пом.25
-
не соответствует требованиям ТР ТС 021/2011, утвержденного Решением Комиссии Таможенного союза от 09.12.2011 №880, Санитарных норм и правил, ГН, утвержденных постановлением Министерства здравоохранения Республики Беларусь от 21.06.2013 № 52, ГН, утвержденного постановлением Совета Министров Республики Беларусь от 25.01.2021 № 37, по микробиологическим показателям: содержанию плесени в количестве 1,8х103 КОЕ/г, при нормируемом значении не более 5х102.
Икра лососевых рыб имитированная «РЫБАХИТ»

-
дата изготовления 18.10.2021, годен до 18.08.2022.
-
Изготовитель: ООО «Лунское море», 603038, Российская Федерация, Нижегородская область, г. Нижний Новгород, ул. Кима, 337 (юридический адрес: 684010, Российская Федерация, Камчатский край, Елизовский район, пос. Нагорный, территория Птицефабрика Восточная).
-
Поставщик в Республику Беларусь: ООО «Евроторг» (юридический адрес: 220099, Республика Беларусь, г. Минск, ул. Казинца, 52А-22).
-
не соответствует требованиям ТР ТС 029/2012, утвержденного решением Совета Евразийской экономической комиссии от 20.07.2012 г № 58 по безопасности: в составе пищевой продукции обнаружена бензойная кислота с массовой долью 0,85±0,09 г/кг, 0,66±0,06 г/кг
Соус соевый стерилизованный острый «Columb»

-
дата изготовления: 10.05.2021, годен до 10.05.2023.
-
штриховой код 8 936032 097065
-
Изготовитель: «VIETNAM LOTUS.,JSC» ROOM 401, HOUSE N2D, LEVANLUONG STR., THANHXUAN DIS., HANOI, Вьетнам.
-
Импортер в Республику Беларусь: общество с ограниченной ответственностью «Добрада», 220113, г. Минск, ул. Якуба Колоса, д. 73/2 (юридический адрес: 220125, г. Минск, ул. городецкая, д. 64, к.3).
-
не соответствует требованиям ТР ТС 029/2012, утвержденного решением Совета Евразийской экономической комиссии от 20.07.2012 г № 58 по безопасности: в составе пищевой продукции обнаружена сорбиновая кислота в комбинации с бензойной кислотой (1,50 г/кг (в том числе сорбиновая кислота (0,80±0,09) г/кг, бензойная кислота (0,70±0,07 г/кг.
Паприка сладкая торговой марки «Avokado»

-
дата изготовления и упаковывания 13.09.2021, годен до 13.09.2024.
-
Изготовитель: Прымат ООО, ul. Chlebowa 14, 44-337 Jastrzebie-Zdroj, Польша, тел.: +48/32/47 33 833.
-
Импортер в Республику Беларусь: ООО «АРШСОЛЬ», 220114, г. Минск, ул. П.Мстиславца, 13-275.
-
не соответствует требованиям ТР ТС 021/2011, утвержденного Решением Комиссии Таможенного союза от 09.12.2011 №880, гигиенического норматива «Показатели безопасности и безвредности для человека продовольственного сырья и пищевых продуктов», утвержденного постановлением Министерства здравоохранения Республику Беларусь № 52 от 21.06.2013, гигиенического норматива «Показатели безопасности и безвредности продовольственного сырья и пищевых продуктов», утвержденного постановлением Совета Мннистров Республику Беларусь № 37 от 25.01.2021 по микробиологическому показателю: в 0,01 г обнаружены БГКП; КМАФАнМ 7,2*106 КОЕ/г; контрольная проба: в 0,01 г обнаружены БГКП; КМАФАнМ 8,9*106 КОЕ/г.
Консервы овощные горошек зеленый из мозговых сортов стерилизованный сорт высший

-
дата изготовления 12.07.2021, срок годности 4 года.
-
штриховой код 4812062007271
-
Изготовитель: акционерное общество «Консеврный завод «Поречский», Российская Федерация, Ярославская обл., Ростовский район, рабочий поселок «Поречье-рыбное,ул. Булатова, д. 51;
-
грузоотправитель (импортер в Республику Беларусь): общество с дополнительной ответственностью «Виталюр» (юридический адрес: Минская обл., Минский р-н, Колодищанский с/с, 9-й км. Московского шоссе, АБК, ком.1).
-
гигиенического норматива «Показатели безопасности и безвредности для человека продовольственного сырья и пищевых продуктов», утвержденного постановлением Министерства здравоохранения Республику Беларусь № 52 от 21.06.2013 по органолептическому показателю (по вкусу образец неоднороден, в одной банке без постороннего привкуса, во второй – с кисловатым привкусом).
Уважаемые покупатели!
При покупке пищевой продукции обращайте внимание на соблюдение условий хранения пищевой продукции, в том числе на температурный режим, внимательно читайте информацию на этикетке (маркировке)!
Информацию подготовила помощник врача-гигиениста Ошмянского районного ЦГЭ Михайлова Анна Сергеевна
31.12.2021
В целях защиты потребительского рынка от небезопасной и некачественной продукции санитарно-эпидемиологической службой Республики Беларусь продолжаются мероприятия технического (технологического, проверочного) характера по отбору проб и образцов пищевой продукции, находящейся в реализации.
По результатам испытаний, выявлена пищевая продукция, несоответствующая санитарно-эпидемиологическим требованиям:
Смесь из сухофруктов (компотная смесь) № 1 сорт 1

-
дата изготовления 28.02.2021
-
дата упаковывания 28.02.2021
-
срок годности 12 месяцев с даты изготовления
-
изготовитель ЧП «Umar Kishmish Servis», Республика Узбекистан, 141500, Самаркандская область, Паярикский район, г. Челек, ССГ Кумчук, ул. Истиклал
-
импортер в Республику Беларусь ООО «Грасп», Республика Беларусь, 212012, г. Могилев, пер. Гаражный, 29
-
не соответствует требованиям по микробиологическому показателю (обнаружена плесень и КМАФАнМ).
Виноград сушеный черный 2-й сорт

-
дата изготовления 16.10.2021
-
дата упаковывания 29.11.2021
-
срок годности 12 месяцев с даты изготовления
-
изготовитель ЧП «Umar Kishmish Servis», Республика Узбекистан, 141500, Самаркандская область, Паярикский район, г. Челек, ССГ Кумчук, ул. Истиклал
-
импортер в Республику Беларусь ООО «Грасп», Республика Беларусь, 212012, г. Могилев, пер. Гаражный, 29
-
не соответствует требованиям по микробиологическому показателю (обнаружена плесень).
Мивина. Приправа вкусовая куриная сухая

-
упаковано в потребительскую упаковку массой нетто 160 г
-
дата изготовления 11.10.2021
-
срок годности 12 месяцев
-
штриховой код 7613035794078, ТУ У 22686908-004-99
-
изготовитель ООО «Техноком», Украина, 61105, г. Харьков, пр. Героев Сталинграда, д.45
-
импортеры в Республику Беларусь ООО «Нестле Бел», Республика Беларусь, 220140, г. Минск, ул. Домбровская, 9, офис 3.1.1, ИООО «АЛИДИ-вест» Республика Беларусь, 2201140, г. Минск, ул. Домбровская, 9, офис 7.3.1
-
не соответствует требованиям по микробиологическому показателю (обнаружена плесень).
Уважаемые покупатели!
В целях недопущения употребления в пищу недоброкачественных пищевых продуктов обращайте внимание на условия хранения пищевой продукции, внимательно читайте информацию на этикетке (маркировке), просите продавца предоставить документы, подтверждающие качество и безопасность!
04.01.2022

Государственное учреждение «Ошмянский районный центр гигиены и эпидемиологии» информирует, что Заместителем Главного государственного инспектора Республики Беларусь по надзору за соблюдением технических регламентов с 9 декабря 2021 года разрешен ввоз и обращение на территории Республики Беларусь пищевой продукции:
киви сушеный весовой (цукаты), изготовитель ««JUNAN GUANGYUAN IMPORT AND EXPORT CO., LTD», Китай, запрещенный предписанием Главного государственного инспектора Республики Беларусь по надзору за соблюдением технических регламентов от 29.10.2021 № 06-18-13/1415 (разрешение от 09.12.2021 № 06-18-4/1544);.
скумбрия атлантическая холодного копчения кусочки «Набор к пиву» «НОРД ПОРТ», изготовитель АО «Русское море», г. Ногинск, Российская Федерация, запрещенная предписанием Главного государственного инспектора Республики Беларусь по надзору за соблюдением технических регламентов от 05.10.2021 № 06-18-123/1333 (разрешение от 09.12.2021 № 06-18-4/1545).
Информацию подготовила помощник врача-гигиениста Ошмянского районного ЦГЭ Михайлова Анна Сергеевна
24.12.2021
Пюре из цветной капусты для детского питания для детей раннего возраста гомогенизиро-ванное, стерилизованное, торговой марки «Ложка в ладошке».

-
партия №30124, дата изготовления 14.05.2021, срок годности 24 месяца
-
в стеклянной банке, масса нетто 100г. штриховой код 4812021000183, СТБ 2051-2010, РЦ BY 691623888.052-2021.
-
изготовитель: общество с ограниченной ответственностью «ЛВЛ Эволюшн», Минская область, Дзержинский район, Станьковский сельский совет, 43.
-
Не соответствует требованиям Санитарных норм и правил, ГН утвержденным постановлением Министерства здравоохранения Республики Беларусь 21.06.2013 № 52, СТБ 2051-2010, РЦ BY 691623888.052-2021 по органолептическому показателю: присутствует посторонний привкус горечи
Рыбные консервы. Консервы из печени рыб стерилизованные, «Печень минтая по-приморски», тонкоизмельчен-ная масса торговой марки «Примрыбснаб»

-
в металлической банке массой нетто 240 г, ГОСТ 13272-2009, штриховой код 4680009030190.
-
дата изготовления 15.12.2019 (3 смена), срок годности не более 24 месяца, условия хранения.
-
Изготовитель АО «Южнорыбфлот», 692954, Россия, Приморский край, г. Находка, мкр. Ливадия, ул. Заводская, 16, Код изготовителя 012 13.
-
Импортер в Республику Беларусь ООО «Белое Море», 220039, г. Минск, ул. Аэродромная, 125, пом. 29А.
-
Не соответствует требованиям ТР ТС 029/2012, принятого решением Совета Евразийской экономической комиссии Решением Комиссии Таможенного союза от 20.07.2012 № 58 по содержанию пищевой добавки: сорбиновая кислота и ее соли ссорбаты в пересчете на сорбиновую кислоту в количестве 99,8±11,0 мг/кг и 130,0±14,8 мг/кг.
Печенье песочное «КУРАБЬЕ БАКИНСКОЕ»

-
в картонной коробке, покрытой полимерной пленкой, вес нетто 0,5 кг.
-
штриховой год 4650063133861, изготовлено по ТУ 9131-002-38042604-2012.
-
дата изготовления 30.11.2021, срок годности 90 суток.
-
изготовитель ООО «Арт-Конд», 188661, Российская Федерация, Ленинградская область, Всеволожский район, пос. Новое Девяткино, территория северной ТЭЦ, дом 5 (юридический адрес: 194352,Россия, г. Санкт-Петербург, ул. Ивана Фомина, д.15/, литера А, помещение 1-Н, оф.1).
-
импортер в Республику Беларусь ЧТПУП «Еванив», 223056, Минская область, Минский район, Смиловичский сельский совет, аг. Сеница, Военный городок № 135а, здание с инвентарным №600/С-32429, пом.35.
-
Не соответствует требованиям ТР ТС 029/2012, утвержденного решением Совета Евразийской экономической комиссии от 20.07.2012 г № 58, ТР ТС 021/2011, утвержденного Решением Комиссии Таможенного союза от 09.12.2011 №880, ТС 022/2011, утвержденного Решением Комиссии Таможенного союза от 09.12.2011 № 881, Санитарных норм и правил, ГН, утвержденных постановлением Министерства здравоохранения Республики Беларусь от 12.12.2012 № 195 по безопасности и маркировке: в составе пищевой продукции обнаружены пищевые добавки, не указанные на маркировке (массовая доля бензойной кислоты и бензоатов (в пересчете на бензойную кислоту) составила 014±0,02 г/кг; массовая доля сернистой кислоты (диоксид серы) и ее солей (в пересчете на диоксид серы) составила 25±4 мг/кг; массовая доля сорбиновой кислоты и сорбатов (в пересчете на сорбиновую кислоту) составила 0,13±0,02 г/кг).
Информацию подготовила помощник врача-гигиениста Ошмянского районного ЦГЭ Михайлова Анна Сергеевна
24.12.2021

Государственное учреждение «Ошмянский районный центр гигиены и эпидемиологии » информирует, что Главным государственным инспектором Республики Беларусь по надзору за соблюдением технических регламентов:
1) запрещен ввоз и обращение опасной продукции, прекращены действия документов об оценке соответствия на территории Республики Беларусь:
мармелад на палочке «Мармеладный светофор» в полимерной упаковке, масса нетто 18 г, дата изготовления 05.07.2021, годен до 04.07.2023, изготовитель «GUANGZHOU YANGTAO TRADING CO., LTD», Китай (поставщик (импортер) в Республику Беларусь ООО «ЭкоПродМаркет», г. Лида) - не соответствует ТР ТС 021/2011, ТР ТС 022/2011, ТР ТС 029/2012 в части ввода потребителя в заблуждение: в результате проведенных испытаний в составе продукта выявлены красители, не заявленные в маркировке – тартразин (Е102), в количестве 163,7 мг/кг (превышено в 3,3 раза), очаровательный красный (Е129), в количестве 81,5 мг/кг (превышено в 1,6 раз), синий блестящий (Е133), в количестве 2,8 мг/кг (предписание о запрете ввоза и обращения опасной продукции, прекращении действия на территории Республики Беларусь документов об оценке соответствия, об изъятии (отзыве из обращения) продукции от 10.12.2021 №06-18-123/1555; прекращено действие на территории Республики Беларусь декларации о соответствии ЕАЭС N RU Д-CN.IIX01.В.10743/20 – с 15.12.2021);
набор карамели «Рози блюз» («Рози блюз» со вкусом апельсина и сливок, «Рози блюз» со вкусом малины и сливок, «Рози блюз» со вкусом земляники и сливок ) весовой в полимерной упаковке, масса нетто 1000 г, в коробке из гофрированного картона, масса нетто 5,0 кг (5 шт. по 1000г), дата изготовления 12.04.2021, годен до 12.04.2022, ТУ 9121-002-00361790-2013, изготовитель АО «АККОНД», Россия, г. Чебоксары (поставщик в Республику Беларусь ОАО «Вельми Смачна», г. Минск; импортер в Республику Беларусь ЗАО «МераГолд», г. Гомель) - не соответствует ТР ТС 021/2011, ТР ТС 029/2012 по безопасности: при производстве данной продукции применялась заявленная в маркировке пищевая добавка – краситель аннато (Е160b), не допустимая для использования при производстве сахаристых кондитерских изделий (предписание о запрете ввоза и обращения опасной продукции, прекращении действия на территории Республики Беларусь документов об оценке соответствия, об изъятии (отзыве из обращения) продукции от 13.12.2021 №06-18-123/1538; прекращено действие на территории Республики Беларусь декларации о соответствии ЕАЭС N RU Д – RU. ТП.02.В.00942/20 - с 18.12.2021);
конфеты неглазированные с желейными корпусами с начинкой «РЫЖАЯ-БЕСТЫЖАЯ» весовые, дата изготовления 21.08.2021, срок годности 6 месяцев, изготовитель ООО «Сладуница», Российская Федерация (поставщик в Республику Беларусь ОАО «Вельми Смачна», г. Минск) - не соответствует ТР ТС 021/2011, ТР ТС 029/2012 по безопасности: при производстве данной продукции применялась заявленная в маркировке не допустимая пищевая добавка – краситель аннато (Е160b) (предписание о запрете ввоза и обращения опасной продукции, прекращении действия на территории Республики Беларусь документов об оценке соответствия, об изъятии (отзыве из обращения) продукции от 13.12.2021 №06-18-123/1560; прекращено действие на территории Республики Беларусь декларации о соответствии ЕАЭС N RU Д.РА.01.В.42983/21 - с 18.12.2021);
2) запрещен ввоз и обращение опасной продукции, на территории Республики Беларусь:
пищевая рыбная продукция кальмар солено-сушеный стружка в полимерной упаковке, масса нетто 18 г, дата изготовления 18.08.2021, срок годности 10 месяцев, ТУ 10.20.32-622-37676459-2019, изготовитель ООО «Витязь», Российская Федерация, Владимирская область, Ковровский район, д. Шевинская (иимпортер в Республику Беларусь ООО «ГрандБиТорг», Минская область) - не соответствует ТР ЕАЭС 040/2016, ТР ТС 029/2012, ТР ТС 021/2011 по безопасности: при производстве продукции использовалась заявленная изготовителем в маркировке недопустимая пищевая добавка –консервант сорбат калия (предписание о запрете ввоза и обращения опасной продукции, об изъятии (отзыве из обращения) продукции от 13.12.2021 № 06-18-13/1557 – с 18.12.2021);
печенье сахарное сложное «ПАРАВОЗИК» постное, весовое, масса нетто 2,5 кг, дата изготовления 30.08.2021, изготовитель ООО «Торговый дом Кондитер», Россия, Ивановская область, г. Купалищи; адрес производства Россия, Ивановская область, Савинский район, п. Савино (поставщик в Республику Беларусь ООО «Витрум-Плюс», г. Минск) - не соответствует ТР ТС 021/2011, ТР ТС 022/2011, ТР ТС 029/2012 по безопасности и маркировке: в результате проведенных испытаний в составе продукта обнаружена не заявленная изготовителем пищевая добавка – синтетический краситель понсо 4R (Е124) в количестве 70,4 мг/кг, при норме не более 50 мг/кг (предписание о запрете ввоза и обращения опасной продукции, об изъятии (отзыве из обращения) продукции от 13.12.2021 № 06-18-13/1559 – с 18.12.2021);
Информацию подготовила помощник врача-гигиениста Ошмянского районного ЦГЭ Михайлова Анна Сергеевна
24.12.2021
В целях защиты потребительского рынка от небезопасной и некачественной продукции санитарно-эпидемиологической службой Республики Беларусь продолжаются мероприятия технического (технологического, проверочного) характера по отбору проб и образцов пищевой продукции, находящейся в реализации.
По результатам лабораторных испытаний выявлена пищевая продукция, несоответствующая санитарно-эпидемиологическим требованиям:
Быстрозамороженные овощи для жарки «По-болгарски» торговой марки «Живи Здорово», дата изготовления 28.09.2021, срок годности до 28.09.2023, штриховой код 4812787004418, масса нетто 400 г, хранить при температуре не выше минус 18°С, после вскрытия упаковки хранить при температуре не выше минус 18°С, изготовитель Oerlemans Foods Siemiatycze Sp. z.o.o., Республика Польша, Семятыче, ул. Армии Краёвой, 31; уполномоченный представитель изготовителя, импортер на территорию Республики Беларусь СП «Санта Импэкс Брест» ООО, г. Брест, ул. Катин Бор, 106А – не соответствуют требованиям по микробиологическим показателям (обнаружены бактерии группы кишечных палочек).
Варено-мороженые водные безпозвоночные. Мясо мидий варено-мороженое, масса нетто 0,5 кг, штриховой код 4814054000130, дата изготовления март 2021 года, дата упаковывания 26.10.2021, срок годности и условия хранения с даты изготовления не более 24 месяцев при температуре минус 180С, изготовитель RIZHAO HUILI AQUATIC РRODUCTS CO. LTD, Китай, упаковщик ООО «Акварезерв», г. Могилев, ул. Резервная, 9а – не соответствует требованиям по микробиологическим показателям (обнаружены бактерии группы кишечных палочек и энтерококки).
Изюм GOLDEN (виноград сушеный желтый), дата изготовления 01.01.2021, дата упаковывания 27.03.2021, годен до 01.01.2023, штриховой код 4810948008626, хранить при температуре не выше 200С и относительной влажности воздуха не более 75%, изготовитель «KOUROSN DRIED FRUITS AND LEGUMES INDUSTRY», Иран, №16, 20th St.Valiasr St, Tehran—Iran, импортер в Республику Беларусь (упаковщик) ЧП «Шалу», Минская область, Минский район, Щомыслицкий с/с, аг. Озерцо, ул. Центральная, д.35 А, пом.25 – не соответствует требованиям по микробиологическим показателям (обнаружены плесени).
Вишня сушеная торговой марки «Белый пеликан», упаковано по ТУ РБ 100523831.001, масса нетто 150 г, дата изготовления 01.10.2020, дата упаковывания 05.04.2021, срок годности до 05.01.2022, штриховой код 4811028004415, изготовитель «JUNAN GUANGYUAN IMPORT AND EXPORT CO. LTD», Китай, INDASTRY DEVELOPMENT ZONE, JUNAN SHANDONG; импортёр, первый поставщик товара на территорию Республики Беларусь и упаковщик ООО «Детави», г. Минск, 2-ой Велосипедный переулок, 32-9 – не соответствует требованиям по содержанию красителей (обнаружено наличие в составе пищевых красителей красный очаровательный Е129 и понсо 4R Е124, не допустимых для использования при производстве фруктов сушеных).
Абрикос сушеный (курага) 1 сорт, дата изготовления 09.2021, дата упаковывания 08.11.2021, годен до 01.09.2022, масса нетто 500 г, штриховой код 4810948009173, изготовитель Фермерское хозяйство (СП ООО) «SIROJIDDIN AGRO FRUITS», Республика Узбекистан, Самаркандская область, Ургутский район, село Карабулок, импортер в Республику Беларусь (упаковщик) ЧП «Шалу», Минская область, Минский район, Щомыслицкий с/с, аг. Озерцо, ул. Центральная, д.35 А, пом.25 – не соответствует требованиям по содержанию консерванта «сернистая кислота».

Изюм «Голден» 2 сорт, дата изготовления 11.2021, дата упаковывания 02.11.2021, годен до 02.11.2022, масса нетто 500 г, штриховой код 4780086400098, хранить при температуре не выше 250С и относительной влажности воздуха не более 75%, изготовитель ООО «AGRO FOOD PARTINTER», Республика Узбекистан, Сырдарьинская область, Мирзаабадский район, Т.Ахмедов СИУ, дом 1, импортер в Республику Беларусь ООО «Асгир», г. Минск, ул. М.Лынькова, дом 125, помещение 13, комната 48 – не соответствует требованиям по маркировке (отсутствует информация о содержании в составе диоксида серы и сульфитов).
Печенье сдобное «Sofio» «Софийка» с кунжутом, масса нетто 1х2,5 кг, дата изготовления 03.11.2021, срок годности 180 суток, штриховой код 460071600288, изготовитель ООО «ДИАД», Россия, Пензенская область, Каменский район, г. Каменка, ул. Рокоссовского, 58, поставщики/импортеры в Республику Беларусь ООО «Витрумплюс», Минская область, Червенский район, Смиловичский сельский совет, аг. Заполье, ул. Садовая, 10; ООО «Евроторг», г. Минск, ул. Казинца, 52А-22 – не соответствует требованиям по маркировке (информация о составе продукции не содержит сведений о наличии пищевой добавки сернистая кислота).
Кабачки свежие, урожай 2021 года, дата упаковывания 22.11.2021, срок годности с даты упаковывания 30 суток, хранить при температуре от 50С до 100С и относительной влажности воздуха от 90 до 95%, изготовитель 3RED TURIZM TASIMACIIK SANAYI VE TICARET LIMITED SIRKETI, Турция, CEDIZLI MAH. TERMESSOS BULVARI NO:42/2102 MURATPASA/ANTALYA/TURKIYE, импортер в Республику Беларусь ООО «Фрутреал», г.Полоцк, ул. Октябрьская, 25/1-6 – не соответствуют требованиям по содержанию нитратов.’

Уважаемые покупатели! Берегите себя и свое здоровье!
Информацию подготовила помощник врача-гигиениста Ошмянского районного ЦГЭ Михайлова Анна Сергеевна
23.12.2021
В целях обеспечения санитарно-эпидемиологического благополучия населения и недопущения к реализации продукции, представляющей потенциальную опасность для здоровья людей информируем, что по результатам испытаний лабораторным отделом выявлена пищевая продукция, несоответствующая санитарно-эпидемиологическим:
Мороженая пищевая рыбная продукция глазированная скумбрия неразделанная, дата изготовления 02.2021, дата фасовки 20.05.2021, срок хранения 24 месяца с даты изготовления при температуре не выше минус 180С, изготовитель 4396 EMPACADORA ALKRISTO DEL MAR S.A., Эквадор, импортер в Республику Беларусь ООО «Белое море», г. Минск, ул. Аэродромная, 125, оф. 29а – не соответствует требованиям по органолептическим показателям – имеется поверхностное и подкожное пожелтение, проникающее в толщу мяса. Рыба с наружными повреждениями, консистенция (после размораживания) – ослабевшая, запах (после размораживания) – окислившегося жира.
Консервы стерилизованные. Икра из кабачков обжаренных Alio premium. Сорт высший, масса нетто 450 г, ГОСТ 2654-2017, дата изготовления 24.07.2020, 29.07.2020, срок годности 36 месяцев, условия хранения : хранить при температуре от 0°С до 25°С и относительной влажность воздуха не более 75 %, изготовитель ООО «Белгородский консервный комбинат», Россия, Белгород, ул. Коммунальная, 1-А, импортеры в Республику Беларусь ООО «Белинтерпродукт», г. Минск, ул. Кижеватова, д.72, корп. 1, комната 3, ООО «Санта Ритейл», г. Брест, ул. Советской Конституции, 26/1 – не соответствует требованиям по содержанию нитратов.
Информацию подготовила помощник врача-гигиениста Ошмянского районного ЦГЭ Михайлова Анна Сергеевна
16.12.2021
В целях обеспечения санитарно-эпидемиологического благополучия населения и недопущения к реализации продукции, представляющей потенциальную опасность для здоровья людей информируем, что по результатам испытаний лабораторным отделом выявлена пищевая продукция, несоответствующая санитарно-эпидемиологическим требованиям:
Рыбные консервы стерилизованные. «Шпроты неразделанные в масле из кильки и хамсы подкопченной», масса нетто 150 г, масса рыбы не менее 90 г, дата изготовления 08.06.2021, срок годности и хранения не более 30 месяцев от даты изготовления, ТУ 10.20.25-001-00101652-2019, штриховой код 4812626000657, изготовитель ООО «Фортуна Крым», Россия, Республика Крым, г. Симферополь, ул. К. Маркса, 14/9, лит. Ц, пом. 81; поставщик в Республику Беларусь ЗАО «Доброном», г. Минск, ул. Янки Лучины, 5 – не соответствует требованиям по органолептическим показателям (вкус: с выраженным привкусом горечи; консистенция: мягкая; состояние: рыба в основной массе с лопнувшими брюшками, разваренная, со сползшей кожицей, при выкладывании из банки разламывается; цвет кожных покровов: коричневый; порядок укладывания: безрядовое, рыба спрессована по форме банки).
Мука пшеничная хлебопекарная высший сорт «Липецкая», ГОСТ 26574-2017, в бумажном пакете массой нетто 2 кг, штриховой код 4602950165776, дата изготовления 23.04.2021, срок годности 12 месяцев, изготовитель филиал Подгоренский мукомольный завод АО «Продовольстенная компания «ЛИМАК», Россия, Липецкая область, г. Липецк, ул. Барашева, дом 3а; поставщик в Республику Беларусь ООО «Фудлогистик», г. Минск, 4-ый переулок Кольцова, д. 53, помещение 1, кабинет 30 – не соответствует требованиям по органолептическому показателю (наличие постороннего вкуса не свойственного пшеничной муке, с кисловатым привкусом).
Сливы сушеные без косточки (чернослив), дата изготовления 01.09.2021, дата упаковывания 12.10.2021, срок годности 09.2022, масса нетто 500 г, штриховой код 4813635006028, изготовитель ООО «Samarkand export fruits», Республика Узбекистан, Самарская область, Самарский р-н, село Дашти Сухта, импортер в Республику Беларусь ООО «Евроторг», г. Минск, ул. Казинца, 52а-22 – не соответствует требованиям по микробиологическим показателям (дрожжи).
Крекер «Кристо-Твисто» со вкусом сметаны и зеленью, дата изготовления 03.11.2021, срок годности 03.08.2022, штриховой код 4602292015425, в полимерной упаковке массой 205 г, изготовитель АО «Кондитерская фабрика «БЕЛОГОРЬЕ», Россия, Белгородская область, г. Белгород, ул. Промышленная, д. 19; поставщики в Республику Беларусь ООО «Евроторг», г. Минск, ул. Казинца, 52а-22; ЗАО «Доброном», Республика Беларусь, г. Минск, ул. Янки Лучины, 5; ООО «ОрионСвит», Минский район, п/у Колядичи, ул. Бабушкина, 90, офис 304 – маркировка продукта не содержит сведений о наличии пищевой добавки «сернистая кислота».
Информацию подготовила помощник врача-гигиениста Ошмянского районного ЦГЭ Михайлова Анна Сергеевна
16.12.2021
В целях обеспечения санитарно-эпидемиологического благополучия населения и недопущения к реализации продукции, представляющей потенциальную опасность для здоровья людей информируем:
Печенье сахарное «Говорушки» с ароматом топленного молока
-
дата изготовления 31.03.2021, срок годности 12 месяцев.
-
штриховой код 4640013455013
-
в упаковке по1,0 кг ,хранить при температуре (18±5°С) и относительной влажности не более 75%.
-
изготовитель: ООО «Кондидерское объединение «Сладиал», Российская Федерация, 623388, Свердловская область, г. Полевской, Восточно- промышленный район, 4/5.
-
импортер в Республику Беларусь: «ВитаПродСервис», Республика Беларусь, Гродненская область. г. Лида, ул. Толстого, 26.
-
не соответствует требованиям TP ТС 029/2012, утвержденного решением Совета Евразийской экономической комиссии от20.07.2012 г№58 по содержанию пищевой добавки сернистой кислоты. В данном виде продукта наличие сернистой кислоты не допускается, фактическое значение 43,б±7,8 мг/кг.
Свекла столовая свежая

-
дата фасовки 21.11.2021, срок годности 30 суток
-
изготовитель: фермерское хозяйство «Чубенко В.А.», Гомельская область, Октябрьский р-н, д. Романищи, ул. Фермерская, 1.
-
поставщик в Республику Беларусь: ООО «Фудлогистик, г. Минск, пер. 4-й, Кольцова 53, пом. 1.
-
не соответствует требованиям Санитарных норм и правил ГН, утвержденных Постановлением Министерства здравоохранения Республики Беларусь от 21.06.2013 №52, по содержанию нитратов: содержание нитратов в исследованном образце (пробе) составила 2217,000 при норме 1400,0.
Приправа для курицы SPICE EXPERTв бумажных пакетах
-
дата изготовления 21.02.2021, срок годности 24 месяца
-
масса нетто 15 г, штриховой код 4780048900208
-
хранить в сухом прохладном месте при температуре не выше 20° С и относительной влажности воздуха не более 75%
-
изготовитель: ООО «SPICE EXPERT», Узбекистан, г. Ташкент, ул. Богишамол, 160.
-
импортер в Республику Беларусь ООО «Первая торгово- логистическая компания», Минская область, Минский р-н, Боровлянский с/с, 81-1в каб. 14, р-н д. Дроздове.
-
не соответствует требованиям ГН, утвержденных Постановлением Министерства здравоохранения Республики Беларусь OT 21.06.20I3 №52, TP ТС 021/2011, утвержденного Решением Комиссии Таможенного союза от 09.12.2011 №880 по микробиологическим показателям: обнаружены КМАФАнМ 8,5x10s КОЕ/г при нормативе не более 5,0x10s КОЕ/г, плесени 1,5x10* КОЕ/г, при нормативе не более 1хЮ3КОЕ/г.
Мясосодержащие полуфабрикаты в тесте замороженные с мясосодержащей начинкой категории В Манты «По- домашнему»

-
дата изготовления 13.10.2021, срок годности 6 месяцев.
-
штриховой код 4607048470619, ТУ 9214-339-01597945-03.
-
Условия хранения- хранитъ при температуре не выше минус 18°С, после вскрытия упаковки условия хранения и срок годности не изменяются.
-
изготовитель: ИП Кузнецова Татьяна Васильевна, 606032, Российская Федерация, Нижегородская область, г. Дзержинск, ул. Бутлерова, д. 36, кв. 15, адрес производства Российская Федерация, 606007, Нижегородская область, г. Дзержинск, ул. Водозаборная, 10.
-
Поставщик в Республику Беларусь ОДО «Айскинг», 220013, Республика Беларусь, г. Минск, ул. Н.Бровки, 30-29.
-
не соответствует требованиям ГН, утвержденных Постановлением Министерства здравоохранения Республики Беларусь от 21.06.2013 №52, ГН, утвержденных постановлением Совета Министров Республики Беларусь от 25,01.2021 №-37, TP ТС 021/2011, утвержденного Решением Комиссии Таможенного союза от 09.12.2011 №880 по микробиологическому показателю обнаружены БГКП (колиформы) в 0,0001 г.
Полуфабрикат из мяса индейки натуральный (кусковой мясокостный) Стейк голени замороженный
-
СТО 34723448-001-2020, массой 1,055 кг
-
дата изготовления и упаковки: 29.09.2021, годен до 28.03.2022
-
штриховой код 2520815010554
-
Изготовитель: ООО ПК «Урал» (юридический адрес 453852, Россия, Республика Башкортостан, Мелеузовский район, г. Мелеуз, ул. Совхозная, здание II, эт/пом2/1), адрес производства 453852, Россия, Республика Баитортостан, Мелеузовский район, г.Мелеуз, ул. Совхозная, здание П.
-
Поставщик в Республику Беларусь ООО «ТД Меркаре», 220033, г. Минск, пр-т. Партизанский, д. 8. корп. 14, oqbuc 18, бытовой корпус, К.1) расположенный по адресу: г. Минск, ул. Ольшевского, 4.
-
не соответствует требованиям ГН, утвержденных постановлением Министерства здравоохранения Республики Беларусь от21.06.2013 №52, ГН, утвержденных постановлением Совета Министров Республики Беларусь от 25.01.2021 №37, TP ТС 021/2011, утвержденного Решением Комиссии Таможенного союза от 09.12.2011 №880 по микробиологическому показателю в 0,001 г обнаружены БГКП в 0,001г.
Смесь «Тропикана»
-
25.10.2021, годен до 25.04.2022
-
Изготовитель: ООО «ГРИСАК», Минский р-н, Юзуфовский с/с, район д. Юзуфово, здание с инв. № 600/С-128519, адрес производства г. Минск, ул. Промышленная, 15.
-
не соответствует требованиям Санитарных норм и правил, ГН, утвержденных Постановлением Министерства здравоохранения Республики Беларусь от 21.06.2013 №52, ГН, утвержденного постановлением Совета Министров Республики Беларусь от 25.01.2021 №37 по органолептическим показателям вкус и запах с посторонним привкусом.
Кабачки цукини
-
урожай 2021 года, дата упаковывания 02.11.2021, срок годности 180 суток с даты упаковывания.
-
Изготовитель EXQUISTE FRUITS,Plaza del Prado, 21 46702 Gandia (Valencia), Espanda, Испания.
-
Импортер в Республику Беларусь ООО «Артиус-16», 223054, Минская область, Минский р-н, д. Околица, ул. Садовая, д. 3, офис 2.
-
не соответствует требованиям ГН, утвержденному постановлением Совета Министров Республики Беларусь от 25.01.2021 №37, TP ТС 021/2011, утвержденного Решением Комиссии Таможенного союза от 09.12.2011 № 880 по содержанию нитратов (фактическое значение массовой доли нитратов 477±27,0 мг/кг
Арахис (драже) в цветной сахарной глазури
-
дата изготовления 24.08.2021, срок годности 6 месяцев.
-
изготовитель ООО «Деловое партнерство», Российская Федерация, Московская область, городской округ Подольск, деревня Матвеевское, ул. Оборонная, 6.
-
грузоотправитель/поставщик ООО «МАСТЕРФУД», Российская Федерация; грузополучатель ООО «ГРИСАК», Минский район, Юзуфовский с/с, район д. Юзуфово, здание с инв.№600/С-128519.
-
не соответствует требованиям Санитарных норм и правил, ГН, утвержденных Постановлением Министерства здравоохранения Республики Беларусь от 21.06.2013 №52 по микробиологическому показателю - фактическое содержание «плесени» 3,4х103 КОЕ г/см3.
Огурцы свежие среднеплодные гладкие «МЕВА»

-
с датой сбора 17.11.2021 с датой упаковывания 17.11.2021 и сроком годности 15 суток.
-
изготовитель ООО «Тепличный комбинат «Елецкие овощи», Россия, Липецкая область, Елецкий район.
-
импортер в Республику Беларусь ООО «ВитаБалт», г. Гомель, ул. Кооперативная, 30, 4-4 расположенный по адресу: Минская область, Минский р-н, Щомыслицкий с/с, Западный промузел, ТЭЦ-4, каб. 229.
Уважаемые покупатели!
При покупке пищевой продукции обращайте внимание на соблюдение условий хранения пищевой продукции, в том числе на температурный режим, внимательно читайте информацию на этикетке (маркировке)!
Информацию подготовила помощник врача-гигиениста Ошмянского районного ЦГЭ Михайлова Анна Сергеевна
13.12.2021
В связи с выявленными неоднократными фактами обращения на территории Республики Беларусь импортных товаров, не соответствующих установленным санитарно-эпидемиологическим требованиям по показателям безопасности, заместителем Министра здравоохранения – Главным государственным санитарным врачом Республики Беларусь вынесено постановление «О запрете ввоза на территорию Республики Беларусь, реализации, хранения, транспортировки, использования пищевой продукции производства
ООО «ВАЦАК ИНДАСТРИ»
-
Украина» (от 06.12.2021 № 34)
-
на кондитерские изделия в ассортименте производства ООО «ВАЦАК ИНДАСТРИ»
-
место нахождения: Украина, 24000, Винницкая область, г. Могилев-Подольский, ул. Островская, 294;
-
импортер в Республику Беларусь ООО «КД ВАЦАК», Республика Беларусь, Брестская область, г. Пинск, пл. Ленина, 2-19
-
не соответствует требованиям технического регламента Таможенного союза «О безопасности пищевой продукции (ТР ТС 021/2011) по микробиологическим показателям в части превышения допустимых значений содержания БГКП, дрожжей.
Информацию подготовила помощник врача-гигиениста Ошмянского районного ЦГЭ Михайлова Анна Сергеевна
13.12.2021
В целях обеспечения санитарно-эпидемиологического благополучия населения и недопущения к реализации продукции, представляющей потенциальную опасность для здоровья людей информируем:
Каша сухая безмолочная быстрорастворимая обогащенная пробиотическими культурами «NESTLE»

каша сухая безмолочная гречневая с бифидобактериями быстрорастворимая, обогащенная витаминами и минералами, гипоаллергенная без сахара» для питания детского возраста, с 4 месяцев
- упакованная в картонную коробку с бумажным пакетом по 200 г
- дата изготовления 25.08.2021
- годен до 18.11.2022
- штриховой код 4606272031047, ТУ 10.86.10-004-96436727GA426-2A
- изготовитель ООО «Нестле Россия», 115054, Российская Федерация, г. Москва, Павелецкая пл, д. 2, стр.1 (филиал в г. Вологде: 160010, Россия, г. Вологда, ул. Михаила Поповича, д.4а)
- поставщик в Республику Беларусь ИООО «АЛИДИ-Вест», 220140, г. Минск, ул. Домбровская, 9, офис 7.3.1; ООО «ДПМ», 223049, Минская область, Минский р-н, Щомыслицкий с/с, 32/4
- не соответствует требованиям по микробиологическому показателю (обнаружены КМАФАнМ).
Печенье «Сердце сахарное»
- дата изготовления 24.08.2021
- срок годности 180 суток
- по ТУ1072.12-001-87073730-2019
- штриховой код 463058841803
- весовое
- изготовитель ИП Киселева И.М, Российская Федерация, Пензенская область, г. Заречный, ул. Индустриальная,31
- импортер в Республику Беларусь ООО «Витрум плюс», Минская область, Червенский р-н, Смиловичский с/с, аг. Заполье, ул. Садовая, 10, каб. 17
- не соответствует требованиям по содержанию пищевой добавки сернистой кислоты (в данном виде продукта наличие сернистой кислоты не допускается).
Информацию подготовила помощник врача-гигиениста Ошмянского районного ЦГЭ Михайлова Анна Сергеевна
03.12.2021
В целях обеспечения санитарно-эпидемиологического благополучия населения и недопущения к реализации продукции, представляющей потенциальную опасность для здоровья людей информируем:
ГУАВА СУШЕНАЯ

-
торговой марки «OLMISH» Premium
-
дата изготовления 10.06.2021
-
срок годности до 10.06.2022
-
штриховой код 8938533410114
-
изготовитель OLMISH ASIA FOOD COMPANI LIMITED, Въетнам
-
поставщик в Республику Беларусь ООО «ФортунаЛогистик», г. Гомель, проспект Победы, 5А-1
-
не соответствует требованиям по содержанию пищевой добавки и маркировке ((в состав входит обнаруженный в результате проведенных испытаний, незаявленный изготовителем на маркировке консервант: сорбиновая кислота).
РЫБНЫЕ КОНСЕРВЫ

-
Консервы из печени рыб стерилизованные, «Печень минтая по-приморски»
-
тонкоизмельченная масса в металлической банке массой нетто 240 г
-
штриховой код 4680009030190
-
дата изготовления 22.11.2019
-
срок годности не более 24 месяцев
-
изготовитель АО «Южморрыбфлот», 692954, Российская Федерация, Приморский край, г. Находка, мкр. Ливадия, ул. Заводская, 16, завод №13
-
импортер в Республику Беларусь ООО «Белое Море», 220039, г. Минск, ул. Аэродромная, 125, пом. 29А
-
не соответствует требованиям по содержанию пищевой добавки и маркировке (в состав входит обнаруженный в результате проведенных испытаний, незаявленный изготовителем на маркировке консервант: сорбиновая кислота).
НАПИТОК КИСЛОМОЛОЧНЫЙ АЙРАН

-
с массовой долей жира 0,9 % «ТВОЙ ДЕНЬ»
-
ТУ 9220-001-27100863-2015
-
штриховой код 4640107090540
-
в потребительских упаковках (бутылках) из полимерного материала объемом по 0,5 л
-
дата изготовления 13.10.2021, годен до 11.04.2021
-
изготовитель ООО «Реамол», 129347, Российская Федерация, г. Москва, Ярославское шоссе, д. 146, к. 2, оф. 311
-
импортер в Республику Беларусь ООО «Главмолснаб», 212030, г. Могилев, пр-т Мира, 73, офис 801
-
не соответствует требованиям по микробиологическому показателю (по содержанию плесени).
ОРЕХ ГРЕЦКИЙ ОЧИЩЕННЫЙ

-
дата изготовления 08.2021
-
годен до 01.08.2022
-
изготовитель SIROJIDDIN AGRO FRUITS», Республика Узбекистан, Самаркандская область, Ургутский р-н, село Кара булок
-
импортер в Республику Беларусь ЧПТУП «Шалу», Республика Беларусь, 223021, Минская область, Минский р-н, Щомыслицкий с/с, аг. Озерцо, ул. Центральная, д. 35А, пом. 25
-
не соответствует требованиям по микробиологическому показателю (по содержанию плесени).
ДЕСЕРТ ФРУКТОВЫЙ

-
Кисель плодово-ягодный готовый к употреблению клюквенный
-
объем 900 мл
-
дата изготовления 09.11.2021
-
годен до 07.02.2022
-
штриховой код 4620002686864
-
изготовитель ООО «РостАгроКомплекс», Российская Федерация, Московская область, г. Пушкино. Петушки, территория 6-ой км шоссе Братовщина-Ельдигино, владение 1
-
импортер в Республику Беларусь ООО «ЛибераТоргПлюс», г. Минск, пер. Автодоровский, д.15, корп. 2, каб. 215/1
-
не соответствует требованиям по безопасности и маркировке (отсутствует информация на маркировочном ярлыке о содержании в составе синтетического красителя Е-122 «Азорубин» и предупреждающая надпись: «Содержит краситель, который может оказывать отрицательное влияние на активность и внимание детей»).
Информацию подготовила помощник врача-гигиениста Ошмянского районного ЦГЭ Михайлова Анна Сергеевна
30.11.2021
В целях обеспечения санитарно-эпидемиологического благополучия населения и недопущения к реализации продукции, представляющей потенциальную опасность для здоровья людей информируем:
Приправа для плова

-
штриховой код 4780048900147
-
упакована в бумажный пакет
-
масса нетто 15 г, дата изготовления 12.02.2021,
-
cрок годности 24 месяца
-
изготовитель ООО «SPICE EXPERT», Узбекистан, г. Ташкент, ул. Богишамол, 160
-
импортёр в Республику Беларусь ООО «Первая торгово — логистическая компания», Минская область, Минский р-н, Боровлянский с/с, 81-1в, каб. 14, район д. Дроздово
-
не соответствует установленным требованиям по микробиологическому показателю (по содержанию плесени).
Каша сухая молочная быстрорастворимая овсяная с грушей и бананом

-
с бифидобактериями, обогащенная витаминами и минеральными веществами для питания детей раннего возраста с 6 месяцев «NESTLE»
-
продукт упакован в модифицированной атмосфере с азотом в пакет Дой Пак, масса нетто 200 г
-
дата изготовления 30.07.2021
-
штриховой код 4600680005249
-
изготовитель ООО «Нестле Россия», 115054, Российская Федерация, г. Москва, пл. Павелецкая, д.2, стр.1 (филиал в Вологде, 160010, Российская Федерация, г. Вологда, ул. Михаила Поповича, д. 4а)
-
поставщик в Республику Беларусь ИООО «АЛИДИ-Вест», 220140, г. Минск, ул. Домбровская, 9, офис 7.3.1; ООО «ДПМ», 223049, Минская область, Минский р-н, Щомыслицкий с/с, 32/4
-
не соответствует установленным требованиям по микробиологическому показателю (по содержанию дрожжи).
РЫБНЫЕ КОНСЕРВЫ СТЕРИЛИЗОВАННЫЕ «Печень трески по-мурмански»

-
дата изготовления 13.07.2021 г.
-
срок годности 2 года
-
штриховой код 4607019904860
-
изготовитель ООО «Дэма», Российская Федерация, г. Мурманск, ул. Промышленная, 10
-
импортер в Республику Беларусь ООО «Евроторг» г. Минск, ул. Казинца, 52А
-
не соответствует требованиям по органолептическим показателям (внешний вид и цвет: тонкоизмельченная масса, светло-коричневого цвета, цвет выделившегося жира: коричневый, с неприятным запахом).
МОРОЖЕНАЯ ПИЩЕВАЯ РЫБНАЯ ПРОДУКЦИЯ сельдь атлантиченская мороженая 300+ с головой, неразделанная
-
дата изготовления 18.02.2020 г.
-
срок годности до 18.02.2022
-
штриховой код 470009337040000018
-
изготовитель М359, Sevrin Tranvag AS, Tranvagen 6, 6035 FISKARSTRAND, Норвегия
-
импортер в Республику Беларусь ООО «Евроторг», г. Минск, ул. Казинца, 52А
-
не соответствует требованиям по органолептическим показателям (после размораживания поверхность рыбы, с наличием желтоватого налета на поверхности, с участками подкожного пожелтения, проникающего в толщу мяса; с запахом окислившегося жира).
ОГУРЦЫ СВЕЖИЕ

-
среднеплодные гладкие «Мева»
-
дата сбора 04.11.2021
-
дата упаковывания 04.11.2021
-
срок годности с даты упаковывания 15 суток
-
изготовитель ООО «Тепличный комбинат» «Елецкие овощи», Российская Федерация, Липецкая область, Елецкий р-н, Территория Тепличный комбинат Елецкие овощи, сооружение 1
-
импортёр в Республику Беларусь ООО «ВитаБалт», г. Гомель, ул. Кооперативная, д.30, ком. 4-4
-
не соответствует установленным требованиям по санитарно-химическому показателю(содержанию «нитратов» ).
Информацию подготовила помощник врача-гигиениста Ошмянского районного ЦГЭ Михайлова Анна Сергеевна
22.11.2021
В целях обеспечения санитарно-эпидемиологического благополучия населения и недопущения к реализации продукции, представляющей потенциальную опасность для здоровья людей информируем:
Крекер классический

-
штриховой код 4640013457451
-
дата изготовления 24.09.2021, срок годности 6 месяцев
-
изготовитель ООО Кондитерское объединение «Сладиал», 623388, Российская Федерация, Свердловская область, г. Полевской, Восточно-промышленный район, 4/5
-
импортеры в Республику Беларусь ООО «ВитаПродСервис», Гродненская область, г. Лида, ул. Толстого, 26;ООО «ЛенПродуктСервис», г. Минск, ул. Казинца, д. 11 А, офис 506А; ООО «МосПродуктСервис», г. Брест, ул. Карьерная, д.12, корп. 18; ООО «ВитебскПродуктСервис», г. Витебск, пр-т Московский, д. 53, пом № 4; ООО «ГомельПродуктСервис», г. Гомель, ул. Федюнинского, д.17, каб. 4-6
-
не соответствует требованиям по содержанию сернистой кислоты.
Десерт глазированный с варенкой торговой марки «Своя корова»

-
40 г. в упаковке, массовая доля жира 23 % с заменителем молочного жира.
-
штрих-код 4620002688462
-
дата изготовления 31.07.2020, срок годности до 30.08.2020
-
изготовитель ООО «РостАгроКомплекс» (Россия).
-
поставщик на территорию Республики Беларусь ООО «ЛибераТоргПлюс» (г. Минск)
-
не соответствует требованиям по микробиологическим показателям.
Сок гранатовый восстановленный пастеризованный с добавлением сахара торговой марки «Азербайджанский гранат»

-
в стеклянных бутылках, объем 1 л
-
дата изготовления 28.06.2021, срок годности 12 месяцев.
-
изготовитель общество с ограниченной ответственностью «Лидер» (Российская Федерация, г. Москва).
-
поставщик в Республику Беларусь общество с ограниченной ответственностью «Бэст Прайс Экспорт, Российская Федерация, г.Химки»
-
не соответствует требованиям по физико- химическому показателю, обнаружен синтетический краситель азорубин (Е122).
Информацию подготовила помощник врача-гигиениста Ошмянского районного ЦГЭ Михайлова Анна Сергеевна
22.11.2021
В целях обеспечения санитарно-эпидемиологического благополучия населения и недопущения к реализации пищевой продукции, представляющей потенциальную опасность для здоровья людей информируем:
ОРЕХ ГРЕЦКИЙ, ОЧИЩЕННЫЙ

- дата изготовления 01.04.2021
- срок годности 01.04.2022
- изготовитель Shandong Kingland Co., Ltd, East Of North Shugang Road. Lingang Economic Development Zone, Linyi. Shandong Province, Китай
- импортер в Республику Беларусь ООО «Фрутреал», 211401, Республика Беларусь, г. Полоцк, ул. Октябрьская, 25\1-6
- не соответствует требованиям по микробиологическому показателю (обнаружены БГКП (колиформы)).
ЯДРО ГРЕЦКОГО ОРЕХА

- (орех грецкий очищенный светло-янтарный) МИКС (30-35%) «Царские»
- штриховой код 4813635001726
- в полимерных пакетах, массой нетто 60 г
- дата изготовления 25.06.2021, дата упаковывания 07.09.2021
- срок годности 25.06.2022
- изготовитель ООО «Натси», 89422, Украина, Закарпатская область, Ужгородский район, с. Минай, ул. Можайского, д. 12
- импортер в Республику Беларусь ООО «Продхимснаб», 220075, г. Минск, ул. Промышленная, д. 6 Б/2, ком. 12
- не соответствует требованиям по микробиологическому показателю (обнаружена плесень).
Чернослив сушеный «Испанка» без косточки

- в картонных коробах с полиэтиленовым вкладышем внутри массой 10,0 кг.
- дата изготовления 22.06.2021, срок годности 22.06.2022,
- изготовитель ООО «TRUSTAGRO», Республика Узбекистан, Самаркандская область, Пайарынский р-н, Ахмад Яссавий КФЙ, ул. Обод, 1; импортер в Республику Беларусь ООО «Фрутреал», 211401, Республика Беларусь, г. Полоцк, ул. Октябрьская, 25/1-6, комн. 17;
- продукция не соответствует по микробиологическому показателю: обнаружены дрожжи в количестве 7,8х103КОЕ/г.
Смеси пряностей и специй «Деликат» смесь
- штриховой код 4660009993275
- дата изготовления 16.08.2021, упаковано 16.08.2021, срок годности 24 месяца с даты изготовления.
- изготовитель ООО «Колычевское, производственное предприятие, 142000, Российская Федерация, Московская область, г. Домодедово, Центральный м-н, ул. Промышленная, д. 17; поставщик в Республику Беларусь ЧТУП «Спецальянсбел», 220141, г. Минск, ул. Ф.Скорины, д. 50, к. 5;
- продукция не соответствует по микробиологическому показателю: обнаружены КМАФАнМ в количестве 1,5х105КОЕ/г, плесени в количестве 1,6х103КОЕ/г.
П
ищевая рыбная продукция мороженная фасованная форель радужная «Стейк» мороженная
- дата изготовления 11.03.2021, срок годности 10.03.2022, дата упаковывания 23.03.2021.
- штриховой код 4812921004663;
- изготовитель ООО «Фуд Тим», Российская Федерация, Московская область, г. Дмитров, ул. Внуковская, д. 66, к. 1; импортер в Республику Беларусь ООО «Камиро-Групп» (юридический адрес: Республика Беларусь, г. Минск, пр. Дзержинского, д. 8, ком. 4);
- продукция не соответствует по органолептическим показателям: внешний вид: после размораживания: куски рыбы с участками подкожного пожелтения, проникающего в толщу мяса, запах (после размораживания) с запахом окислившегося жира, запах (после отваривания) с запахом окислившегося жира.
Информацию подготовила помощник врача-гигиениста Ошмянского районного ЦГЭ Михайлова Анна Сергеевна
12.11.2021
Открыть приготовленные своими руками деликатесы: баночку варенья или маринованных огурчиков, грибов - особое удовольствие.
У каждой хозяйки дома хранятся закупоренные банки овощей, фруктов, ягод, грибов собственного приготовления. Но при несоблюдении правил приготовления консервированных продуктов в банке может таиться смертельная опасность – ботулизм.
В прошлом году на Гродненщине было зафиксировано 3 случая заболевания ботулизмом, пострадало 3 человека, из них 1 ребенок. В двух случаях отравление произошло маринованными грибами и в одном – рыбной продукцией, всё домашнего приготовления. На территории Ошмянского района с 2018 года случаев ботулизма не регистрировалось.
Ботулизмом называется отравление, наступающее при употреблении пищи, содержащей токсин бактерий клостридиум ботулинум. Возбудители ботулизма широко распространены в почве и воде открытых водоёмов, что неизбежно ведёт к попаданию их на овощи и фрукты, в кишечник домашних животных, к заражению рыбы.

Попадая в пищевые продукты, бациллы размножаются и выделяют токсин, который является самым сильным из известных микробных ядов. Причём идеальной средой для появления токсина являются герметично закрытые банки: яд выделяется лишь в анаэробных условиях, то есть без доступа воздуха. Соль и кислоты препятствуют выделению токсина, однако наличие уксуса и соли в заготовках не может на 100% гарантировать их безопасность для здоровья человека. Зачастую токсин в банке никак себя не проявляет (кроме вздутия крышки) - внешний вид продукта остается не изменён, запах и вкус обычные.
Первые симптомы ботулизма — тошнота, рвота, боль в животе, жидкий стул. Затем развивается чувство распирания в желудке, запоры. Позже появляются расстройство зрения, сухость во рту и мышечная слабость. Голова свисает, и больные вынуждены поддерживать её руками. Дыхание становится поверхностным, едва заметным.

При консервации в домашних условиях продуктов необходимо соблюдать элементарные правила: перед тем, как приступить к консервированию чего-либо, необходимо тщательно промыть продукты, банки, в которых вы намерены консервировать, столовые приборы, которые будете использовать; банки после мытья обязательно следует стерилизовать, а крышки, будь то полиэтиленовые или металлические, кипятить. То есть необходимо применить все меры, направленные на исключение загрязнения консервации.

Если среди законсервированных банок Вы заметили бомбажные (вздутые), немедленно выбросьте их содержимое. Если же Вы сами не занимаетесь консервацией, но любите полакомиться такой продукцией, не рискуйте и не покупайте подобные продукты у незнакомых людей с рук. Всегда отдавайте предпочтение консервированной продукции промышленного производства.
В завершение следует отметить, что если после употребления каких-либо консервов Вы заметили ухудшение своего самочувствия, необходимо немедленно обратиться за медицинской помощью. Промедление при этом заболевании крайне опасно. Единственное специальное лекарственное средство от ботулизма - антитоксическая сыворотка, вводимая больному только в стационарном медицинском учреждении. Это единственный препарат, который может спасти. Будьте внимательны к своему самочувствию и здоровью своих близких!!!
Информацию подготовила помощник врача-гигиениста Ошмянского районного ЦГЭ Семенова Антонина Викторовна
15.11.2021
В связи с выявленными неоднократными фактами обращения на территории Республики Беларусь импортных товаров, не соответствующих установленным санитарно-эпидемиологическим требованиям по показателям безопасности, заместителем Министра здравоохранения – Главным государственным санитарным врачом Республики Беларусь вынесены постановления «О запрете ввоза, реализации, транспортировки, использования на территории Республики Беларусь импортной продукции» (от 03.11.2021 №№ 30, 31) на пищевую продукцию:
замороженные полуфабрикаты в ассортименте производства ООО ПЗП «Элика», Украина, Николаевская область, Витовский район, село Котлярево, ул. Комарова, 62; импортер в Республику Беларусь СП «Санта Импэкс Брест» ООО, Республика Беларусь, г. Брест, ул. Катин Бор, 106 а — не соответствует требованиям технического регламента Таможенного союза «О безопасности пищевой продукции (ТР ТС 021/2011) по микробиологическим показателям в части превышения допустимых значений содержания БГКП, L.monocytogenes;
кондитерские изделия в ассортименте производства ООО «КД «ВАЦАК», Украина, Винницкая область, г. Могилев-Подольский, ул. Армянская, 12; адреса места осуществления деятельности по изготовлению продукции: Украина, Винницкая область, г. Могилев — Подольский, ул. Армянская, 4; ул. Владимировская, 9а; площадь Шевченко, 2; импортер в Республику Беларусь ООО «КД ВАЦАК», Республика Беларусь, Брестская область, г. Пинск, пл. Ленина, 2-19 — не соответствует требованиям технического регламента Таможенного союза «О безопасности пищевой продукции (ТР ТС 021/2011) по микробиологическим показателям в части превышения допустимых значений содержания БГКП, КМАФАнМ, S.aureus, плесени, дрожжей.
Информацию подготовила помощник врача-гигиениста Ошмянского районного ЦГЭ Михайлова Анна Сергеевна
11.11.2021
В целях обеспечения санитарно-эпидемиологического благополучия населения и недопущения к реализации пищевой продукции, представляющей потенциальную опасность для здоровья людей информируем:
Хинкали замороженные

мясосодержащий полуфабрикат, штриховой код 4820196524274, дата изготовления 24.07.2021, срок годности 6 месяцев, хранить при температуре не выше минус 180С; изготовитель ООО Производство Замороженных Продуктов «Элика», 57260, Украина, Николаевская область, Витовский р-н, с. Котлярево, ул. Комарова, 62; импортер в Республику Беларусь 224004, СП «Санта Импэкс Брест» ООО, Республика Беларусь, г. Брест, ул. Катин Бор, 106А; продукция не соответствует по микробиологическому показателю: обнаружены БГКП (колиформы) в 0,0001 г, что не допускается.
Мороженная пищевая рыбная продукция «килька мороженая неразделанная фасованная

дата изготовления 28.09.2020, дата упаковывания 21.02.2021, годен до 28.03.2022; изготовитель Латвия SIA «Vergi», Sarkanmuizasdambis, 29, Ventspils, LV-3601; импортер в Республику Беларусь ООО «Фудлогистик» (юридический адрес: г. Минск, пер. Кольцова, 4-й, 53-1, каб. 30); продукция не соответствует по органолептическим показателям: внешний вид рыбы (после размораживания): поверхность рыбы с наличием желтоватого налета на поверхности, окраска светло-серая, с участками подкожного пожелтения, проникающего в толщу мышечной ткани, наружные повреждения: большинство экземпляров рыбы с повреждениями кожи; запах (после размораживания): запах окислившегося жира; запах окислившегося жира; запах (после отваривания): запах окислившегося жира.
Мороженая пищевая продукция, скумбрия атлантическая 300-500 г., штриховой код 4810168049256, дата изготовления 06.09.2020, годен до 01.09.2022; изготовитель А615, SILDARVINNSLAN HF, HAFNARNAUST 6 740, Исландия; импортер в Республику Беларусь СП «Санта Импэкс Брест» ООО, г. Брест, ул. Катин Бор, 106А; продукция не соответствует по органолептическим показателям: внешний вид рыбы с наличием желтоватого налета на поверхности, с участками подкожного пожелтения, проникающего в толщу мышечной ткани, консистенция ослабевшая, с запахом окислившегося жира.
В целях обеспечения санитарно-эпидемиологического благополучия населения и недопущения к реализации пищевой продукции, представляющей потенциальную опасность для здоровья людей информируем:
Хинкали замороженные

мясосодержащий полуфабрикат, штриховой код 4820196524274, дата изготовления 24.07.2021, срок годности 6 месяцев, хранить при температуре не выше минус 180С; изготовитель ООО Производство Замороженных Продуктов «Элика», 57260, Украина, Николаевская область, Витовский р-н, с. Котлярево, ул. Комарова, 62; импортер в Республику Беларусь 224004, СП «Санта Импэкс Брест» ООО, Республика Беларусь, г. Брест, ул. Катин Бор, 106А; продукция не соответствует по микробиологическому показателю: обнаружены БГКП (колиформы) в 0,0001 г, что не допускается.
Мороженная пищевая рыбная продукция «килька мороженая неразделанная фасованная

дата изготовления 28.09.2020, дата упаковывания 21.02.2021, годен до 28.03.2022; изготовитель Латвия SIA «Vergi», Sarkanmuizasdambis, 29, Ventspils, LV-3601; импортер в Республику Беларусь ООО «Фудлогистик» (юридический адрес: г. Минск, пер. Кольцова, 4-й, 53-1, каб. 30); продукция не соответствует по органолептическим показателям: внешний вид рыбы (после размораживания): поверхность рыбы с наличием желтоватого налета на поверхности, окраска светло-серая, с участками подкожного пожелтения, проникающего в толщу мышечной ткани, наружные повреждения: большинство экземпляров рыбы с повреждениями кожи; запах (после размораживания): запах окислившегося жира; запах окислившегося жира; запах (после отваривания): запах окислившегося жира.
Мороженая пищевая продукция, скумбрия атлантическая 300-500 г., штриховой код 4810168049256, дата изготовления 06.09.2020, годен до 01.09.2022; изготовитель А615, SILDARVINNSLAN HF, HAFNARNAUST 6 740, Исландия; импортер в Республику Беларусь СП «Санта Импэкс Брест» ООО, г. Брест, ул. Катин Бор, 106А; продукция не соответствует по органолептическим показателям: внешний вид рыбы с наличием желтоватого налета на поверхности, с участками подкожного пожелтения, проникающего в толщу мышечной ткани, консистенция ослабевшая, с запахом окислившегося жира.
03.11.2021
В целях обеспечения санитарно-эпидемиологического благополучия населения и недопущения к реализации пищевой продукции, представляющей потенциальную опасность для здоровья людей информируем:
Котлеты «Казачьи»

полуфабрикаты мясосодержащие рубленые категории Д, быстрозамороженные, дата изготовления и упаковывания 04.05.2021, срок годности 6 месяцев с даты изготовления при соблюдении условий хранения, хранить при температуре не выше 180С, упакован в потребительскую упаковку, массой нетто 450 г; изготовитель 115088, ООО «Триада-Покоторг», Российская Федерация, г. Москва, ул. Угрешская, д. 26, стр. 2; импортер в Республику Беларусь 22013, ОДО «Айскинг», г. Минск, ул. П. Бровки, 30-29; продукция не соответствует по микробиологическому показателю: обнаружена Listeria monocytogenes: фактическое значение показателей по результатам испытаний: обнаружена Listeria monocytogenes в 25,0 при нормирующем значении не допускается в 25.0.м
Цветная капуста быстрой заморозки торговой марки «HORTEX»

0,45 кг, дата изготовления 27.02.2021, срок годности 27.02.2023, штриховой код 5900477015789; изготовитель: Polski Ogrod Sp. z.o.o, Польша; импортер в Республику Беларусь: 224025, СП «Санта Импэкс Брест» ООО, г. Брест, ул. Катин Бор, 106А; продукция не соответствует по микробиологическому показателю: КМАФАнМ – 4,0х105 КОЕ/г при норме не более 1,0х104 КОЕ/г.
Сушеная пищевая рыбная продукция «Тушки анчоусов Столефорус сушеные»

ТУ У 15.2-31959328-003:2005, штриховой код 4820111210343, масса нетто 36 г, дата изготовления, 19.07.2021, срок годности 19.04.2022, хранить при температуре не выше +250С и относительной влажности воздуха не более 75%; изготовитель ООО «Море-2007», Украина, Днепровская область, г. Днепр, ул. Универсальная, д. 1, пом. 17, оф. 4, адрес производственных мощностей, 52500, Украина, Днепропетровская область, г. Синельково, ул. Мира, 5; импортер в Республику Беларусь 220082, ООО «Альфа-Дистрибьюция», г. Минск, ул. Матусевича, д. 20, пом. 12/1; продукция не соответствует по микробиологическому показателю: КМАФАнМ – 2,5х105 КОЕ/г при норме не более 2,0х104 КОЕ/г.
Продукт творожный с клубникой и земляникой «Данон», массовая доля жира 3,6%

ТУ 10.51.56-014-48779702, штриховой код 4600605020081, масса нетто 170 г, дата изготовления 06.09.2021, срок годности 11.10.2021, хранить при температуре 4±20С; изготовитель АО «Данон», 127015, Российская Федерация, г. Москва, ул. Вятская, 27, корп. 13-14, адрес производства 142380, Российская Федерация, Московская область, Чеховский р-н, п. Любучаны, ул. Полевая, 4; импортер в Республику Беларусь ИООО «ДАНОНБЕЛ», Республика Беларусь, г. Минск, пр-т Машерова, д. 76А, пом. 3, оф. 3; продукция не соответствует по микробиологическому показателю: обнаружены БГКП (колиформы) в 0,01 г.
Чебуреки с мясом обжаренные замороженные, мясосодержащий полуфабрикат

штриховой код 4820196524250, дата изготовления 07.08.2021, срок годности 6 месяцев, хранить при температуре не выше -180С; изготовитель ООО «ПЗП» «Элика», Украина, Николаевская область, г. Котлярево, Витовский р-н, ул. Комарова, 62; импортер в Республику Беларусь 224004, СП «Санта Импэкс Брест» ООО, Республика Беларусь, г. Брест, ул. Катин Бор, 106А; продукция не соответствует по микробиологическому показателю: обнаружены БГКП (колиформы) в 0,01 г.
Мороженная пищевая рыбная продукция балтийская шпрот (килька)

8-12 см мороженный упакованный, масса 1,0 кг, штриховой код 4810168050689, дата изготовления 13.10.2020, дата упаковывания 02.11.2020, годен до 13.04.2022; изготовитель SIA «Vergi», Sarkanmuizas dambis, 29, Ventspils, LV-3601, Латвия (юридический адрес: Брестская область, ул. Катина Бор, д. 106А); импортер в Республику Беларусь белорусского-германское совместное предприятие «Санта Импэкс Брест» ООО; продукция не соответствует по органолептическим показателям: внешний вид: часть экземпляров рыбы с наличием желтоватого налета на поверхности; окраска: от светло-серой с участками подкожного пожелтения, проникающего в толщу мышечной ткани; наружные повреждения: большинство экземпляров рыбы с повреждениями кожи; запах (после отваривания): с запахом окислившегося жира.
Информацию подготовила помощник врача-гигиениста Ошмянского районного ЦГЭ Михайлова Анна Сергеевна
01.11.2021
В целях обеспечения санитарно-эпидемиологического благополучия населения и недопущения к реализации пищевой продукции, представляющей потенциальную опасность для здоровья людей информируем:
Дыня свежая

- урожай 2021 года, дата сбора: 16.09.2021, срок годности: 50 суток с даты сбора.
- страна происхождения: Российская Федерация, изготовитель: Крестьянское (фермерское) хозяйство Девятаева Александра Егоровича, Российская Федерация, 403408, Волгоградская обл., Кумылженский р-н, хутор Чиганаки 2-е, импортер в Республику Беларусь и поставщик: ООО «Санта Ритейл», Республика Беларусь, г.Брест, ул.Советской Конституции, д.26/1.
-
Не соответствует требованиям требованиям ТНПА по физико-химическому показателю «нитраты»: фактическое значение: 135±13 мг/кг, при допустимом уровне: не более 90 мг/кг.
Соус соевый классический стерилизованный COLUMB

-
дата изготовления 10.04.2021, срок годности 10.04.2023.
-
изготовитель «VIETNAM LOTUS., JSC» ROOM 401, HOUSE N2D. LEVAN LUONG STR., THANH XUAN DIST., HANOI, Вьетнам; импортер в Республику Беларусь ООО «Добрада», 220125, г. Минск, ул. Городецкая, д. 64, к.3.
-
Не соответствует требованиям по содержанию консервантов: сорбиновая кислота (Е200) и сорбаты (Е201-Е203) в комбинации с бензойной кислотой (Е210) и бензоатами (Е211-Е213), в перерасчете на соответствующую кислоту составило 1,5 г/кг (в т.ч. сорбиновая кислота 0,8±0,1 г/кг, бензойная кислота 0,7±0,1 г/кг) при нормативе не более 1,0 г/кг.
Приправа сухая «Карри нежная»

- Дата изготовления: 11.01.2021, срок годности 24 месяца,
- Изготовитель VIJI FOODS E-2, LATI BAZAR, ZONE-1, JAMALPUR ROAD, AHMEDABAD, GUJARAT, INDIA Индия, (юридический адрес: Республика Беларусь, 220141, г. Минск, ул. Ф. Скорины, д. 50, к. 5; импортер в Республику Беларусь ЧТУП «Спецальянсбел», г. Минск, ул. Ф. Скорины, д. 50, к. 5 .
- Не соответствует по микробиологическому показателю: обнаружены КМАФАнМ в количестве 5,0х104 КОЕ/г, плесени в количестве 3,6х103 КОЕ/г.
Смесь универсальная «Смеси пряностей и специй Деликат»

- Дата изготовления 05.2021, упаковано 05.2021, срок годности 24 месяца с даты изготовления .
- Изготовитель ООО «Колычевское производственное предприятие», Российская Федерация, 14000, Московская область, г. Домодедово, Центральный м-рн, ул. Промышленная, д. 17 (юридический адрес: Республика Беларусь, 230025, г. Гродно, ул. Победы, 31); импортер в Республику Беларусь ООО «СпецНатурПродукт», г. Гродно, ул. Победы, 31 .
- Не соответствует требованиям по микробиологическому показателю: обнаружены КМАФАнМ в количестве 4,3х104 КОЕ/г, плесени в количестве 4,5х102 КОЕ/г
Свекла столовая свежая фасованная

-
Урожай 2021, дата сбора 22.09.2021, дата фасовки 22.09.2021, срок годности не более 30 суток с даты изготовления.
-
Изготовитель КФХ «АгроЛайнПлюс», Республика Беларусь, Минская область, Смолевичский р-н, аг. Слобода, ул. Железнодорожная, 84.
-
Не соответствует по содержанию нитратов: фактическое содержание нитратов 2488 мг/кг при норме 1400 мг/кг.
Информацию подготовила помощник врача-гигиениста Ошмянского районного ЦГЭ Михайлова Анна Сергеевна
22.10.2021
В целях обеспечения санитарно-эпидемиологического благополучия населения и недопущения к реализации пищевой продукции, представляющей потенциальную опасность для здоровья людей информируем:
Мивина. Приправа вкусовая грибная сухая.

- Дата изготовления 09.06.21г. годен до 04.06.22г.
- Изготовитель: ООО «Техноком», Украина, 61105. г.Харьков, пр.Героев Сталинграда, д.45. Адрес производства: Украина, 61031г.Харьков, пр.Гагарина, д.217. Импортеры в Республике Беларусь: ООО «Нестле Бел», Беларусь,220140, г.Минск, ул.Домбровская,9 офис 3.1.1.; ИООО «АЛИДИ-Вест», Беларусь, 220140, г.Минск, ул.Домбровская,9, офис 7.3.1.
- Не соответствует требованиям технического регламента Таможенного союза 021/2011 «О безопасности пищевой продукции»,утв. Решением Комиссии Таможенного союза от 09.12.2011 № 880, Гигиенического норматива, утвержденного постановлением Министерства здравоохранения Республики Беларусь от 21 июня 2013 №52, Гигиенического норматива «Показатели безопасности и безвредности для человека продовольственного сырья и пищевых продуктов», утвержденного Постановлением Совета Министров Республики Беларусь от 25.01.2021 №37: не прошли испытания по исследованному показателю наличию БГКП(коли-формы) в 0,01г: обнаружены в 0,01г.
Хинкали замороженные мясосодержащий полуфабрикат

- Дата изготовления 07.08.21г. срок годности 6 месяцев.
- Изготовитель: ООО ПЭП «Элика», Украина, Николаевская область, Витовский район, с. Котлярево,ул. Комарова, 62, 57260, тел./факс (0512) 683633. Поставщик: ООО «ЮГФУД», 19-км Старокиевской дороги, г. Одесса, Одеская область, 65025, Украина, тел.(+380482)305315.Адрес мощностей производства: 463км + 700м автодороги Киев-Одесса, Беляевский р-н, Одесская обл., 65031, Украина. Импортер и организация уполномоченная на принятие претензий в Республике Беларусь: СП «Санта Импэкс Брест», ООО Республика Беларусь, 224004, г. Брест, ул. Катин Бор 106А.тел.
- Не соответствует требованиям технического регламента Таможенного союза 021/2011 «О безопасности пищевой продукции»,утв. Решением Комиссии Таможенного союза от 09.12.2011 № 880, Гигиенического норматива, утвержденного постановлением Министерства здравоохранения Республики Беларусь от 21 июня 2013 №52, Гигиенического норматива «Показатели безопасности и безвредности для человека продовольственного сырья и пищевых продуктов», утвержденного Постановлением Совета Министров Республики Беларусь от 25.01.2021 №37: не прошли испытания по исследованному наличию Listeria Monocytogenes в 25,0г: обнаружены в 25,0г.
ТМ «Пломбиркин» Мороженое с заменителем молочного жира с ароматом йогурта с фруктово-ягодным наполнителем «киви» в вафельном стаканчике «киви в йогурте»

- Дата изготовления:08.07.2021 (А), годен до 08.07.2022
- Изготовитель (А): индивидуальный предприниматель Пашин Александр Юрьевич. Юридический адрес: 603116, Российская Федерация, Нижегородская область, город Нижний Новгород, улица Генерала Зимина, дом 22, квартира 57. Адрес производства: 607664, Российская Федерация, Нижегородская область, город Кстово, улица Ступишина, дом 2. Поставщик в Республику Беларусь ОДО «Айскинг», 220013, г. Минск, ул. П.Бровки 30-29, Республика Беларусь.
- Не соответствует требованиям технического регламента Таможенного союза 021/2011 «О безопасности пищевой продукции»,утв. Решением Комиссии Таможенного союза от 09.12.2011 № 880, Гигиенического норматива, утвержденного постановлением Министерства здравоохранения Республики Беларусь от 21 июня 2013 №52, Гигиенического норматива «Показатели безопасности и безвредности для человека продовольственного сырья и пищевых продуктов», утвержденного Постановлением Совета Министров Республики Беларусь от 25.01.2021 №37: не прошли испытания по микробиологическому показателю.
Хрумпилсы из курицы барбекю (BBQ) «Мираторг». Изделие кулинарное из мяса птицы рубленое замороженное

- Дата изготовления 03.03.2021 в 09:38:29, годен до 02.05.2022.
- Изготовитель: ООО «Мираторг Запад», Адрес: 238324, Россия, Калининградская обл., Гурьевский р-н, п. Невское, ул. Совхозная, д. 12. Поставщик в Республику Беларусь: СООО «Морозпродукт», адрес: 222810, Республика Беларусь, г. Марьина Горка, ул. Октябрьская, 133-5, тел.: +375172660925. Импортер: ТОО «ПК Деметра». Адрес: Республика Казахстан, г. Алматы, ул. Толе би 302, каб. 15.
- Не соответствует требованиям технического регламента Таможенного союза 021/2011 «О безопасности пищевой продукции»,утв. Решением Комиссии Таможенного союза от 09.12.2011 № 880, Гигиенического норматива, утвержденного постановлением Министерства здравоохранения Республики Беларусь от 21 июня 2013 №52, Гигиенического норматива «Показатели безопасности и безвредности для человека продовольственного сырья и пищевых продуктов», утвержденного Постановлением Совета Министров Республики Беларусь от 25.01.2021 №37: не прошли испытания по микробиологическому показателю.
Информацию подготовила помощник врача-гигиениста Ошмянского районного ЦГЭ Михайлова Анна Сергеевна
21.10.2021
В целях обеспечения санитарно-эпидемиологического благополучия населения и недопущения к реализации пищевой продукции, представляющей потенциальную опасность для здоровья людей информируем:
Полуфабрикаты рубленные из мяса птицы замороженные нагетсы «любительские»

- дата изготовления 29.07.2021, срок годности 180 суток
- Изготовитель ООО «Морозко» 188644, РФ, Ленинградская обл., Всеволожский район, п. Ковалево, ул. Поперечна, д. 15. Импортер в Республику Беларусь ООО «Белое море» г. Минск, ул. Аэродромная, д. 125, пом. 29 А.
Не соответствует требованиям ГН, утвержденного постановлением Министерства здравоохранения Республики Беларусь 21.06.2013 № 52;ГН, утвержденному постановлением Совета Министров Республики Беларусь от 25.01.2021 № 37, ТР ТС 021/2011, утвержденный Решением Комиссии Таможенного союза от 09.12.2011 № 880 по микробиологическим показателям- обнаружена Listeria ( при нормируемом значении не допускается)
Паста ореховая «Nut story» с добавлением каакао

- дата изготовления 22.08.2021, срок годности 22.08.2022.
- Изготовитель ООО «Кондитерский комбинат«Озерский сувенир» 140560, РФ, Московская обл., г. Озерцы, ул. Ленина, д. 13, каб 3. Импортер в Республику Беларусь ИТУП «КДВ БЕЛ», РБ, г. Минск, пер. Липковский , д. 12, оф. 205.
Не соответствует требованиям ГН, утвержденного постановлением Министерства здравоохранения Республики Беларусь 21.06.2013 № 52;ГН, утвержденному постановлением Совета Министров Республики Беларусь от 25.01.2021 № 37, ТР ТС 021/2011, утвержденный Решением Комиссии Таможенного союза от 09.12.2011 № 880 по микробиологическим показателям- обнаружены БГКП (колиформы).
Торт «Наполеон» в картонной упаковке массой нетто 2,0 кг

- дата изготовления 20.09.2021, годен до 27.09.2021 20:00.
- Изготовитель ООО «КД ВАЦАК», (юридический адрес: Украина, 24000, Винницкая обл., г.Могилев-Подольский, ул. Армянская, д.12), адрес производственных мощностей Украина, 24000, Винницкая обл., г. Могилев-Подольский, ул. Армянская, д.14.Импортер в Республику Беларусь ООО «КД «ВАЦАК», 225710, Республика Беларусь, Брестская обл., г. Пинск, пл. Ленина, д. 2-19.
- Не соответствует требованиям ГН, утвержденного постановлением Министерства здравоохранения Республики Беларусь 21.06.2013 № 52;ГН, утвержденному постановлением Совета Министров Республики Беларусь от 25.01.2021 № 37, ТР ТС 021/2011, утвержденный Решением Комиссии Таможенного союза от 09.12.2011 № 880 по микробиологическим показателям - содержанию БГКП (колиформы) (фактическое значение- «обнаружены в 0,1 г», при допустимом уровне «не допускаются в 0,1 г)».
Орех грецкий очищенный, 1 сорт

- Дата изготовления 06.04.2021. срок годности 1 мес.
- Изготовитель ООО «Эгоизм», Украина, Киевская обл., г. Вышеород, ул. Ватутина, д. 69Г, оф. 1/13
- . Импортер в Республику Беларусь/фасовщик ООО «Андивал групп» 212012, г. Молодечно, Ул. Великий гостинец, д. 43,оф. 546.
- Не соответствует требованиям ТР ТС 021/2011, утвержденного Решением Комиссии Таможенного союза от 09.12.2011 № 880, ГН, утвержденному постановлением Совета Министров Республики Беларусь от 25.01.2021 № 37 по микробиологическим показателям: обнаружено содержание «плесени»
Торт «Женский каприз»

- дата 20.09.2021, годен до 27.09.2021.
- Изготовитель ООО «КД ВАЦАК», (юридический адрес: Украина, 24000, Винницкая обл., г. Могилев-Подольский, ул. Армянская, д.12), адрес производственных мощностей Украина, 24000, Винницкая обл., г. Могилев-Подольский, ул. Армянская, д. 4. Поставщик в Республику Беларусь ООО «КД «ВАЦАК», 225710, Республика Беларусь, Брестская обл., г. Пинск, пл. Ленина, д. 2-19.
- Не соответствует требованиям ГН, утвержденному постановлением Совета Министров Республики Беларусь от 25.01.2021 № 37 по микробиологическому показателю: обнаружены БГКП в 0,1 г при требовании ТНПА – не допускается.
Торт «Апельсиновая соната»

- дата 20.09.2021, годен до 27.09.2021.
- Изготовитель ООО «КД ВАЦАК», (юридический адрес: Украина, 24000, Винницкая обл., г. Могилев-Подольский, ул. Армянская, д.12), адрес производственных мощностей Украина, 24000, Винницкая обл., г. Могилев-Подольский, ул. Армянская, д. 4. Поставщик в Республику Беларусь ООО «КД «ВАЦАК», 225710, Республика Беларусь, Брестская обл., г. Пинск, пл. Ленина, д. 2-19.
- Не соответствует требованиям ГН, утвержденному постановлением Совета Министров Республики Беларусь от 25.01.2021 № 37 по микробиологическому показателю: обнаружены БГКП в 0,1 г при требовании ТНПА – не допускается.
Торт «Рафаэль»

- дата изготовления 20.09.2021 20:00, годен до 27.09.2021 20:00 .
- Изготовитель ООО «КД ВАЦАК», (юридический адрес: Украина, 24000, Винницкая обл., г. Могилев-Подольский, ул. Армянская, д.12), адрес производственных мощностей Украина, 24000, Винницкая обл., г. Могилев-Подольский, ул. Армянская, д. 4. Поставщик в Республику Беларусь ООО «КД «ВАЦАК», 225710, Республика Беларусь, Брестская обл., г. Пинск пл. Ленина, д. 2-19.
- Не соответствует ГН, утвержденному постановлением Совета Министров Республики Беларусь от 25.01.2021 № 37 по микробиологическому показателю: обнаружен S.aureus в 0 г при требовании ТНПА - не допускается.
Торт «Смайл»

- дата изготовления 20.09.2021, годен до: 27.09.2021.
- Изготовитель ООО «КД ВАЦАК», (юридический адрес: Украина, 24000, Винницкая обл., г. Могилев-Подольский, ул. Армянская, д.12), адрес производственных мощностей Украина, 24000, Винницкая обл., г. Могилев-Подольский, ул. Армянская, д. 4. Поставщик в Республику Беларусь ООО «КД «ВАЦАК», 225710, Республика Беларусь, Брестская обл., г. Пинск пл. Ленина, д. 2-19.
- Не соответствует требованиям Санитарных норм и правил, ГН, утвержденных Постановлением Министерства здравоохранения Республики Беларусь от 21.06.2013 № 52, ГН, утвержденному постановлением Совета Министров Республики Беларусь от 25.01.2021 № 37,ТР ТС 021/2011, утвержденного Решением Комиссии Таможенного союза от 09.12.2011 № 880 по микробиологическому показателю: обнаружены БГКП (колиформы) в 0,01г, при нормируемом значении: не допускаются в 0,01 г.
Информацию подготовила помощник врача-гигиениста Ошмянского районного ЦГЭ Михайлова Анна Сергеевна
14.10.2021
Паста ореховая NUT STORY с добавлением какао

масса нетто 350 г, дата изготовления 26.05.2021, годен до 26.05.2022, штриховой код 4600452021606, упакована в полимерную упаковку, изготовитель ООО «Кондитерский комбинат «Озерский сувенир»; импортер в Республику Беларусь ИТУП «КДВ БЕЛ», 220138, Республика Беларусь, г. Минск, пер. Липковский, д. 12, офис 205 — не соответствует установленным требованиям по микробиологическому показателю (фактическое содержание «КМАФАнМ» 5,3×104 КОЕ/г, при допустимом уровне не более 5×104КОЕ/г).
Вино гранатовое натуральное полусладкое «NAR»
дата изготовления 16.05.2020, срок годности 2 года, штриховой код 4760022402409; изготовитель Азербайджанская Республика; импортер в Республику Беларусь ООО «Торговый Дом Азербайджана», г. Минск, ул. Ф.Скорины, д. 2, пом. 3 А; поставщик ЗАО «Доброном», г. Минск, ул. Я. Лучины, 5 — не соответствует установленным требованиям по маркировке (на этикетке отсутствует информация о содержании бензойной кислоты).
Уважаемые покупатели!
При покупке пищевой продукции обращайте внимание на соблюдение условий хранения пищевой продукции, в том числе на температурный режим, внимательно читайте информацию на этикетке (маркировке)!
Информацию подготовила помощник врача-гигиениста Ошмянского районного ЦГЭ Михайлова Анна Сергеевна
10.09.2021
В целях обеспечения санитарно-эпидемиологического благополучия населения и недопущения к реализации пищевой продукции, представляющей потенциальную опасность для здоровья людей информируем:
Лещ (сушеный, неразделанный)

сорт 1, в транспортной упаковке – картонной коробке массой нетто 5 кг, дата изготовления 19.04.2021, срок хранения и годности при температуре от 0°С до+20°С и влажности воздуха не выше 75% не более 6 месяцев, изготовитель «ФИШПРОД», Российская Федерация (г. Астрахань, ул. Энергетическая, д. 28Б, пом. 3); импортер в Республику Беларусь ИП Мухин А.В. (г.Гродно, ул. Сов. Пограничников, д. 116) — не соответствует установленным требованиям по микробиологическому показателю (обнаружены «БГКП» (колиформы)).
Хинкали замороженные мясосодержащий полуфабрикат

дата изготовления 10.07.2021, срок годности 6 месяцев до 10.01.2022, изготовитель ООО ПЭП «Элика», Украина (Николаевская область, Витовский район, с. Котлярево, ул. Комарова, 62); поставщик ООО «ЮГФУД», Украина (Одесская область, г. Одесса, 19-км Старокиевской дороги); импортер и организация уполномоченная на принятие претензий в Республике Беларусь СП «Санта Импэкс Брест» ООО, Республика Беларусь (г. Брест, ул. Катин Бор 106А) — не соответствуют установленным требованиям по микробиологическим показателям (обнаружена Listeria monocytogenes).
Дыня свежая

урожай 2021 года, дата упаковывания 28.07.2021, срок годности 30 суток с даты упаковывания при температуре воздуха от +4С до + 6С и относительной влажности воздуха от 85% до 95%, изготовитель Индивидуальный предприниматель «Береке», Казахстан, Туркестанская область, Мактааральский район, поселок Атакент, ул. Ташкентская, 19/20, импортер в Республику Беларусь ООО «РикусФрут», Республика Беларусь, г. Минск ул. Волгоградская, д. 13, каб. 213-103, поставщик ООО «СэйлсГрин», Республика Беларусь, г. Минск, ул. Восточная, д. 39, пом. 2Н — не соответствует установленным требованиям по содержанию нитратов.
Торт «Женский каприз»

в картонной упаковке массой нетто 0,5 кг, дата изготовления 05.08.2021 20:00, годен до 12.08.2021 20:00, изготовитель ООО «КД «Вацак»; импортер в Республику Беларусь ООО «КД «Вацак», 225710, (Республика Беларусь, Брестская обл., г. Пинск, пл. Ленина, д. 2-19) — не соответствует установленным требованиям по микробиологическому показателю – (обнаружен S.aureus).
Сырок творожный глазированный в белом шоколаде с ванилью.

- Дата изготовления 07.2021, срок годности 21.08.2021.
- Изготовитель: ООО «РостАгроКомплекс», 141255, Россия, Московская область. Пушкинский район, шоссе Братовщина-Ельдигино, 6 км.
- Не соответствует требованиям санитарных норм и правил», по микробиологическому показателю: обнаружены дрожжи.
Информацию подготовила помощник врача-гигиениста Ошмянского районного ЦГЭ Михайлова Анна Сергеевна
10.09.2021
Несмотря на хорошо известные внешние признаки ядовитых грибов ежегодно в различных странах мира происходят тяжелые, порой массовые отравления, заканчивающиеся в отдельных случаях смертельным исходом.

Отравления грибами носят чёткий сезонный характер. Наибольшее количество отравлений отмечается в конце лета — начале осени. Однако всё чаще в течение всего года встречаются отравления замороженными в домашних условиях грибами.
Отравление могут вызвать собственно ядовитые грибы (бледная поганка, мухоморы, ложные опята, ложные дождевики и др.), условно съедобные грибы в результате неумелой или неправильной кулинарной обработки и даже неправильно приготовленные съедобные гриба, а также съедобные грибы, получившие название «мутанты» (накопление в мицелии ядовитых веществ, в том числе вредных для человека продуктов разложения белков в старых плодовых телах, а также продуктов жизнедеятельности насекомых и червей).

Грибы являются трудно перевариваемым продуктом. Не рекомендуется есть грибы беременным и кормящим женщинам, они противопоказаны детям до 8 лет (независимо от способа и времени приготовления), а также лицам с заболеваниями ЖКТ (гастриты, холециститы, панкреатиты, гепатиты и др.) - приём грибов может спровоцировать обострение хронического заболевания.
Наиболее ранними симптомами отравления грибами являются тошнота, рвота, диарея. При появлении данных симптомов после употребления в пищу грибов немедленно обратитесь к врачу, особенно, если такие же нарушения отмечаются у всех членов семьи или всех тех, кто ел вместе с вами. Острые отравления грибами протекают намного тяжелее других пищевых отравлений. Если вы на даче, в деревне, а врач далеко, окажите себе первую помощь: промойте желудок чистой холодной водой (без марганцовки), примите активированный уголь в большом количестве (1г на кг массы тела), пейте как можно больше жидкости — это позволит предотвратить обезвоживание. Однако, все принятые вами меры ни в коем случае не отменяют визита к врачу.

Грибы могут быть источником очень тяжелого заболевания — ботулизма. Возбудители ботулизма в виде спороносных палочек содержатся главным образом в почве. Если перед консервированием грибы были плохо очищены и промыты, на их поверхности вместе с мельчайшими частицами земли могут оказаться и возбудители ботулизма. Домашняя термическая обработка их не убивает, а условия в герметически закупоренной банке, без доступа кислорода, благоприятны для развития в них микробного токсина — опаснейшего для человека яда. Чтобы избежать заболевания ботулизмом, надо очень тщательно очищать и промывать от земли, предназначенные для консервирования грибы, причем они должны быть свежими и доброкачественными. При обработке в домашних условиях грибы рекомендуется консервировать в банках с неплотно притертыми крышками.

Заболевание ботулизмом проявляется спустя 12-72 часа после приема грибов в пищу. Клинические проявления заболевания ботулизма: головная боль, сухость во рту, тошнота, рвота, понос, судороги, затруднение глотания и нарушение зрения (предметы двоятся, становятся расплывчатыми). При появлении хотя бы одного-двух указанных признаков следует срочно обратиться к врачу.
В Ошмянском районе последний случай отравления грибами зарегистрирован в 2014 году, ботулизм - в 2017 году.
Запомните самые важные правила:
- Не употребляйте в пищу как сырые, так и приготовленные дикорастущие грибы, в съедобности которых вы не уверены;
- Собирать только те грибы, которые вы хорошо знаете. Обязательно с ножкой;

- Не собирайте грибы вдоль автомобильных дорог, железнодорожных путей, в черте города;
- Не полагайтесь на иллюстрированные руководства при идентификации грибов и определении их съедобности;
- Не определяйте съедобность грибов по их названиям, поскольку они могут различаться в различных географических регионах;
- Не верьте распространённому мифу о съедобности грибов, если они не оставляют тёмных пятен на серебре или их едят птицы, насекомые, улитки, черви и т.п.;
- Не пробуйте сырые грибы на вкус;
- Не кормите грибами детей;
- Не покупайте грибы у случайных людей;
- Не рекомендуем употреблять в пищу грибы людям с заболеваниями органов пищеварения;
- Избегайте употребления грибов, которые ранее вызывали заболевания у вас, ваших родственников или животных;
- Помните, что ядовитые грибы нередко растут рядом со съедобными и могут быть очень похожи на них;
- Помните, что даже съедобные грибы при неправильном приготовлении и хранении могут стать несъедобными и токсичными;
- Помните, что употребление в пищу грибов совместно с алкоголем, а также их приготовление с добавлением алкоголя может активировать ряд токсинов и приводить к возникновению отсроченного токсического синдрома;
- Помните, что даже съедобные правильно приготовленные грибы должны употребляться у пищу в умеренных количествах в качестве гарнира, а не основного блюда;
- Нельзя хранить свежие грибы более суток, даже в холодильнике, а солёные и маринованные грибы более года.
- Не занимайтесь самолечением - обратитесь за медицинской помощью.
Материал подготовил врач-гигиенист Ошмянского районного ЦГЭ Матовия Мария Васильевна
31.08.2021
В целях обеспечения санитарно-эпидемиологического благополучия населения и недопущения к реализации пищевой продукции, представляющей потенциальную опасность для здоровья людей информируем:
Питьевая вода природная негазированная «Боровая»,у 18,9 л

Дата розлива 26.07.2021, срок годности и условия хранения после вскрытия потребительской упаковки -5 суток при температуре от 2°С до 20°С.
- Изготовитель Государственное предприятие «Беларусьторг», Республика Беларусь, г. Минск, пер. Велосипедный 6/3 -2, каб. 300.
- Не соответствуют требованиям Единых санитарно эпидемиологических и гигиенических требований к товарам, подлежащим санитарно эпидемиологическому надзору, утв. Решением Комиссии Таможенного союза от 28.08.2010 №299, Санитарных норм и правил" «Требования к питьевой воде, расфасованной в емкости», утв. Постановлением №123 МЗ РБ 15.12.2015 по микробиологическому показателю: «плесени».
Вода питьевая негазированная «Графская лайт», 18,9 л

- Дата розлива 26.07.2021, 28.07.2021, срок годности 365 суток
- Изготовитель Унитарное предприятие «ОРВИГО», Республика Беларусь, Минская область,г. Дзержинск, ул. Лермонтова, 10а.
- Не соответствуют требованиям Единых санитарно эпидемиологических и гигиенических требований к товарам, подлежащим санитарно эпидемиологическому надзору, утв. Решением Комиссии Таможенного союза от 28.08.2010 №299, Санитарных норм и правил" «Требования к питьевой воде, расфасованной в емкости», утв. Постановлением №123 МЗ РБ 15.12.2015 по микробиологическому показателю: «плесени».
Приправа вкусовая куриная сухая «Мивина».

- Дата изготовления 03.05.2021, срок годности 12 месяцев.
- Изготовитель: : ООО «Техноком», Украина, г. Харьков, пр. Героев Сталинграда, д. 45. адрес производства: Украина, г. Харьков пр-т Гагарина, д.217,Импортеры в Республику Беларусь: ООО «Нестле Бел», г. Минск,ул. Домбровская, 9, офис 3.1.1, ИООО «АЛИДИ-Вест», г.Минск,ул. Домбровская, 9, офис 7.3.1,поставщик: ИООО«АЛИДИ-Вест»,г.Минск,ул. Домбровская, 9, офис 7.3.1.
- Не соответствует требованиям ГН, утв. постановлением Министерства здравоохранения Республики Беларусь 21.06.2013 N° 52, TP ТС 021/2011, утв. Решением Комиссии Таможенного союза от 09.12.2011 № 880, по микробиологическим показателям в 0,1 обнаружены БГКП (колиформы)
«Чай черный байховый с ароматом лимона в пакетиках для разовой заварки торговой марки «Царская чаша»

- Дата изготовления 22.06.2021, срок годности 24 месяца.
-
Изготовитель: изготовитель ООО «Санти» (РФ, г. Москва, ул. Березина, д.36, стр. 2), поставщик в Республике Беларусь ООО «Евроторг» (г. Минск, ул. Казинца, 52а-22)
- Не соответствует требованиям санитарно-эпидемиологического законодательства.
Орех грецкий очищенный 1 сорт

- Дата изготовления 06.04.2021, дата упаковывания 13.05.2021, срок годности 12 месяцев с даты изготовления.
- Изготовитель: ООО «ЭГОЗИМ» (Украина, Киевская область, Вышгородский район, г.Вышгород, ул. Ватутина, д. 69Г, офис 1/33), импортер в Республику Беларусь ООО «Андивал Групп» (Минская область, г. Молодечно, ул. Либаво-Роменская, д.54, каб.24-25)
- Не соответствует требованиям санитарно-эпидемиологического законодательства
Арахис очищенный целый

- Дата изготовления: 20.11.2020, дата упаковки 15.04.2021, годен до 20.11.202].
- Изготовитель: JALARAM AGRIEXPORTS PVL.LTD; адрес изготовителя: ANAND BAZAR, B/H. BUS STATION, DIST. GIR SOMNATH, UNA-362560 CUJARAT, Индия. Импортер в Республику Беларусь: ОАО «Брестская областная база Бакалея», г. Брест, ул. Янки Купалы, 100
- Не соответствует требованиям ГН «Показатели безопасности и, безвредности для человека продовольственного сырья и пищевых продуктов» утвержденного постановлением Министерства здравоохранения Республики Беларусь от 12.06.2013 № 52, TPYC 021/2011 «О безопасности пищевой продукции», принятого Решением Комиссии Таможенного союза от 09 декабря 2011 № 880, по микробиологическим показателям: обнаружены плесени, в количестве 2,0 хЮ" КОЕ/г при нормируемом значении не более 1x10'.
Мюсли «Фруктовые микс»

- Изготовлено: 21.05.2021, годен до 19.08.2021
- Изготовитель: ООО «ПТК ЛИКА», Российская Федерация, Самарская область, г. Отрадный, ул. Спортивная, д. 7, офис 1.Импортеры в Республику Беларусь: ООО«ЛенПродуктСервис» г. Минск, ул.Казинца, д. 11 А, офис А506; ООО «МосПродуктСервис»,
- Не соответствуют требованиям ГН, утв. Постановлением Министерства здравоохранения Республики Беларусь 21.06.2013 №52, ГН, утв. Постановлением Совета Министров Республики Беларусь от 25.01.2021 №37, TP ТС 021/2011, утв. Решением Комиссии Таможенного союза от 09.12.2011 №880 по микробиологическому показателю: «плесени»
Дыня «Торпеда» свежая

- Урожай 2021 года, дата упаковывания 03.07.2021, срок годности с даты упаковки 90 суток.
- Изготовитель/импортер КХ «КАМАЛ-КАРАХАН» (Республика Казахстан, Туркестанская область, Жетысайский район, со Жанауыл).
- Не соответствует требованиям TP ТС 021/2011, утв. Решением Комиссии Таможенного союза от 09.12.2011 №880, ГН, утв. постановлением Совета Министров Республики Беларусь от 25.01.2021 № 37, по содержанию нитратов.
Свекла столовая свежая

- Дата изготовления и упаковывания упаковывания 30.06.2021, срок годности с даты упаковывания 4 месяца.
- Изготовитель: ООО«КАЛИПСО ВВП»,Украина, 14017,г. Чернигов, ул. Ивана Мазепы, д. 48, офис 3. Импортер в Республике Беларусь: ОДО «Виталюр», Республика Беларусь, 223010, Минский район, 9-й километр Московского шоссе, Административно-Бытовой Комплекс (АБК), комната 1
- Не соответствует требованиям TP ТС 021/2011, утв. Решением Комиссии Таможенного союза от 09.12.2011 №880, ГН, утв. постановлением Совета Министров Республики Беларусь от 25.01.2021 № 37, по содержанию нитратов.
Мини круассаны 7 Days с двоной начинкой «Вишня» и с кремом со вкусом «Ваниль».

- Дата изготовления 25.04.2021 срок годности 22.09.2021.
- Изготовитель: ООО «Чипита Санкт-Петербург», РФ, Санкт-Петербург, г.Красное, ул.Свободы, д.50, ЛИТЕР Д. Импортер в РБ: : ООО «Чипита Лефко», г.Минск, ул. Тимирязева, 72, пом. 49, офис 1204.
- Не соответствуют требованиям ГН, утв. Постановлением Министерства здравоохранения Республики Беларусь 21.06.2013 №52, ГН, утв. Постановлением Совета Министров Республики Беларусь от 25.01.2021 №37, TP ТС 021/2011, утв. Решением Комиссии Таможенного союза от 09.12.2011 №880 по микробиологическому показателю: «плесени»
Информацию подготовила помощник врача-гигиениста Ошмянского районного ЦГЭ Михайлова Анна Сергеевна
27.08.2021
В целях обеспечения санитарно-эпидемиологического благополучия населения и недопущения к реализации товаров личной гигиены, представляющей потенциальную опасность для здоровья людей информируем:
Салфетки бумажные ТМ "Luxy", номинальное количество - 20 штук, ЗЗсмхЗЗсм, 3-слойные

-
Изготовлены 05.06.2021, срок годности не ограничен.
-
Производитель: ООО «КТА», 08306, Украина, Киевская обл., г.Борисполь, ул.Сергея Оврашка, 1. Импортер в РБ: ООО «Парфюмбытхим», 223021, Менковский тракт, 14. Комната 103, Щомыслицкий с/с, район деревни "Озерцо, Минский
-
Не соответствуют Единым санитарно- эпидемиологическим и гигиеническим требованиям к продукции (товарам), подлежащей санитарно- эпидемиологическому надзору (контролю), утвержденных решением Комиссии Таможенного союза от 28.05.2010 № 299, глава II, раздел 12, по органолептическим показателям: окрашивание вытяжки в светло-желтый цвет.
Пом.врача-гигиениста А.С.Михайлова
25.08.2021
В целях обеспечения санитарно-эпидемиологического благополучия населения и недопущения к реализации товаров контактирующих с пищевой продукцией, представляющей потенциальную опасность для здоровья людей информируем:
Набор вилок «Люмьер», 6штук, (apT.DX-415),штриховой код:2000000007533, материал: нержавеющая-сталь

-
Дата производства: ноябрь 2020, срок годности не ограничен.
-
Изготовитель: MARKET UNION CO., LTD. Address: No.113 Qiu Shi Road Bei Yuan YiWu 322000, Китай. Импортер: ООО «КИТтрейд и поставки», юридический адрес: 220020, г. Минск, ул. Тимирязева, 97, каб. 1.
-
Не соответствует требованиям Единых санитарно-эпидемиологических и гигиенических требований, утв. решением Комиссии Таможенного союза от 28.05.2010 № 299 (глава II, раздел 16), Санитарных норм и правил и ГН, утв. Министерством здравоохранения Республики Беларусь от 30.12.2014 № 119; ГН, утв. Постановлением Совета Министров Республики Беларусь от 25.01.2021 № 37: миграция железа в 5% раствор поваренной соли составила 1,14±0,14 мг/дм^ (ДКМ - не более 3 мг/дм'') (протокол испытаний Мозырского зонального ЦГЭ от 09.08.2021.
Нож кухонный с зубцами, 11,5 см,
пластиковая ручка, микс цветов, артикул XJN -29

- Дата производства: август 2020, срок годности не ограничен.
-
MARKET UNION CO., LTD, Address No. 113 Qiu Shi Road BeiYuan YiWu, 322000, Китай .Импортер в Республику Беларусь: ООО «КИТТРЕЙД и ПОСТАВКИ», KIT-TRADE. BY, г. Минск, ул. Тимирязева, 97, каб. 1
-
Не соответствует требованиям Единых санитарно-эпидемиологических и гигиенических требований, утв. решением Комиссии Таможенного союза от 28.05.2010 № 299 (глава II, раздел 16), ГН, утв. Министерством здравоохранения Республики Беларусь от 30.12.2014 № 119; ГН, утв. Постановлением Совета Министров Республики Беларусь от 25.01.2021 № 37; миграция железа в 5% раствор поваренной соли составила 0,76±0,09 мг/дм (ДКМ - не более 300 мг/дм3) (протокол испытаний образцов непродовольственной продукции Мозырского зонального ЦГЭ от 12.08.2021.
Пом.врача-гигиениста А.С.Михайлова
25.08.2021
В целях обеспечения санитарно-эпидемиологического благополучия населения и недопущения к реализации пищевой продукции, представляющей потенциальную опасность для здоровья людей информируем:
Я года протертая с сахаром Черника с маркировкой «СТОЕВЪ», в стеклянной банке, масса нетто 280г

- Дата изготовления 15.12.2020, срок годности с даты изгетовяения 2 года и дата изготовления 01.12.2020, срок годности с даты изготовления 2 года .
-
Изготовитель ООО «Стоев-Кубанский продукт», Российская Федерация, Краснодарский край. Импортер в Республику Беларусь ОДО «Орбиус», г. Мииск).
-
Не соответствуют TP ТС 021/2011, TP ТС 022/2011, TP ТС 029/2012 по безопасности и маркировке: при производстве продукции использовалась незаявленная в маркировке пищевая добавка консервант бензойная кислота.
Ягода протертая с сахаром Фейхоа с маркировкой «СТОЕВЪ», в стеклянной банке, масса нетто 280г.

- Дата изготовления 21.04.2021, срок годности с даты изгетовяения 2 года.
-
Изготовитель ООО «Стоев-Кубанский продукт», Российская Федерация, Краснодарский край. Импортер в Республику Беларусь ОДО «Орбиус», г. Мииск).
-
Не соответствуют TP ТС 021/2011, TP ТС 022/2011, TP ТС 029/2012 по безопасности и маркировке: при производстве продукции использовалась незаявленная в маркировке пищевая добавка консервант бензойная кислота.
Томатная паста нестерилизованная с массовой долей растворимых сухих веществ 28% с маркировкой «ТОМАТНАЯ ПАСТА ИРАНСКАЯ»

-
Дата изготовления 15.04.2021, срок годности 15.04.2022.
-
Изготовитель «Стоев-Кубанский продукт», Российская Федерация, Краснодарский край, г. Приморско-Ахтарск (импортер в Республику Беларусь ОДО «Орбиус». г. Минск)
-
Не соответствуют TP ТС 021/201 1, TP ТС 022/201 , TP ТС 029/2012 по безопасности: в результате проведенных испытаний фактическое содержание консервантов (сорбиновой кислоты в комбинации с бензойной кислотой ) составило 2,44 г/кг, при допустимом уровне - не более 1,0 г/кг
Сок свекольный BIO прямого отжима пастеризованный торговой марки «Pfaner»

-
Дата изготовления 18.02.2020, годен до 18.08.2021.
-
Изготовитель «Стоев-Кубанский продукт», Российская Федерация, Краснодарский край, г. Приморско-Ахтарск (импортер в Республику Беларусь ОДО «Орбиус». г. Минск)
- Не соответствуют TP ТС 021/2011 по безопасности -превышению допустимого уровня содержания нитратов: при допустимом уровне не более 700 мг/кг, фактическое значение показателя составило 1428 мг/кг
Имбирь маринованный розовый пастеризованный с маркировкой «HOShi» в упаковке из полимерных материалов, масса нетто 290 г
-
Дата изготовления 16.01.2021, срок годности 18 месяцев.
-
Изготовитель ООО «LAIWU TAIFENG FOODS CO., LTD», Китай {импортер в Республику Беларусь ООО «ИмЭксТрейд», г. Минск)
- Не соответствуют TP ТС 021/2011, TP ТС 029/2012 по безопасности: при производстве применялась заявленная изготовителем в маркировке пищевая добавка краситель AC (Е129) красный очаровательный, недопустимая для использования при производстве данной продукции.
Сырная соломка, массовая доля жира в пересчете на сухое вещество 45%, полимерная упаковка, масса нетто 500 г.

-
Дата изготовления 28.06.2021, срок годности 6 месяцев.
-
Изготовитель ООО «ПК Золотой парус», Россия, г. Москва (поставщик в Республику Беларусь ООО «БИРШТАТ ТРЕИД», Витебский район)
-
Не соответствуют TP ТС 021/2011, TP ТС 022/2011, TP ТС 029/2012, TP ТС -033/2013 по безопасности и маркировке и является опасной продукцией, так как изготовитель умышленно придал внешний вид и отдельные свойства молочного продукта (сыра), но при этом она не может быть идентифицирована как та, за которую выдается.
Грецкий орех очищенный торговой марки «Эконом» с маркировкой «Shalu», упакованный в полипропиленовый пакет массой нетто 70 г

- Дата изготовления 06.04.2021, дата упаковывания 13.05.2021, срок годности 12 месяцев с даты изготовления. 01.12.2020, дата упаковывания 12.01.2021, годен до 01.12.2021
- Изготовитель: ООО «ЭГОЗИМ» (Украина, Киевская область, Вышгородский район, г.Вышгород, ул. Ватутина, д. 69Г, офис 1/33),Импортер в РБ: ФХ «SIROJIDDIN AGRO FRUITS», Республика Узбекистан, Самаркандская область, Ургутский район, село Кара булок; импортер и упаковщик в Республике Беларусь: Частное производственно-торговое унитарное предприятие «Шалу» (Республика Беларусь, 223021, Минский район, Щомыслицкий с/с, аг. Озерцо, ул. Центральная, 35А, пом. 25
- Не соответствует санитарно-эпидемиологическим и гигиеническим требованиям по микробиологическому показателю.
Дыня «Торпеда» свежая

- Урожай 2021 года, дата упаковывания 15.07.2021, срок годности с даты упаковки 30 суток.
- Изготовитель: общество с ограниченной ответственностью «Федерация футбола Сарыагашского района», Южно-Казахстанская область, г. Сарыагаш, ул. Майлыкожа, Республика Казахстан (импортер в Республику Беларусь: ООО «Фрутреал», г. Полоцк, ул. Октябрьская, 25/1-6, комн. 17).
- Не соответствует санитарно-эпидемиологическим и гигиеническим требованиям по содержанию «нитратов»
Дыня свежая

- Урожай 2021 года, дата упаковывания 14.07.2021, срок годности с даты упаковки 30 суток.
- Изготовитель: ИП Ибрагимова Р.Н., Республика Казахстан, г. Шымкент, проспект Тауке-Хана, д. 10, кВ. 11; поставщик в Республику Беларусь ООО «Санта Ритейл», Республика Беларусь, г. Брест, ул. Советской Конституции, 26/1)
- Не соответствует санитарно-эпидемиологическим и гигиеническим требованиям по содержанию «нитратов»
Информацию подготовила помощник врача-гигиениста Ошмянского районного ЦГЭ Михайлова Анна Сергеевна
25.08.20121
В целях обеспечения санитарно-эпидемиологического благополучия населения и недопущения к реализации пищевой продукции, представляющей потенциальную опасность для здоровья людей информируем:
Жевательная резинка «БОМБЁР» (BOMBER) со вкусами клубники, тутти-фрутти, апельсина, колы, арбуза

- Дата изготовления 06.05.2021, годен до 06.05.2023.
-
изготовитель ООО «СААДЕТ УКРАИНА» (Украина, г. Черновцы, ул. Коломыйская, 1-ж), импортер в Республику Беларусь ООО «Вельми Смачна» (г. Минск, Логойский тракт, 37, пом. 7, офис 19)
-
не соответствуют требованиям санитарно-эпидемиологического законодательства
Пирожные бисквитные «КотоМишки»

- Дата упаковывания 27.05.2021, срок годности 8 месяцев с даты изготовления
- Изготовитель: изготовитель ООО «КФ «Виктория» (РФ, Краснодарский край, Белореченский район, г. Белореченск, ул. Победы, 102), импортер в Республику Беларусь ООО «Алиара-Трейд» (г. Минск, ул. Уборевича, 95а, каб. 13)
- Не соответствует требованиям санитарно-эпидемиологического законодательства
Виноград сушенный коричневый 2 сорт

-
Дата изготовления 02.2021, годен до 02.2022.
-
Изготовитель: изготовитель ООО «BULUNG UR GOLD FRU1TS» (Узбекистан, Самаркандская область, Булунгурский район, село Ку%font-family: Times New Roman, serif;">Изготовитель: изготовитель ООО «BULUNG UR GOLD FRU1TS» (Узбекистан, Самаркандская область, Булунгурский район, село Кулбачий, ул. КунгирвFspan>
- Не соответствует требованиям санитарно-эпидемиологического законодательства
Финик сушеный с косточкой SAYER DATES

- Дата изготовления 01.04.2021, дата упаковывания 14.05.2021, годен до 01.04.2023
-
Изготовитель: «KOUROSH DRIED FRUITS AND LEGUMES INDUSTRY» (Иран, №16, 20th St.Valiasr St, Tehran Iran), импортер и упаковщик ЧП «Шалу» (Минская область, Минский район, Щомыслицкий с/с, аг. Озерцо, ул. Центральная, д. 35А, пом. 25).
- Не соответствует требованиям санитарно-эпидемиологического законодательства
Изделия макаронные быстрого приготовления «Вермишель с куриным вкусом» торговой марки «Петра»

- Дата изготовления 04.06.2021, срок годности 12 месяцев
- Изготовитель: ООО «МаревенФудСэнтрал (РФ, Московская область, г. Серпухов, д. Ивановское), импортер в Республику Беларусь ООО «Тибетрэй» (г. Минск, ул. Уручская, ПА, комн. 43)
- Не соответствует требованиям санитарно-эпидемиологического законодательства
«Чай черный байховый с ароматом лимона в пакетиках для разовой заварки торговой марки «Царская чаша»

- Дата изготовления 04.05.2021, срок годности 24 месяца.
-
Изготовитель: изготовитель ООО «Санти» (РФ, г. Москва, ул. Березина, д.36, стр. 2), поставщик в Республике Беларусь ООО «Евроторг» (г. Минск, ул. Казинца, 52а-22)
- Не соответствует требованиям санитарно-эпидемиологического законодательства.
«Сельдь атлантическая кусочки пряного посола» DEL MARE

- Дата 07.06.2021, срок годности 90 суток
- Изготовитель: СП «ЛеорПластик» (Гродненская область, г. Новогрудок, ул. Свердлова, 38а).
- Не соответствует требованиям санитарно-эпидемиологического законодательства
Орех грецкий очищенный 1 сорт

- Дата изготовления 06.04.2021, дата упаковывания 13.05.2021, срок годности 12 месяцев с даты изготовления.
- Изготовитель: ООО «ЭГОЗИМ» (Украина, Киевская область, Вышгородский район, г.Вышгород, ул. Ватутина, д. 69Г, офис 1/33), импортер в Республику Беларусь ООО «Андивал Групп» (Минская область, г. Молодечно, ул. Либаво-Роменская, д.54, каб.24-25)
- Не соответствует требованиям санитарно-эпидемиологического законодательства
Изделия кондитерские мучные печенье «Дамские пальчики» с повидлом

-
Дата изготовления и упаковывания 26.04.2021, срок годности не более 90 суток
-
Изготовитель: ООО «Сладовик ПК» (РФ, Пензенская область, г. Пенза, ул. Баумана, 30), сделано по заказу ООО ПО «АЛЕША ПОПОВИЧ» (Московская область, г. Мытищи, ул. Колпакова, д.2, кор. 1, пом. 174), поставщик в Республику Беларусь ООО «РольфТрэйд» (г. Могилев, ул. Мовчанского, д 53, оф.1).
- Не соответствует требованиям санитарно-эпидемиологического законодательства.
Халва подсолнечная ванильная

- Дата изготовления: 25.04.2021, срок годности 25.10.2021.
- Изготовитель: ООО «Три стар» (Украина Кировоградская область, Кировоградский район, с. Черняховка, ул. Полевая, 5), импортеры в Республику Беларусь УП «Здоровый продукт» (Минская область, Минский район, военный городок №137а «Семков городок», здание бывшего штаба, к. 1), ООО «Витрум плюс» (Минская область Червенский район, Свиловичский с/с, аг. Заполье, ул. Садовая, 30, каб.17) .
- Не соответствует требованиям санитарно-эпидемиологического законодательства.
фарш «Семейный» замороженный, торговой марки «Мяскин и Колбаскин»

- Изготовлено: 21.05.2021, годен до 19.08.2021
- Изготовитель: ООО «Производственная Торговая Компания Мяскин и Колбаскин» (Республика Беларусь, Минская область, Минский район, аг. Большевик, ул. Промышленная, 1/7, склад №4, ком. 2).
- Не соответствует требованиям санитарно-эпидемиологического законодательства.
Сельдь атлантическая натуральная с добавлением масла (куски)

- Дата изготовления 17.10.2020, срок годности 24 месяца.
- Изготовитель: изготовитель ООО «Русский рыбный мир» (РФ, г. Москва ул. Центральная, 15/3, поселение Щаповское, поселок Курилово), импортер в Республику Беларусь ООО «Западный Бриг»
- Не соответствует требованиям санитарно-эпидемиологического законодательства.
Дыня «Торпеда» свежая

- Урожай 2021 года, дата упаковывания 03.07.2021, срок годности с даты упаковки 90 суток.
- Изготовитель/импортер КХ «КАМАЛ-КАРАХАН» (Республика Казахстан, Туркестанская область, Жетысайский район, со Жанауыл).
- Не соответствует требованиям санитарно-эпидемиологического законодательств
Рулет бисквитный «KOVIS» с кремом «Варёная сгущёнка»

- Дата изготовления 26.05.2021, срок годности до 26.11.2021.
- Изготовитель ООО «Раменский кондитерский комбинат Самара» (РФ, Самарская область, Кинель-Черкасский район, с. Тимашево, ул. Двор Завода, д.1), импортер в Республику Беларусь ОДО «МОСТРА-ГРУПП» (г. Минск, ул. В. Хоружей, 29-101).
- Не соответствует требованиям санитарно-эпидемиологического законодательства
Полуфабрикат быстрого приготовления «Палочки куриные» быстрого приготовления замороженные.

- Дата изготовления: 16.06.2021, срок годности: 180 суток.
- Изготовитель: ООО «ПровитБел», (Республика Беларусь, Гродненская область, г. Новогрудок, ул. Мицкевича, 57А).
- Не соответствует требованиям ГН утвержденным постановлением Министерства здравоохранения Республики Беларусь 21.06.2013 №52, TP ТС 021/2011микробиологическим показателям -обнаружена Listeria
Сырок творожный глазированный в белом шоколаде с ванилью.

- Дата изготовления 01.07.2021, срок годности 31.07.2021.
- Изготовитель: ООО «РостАгроКомплекс», 141255, Россия, Московская область. Пушкинский район, шоссе Братовщина-Ельдигино, 6 км.
- Не соответствует требованиям санитарных норм и правил», по микробиологическому показателю: обнаружены дрожжи.
Информацию подготовила помощник врача-гигиениста Ошмянского районного ЦГЭ Михайлова Анна Сергеевна
30.07.2021
На сегодняшний день подавляющее большинство заболеваний щитовидной железы излечимо, а в части случаев предотвратимо. Последнее касается заболеваний, связанных с дефицитом йода в питании. Йодный дефицит, вопреки популярным представлениям, приводит не только к увеличению размера щитовидной железы, но. воздействуя, например, па организм, беременной женщины, может привести к необратимым изменениям со стороны нервной системы плода, крайним проявлением которых является кретинизм, сопровождающихся тяжелой умственной отсталостью.
Эндемический зоб — это заболевание щитовидной железы, проявляющееся увеличением ее объема и встречающееся в географических районах с недостаточным содержанием йода, в пище, воде, воздухе. На всей территории Республики Беларусь регистрируется йодный дефицит той или иной степени выраженности. В связи с этим особо важное значение для профилактики заболеваний щитовидной железы имеет использование в пищу йодированной соли. Суточная потребность человека, в йоде составляет180—220мкг. Благодаря Государственной программе йодный дефицит ликвидирован в Республике Беларусь, но при прекращении или сокращении использования йодированной соли йодный дефицит возникает вновь, поскольку естественное содержание йода в почве, воде и продуктах питания незначительное, территория по-прежнему остается эндемичной по дефициту йода.
С целью профилактики заболеваний, вызванных дефицитом йода, ВОЗ рекомендовало проводить обогащение пищевой соли йодом. Потребность организма в йоде может быть удовлетворена за счет поступления его в составе йодированной соли. В торговой сети йодированной соли должно быть не менее 75%.
Информацию подготовила помощник врача-гигиениста Ошмянского районного ЦГЭ Семенова Антонина Викторовна
20.07.2021
Государственное учреждение «Ошмянский районный центр гигиены и эпидемиологии» информирует, что Главным государственным инспектором Республики Беларусь по надзору за соблюдением технических регламентов разрешен ввоз и обращение с 10 июня 2021 года на территории Республики Беларусь следующей продукции:
драже МАОМАМ Конфеты - драже, конфеты жевательные «МАО МИКС» торгового знака «МАОМАМ», изготовитель: Edmund Minister GmbH&Co. KG, Германия; шамеллоус Шпек HARIBO Суфле-Маршмелоу, шамеллоус Барбекю HARIBO Суфле-Маршмелоу, шамеллоус Цветные трубочки HARIBO Суфле-Маршмелоу, мини суфле-Маршмелоу HARIBO Суфле-Маршмелоу, изготовитель: HARIBO Belgique bvba, Бельгия; жевательный мармелад Арбуз HARIBO, изготовитель: PAMIR GIDA SAN.A.S., Турция, запрещенных предписаниями Главного государственного инспектора Республики Беларусь по надзору за соблюдением технических регламентов от 09.02.2021 № 06-18-1/116, от 26.02.2021 № 06-18-1/235, от 20.04.2021 № 06-18-13/514, от 17.05.2021 № 06-18-123/603, № 06-18-1/605 (разрешение от 10.06.2021 № 06-18-4/763);
конфеты «Аккондовская КАРТОШКА», десерт «Фараделла», конфеты «Ледди Ночь» с кокосом, десерт «Ломтишка» глазированный, конфеты «Отломи», изготовитель: АО «Акконд», Россия, запрещенные предписанием Главного государственного инспектора Республики Беларусь по надзору за соблюдением технических регламентов от 09.02.2021 № 06-18-1/116, от 24.02.2021 № 06-18-1/177, от 25.11.2020 № 06-18-1/1911, (разрешение от 10.06.2021 №06-18-4/764);
мармелад резанный «Добрые дольки» микс, мармелад желейный формовой «Мармеладный букет», печенье сдобное песочное «Диана»; изготовитель: ООО «Сладкий рай», Россия, запрещенные предписанием Главного государственного инспектора Республики Беларусь по надзору за соблюдением технических регламентов от 23.10.2020 № 06-18-1/1775, от 01.12.2020 № 06-18-1/1986 (разрешение от 10.06.2021 № 06-18-4/766).
Информацию подготовила помощник врача-гигиениста Ошмянского районного ЦГЭ Семенова Антонина Викторовна
30.06.2021
В целях защиты потребительского рынка от небезопасной и некачественной продукции, санитарно-эпидемиологической службой республики проводятся мероприятия технического (технологического, поверочного) характера по отбору проб и образцов пищевой продукции, находящейся в реализации.
По результатам лабораторных испытаний выявлена продукция, несоответствующая санитарно-эпидемиологическим требованиям:
Вино виноградное натуральное розовое полусладкое «РОЗЕ БЛАЗОН»

- дата розлива 28.09.2020, срок годности 24 месяца с даты розлива, объем 750 мл, спирт 11, 5%, сахар 18,1-45 г/л, штриховой код 840045004627;
- изготовитель: SA «VINURI DE COMRAT», Республика Молдова, MD-3805, г. Комрат, ул. Винзаводская, 1;
- не соответствует требованиям ТР ТС 022/2011 «Пищевая продукция в части ее маркировки» по санитарно-химическим показателям: отсутствует информация на маркировочном ярлыке о содержании сорбиновой кислоты (обнаружена сорбиновая кислота в количестве 131,6 мг/кг).
Арбуз свежий

- урожай 2021 года, № партии - 41330, дата упаковывания -26.05.2021, срок годности - 30 суток;
- изготовитель: Inter imeks tarim urunleri ithalat ihracat sanayi ve ticaret LTD.STL, Турция; экспортер: Inter imeks tarim urunleri ithalat ihracat sanayi ve ticaret LTD.STL, Cakmak CAD., Gazioglu ishani B-Blok K-4 NO-8;
- не соответствует Гигиеническому нормативу «Показатели безопасности и безвредности для человека продовольственного сырья и пищевых продуктов», утвержденному постановлением Министерства здравоохранения Республики Беларусь от 21.06.2013 №52; TP ТС 021/2011 «О безопасности пищевой продукции», утвержденному Решением Комиссии Таможенного союза от 09.12.2011 № 880 по показателю безопасности «нитраты»: фактическое значение 123 мг/кг, при нормируемом не более 60 мг/кг.
Информацию подготовила помощник врача-гигиениста Ошмянского районного ЦГЭ Семенова Антонина Викторовна
23.06.2021
В целях обеспечения санитарно-эпидемиологического благополучия населения и недопущения к реализации пищевой продукции, представляющей потенциальную опасность для здоровья людей информируем:
Пюре картофельное (сухое) с куриным вкусом «Ролтон».

- Дата изготовления 25.01.2021, срок годности 12 месяцев.
- Изготовитель: ООО «Маревен Фуд Сэнтрал», Российская Федерация, Московская область, г. Серпухов, д. Ивановское, территория Маревен Фуд Сэнтрал» (импортеры в Республику БеларусьООО: «Евроторг», г Минск, ул. Казинца, 52А-22; ООО «Тибетрэй», г. Минск, ул. Уручская, д. 11 а, комн.43; ООО «Альфа-Дистрибьюция», г. Минск, ул. Матусевича, д. 20, пом.12/1; ООО «БерталСервис», г. Минск, ул. Сурганова, д.43, пом. 40-1) - письмо ООО «Ероторг» от 13.05.2021 № 24/6423; .
- Не соответствует требованиям санитарно-эпидемиологического законодательства по микробиологическим показателям.
Чай черный байховый цейлонский «Принцесса Канди Медиум»

- Дата изготовления 08.2020, годен до 07.2023;
- Изготовитель: ООО «Орими», Российская Федерация, Ленинградская область, Всеволожский район, пос.им. Свердлова, 1 мкр., уч-к 15/4 (поставщики в Республику Беларусь: ООО «Тибетрэй», г. Минск, ул., Уручская, д.Па, оф.43; ООО «Альфа-Дистрибьюция», г. Минск, ул. Матусевича, д.20, пом.12/1; УП КМА ПРОД-ТРЕЙД, г. Витебск, пер.4-й, Великолукский 18-1; ООО «Евроторг», г Минск, ул. Казинца, 52А-22);
- Не соответствует требованиям санитарно-эпидемиологического законодательства по микробиологическим показателям.
Сушено - вяленая пищевая рыбная продукция «Вобла сушено-вяленая» (неразделанная)

- дата изготовления 02.03.2021, срок годности 6 месяцев;
- Изготовитель: ООО «Улан» Российская Федерация, Астраханская область, г. Астрахань, ул. Дзержинского, 36, литер 3. Поставщик в Республику Беларусь: ООО «Евроторг», г. Минск, ул. Казинца 52А-22.
- Не соответствует требованиям санитарно-эпидемиологического законодательства по микробиологическим показателям.
Информацию подготовила помощник врача-гигиениста Ошмянского районного ЦГЭ Михайлова Анна Сергеевна
28.05.2021
С приходом весны на улицах города, появляются пенсионерки с пучками зелени, женщины, продающие халаты и носки, торговцы, игрушками, селедкой, сгущенным молоком, мясом, салом… Разнообразию ассортимента позавидует любой рынок.

Санитарно-эпидемиологическая служба предупреждает об опасности приобретения продуктов питания в местах неустановленной торговли.
У продавцов, предлагающих продукцию «с рук» отсутствуют:
- необходимая информация о происхождении товара, сроках его реализации, производителе, документы, подтверждающие качество и безопасность;
- условия для соблюдения температурных условий хранения продукции;
- условия, препятствующие загрязнению продукции; условия соблюдения правил личной гигиены;
- санитарная одежда; медицинская справка о состоянии здоровья, подтверждающая отсутствие инфекционных заболеваний.
Употребление в пищу продуктов, приобретенных в местах несанкционированной торговли, может стать причиной возникновения пищевых отравлений (в том числе ботулизма), острых кишечных инфекций.
Помните, что качество и безопасность продукции, реализуемой в торговых объектах, на рынках и в иных установленных местах, обеспечивается ответственными должностными лицами субъектов торговли, изготовителями и поставщиками товаров.
Уважаемые жители города!
Призываем Вас проявить осторожность, бдительность и не приобретать пищевые продукты в местах неустановленной торговли. Не рискуйте своим здоровьем и близких Вам людей. Неприятие обществом такой торговли будет лучшим результатом борьбы с ней.
Информацию подготовила помощник врача-гигиениста Ошмянского районного ЦГЭ Антонина Викторовна Семёнова
26.05.2021
В ходе проведения надзорных мероприятий на объектах торговли, общественного питания и бытового обслуживания специалисты центра гигиены и эпидемиологии продолжают выявлять нарушения санитарно-эпидемиологического законодательства.
Так, за истекший период 2021 года мониторингом охвачено 87 объектов различной формы собственности. Нарушения установлены на 63 объектах, что составило 72,4%.
Основными нарушениями явились:
- Не содержание в чистоте оборудования;
- отсутствие сигнальной разметки для соблюдения социальной дистанции;
- не проведение ежедневно влажной уборки помещений с применением моющих средств и средств дезинфекции;
- не содержание в чистоте помещений;
- не проведение обработки контактных поверхностей;
- отсутствие бесконтактных дозаторов с антисептиками для обработки рук;

- не проведение контроля за состоянием здоровья работников;
- неиспользование персоналом торговых объектов средств индивидуальной защиты (масок);
- отсутствие запаса дезинфицирующих средств, антисептиков;
- отсутствие на объектах антисептика в дозаторах для обработки рук;
- реализация по типу самообслуживания хлебобулочных и кондитерских изделий, неупакованных в потребительскую тару и другие
В связи с неустойчивой эпидемиологической ситуацией по инфекции COVID-19 специалисты органов государственного санитарного надзора еще раз напоминают о необходимости всеми субъектами хозяйствования принятия исчерпывающих мер по предупреждению распространения вирусных инфекций, в том числе коронавирусной инфекции путем соблюдения всех рекомендаций Министерства здравоохранения.
Информацию подготовила помощник врача-гигиениста Ошмянского районного ЦГЭ Семенова Антонина Викторовна
18.05.2021
В целях обеспечения санитарно-эпидемиологического благополучия населения и недопущения к реализации пищевой продукции, представляющей потенциальную опасность для здоровья людей информируем:
Жевательная резинка «Вкусный градусник»

- Дата изготовления 20.09.2020, срок годности 19.09.2023
- Изготовитель: «GUANGZHOUYANGTAOTRADINGCO., LTD», Китай (поставщик в Республику Беларусь: ИП Дворецкий О.В., г. Могилев)
- не соответствуетTP ТС 021/2011, TP ТС 022/2011, TP ТС 029/2012 по безопасности и маркировке(предписание о запрете ввоза и обращения опасной продукции от 26.02.2021 № 06-18-1/213; предписание о прекращении действия документов об оценке соответствия от 26.02.2021 № 06-18-2/214) - с 03.2021
Напиток безалкогольный сокосодержащий газированный виноградный «Mickey Моusе»/«Микки Маус»

- Дата розлива 18.09.2019, употребить до 18.09.2021
- Изготовитель: «Vitapress Кп», Венгрия (импортер в Республику Беларусь: общество с ограниченной ответственностью «Европейские вина» г. Минск)
- Не соответствуетTP ТС 021/2011, TP ТС 029/2012 по безопасности(предписание о запрете ввоза и обращения опасной продукции от 26.02.2021 № 06-18-1/215; предписание о прекращении действия документов об оценке соответствия от 26.02.2021 № 06-18-2/216) - с 03.2021
Напиток безалкогольный негазированный - жидкая конфета-спрей «Газовый баллон XXL»

- Дата производства 05.07.2020, годен до 04.07.2023
- Изготовитель: «CHAOZHOUCHAOANWANGQINGFOODSСО, LTD», Китай (поставщик в Республику Беларусь: ИП Дворецкий О.В, г. Могилев)
- Не соответствуетTP ТС 021/2011, TP ТС 022/2011, TP ТС 029/2012 по безопасности и маркировке(предписание о запрете ввоза и обращения опасной продукции от 26.02.2021 №06-18-1/217) - с 03.2021
Напиток безалкогольный тонизирующий (энергетический) газированный «ВLАСК MONSTER»

- Изготовлено 17.11.2020, годен до 17.11.2022
- Изготовитель: ООО «КОКА-КОЛА ЭЙЧБИСИ ЕВРАЗИЯ», Россия, г. Нижний Новгород; адрес производства филиал ООО «КОКА-КОЛА ЭЙЧБИСИ ЕВРАЗИЯ», Россия, г. Москва (поставщик в Республику Беларусь: унитарное предприятие «Кока-Кола Бевриджис Белорусия», Минская область).
- не соответствуетTP ТС 021/2011, TP ТС 029/2012 по безопасности(предписание о запрете ввоза и обращения опасной продукции от 26.02.2021 № 06-18-1/219; предписание о прекращении действия документов об оценке соответствия от 26.02.2021 № 06-18-2/220) - с 03.2021
Смесь пряностей и специй «Деликат» «Для супа»
- Изготовления 21.12.2020, срок годности 24 месяца
- Изготовитель: ООО «Колычевское производственное предприятие», Российская Федерация, Московская область, г. Домодедово, (импортер в Республику Беларусь: ИП Веремиенко О.П, Минский район, д. Копище)
не соответствуют TP ТС 021/2011 по микробиологическим показателям (предписание о прекращении действия от 24.02.2021 № 06-18-2/221) - с 04.03.2021
Какао-напиток растворимый с ароматом лесных «MacChocolate»

- Дата изготовления 01.02.2020, срок годности 24 месяца
- импортеры в Республику Беларусь: ОДО «НП- СЕРВИС», ООО «Альфа-Дистрибьюция», г. Минск
- Не соответствуют ТР ТС 021/2011, TP ТС 029/2012 по безопасности (предписание о запрете) ввоза и обращения опасной продукции от 26.02.2021 № 06-18-1/222) - с 03.2021
Напиток кофейный растворимый (3 в 1) «Strong» с товарным знаком «MacCoffee»

- Дата изготовления ОТЛ 1.2019, срок годности 24 месяца
- Импортеры в Республику Беларусь: ОДО «НП-СЕРВИС», ОДО «Монстра Групп», г. Минск
- Не соответствуют ТР ТС 021/2011, TP ТС 029/2012 по безопасности (предписание о запрете) ввоза и обращения опасной продукции от 26.02.2021 № 06-18-1/222) - с 03.2021
Жевательные конфеты «МАМВА КОЛА & ФРУКТЫ»

- Дата изготовления 29.03.2020, срок годности 29.03.2021
- Изготовитель: «AUGUSTSTORCKKG (АУГУСТ ШТОРК КГ)», Германия (импортер в Республику Беларусь: ООО «Альфа-Дистрибьюция», г. Минск)
- не соответствуетTP ТС 021/2011, TP ТС 029/2012 по безопасности(предписание о запрете ввоза и обращения опасной продукции от 26.02.2021 № 06-18-1/224; предписание о прекращении действия документов об оценке соответствия от 26.02.2021 № 06-18-2/225) - с 03.2021
Коржи бисквитные торговой марки «Русский бисквит» с какао

- Даты изготовления 13.11.2020, 30.11.2020, срок годности 6 месяцев
- Изготовитель: АО «Русский бисквит», Россия, г. Череповец (импортер в Республику Беларусь: ООО «Альтерини», Минская область
- не соответствует TP ТС 021/2011, TP ТС
029/2012 по безопасности (предписание о запрете ввоза и обращения
опасной продукции от 26.02.2021 № 06-18-1/224; предписание о
прекращении действия документов об оценке соответствия от 26.02.2021 № 06-18-2/225) - с 03.2021
Изделие кондитерское сахарное («зефир»), «EASTER MARSHMALLOW»

- Дата изготовления 12.12.2019 ,годен до 11.12.2022
- Изготовитель: «JINJIANGLULUSHUNIMPORT & EXPORTTRADINGCO., LTD», Китай (импортер в Республику Беларусь: ООО «СТБелПлюс», г. Минск)
- не соответствуетTPТС 021/2011, TP ТС 029/2012 по безопасности(предписание о запрете ввоза и обращения опасной продукции от 02.03.2021 № 06-18-2/239) - с 03.2021
Печенье затяжное «CHOCOTARTIN» с начинкой какао крем

- Дата изготовления 24.11.2020, срок годности 12 месяцев.
- Изготовитель: ООО «Нефис», Республика Молдова, г. Кишинев (импортер (поставщик) в Республику Беларусь: ООО «ВитаПродСервис», Гродненская область, г. Лида)
- Не соответствуетTP ТС 021/2011, TP ТС 029/2012 по безопасностии маркировке (предписание о запрете ввоза и обращения опасной продукции от 02.03.2021 № 06-18-2/240) - с 03.2021
Смесь арахиса в хрустящей корочке со вкусами «Сыра», «Бекона», «Васаби», ЭКСТРА торговой марки «Фома Лукич»

- Дата изготовления 11.01.2021, срок годности 6 месяцев
- Изготовитель: ООО «ПК «Астраханкина рыбка», Российская Федерация, Московская область, г. Талдом (поставщик в Республику Беларусь: частное торговое унитарное предприятие «Зевскомторг», г. Орша)
- не соответствуетTP ТС 021/2011, TP ТС 022/2011 по маркировке(предписание о запрете ввоза и обращения опасной продукции от 02.03.2021 № 06-18-2/241) - с 03.2021
Рулет бисквитный «Мини-рулет» Вишня со сливками»

- Дата изготовления 13.01.2020, срок годности 20 месяцев
- Изготовитель: ООО «Солнечная Долина», Российская Федерация, Московская область, г. Балашиха (поставщик в Республику Беларусь: частное торговое унитарное предприятие «Зевскомторг», г. Орша)
- не соответствуетTP ТС 021/2011, TP ТС 022/2011 по маркировке(предписание о запрете ввоза и обращения опасной продукции от 02.03.2021 № 06-18-2/242) - с 03.2021
Сушеная пищевая рыбная продукция: «Треска сушеная нарезка» торговой марки «Chipka»

- Дата изготовления 24.08.2020, срок годности 18 месяцев
- «LongkouYunfengAquaticFoodCo, Ltd», Китай, (поставщик в Республику Беларусь: частное торговое унитарное предприятие «Зевскомторг», г. Орша)
- не соответствуетTP ЕАЭС 040/2016, TP ТС 029/2012, TP ТС 021/2011 по безопасности(предписание о запрете ввоза и обращения опасной продукции от 02.03.2021 № 06-18-2/243) -с 03.2021
Жевательная резинка с маркировкой Джамбура «КАРТОШКА ФРИ»

- дата изготовления 20.01.2020, годен до 20.01.2022
- Изготовитель: «GUJRANWALA FOOD INDUSTRIES (PVT.) LTD», Пакистан (импортер в Республику Беларусь: общество с ограниченной ответственностью «БелСивАрт», г. Барановичи)
- не соответствуетTP ТС 021/2011, TP ТС 022/2011, TP ТС 029/2012 по безопасности и маркировке(предписание о запрете ввоза и обращения опасной продукции от 26.02.2021 № 06-18-1/229; предписание о прекращении действия документов об оценке соответствия от 26.02.2021 № 06-18-2/230)
Жевательный мармелад «SOUR ROPE

- Дата изготовления 11.2020, годен до 11.2022
- изготовитель: «ТоуЬох GidaPazarlamaSanayiVeTicaretLtdSti», Турция (импортер в Республику Беларусь: общество с ограниченной ответственностью «ЕвроСмокТрейд», г. Витебск)
- не соответствуетTP ТС 021/2011, TP ТС 029/2012 по безопасности(предписаниео запрете ввоза и обращения опасной продукции от 26.02.2021 № 06-18-1/231; предписание о прекращении действия документов об оценке соответствия от 26.02.2021 № 06-18-2/232)
Напиток безалкогольный сильногазированный «YESTA COLA

- Дата розлива 08.12.2020, годен "до - 09.2021
- Изготовитель: ООО «Ярцевский комбинат алкогольных и. безалкогольных напитков», Российская Федерация, Московская ; обл.,г. Пушкино (импортер в Республику Беларусь: ООО «МосПродуктСервис» г. Брест)
- не соответствуетTP ТС 021/2011, TP ТС 022/2011, TP ТС 029/2012 по маркировке(предписание о запрете ввоза и обращения опасной продукции от 26.02.2021 № 06-18-1/233; предписание о прекращении действия документов об оценке соответствия от 26.02.2021 № 06-18-2/234)
HARIBO. Суфле-Маршмеллоу

- Дата изготовления 09.12.2019, годен до 05.03.2021
- Изготовитель: «HARIBOBelglquebvba» (ХАРИБО Бельгия баба), Бельгия (поставщик в Республику Беларусь: ООО «Запад Ритейл Логистика», г. Минск)
- не соответствуетTP ТС 021/2011, TP ТС 029/2012 по безопасности(предписание о запрете ввоза и обращения опасной продукции от 26.02.2021 № 06-18-1/235; предписание о прекращении действия документов об оценке соответствия от 26.02.2021 №06-18-2/236)
Информацию подготовила помощник врача-гигиениста
Ошмянского районного ЦГЭ Михайлова Анна Сергеевна
19.03.2021
В целях обеспечения санитарно-эпидемиологического благополучия населения и недопущения к реализации пищевой продукции, представляющей потенциальную опасность для здоровья людей информируем:
Жевательная резинка «Вкусный градусник»
- Дата изготовления 20.09.2020, срок годности 19.09.2023
- Изготовитель: «GUANGZHOUYANGTAOTRADINGCO., LTD», Китай (поставщик в Республику Беларусь: ИП Дворецкий О.В., г. Могилев)
- не соответствуетTP ТС 021/2011, TP ТС 022/2011, TP ТС 029/2012 по безопасности и маркировке(предписание о запрете ввоза и обращения опасной продукции от 26.02.2021 № 06-18-1/213; предписание о прекращении действия документов об оценке соответствия от 26.02.2021 № 06-18-2/214) - с 03.2021
Напиток безалкогольный сокосодержащий газированный виноградный «Mickey Моusе»/«Микки Маус»

- Дата розлива 18.09.2019, употребить до 18.09.2021
- Изготовитель: «Vitapress Кп», Венгрия (импортер в Республику Беларусь: общество с ограниченной ответственностью «Европейские вина» г. Минск)
- Не соответствуетTP ТС 021/2011, TP ТС 029/2012 по безопасности(предписание о запрете ввоза и обращения опасной продукции от 26.02.2021 № 06-18-1/215; предписание о прекращении действия документов об оценке соответствия от 26.02.2021 № 06-18-2/216) - с 03.2021
Напиток безалкогольный негазированный - жидкая конфета-спрей «Газовый баллон XXL»

- Дата производства 05.07.2020, годен до 04.07.2023
- Изготовитель: «CHAOZHOUCHAOANWANGQINGFOODSСО, LTD», Китай (поставщик в Республику Беларусь: ИП Дворецкий О.В, г. Могилев)
- Не соответствуетTP ТС 021/2011, TP ТС 022/2011, TP ТС 029/2012 по безопасности и маркировке(предписание о запрете ввоза и обращения опасной продукции от 26.02.2021 №06-18-1/217) - с 03.2021
Напиток безалкогольный тонизирующий (энергетический) газированный «ВLАСК MONSTER»

- Изготовлено 17.11.2020, годен до 17.11.2022
- Изготовитель: ООО «КОКА-КОЛА ЭЙЧБИСИ ЕВРАЗИЯ», Россия, г. Нижний Новгород; адрес производства филиал ООО «КОКА-КОЛА ЭЙЧБИСИ ЕВРАЗИЯ», Россия, г. Москва (поставщик в Республику Беларусь: унитарное предприятие «Кока-Кола Бевриджис Белорусия», Минская область).
- не соответствуетTP ТС 021/2011, TP ТС 029/2012 по безопасности(предписание о запрете ввоза и обращения опасной продукции от 26.02.2021 № 06-18-1/219; предписание о прекращении действия документов об оценке соответствия от 26.02.2021 № 06-18-2/220) - с 03.2021
Смесь пряностей и специй «Деликат» «Для супа»
- Изготовления 21.12.2020, срок годности 24 месяца
- Изготовитель: ООО «Колычевское производственное предприятие», Российская Федерация, Московская область, г. Домодедово, (импортер в Республику Беларусь: ИП Веремиенко О.П, Минский район, д. Копище)
не соответствуют TP ТС 021/2011 по микробиологическим показателям (предписание о прекращении действия от 24.02.2021 № 06-18-2/221) - с 04.03.2021
Какао-напиток растворимый с ароматом лесных «MacChocolate»

- Дата изготовления 01.02.2020, срок годности 24 месяца
- импортеры в Республику Беларусь: ОДО «НП- СЕРВИС», ООО «Альфа-Дистрибьюция», г. Минск
- Не соответствуют ТР ТС 021/2011, TP ТС 029/2012 по безопасности (предписание о запрете) ввоза и обращения опасной продукции от 26.02.2021 № 06-18-1/222) - с 03.2021
Напиток кофейный растворимый (3 в 1) «Strong» с товарным знаком «MacCoffee»

- Дата изготовления ОТЛ 1.2019, срок годности 24 месяца
- Импортеры в Республику Беларусь: ОДО «НП-СЕРВИС», ОДО «Монстра Групп», г. Минск
- Не соответствуют ТР ТС 021/2011, TP ТС 029/2012 по безопасности (предписание о запрете) ввоза и обращения опасной продукции от 26.02.2021 № 06-18-1/222) - с 03.2021
Жевательные конфеты «МАМВА КОЛА & ФРУКТЫ»

- Дата изготовления 29.03.2020, срок годности 29.03.2021
- Изготовитель: «AUGUSTSTORCKKG (АУГУСТ ШТОРК КГ)», Германия (импортер в Республику Беларусь: ООО «Альфа-Дистрибьюция», г. Минск)
- не соответствуетTP ТС 021/2011, TP ТС 029/2012 по безопасности(предписание о запрете ввоза и обращения опасной продукции от 26.02.2021 № 06-18-1/224; предписание о прекращении действия документов об оценке соответствия от 26.02.2021 № 06-18-2/225) - с 03.2021
Коржи бисквитные торговой марки «Русский бисквит» с какао

- Даты изготовления 13.11.2020, 30.11.2020, срок годности 6 месяцев
- Изготовитель: АО «Русский бисквит», Россия, г. Череповец (импортер в Республику Беларусь: ООО «Альтерини», Минская область
- не соответствует TP ТС 021/2011, TP ТС
029/2012 по безопасности (предписание о запрете ввоза и обращения
опасной продукции от 26.02.2021 № 06-18-1/224; предписание о
прекращении действия документов об оценке соответствия от 26.02.2021 № 06-18-2/225) - с 03.2021
Изделие кондитерское сахарное («зефир»), «EASTER MARSHMALLOW»

- Дата изготовления 12.12.2019 ,годен до 11.12.2022
- Изготовитель: «JINJIANGLULUSHUNIMPORT & EXPORTTRADINGCO., LTD», Китай (импортер в Республику Беларусь: ООО «СТБелПлюс», г. Минск)
- не соответствуетTPТС 021/2011, TP ТС 029/2012 по безопасности(предписание о запрете ввоза и обращения опасной продукции от 02.03.2021 № 06-18-2/239) - с 03.2021
Печенье затяжное «CHOCOTARTIN» с начинкой какао крем

- Дата изготовления 24.11.2020, срок годности 12 месяцев.
- Изготовитель: ООО «Нефис», Республика Молдова, г. Кишинев (импортер (поставщик) в Республику Беларусь: ООО «ВитаПродСервис», Гродненская область, г. Лида)
- Не соответствуетTP ТС 021/2011, TP ТС 029/2012 по безопасностии маркировке (предписание о запрете ввоза и обращения опасной продукции от 02.03.2021 № 06-18-2/240) - с 03.2021
Смесь арахиса в хрустящей корочке со вкусами «Сыра», «Бекона», «Васаби», ЭКСТРА торговой марки «Фома Лукич»

- Дата изготовления 11.01.2021, срок годности 6 месяцев
- Изготовитель: ООО «ПК «Астраханкина рыбка», Российская Федерация, Московская область, г. Талдом (поставщик в Республику Беларусь: частное торговое унитарное предприятие «Зевскомторг», г. Орша)
- не соответствуетTP ТС 021/2011, TP ТС 022/2011 по маркировке(предписание о запрете ввоза и обращения опасной продукции от 02.03.2021 № 06-18-2/241) - с 03.2021
Рулет бисквитный «Мини-рулет» Вишня со сливками»

- Дата изготовления 13.01.2020, срок годности 20 месяцев
- Изготовитель: ООО «Солнечная Долина», Российская Федерация, Московская область, г. Балашиха (поставщик в Республику Беларусь: частное торговое унитарное предприятие «Зевскомторг», г. Орша)
- не соответствуетTP ТС 021/2011, TP ТС 022/2011 по маркировке(предписание о запрете ввоза и обращения опасной продукции от 02.03.2021 № 06-18-2/242) - с 03.2021
Сушеная пищевая рыбная продукция: «Треска сушеная нарезка» торговой марки «Chipka»

- Дата изготовления 24.08.2020, срок годности 18 месяцев
- «LongkouYunfengAquaticFoodCo, Ltd», Китай, (поставщик в Республику Беларусь: частное торговое унитарное предприятие «Зевскомторг», г. Орша)
- не соответствуетTP ЕАЭС 040/2016, TP ТС 029/2012, TP ТС 021/2011 по безопасности(предписание о запрете ввоза и обращения опасной продукции от 02.03.2021 № 06-18-2/243) -с 03.2021
Жевательная резинка с маркировкой Джамбура «КАРТОШКА ФРИ»

- дата изготовления 20.01.2020, годен до 20.01.2022
- Изготовитель: «GUJRANWALA FOOD INDUSTRIES (PVT.) LTD», Пакистан (импортер в Республику Беларусь: общество с ограниченной ответственностью «БелСивАрт», г. Барановичи)
- не соответствуетTP ТС 021/2011, TP ТС 022/2011, TP ТС 029/2012 по безопасности и маркировке(предписание о запрете ввоза и обращения опасной продукции от 26.02.2021 № 06-18-1/229; предписание о прекращении действия документов об оценке соответствия от 26.02.2021 № 06-18-2/230)
Жевательный мармелад «SOUR ROPE

- Дата изготовления 11.2020, годен до 11.2022
- изготовитель: «ТоуЬох GidaPazarlamaSanayiVeTicaretLtdSti», Турция (импортер в Республику Беларусь: общество с ограниченной ответственностью «ЕвроСмокТрейд», г. Витебск)
- не соответствуетTP ТС 021/2011, TP ТС 029/2012 по безопасности(предписаниео запрете ввоза и обращения опасной продукции от 26.02.2021 № 06-18-1/231; предписание о прекращении действия документов об оценке соответствия от 26.02.2021 № 06-18-2/232)
Напиток безалкогольный сильногазированный «YESTA COLA

- Дата розлива 08.12.2020, годен "до - 09.2021
- Изготовитель: ООО «Ярцевский комбинат алкогольных и. безалкогольных напитков», Российская Федерация, Московская ; обл.,г. Пушкино (импортер в Республику Беларусь: ООО «МосПродуктСервис» г. Брест)
- не соответствуетTP ТС 021/2011, TP ТС 022/2011, TP ТС 029/2012 по маркировке(предписание о запрете ввоза и обращения опасной продукции от 26.02.2021 № 06-18-1/233; предписание о прекращении действия документов об оценке соответствия от 26.02.2021 № 06-18-2/234)
HARIBO. Суфле-Маршмеллоу

- Дата изготовления 09.12.2019, годен до 05.03.2021
- Изготовитель: «HARIBOBelglquebvba» (ХАРИБО Бельгия баба), Бельгия (поставщик в Республику Беларусь: ООО «Запад Ритейл Логистика», г. Минск)
- не соответствуетTP ТС 021/2011, TP ТС 029/2012 по безопасности(предписание о запрете ввоза и обращения опасной продукции от 26.02.2021 № 06-18-1/235; предписание о прекращении действия документов об оценке соответствия от 26.02.2021 №06-18-2/236)
Информацию подготовила помощник врача-гигиениста
Ошмянского районного ЦГЭ Михайлова Анна Сергеевна
19.03.2021
Ежегодно 15 марта международная общественность отмечает Всемирный день прав потребителей (WorldConsumerRightsDay), или Всемирный день защиты прав потребителей, проведение которого решением ООН приурочено к годовщине выступления Президента США Джона Ф.Кеннеди (John F Kennedy) в Конгрессе в 1962 году. Тогда в выступлении Президента были сформулированы четыре основных права потребителя:
- право на безопасность,
- право на информацию,
- право на выбор,
- право быть услышанным.
Позднее к ним добавились еще четыре:
- право на возмещение ущерба,
- право на потребительское образование,
- право на удовлетворение базовых потребностей,
- право на здоровую окружающую среду(о последнем поговорим подробней)
Сегодня мы окружены пластиком. Еда, продукты гигиены в него упакованы. Автомобиль, компьютер, мобильник из него сделаны. И вы, возможно, даже едите его, если любите жевательную резинку. Пластик удобен, прост в изготовлении, красив и сохраняет свежесть наших продуктов. Он восхитителен – пока не осознаешь, что после того, как он выполнил свою функцию, от него практически невозможно избавиться.Нам часто пишут на упаковке, что этот пластик будет переработан. Но это не значит, что пластмассовую бутылку из-под молока можно превратить в такую же бутылку. Чаще всего ее можно превратить только в пластиковое бревно, которое дальнейшей переработке не подлежит.И весь пластик, который не сожжен (в конце концов, он же делается из нефти!), весь до единого кусочка, не девается никуда, не разлагается. Свой земной путь он очень часто заканчивает в мировом океане. Около 100 тысяч морских обитателей и около миллиона морских птиц ежегодно умирают от пластика, который они проглотили.
Как сократить количество пластикового мусора?
Откажитесь от соломинок: откажитесь от соломинки для напитка. Предупредите официантку, бармена, что вам она не нужна. Расскажите про существование альтернативного решения – соломинок из бамбука, например.
Откажитесь от пластиковой посуды: откажитесь от одноразовой пластиковой посуды. В конце концов помыть несколько тарелок, стаканов и приборов в наше время – не такая уж трудная задача, а выглядят они намного красивее одноразовых, которые не поддаются переработке.
Многоразовые бутылки для воды: используйте бутылку для воды многократно, не покупайте каждый раз новую. Просто перелейте из большой бутылки в маленькую столько воды, сколько вам нужно в дорогу. Еще лучше – вообще откажитесь от бутылочной воды, берите с собой воду из-под крана.
Многоразовые кружки для кофе: не останавливайтесь на этом – возьмите с собой в кофейню многоразовую кружку для кофе навынос. Средний служащий крупного города выпивает около 500 порций кофе в год, и в основном из стаканов, сделанных с применением пластика.
Многоразовые контейнеры для обедов: идете за обедом в ресторан? Возьмите с собой многоразовые контейнеры. Абсолютное большинство ресторанов не станет возражать против того, чтобы положить еду в принесенную вами тару. То же самое с остатками еды, которую вы хотите унести с собой после обеда в ресторане.
Спички: откажитесь от одноразовых пластиковых зажигалок, используйте вместо них деревянные спички. То же самое с бритвами – используйте бритву со сменными металлическими лезвиями вместо пластиковых одноразовых.
Покупайте еду правильно:при покупке продуктов, и особенно овощей и фруктов, отдайте предпочтение лежащим россыпью, а не упакованным в пластик. Тут вы можете вручную выбрать каждое яблоко или апельсин, а не брать то, что вам заранее положили и упаковали. То же самое с хлебом.
Нет – пластиковым пакетам для покупок: Откажитесь от одноразовых пластиковых пакетов для покупок. Около 500 лет пройдет до того, как этот пакет разложится, если его просто выбросить. Ходите в магазин с многоразовой сумкой, и лучше не из нейлона или полистера (потому что это тоже пластик), а из хлопка.
Нет – микробусинкам: микробусинки используются во многих скрабах для лица и тела и в отбеливающей зубной пасте. Потом эти микрочастицы пластика смываются водой и попадают в реки, моря и океаны, где их проглатывает рыба. Хорошие скрабы делаются на основе натуральных продуктов – абрикосовых косточек и кожуры кокоса.
Молоко в картонных упаковках: откажитесь от упакованных в пластик молочных продуктов.
Неупакованные чистящие средства и косметика: описывая возможности сократить потребление пластика, в которые теперь пакуют продукты для стирки, уборки помещений и так далее, многие специализированные сайты предлагают не только выбирать те, что упакованы в картон, но и вернуться к старинным методам работы по дому. Пищевая сода и уксус – отличные средства для чистки поверхностей, посуды и мойки окон.
Информацию подготовила помощник врача-гигиениста
Ошмянского районного ЦГЭ Михайлова А.С
12.03.2021
В целях обеспечения санитарно-эпидемиологического благополучия населения и недопущения к реализации пищевой продукции, представляющей потенциальную опасность для здоровья людей информируем:
«Полуфабрикат перец фаршированный замороженный»

- Дата изготовления 19.12.2020, срок годности 6 месяцев.
-
Изготовитель: ООО ПЗП «Элика», Украина, Николаевская область, Витовский район, с. Котлярево, ул. Комарова, 62,57260, поставщик: ООО «ЮГФУД», Украина, Одесская область, Одесса, 19 км. Старокиевской дороги, 65025, импортер в Республику Беларусь: СП «Санта Импэкс Брест» ООО, Республика Беларусь, 224004, г. Брест, ул. Катин Бор, 106а .
-
Не соответствует требованиям Санитарных норм и правил «Требования к продовольственному сырью и пищевым продуктам», Гигиенического норматива «Показатели безопасности и безвредности для человека продовольственного сырья и пищевых продуктов», утв. постановлением Министерства здравоохранения Республики Беларусь 21.06.2013 № 52, TP ТС 021/2011 «О безопасности пищевой продукции», утв. Решением Комиссии Таможенного союза от 09.12.2011 № 880, по микробиологическому показателю - в 0,0001 г продукта , обнаружены БГКП.
«Свекла столовая свежая»

- Дата сбора- август 2020, дата упаковки 18.02.2021, срок годности 180 суток.
- Изготовитель (заготовитель)/продавец: ООО «Фрутлинкс», Республика Беларусь, 220012, г. Минск, ул. К.Чорного, 5а, офис 13а.
-
Не соответствует требованиям Санитарных норм и правил «Требования к продовольственному сырью и пищевым продуктам», Гигиенического норматива «Показатели безопасности и безвредности для человека продовольственного сырья и пищевых продуктов», утв. постановлением Министерства здравоохранения Республики Беларусь 21.06.2013 №52, TP ТС 021/2011 «О безопасности пищевой продукции», утв. решением Комиссии Таможенного союза от 09.12.2011 № 880, по содержанию нитратов - обнаружены нитраты в количестве 2300 мг/кг при норме 1400 мг/кг.
Арахис в хрустящей корочке со вкусом бекона т.м. «Южная снековая компания»

- Дата изготовления 23.11.2020, срок годности до 23.07.2021.
-
Изготовитель: ООО «ЮСК», 350075, Россия, г. Краснодар, ул. им. Стасова, дом 178, пом. 209; импортер в РБ: ООО «ВедаПром», 222357, РБ, Минская область, Воложинский район, г. Воложин, ул. Набережная, д. 14, ком.
-
Не соответствует требованиям TP ТС 029/2012, СНиП и ГН от 12.12.2012 № 195 по содержанию красителя «солнечный закат» (FCF El 10) фактическое содержание составило 598,7 мк/кг при норме не более 100 мк/кг.
Информацию подготовила помощник врача-гигиениста
В целях обеспечения санитарно-эпидемиологического благополучия населения и недопущения к реализации пищевой продукции, представляющей потенциальную опасность для здоровья людей информируем:
Изделие кондитерское мучное: пряники с начинками, в индивидуальной упаковке 4,5 кг.

- Дата изготовления 10.11.2020, срок годности 12 месяцев.
- Изготовитель: ООО «Кондитрейд», Российская Федерация, Краснодарский край, г. Армавир; (поставщик в Республику Беларусь: ООО «Витрум плюс», Минская область, Червенский район, аг. Заполье).
- Не соответствуют TP ТС 021/2011, TP ТС 022/2011, по безопасности и маркировке. предписание о запрете ввоза и обращения опасной продукции от 12.02.2021 № 06-18-1/135; предписание о прекращении действия документов об оценке соответствия от 02.2021 № 06-18-2/136).
Карамель леденцовая «Монпасье», в индивидуальной упаковке 3,0 кг.

- Дата изготовления 10.11.2020, срок годности 12 месяцев.
- Изготовитель: ООО «Кондитрейд», Российская Федерация, Краснодарский край, г. Армавир;(поставщик в Республику Беларусь: ООО «Витрум плюс», Минская область, Червенский район, аг. Заполье).
- Не соответствуют TP ТС 021/2011, TP ТС 022/2011, по безопасностии маркировке (предписание о запрете ввоза и обращения опасной продукции от 12.02.2021 № 06-18-1/135; предписание о прекращении действия документов об оценке соответствия от 02.2021 № 06-18-2/136).
Конфеты неглазированные со сбивными корпусами «ХИТВИК», весовые, упакованные в картонный короб, масса 3,0 кг.

- Дата изготовления 27.07.2020, срок годности 6 месяцев.
- Изготовитель: ООО «Сладуница», Российская Федерация, г. Омск (поставщик в Республику Беларусь: ООО «Вельми Ссмачна», УНП 192955293, г. Минск)
- Не соответствуют TP ТС 021/2011, TP ТС 022/2011 по безопасности и маркировке (предписание о запрете ввоза и обращения опасной продукции от 12.02.2021 № 06-18-1/137; предписание о прекращении действия документов об оценке соответствия от 12.02.2021 №06-18-2/138).
Восточные сладости мучные «Кунжут в меде» весовые, в упаковке массой нетто 2,0 кг.

- Изготовлено и упаковано 05.01.2021, срок годности 30 суток.
- Изготовитель: ООО «Стоянка», Российская Федерация (поставщик в Республику Беларусь: ООО «Вкусное дело», Минская область).
- Не соответствуют TP ТС 021/2011, TP ТС 022/2011 по маркировке (предписание о прекращении действия документов об оценке соответствия от 19.02.2021 № 06-18-2/160).
Дражже «Арахис в какао-порошке»

- Дата изготовления 05.12.2020, срок годности 6 месяцев.
- Изготовитель: ООО «ФИРМА «ЭОТ», Российская Федерация (поставщик в Республику Беларусь: ООО «Вкусное дело», Минская область).
- Не соответствуют TP ТС 021/2011, TP ТС 029/2012 по безопасности(предписание о запрете ввоза и обращения опасной продукции от 19.02.2021 На 06-18-1/161; предписание о прекращении действия № 06-18-2/162).
Арахис в хрустящей корочке со вкусом бекона, со вкусом креветки, со вкусом четыре сыра, «Микс».

- Дата изготовления 25.12.2020,срок годности 8 месяцев.
- Изготовитель: ООО «Южная Снековая компания», Российская Федерация (поставщик в Республику Беларусь: ООО «ВедаПром», Минская область).
- Не соответствуют TP ТС 021/2011, TP ТС 029/2012 в части превышения максимального уровня красителя в продукции и TP ТС 022/2011 в части ввода потребителя в заблуждение (предписание о запрете ввоза и обращения опасной продукции от 19.02.2021 № 06-18-1/163; предписание о прекращении действия № 06-18-2/164).
Информацию подготовила помощник врача-гигиениста
Ошмянского районного ЦГЭ Михайлова Анна Сергеевна
03.03.2021
В целях обеспечения санитарно-эпидемиологического благополучия населения и недопущения к реализации продукции, представляющей потенциальную опасность для здоровья людей информируем:
1) Перчатки защитные от механических воздействий торговой марки «Jeta Safety»
- Изготовитель «TONSUN INDUSTRIAL (PSP) CO., LIMITED.», Китай.
- Защитные свойства МИ, артикул JSOllpg

2)Перчатки для защиты рук от механических факторов, трикотажные из хлопчатобумажной пряжи с покрытием из поливинилхлорида, торговой марки «Jeta Safety»
- Изготовитель «LIANYUNGANG HAITAIER PROTECTIVE EQUIPMENT CO.,LTD», Китай.
- Защитные свойства Мп, артикул JP
- Импортер в Республику Беларусь ЧП «Иннель» (г. Ошмяны).
«О прекращении действия на территории Республики Беларусь документов об оценке соответствия» от 02.02.2021 №06-18-2/86 следующих документов: декларации о соответствии ЕАЭС RU Д-СКШФ02.В.01636/19; сертификата соответствия № ЕАЭС RU C-CN.AB61 .В.00403/19; сертификата соответствия № ТС RU С-СКАД78.В.01143/18
В целях обеспечения санитарно-эпидемиологического благополучия населения и недопущения к реализации пищевой продукции, представляющей потенциальную опасность для здоровья людей информируем:
Изделие кондитерское слоеное мучное: слойка «Крекер» с семенами подсолнечника и льна

- Дата выработки 06.02.2020, срок годности 90 суток.
- Изготовитель: ООО «Успех-Вкуснятки», Российская Федерация, Московская область, г. Королев; адрес производства: Российская Федерация, Московская область, Раменский район, д. Кузнецово (поставщик в Республику Беларусь: ЗАО «Доброном», УНП 191178504, г. Минск).
- Не соответствует TP ТС 021/2011, TP ТС 022/2011, по безопасности и маркировке (предписание о запрете ввоза и обращения опасной продукции от 09.02.2021 № 06-18-1/114; предписание о прекращении действия документов об оценке соответствия от 09.02.2021 №06-18-2/115)
Конфеты «Аккондовская КАРТОШКА»

- Изготовлено 01.09.2020, годен до 01.05.2021.
- Изготовитель: АО «АККОНД», Российская Федерация, Чувашская Республика, г. Чебоксары (поставщик в Республику Беларусь: ООО «Вельми Смачна», УНП 192955293, г. Минск).
- не соответствуют TP ТС 021/2011, TP ТС 029/2012 по безопасности (предписание о запрете ввоза и обращения опасной продукции.
«Паста кулинарная томатная», фасованная в стеклянную банку.

- Дата изготовления 18.09.2020, срок годности 1 год.
- Изготовитель: ООО «Тихвинский уездъ», Российская Федерация, г. Смоленск (поставщик в Республику Беларусь: ИП Рудакова Н.П., г. Орша).
- Не соответствует TP ТС 029/2012 по безопасности (предписание о запрете ввоза и обращения опасной продукции от 03.02.2021 № 06-18-1/100; предписание о прекращении действия документов об оценке соответствия от 03.02.2021 № 06-18-2/101) -с 06.02.2021.
Скумбрия холодного копчения

- Дата изготовления 30.12.2020, срок годности 60 суток.
- Изготовитель: ООО «Амадей», Российская Федерация, г. Смоленск (поставщик в Республику Беларусь: ИП Рудакова Н.П., г. Орша).
- Не соответствует TP ЕАЭС 040/2016, TP ТС 029/2012, TP ТС 021/2011 по безопасности (предписание о запрете ввоза и обращения опасной продукции от 03.02.2021
В течении 2020 года приоритетной направленностью работы специалистов Ошмянского районного ЦГЭ являлась профилактика правонарушений, а не только привлечение к ответственности за совершенные субъектами хозяйствования нарушений. Свои поправки и ограничения в деятельность всех организаций и предприятий внесла коронавирусная инфекция COVID-19, поэтому первостепенной задачей санитарно-эпидемиологической службы стала профилактика и недопущение распространения вирусных инфекций, в том числе и коронавирусной на объектах торговли, объектах общественного питания и предприятиях пищевой промышленности.
Специалистами Ошмянского районного ЦГЭ надзорными мероприятиями в течении 2020 года охват надзорными мероприятиями субъектов хозяйствования составил 100% или специалистами посещено 84 субъекта хозяйствования различной формы собственности, из них на 78 установлены нарушения санитарно-эпидемиологического законодательства, что составило 93%.
Самый высокий удельный вес выявляемых на торговых объектах нарушений имели реализация продовольственного сырья и пищевых продуктов без наличия маркировки (с информацией, наносимой в соответствии с требованиями технических регламентов Таможенного союза, Евразийского экономического союза) (26 случаев), реализация (предложение к реализации) продукции с истекшим сроком годности (12 случаев), реализация товара без документов, обеспечивающих прослеживаемость и подтверждающих качество и безопасность (6 случаев). Помимо указанных нарушений устанавливались случаи реализации пищевой продукции с признаками недоброкачественности, порчи.
Кроме реализации недоброкачественного продовольственного сырья и пищевых продуктов участились факты не содержания в чистоте помещений объектов, неудовлетворительное состояние торгового, технологического, холодильного оборудования - 29 случая, нарушение условий хранения и реализации пищевой продукции, обеспечивающих предотвращение ее порчи и защиту от загрязняющих веществ и нарушение температурного режима при хранении и реализации пищевой продукции установлены в 28 случаях.
По результатам профилактических и надзорных мероприятий за 2020 год:
составлено 10 протоколов об административном правонарушении на юридических лиц и 14 протоколов на физических лиц;
направлено 162 рекомендации об устранении нарушений в адрес субъектов хозяйствования и 6 предписаний по устранению нарушений;
вынесено 38 предписаний о приостановлении (запрете) реализации товаров общим весом 288,672 кг.
Данные нарушения свидетельствуют об отсутствии на торговых объектах должного уровня производственного контроля за исполнением установленных требований, как со стороны работников, так и со стороны администрации.
В целях наведения порядка на торговых объектах и выполнения санитарно-эпидемиологического законодательства специалистами Ошмянского районного ЦГЭ будет продолжена работа по выявлению нарушений требований санитарного законодательства и принятия мер по их устранению. Особое внимание будет уделено мерам профилактики стрых респираторных инфекций, в том числе коронавирусной.
19.01.2020
В соответствии со статьей 4.12 «Требования к способам доведения маркировки» технического регламента Таможенного союза ТР ТС 022/2011 «Пищевая продукция в части ее маркировки», в пункте 5 указано, что при фасовании пищевой продукции организациями розничной торговли в отсутствии потребителя на потребительской упаковке или на прикрепленной к ней этикетке должны быть указаны наименование пищевой, дата ее изготовления, срок ее годности и условия хранения. Иные сведения, предусмотренные пунктом 1 части 4.1 и пунктом 13 части 4.4 настоящей статьи:
-
состав пищевой продукции, за исключением свежих фруктов (включая ягоды) и овощей (включая картофель), которые не очищены от кожуры, не нарезаны или не обработаны подобным способом;
-
уксуса, полученного из одного вида продовольственного сырья (без добавления других компонентов) и пищевой продукции, состоящей из одного компонента, при условии, что наименование пищевой продукции позволяет установить наличие этого компонента; количество пищевой продукции;
-
наименование и место нахождения изготовителя и импортера (поставщика) пищевой продукции;
-
рекомендации и (или) ограничения по использованию, в том числе приготовлению пищевой продукции в случае, если ее использование без данных рекомендаций или ограничений затруднено, либо может причинить вред здоровью потребителей, их имуществу, привести к снижению или утрате вкусовых свойств пищевой продукции;
-
показатели пищевой ценности пищевой продукции; сведения о наличии в пищевой продукции компонентов, полученных с применением ГМО;
-
единый знак обращения продукции на рынке государств – членов Таможенного союза; компоненты (пищевые добавки, ароматизаторы), биологически активные добавки, употребление которых может вызвать аллергические реакции или противопоказано при отдельных видах заболеваний) доводятся до потребителя любым способом, обеспечивающим возможность обоснованного выбора этой пищевой продукции (в том числе путем нанесения на потребительскую упаковку и (или) этикетку, и (или) на листок-вкладыш, помещаемый в каждую упаковочную единицу или прилагаемый к каждой упаковочной единице продукции.
В целях обеспечения санитарно-эпидемиологического благополучия населения и недопущения к реализации пищевой продукции, представляющей потенциальную опасность для здоровья людей информируем:
Мармелад жевательный фигурный «Кислые Гусенички» и мармелад жевательный фигурный «Веселые мишки»

-
Дата изготовления 16.10.2020, годен до 16.10.2021.
-
Изготовитель: ООО «Азовская кондитерская фабрика», Российская Федерация, Московская область, г. Мытищи, адрес производства: Российская Федерация, Ростовская область, г. Азов (импортеры в Республику Беларусь: ООО «ЛенПродуктСервис», г. Минск; ООО «МосПродуктСервис», г. Брест; ООО «ВитебскПродуктСервис», г.Витебск; ООО «ГомельПродуктСервис», г. Гомель; ЧПТУП «Здоровый продукт», Минский район).

-
Не соответствуют TP ТС 021/2011, TP ТС 022/2011 по показателям маркировке в части предоставления достоверной информации о составе продукта и отсутствию предупреждающей надписи о наличии красителя, влияющего на активность и внимание детей (предписание о запрете ввоза и обращения опасной продукции от 29.12.2020 № 06-18-1/2201; предписание о прекращении действия документов об оценке соответствия от 29.12.2020 № 06-18-2/2202).
Зефир классический, весовой

-
Дата изготовления 26.07.2020, срок годности 6 месяцев.
-
Изготовитель: ООО «Кондитерское объединение «Сладиал», Российская Федерация, Свердловская область, г.Полевской (импортеры в Республику Беларусь: ООО «ЛенПродуктСервис» г. Минск; ООО «МосПродуктСервис», г .Брест; ООО «ВитебскПродуктСервис», г. Витебск; ООО «ГомельПродуктСервис», г. Гомель)
-
Не соответствует TP ТС 021/2011, TP ТС 022/2011, TP ТС 029/2012 по показателям безопасности и маркировке (предписание о прекращении действия документов об оценке соответствия от 29.12.2020 №06-18-2/2203).
Томатная паста. «Краснодарская», категория «Экстра»

-
Дата изготовления 04.08.2020, срок годности 1 год.
-
изготовитель: ИП Чколян А.Г., Российская Федерация, Балашихинский район, д.Соболиха (поставщик в Республику Беларусь: индивидуальный предприниматель Михайловский Сергей Владимирович, г. Орша)
-
Не соответствует TP ТС 029/2012, TP ТС 021/2011 по показателям безопасности и маркировке (предписание о запрете ввоза и обращения опасной продукции от 29.12.2020 № 06-18-1/2204; предписание о прекращении действия документов об оценке соответствия от 29.12.2020 №06-18-2/2205)
Соус томатный «Краснодарский сладкий»
-
Дата изготовления 22.10.2020 и 23.10.2020, срок годности 1 год.
-
Изготовитель: ООО. «Тихвинский уездъ», Российская Федерация, г.Смоленск (поставщик в Республику Беларусь: индивидуальный предприниматель Михайловский Сергей Владимирович, г. Орша)
-
Не соответствуют TP ТС 021/2011, TP ТС 022/201, TP ТС 029/2012, по показателям безопасности и маркировке (предписание о запрете ввоза и обращения опасной продукции от 29.12.2020 № 06-18-1/2206; предписание о прекращении действия документов об оценке соответствия от 29.12.2020 № 06-18-2/2207)
Майонез «Провансаль» товарного знака «Печагин», массовая доля жира 50 %

-
Дата изготовления 15.10.2020
-
Изготовитель: ООО «Олрос», Российская Федерация, г. Чехов (поставщик в Республику Беларусь: индивидуальный предприниматель Михайловский Сергей Владимирович, г. Орша)
-
Не соответствует TP ТС 021/2011, TP ТС 022/2011, TP ТС 024/2011, TP ТС 029/2012 но показателям безопасности и маркировке (предписание о запрете ввоза и обращения опасной продукции от 29.12.2020 № 06-18-1/2208; предписание о прекращении действия документов об оценке соответствия от 29.12.2020 № 06-18-2/2209).
12.01.2021
В целях обеспечения санитарно-эпидемиологического благополучия населения и недопущения к реализации пищевой продукции, представляющей потенциальную опасность для здоровья людей информируем:

Карамель леденцовая «Lengo» «Спираль» Ассорти № 1 со вкусами: манго, тутти-фрутти, земляника
-
Дата изготовления 01.09.2020, срок годности 2 года
-
Изготовитель: ООО «Свитпро», Российская Федерация, г. Санкт-Петербруг (поставщик в Республику Беларусь: частное предприятие «ЕвроСмокТрейд», г. Витебск)
-
не соответствует TP ТС 021/2011, TP ТС 022/2011, TP ТС 029/2012 по безопасности и маркировке (предписание о запрете ввоза и обращения опасной продукции от 28.12.2020 № 06-18-1/2191; предписание о прекращении действия документов об оценке соответствия от 28.12.2020 № 06-18-2/2192)
Конфеты таблетированные торгового знака «Холодок»: со вкусом винограда с шипучкой, ананаса с шипучкой, «Ассорти»
-
дата изготовления 28.03.2020, со вкусом клубники с шипучкой; дата изготовления 02.10.2020, со вкусом ананаса с шипучкой; дата изготовления 02.09.2020 «Ассорти». Срок годности 2 года
-
изготовитель: ООО «Бастион м.с», Российская
Федерация, г. Москва (поставщик в Республику Беларусь: частное предприятие «ЕвроСмокТрейд», г.Витебск) -
не соответствует TP ТС 021/2011, TP ТС 022/2011, TP ТС 029/2012 по безопасности и маркировке (предписание о запрете ввоза и обращения опасной продукции от 28.12.2020 № 06-18-1/2190; предписание о прекращении действия документов об оценке соответствия от 28.12.2020 № 06-18-2/2189)
Сахарная вата «Я сладкая» Фикси с ароматом «Ежевика», сахарная вата «Я сладкая» Фикси с ароматом «Клубники»

-
Дата изготовления 26.09.2020, срок годности 180 суток
-
Изготовитель: ИП Шорина Н.А., Российская Федерация, г. Москва (поставщик в Республику Беларусь: частное предприятие: «ЕвроСмокТрейд», г. Витебск)
-
не соответствует TP ТС 021/2011, TP ТС 022/2011 по маркировке в части предоставления достоверной информации о составе продукта и отсутствию
предупреждающей надписи о наличии красителя, влияющего на активность и внимание детей (предписание о запрете ввоза и обращения опасной продукции от 28.12.2020 №06-18-1/2188)
12.01.2021
Государственное учреждение «Ошмянский районный центр гигиены и эпидемиологии» информирует, что Главным государственным инспектором Республики Беларусь по надзору за соблюдением технических регламентов запрещен ввоз и обращение и прекращены действия с 23 сентября 2020 года на территории Республики Беларусь деклараций о соответствии:
ЕАЭС N RU Д-RU.АВ31.В.01665/19, сопровождающая сушено-вяленую пищевую рыбную продукцию «Кальмар рваный» (кальмар гигантский, стружка), масса нетто 1,0 кг, дата изготовления 20.08.2020, срок годности 12 месяцев, изготовитель: ООО «СИФУД ИНДАСТРИЗ», Российская Федерация, Калужская область, г. Малоярославец (поставщик в Республику Беларусь: ООО «Фауна», г. Борисов) - предписание о прекращении действия документов об оценке соответствия от 23.11.2020 № 06-18-2/1882.
ЕАЭС N RU Д-RU.АВ31.В.02608/19 сопровождающая сушено-вяленую рыбную продукцию товарного знака «BEERka»: желто-полосатый селар «Желтый полосатик», обезглавленный пласт, расфасована в упаковку из полимерного материала, масса нетто 25 г, изготовлено и упаковано 11.08.2020, годен до 11.02.2021; большеглазый тунец, филе-соломка, расфасован в упаковку из полимерного материала, масса нетто 70 г, изготовлено и упаковано 01.08.2020, годен до 01.02.2021, изготовитель: АО «Галерея вкусов», Российская Федерация, Тверская область, г. Ржев (импортер в Республику Беларусь: иностранное торговое унитарное предприятие «КДВ БЕЛ», г. Минск) - предписание о прекращении действия документов об оценке соответствия от 23.11.2020 № 06-18-2/1887.
ЕАЭС N RU Д-RU.ФК84.В.00332, ЕАЭС N RU Д-RU.ФК84.В.00350, ЕАЭС N RU Д-RU.ФК84.В.00305, сопровождающая сушено-вяленую рыбную продукцию с маркировкой «Сухогруз»: «Путасу с перцем» (путасу северная, палочки), расфасована в упаковку из полимерного материала, масса нетто 36 г, дата изготовления 24.07.2020, годен до 24.07.2021, ТУ 10.20.23-004-19733136-2017; «Кольца кальмара» (кальмар гигантский, кольца), расфасована в упаковку из полимерного материала, масса нетто 18 г, дата изготовления 24.07.2020, годен до 24.07.2021, ТУ 10.20.32-002-19733136-2017, изготовитель: -ООО «СИФУД ИНДАСТРИЗ», Российская
04.12.2020
Государственное учреждение «Ошмянский районный центр гигиены и эпидемиологии» информирует, что Главным государственным инспектором Республики Беларусь по надзору за соблюдением технических регламентов запрещен ввоз и обращение и прекращены действия документов об оценке соответствия на территории Республики Беларусь пищевой продукции:
Кетчуп томатный 2 категории «Шашлычный», с маркировкой «Нежино» нестерилизованный, масса нетто 900 г, партия 3 БР 8, дата изготовления 29.07.2020, срок годности 6 месяцев, ГОСТ 32063-2013, изготовитель: ООО «Тихвинский уездъ», Российская Федерация, г. Смоленск (поставщик в Республику Беларусь: ИП Присухин Федор Иванович, г. Минск) - не соответствует TP ТС 021/2011, TP ТС 022/2011 по маркировке в части предоставления достоверной информации о составе продукции и отсутствию предупреждающей надписи о наличии красителей, влияющих на активность и внимание детей (предписание о запрете ввоза и обращения опасной продукции от 23.11.2020 № 06-18-1/1879; предписание о прекращении действия документов об оценке соответствия от 23.11.2020 №06-18-2/1880).
Майонез «Московский провансаль», оливковый с массовой долей жира 67%, фасованный в пакеты из полимерного материала с дозатором, объем 200 мл (дата изготовления 12.08.2020, годен до 07.02.2021) и объем 390 мл (дата изготовления 08.08.2020, годен до 03.02.2021), ГОСТ 31761, изготовитель: ОАО «Жировой комбинат», Российская Федерация, г. Екатеринбург (поставщик в Республику Беларусь: ОАО «Ника», г. Витебск) - не соответствует TP ТС 021/2011, TP ТС 024/2011, TP ТС 022/2011, TP ТС 029/2012 по безопасности (предписание о запрете ввоза и обращения опасной продукции от 23.11.2020 № 06-18-1/1881).
Вино виноградное натуральное выдержанное полусладкое красное «RAMPOLDI ROSSO», год урожая 2018, сахар 30-80г/дм3, спирт 11%, дата розлива 11.06.2020, стеклянная бутылка, объем 0,75 л, изготовитель: «BOTTER S.P.A.», Италия, (импортер в Республику Беларусь: ОАО «Продтовары», г. Брест) - не соответствует:TP ТС 021 2011. TP ТС 029/2012 по безопасности (предписание о запрете ввоза и обращения опасной продукции от 23.11.2020 №06-18-1/1889; предписание о прекращении действия документов об оценке соответствия от 23.11.2020 №06-18-2/1890).
Карамель на палочке (с фруктовым вкусом) «САКМАК» («мороженое»), в упаковке из полимерных материалов, масса нетто 20 г, дата изготовления 02.09.2019, годен до 02.09.2021, изготовитель: «SHANTOU RICH FOODS CO., LTD», Китай, филиал завода - изготовителя «САКМАК SEKERLEME», Турция (поставщик в Республику Беларусь: ООО «СТБел Плюс», г. Минск) - не соответствует TP ТС 021/2011, TP ТС 022/2011, TP ТС 029/2012 по безопасности и маркировке (предписание о запрете ввоза и обращения опасной продукции от 23.11.2020 № 06-18-1/1885; предписание о прекращении действия документов об оценке соответствия от 23.11.2020 № 06-18-2/1886).
Универсальная приправа «Летний сезон» торговой марки «Приправыч» масса нетто 60 г, дата изготовления и упаковывания 08.02.2019, срок годности 24 месяца, изготовитель: OA КОМПАНИЯ «ПРОКСИМА», Российская Федерация г. Новосибирск (поставщик в Республику Беларусь: ООО «ЮМАБЕЛ», г. Минск) - не соответствует TP ТС 021/2011 по показателям безопасности - микробиологическим показателям (предписание о прекращении действия документов об оценке соответствия от 23.11.2020 № 06-18-2/1883).
Изделие хлебобулочное сдобное длительного хранения «Фигурный мини КРУАССАН с вишневым джемом», упакованное в картонные коробки, масса нетто 2,0 кг, дата изготовления 12.09.2020, срок годности 30 суток, ТУ 9116-001-96320413-11, изготовитель: общество с ограниченной ответственностью «КОНТЕК», Российская Федерация г. Москва (поставщик в Республику Беларусь: Частное торговое унитарное предприятие «Вкусное дело» Минская область, Минский район, Новодворский сельский совет) - не соответствует TP ТС 021/2011, TP ТС 022/2011, TP ТС 029/2012 по безопасности и маркировке (предписание о прекращении действия документов об оценке соответствия от 23.11.2020 № 06-18-2/1884).
Восточные сладости мучные «Вкусняшка», в картонном коробе, обтянутом полимерной пленкой, весовые, масса нетто 2,0 кг, дата изготовления 08.10.2020, срок годности 30 суток, изготовитель: ООО «Кубанский кондитер», Российская Федерация, Краснодарский край, (импортер в Республику Беларусь: Частное торговое унитарное предприятие «Вкусное дело» Минская область, Минский район, Новодворский сельский совет) - не соответствует TP ТС 021/2011, TP ТС 022/2011, TP ТС 029/2012 по маркировке (предписание о прекращении действия документов об оценке соответствия от 23.11.2020 № 06-18-2/1891).
03.12.2020
По результатам лабораторных испытаний выявлена продукция, несоответствующая санитарно-эпидемиологическим требованиям:
Мясо птицы, тушка цыпленка-бройлера, потрошеная, охлажденная, 1-го сорта

- Дата изготовления 29.10.2020, срок годности до 08.11.2020, номер партии 1272
- Изготовитель: ЗАО «Торговый дом «Серволюкс», Республика Беларусь, г.Могилев, ул.Миронова, 4.
- Не соответствует требованиям TP ТС 021/2011 «О безопасности пищевой продукции», утвержденному Решением Комиссии Таможенного союза от 09.12.2011 № 880, Санитарных норм и правил «Требования к продовольственному сырью и пищевым продуктам», Гигиенического норматива «Показатели безопасности и безвредности для человека продовольственного сырья и пищевых продуктов», утвержденных постановлением Министерства здравоохранения Республики Беларусь от 21 июня 2013 года № 52
В целях обеспечения санитарно-эпидемиологического благополучия населения и недопущения к реализации пищевой продукции, представляющей потенциальную опасность для здоровья людей информируем:
Томатная паста стерилизованная торговой марки «Марика»
- дата изготовления 18.09.2020, срок годности 2 года с даты производства.
- Изготовитель: ООО «Алмалык», Россия, Московская область. Подольский район, д.Матвеевское, ул. Оборонная, 5 (изготовлено по заказу ТД «Авангард»).

- Не соответствует требованиямTP ТС 021/2011 «О безопасности пищевой продукции», утвержденному Решением Комиссии Таможенного союза от 09.12.2011 № 880 (статья 39 главы 6), Санитарных норм и правил «Требования к продовольственному сырью и пищевым продуктам», Гигиенического норматива «Показатели безопасности и безвредности для человека продовольственного сырья и пищевых продуктов», утвержденных постановлением Министерства здравоохранения Республики Беларусь от 21 июня 2013 года № 52 (пункт 66 главы 4). а именно: обнаружены не заявленные в составе пищевой продукции. указанном на потребительской упаковке.
Сельдь атлантическая, соленое филе в масле – филе сельди соленое «Рыба Хит»

- Дата изготовления 17.09.2020, годен до 16.12.2020
- Изготовитель: Совместное Белорусско- Израильское предприятие «Леор Пластик» ООО, Гродненская область, г.Новогрудок, ул. Свердлова 38 а.
- Не соответствует требованиям Санитарных норм и правил «Требования к продовольственному сырью и пищевым продуктам», Гигиенического норматива «Показатели безопасности безвредности для человек продовольственного сырья и пищевых продуктов», утвержденных постановлением Министерства здравоохранения Республики Беларусь от 21 июня 2013 года№ 52 (пункты 9, 10).
Компотная смесь с черносливом (Экстра), 500 г.
- Дата изготовления : 03.2020, упаковано 26.06.2020, срок годности до 01.03.2021
- Изготовитель: ООО «FARM LYTJKS INVEST», Узбекистан, г. Самарканд,ул.Спитамен, Шох,100 Б.
- Не соответствует требованиям технического регламента Таможенного союза TP ТС 021/2011 «О безопасности пищевой продукции», утвержденного Решением Комиссии

- Таможенного союза от 09.12.2011 № 880, Санитарных
норм и правил «Требования к продовольственному сырью и пищевым продуктам», Гигиенического норматива «Показатели безопасности и безвредности для человека продовольственного сырья и пищевых продуктов».
Ботулизм является острой пищевой токсикоинфекцией, развивающейся в результате попадания в организм человека ботулотоксина. Заражение происходит алиментарным путем, наиболее часто при употреблении в пищу содержащих споры ботулизма консервов. Ботулизм характеризуется поражением нервной системы в результате блокирования ботулотоксином ацетилхолиновых рецепторов нервных волокон, проявляется в виде мышечных параличей и парезов. Основная опасность ботулизма состоит в развитии таких осложнений, как острая дыхательная недостаточность и нарушения сердечного ритма. Диагностика ботулизма строится в основном на данных анамнеза заболевания и результатах неврологического осмотра.
Симптомы ботулизма
Инкубационный период ботулизма редко превышает сутки, чаще всего, составляя несколько часов (4-6). Однако иногда может затягиваться до недели и 10 дней. Поэтому наблюдение за всеми людьми, употреблявшими одну пищу с больным, продолжается до 10 суток. В начальном периоде заболевания может отмечаться неспецифическая продромальная симптоматика. В зависимости от преимущественного синдрома различают гастроэнтерологический, глазной варианты, а также - клиническую форму в виде острой дыхательной недостаточности.
Гастроэнтерологический вариант всш1индрома различают гастроэнтерологический, глазной варианты, а также - клиничлEинфекции, с болью в эпигастрии, тошнотой и рвотой, диареей. Выраженность энтеральной симптоматики умеренная, однако, отмечается несоответствующая общей потере жидкости сухость кожи, а также нередко больные жалуются на расстройство проглатывания пищи («ком в горле»).
Начальный период ботулизма, протекающий по глазному варианту, характеризуется расстройствами зрения: затуманивание, мельтешение «мушек», потеря четкости и снижение остроты зрения. Иногда возникает острая дальнозоркость. Самым опасным по течению вариантом начального периода ботулизма является острая дыхательная недостаточность (внезапно развивающаяся и прогрессирующая одышка, распространяющийся цианоз, нарушения сердечного ритма). Она развивается крайне быстро и грозит летальным исходом спустя 3-4 часа.
Клиническая картина ботулизма в разгар заболевания достаточно специфична и характеризуется развитием парезов и параличей различных групп мышц. У больных отмечается симметричная офтальмоплегия (зрачок стабильно расширен, имеет место косоглазие, обычно сходящееся, вертикальный нистагм, опущение века). Дисфагия (расстройство глотания) связана с прогрессирующим парезом мышц глотки. Если первоначально больные испытывают дискомфорт и затруднения глотания твердой пищи, то с развитием заболевания становится невозможным и проглатывание жидкости.
Нарушения речи развивается, проходя последовательно четыре стадии. Сначала изменяется тембр голоса, возникает осиплость в результате недостаточной влажности слизистой голосовых связок. В дальнейшем ввиду пареза мышц языка появляется дизартрия («каша во рту»), голос становится гнусавым (парез мышц небной занавески) и исчезает полностью после развития пареза голосовых связок. В результате расстройства иннервации мышц гортани утрачивается кашлевой толчок. Больные могут задохнуться при попадании в дыхательные пути слизи и жидкости.
Ботулотоксин способствует параличам и парезам мимической мускулатуры, вызывая асимметрию лица. В целом отмечается общая слабость, неустойчивость походки. Ввиду пареза кишечной мускулатуры развиваются запоры. Лихорадка для ботулизма не характерна, в редких случаях возможен субфебрилитет. Состояние сердечной деятельности характеризуется учащением пульса, некоторым повышением периферического артериального давления. Расстройства чувствительности, потеря сознания не характерны.
Лечение ботулизма
При подозрении на ботулизм производится обязательная госпитализация в отделение с возможностью подключения аппарата ИВЛ, с целью предупреждения и своевременной помощи в случае развития опасных для жизни осложнений. Первейшим лечебным мероприятием, производимым в первые сутки заболевания, является промывание желудка при помощи толстого зонда.
Профилактика ботулизма
Профилактические меры против ботулизма подразумевают строгое следование санитарно-гигиеническим нормам при изготовлении консервов, стерилизации посуды для заготовления продуктов длительного хранения. Рыбные и мясные продукты должны консервироваться исключительно в свежем и тщательно очищенном от частиц почвы виде. Консервация перезрелых плодов недопустима. Консервирование в домашних условиях должно осуществляться в строгом соответствии с рецептурой при достаточной концентрации соли и кислоты в открытой для доступа кислорода посуде.
24.11.2020
В целях защиты потребительского рынка от небезопасной и некачественной продукции, санитарно-эпидемиологической службой республики проводятся мероприятия технического (технологического, поверочного) характера по отбору проб и образцов пищевой продукции, находящейся в реализации.
По результатам лабораторных испытаний выявлена продукция, несоответствующая санитарно-эпидемиологическим требованиям:
Рис шлифованный длиннозерный сорт первый «Columb»
- дата изготовления 03.2020, годен до 31.08.2021;
- изготовитель: SONA CEREAL PRODUKTS LTD. 5588, Lahori Gate, Naya Bazar, Delhi-110006, Индия;

- не соответствует требованиям п.7 Санитарных норм и правил «Требования к продовольственному сырью и пищевым продуктам», п.4.1 Гигиенического норматива «Показатели безопасности и безвредности для человека продовольственного сырья и пищевых продуктов», утвержденных постановлением Министерства здравоохранения Республики Беларусь от 21 июня 2013 года № 52, по показателю загрязненности мертвыми вредителями хлебных запасов (составил 6 экз/кг и 13 экз/кг в контрольной пробе.
Желе плодово-ягодное «Персик в желе» пастеризованное «Аппетиссимо

- дата изготовления 24.08.2020, срок годности 90 суток. ш.к.4605290001575;
- изготовитель: ООО «Преображенский молочный комбинат», Россия, г.Москва, Открытое шоссе, д. 15, стр.8;
- не соответствует требованиям TP ТС 021/2011 «О безопасности пищевой продукции», утвержденному Решением Комиссии Таможенного союза от 09.12.2011 № 880, TP ТС 022/2011 «Пищевая продукция в части ее маркировки»,утвержденному Решением Комиссии Таможенного союза от 09.12.2011 № 881 в части маркировки: обнаружена бензойная кислота в количестве 133мг/кг, не указанная на маркировке в составе пищевой продукции.
Десерт глазированный с варёной сгущёнкой «Своя корова» 23%

- дата изготовления 02.10.2020, годен до 01.11.2020;
- изготовитель: ООО «РостАгроКомплекс», Россия, Московская область, Пушкинский район, шоссе Братовщина-Ельдигино, 6 км;
- не соответствует требованиям TP ТС 033/2013 «О безопасности молока и молочной продукции», принятому Решением Совета Евразийской экономической комиссии от 09.10.2013 № 67, TP ТС 021/2011 «О безопасности пищевой продукции», утвержденному Решением Комиссии Таможенного союза от 09.12.2011 № 880, по микробиологическим показателям - превышение допустимых уровней содержания дрожжей (2,2x102КОЕ/г), в 0,01 г обнаружены БГКП.
26.10.2020
За 9 месяцев 2020 года надзорными мероприятиями охвачено 191 объект 128 субъектов хозяйствования, которые занимаются оборотом как пищевой продукции, так и товаров промышленной группы. На 111 объектах установлены нарушения, что составляет 58%, в том числе при реализации импортной продукции (товаров) установлены нарушения на 73 объектах, что составило 38% от выявленных нарушений. Основными нарушениями стали, реализация товаров с истекшим сроком годности на 11 объектах, из них на 4 при обороте
импортной продукции, реализация товаров без документов, подтверждающих качество и безопасность на 8 объектах, на 4 – импортной продукции, реализация товара без маркировки или с неполной маркировкой на 26 объектах, на 11 при обороте импортной, также на 6 объектах установлены факты реализации товаров несоответствующего гигиеническим требованиям, из них на 3 при реализации импортной продукции. Предписаниями главного государственного санитарного врача изъято 257,66 кг продовольственного сырья и пищевой продукции, из них 96,19 кг импортной продукции и 55 единиц товара промышленной импортной продукции.
Выход на объекты субъектов хозяйствования с мероприятиями технического (технологического, поверочного) характера осуществляется только с учетом обоснования причин.
08.10.2020
Главным государственным инспектором Республики Беларусь по надзору за соблюдением технических регламентов запрещен ввоз и обращение и прекращены действия документов об оценке соответствия на территории Республики Беларусь с 20 сентября 2020 г. пищевой продукции:
Рахат-лукум рулет весовой, масса нетто 3,0 кг, дата изготовления 14.04.2020, срок хранения 6 месяцев, изготовитель: ИП Икромов Б.Х. (Российская Федерация, Московская область, г. Химки); поставщик в Республику Беларусь ИП Ядогальвис В.Н. (г. Могилев) - не соответствует TP ТС 021/2011, TP ТС 022/2011, TP ТС 029/2012 по маркировке (предписание о запрете ввоза и обращения опасной продукции от 14.09.2020 № 06-18-1/1518).
Ананасы цукаты, фасованные, масса нетто 1 кг, изготовлено в марте 2020 года, срок годности 12 месяцев, изготовитель: «SHANDONG WEIFANG IMPORT AND EXPORT CO., LTD» (Китай) - не соответствуют TP ТС 021/2011, TP ТС 022/2011 по маркировке (предписание о запрете ввоза и обращения опасной продукции от 14.09.2020 № 06-18-1/1519; предписание о прекращении действия документов об оценке соответствия от 14.09.2020 №06-18-2/1520).
Приправа лимонный перец с маркировкой «Остров специй», масса нетто 20г, дата изготовления 08.2019, срок годности 24 месяца, изготовитель: ООО «ПродЛогистика» (Российская Федерация, г. Москва); импортеры в Республику Беларусь: ООО «ЮМАБЕЛ» (Минский район), ООО «Евроторг» (г. Минск), ЧП «Просперыти» (г. Минск) - не соответствует требованиям TP ТС 021/2011 по микробиологическим показателям (предписание о запрете ввоза и обращения опасной продукции от 14.09.2020 №06-18-1/1522; предписание о прекращении действия документов об оценке соответствия от 14.09.2020 № 06-18-2/1523).
Приправа для жаркого Приправыч®, масса нетто 15г, д&та изготовления 15.01.2019, срок годности 24 месяца, изготовитель: АО КОМПАНИЯ «ПРОКСИМА» (Российская Федерация, г. Новосибирск); импортер в Республику Беларусь: ЧП «ВитГалТорг» - не соответствует требованиям TP ТС 021/2011 по микробиологическим показателям (предписание о запрете ввоза и обращения опасной продукции от 14.09.2020 № 06-18-1/1525; предписание о прекращении действия документов об оценке соответствия от 14.09.2020 № 06-18-2/1526).
Печенье «Чоко-Чоко со вкусом апельсина», весовое, масса нетто 2,0 кг, дата изготовления 05.08.2020, срок годности 20 суток; печенье «Букетик со вкусом творога», весовое, масса нетто 2,0 кг, дата изготовления 11.08.2020, срок годности 15 суток, изготовитель: ООО «Моспекарь-производство» (Российская Федерация, г. Москва); импортер в Республику Беларусь: ИП Родкевич Вадим Александрович (г. Минск) - не соответствуют TP ТС 021/2011, TP ТС 029/2012 по показателям безопасности (предписание о запрете ввоза и обращения опасной продукции от 14.09.2020 № 06-18-1/1527).
Прекращено действие с 20 сентября 2020 г. на территории Республики Беларусь декларации о соответствии:
ЕАЭС № BY/112 11.01.ТР021 107 31562, сопровождающая грецкий орех очищенный, светлый весовой, масса нетто 5 кг, дата изготовления 02.2020, годен до 02.2021, изготовитель: «BULUNGUR GOLD FRUITS», Республика Узбекистан (импортер в Республику Беларусь ООО «Ореховград», г. Минск) (предписание о прекращении действия документов об оценке соответствия от 14.09.2020 № 06-18-2/1521);
ЕАЭС N RU Д-RU.ФК84.В.00058/18, сопровождающая рыбную продукцию холодного копчения «Перуанский кальмар, филе «Кольца», масса нетто 38 г, изготовлено и упаковано 04.07.2020, годен до 04.01.2021, изготовитель: АО «Галерея вкусов» (Российская Федерация, Тверская область, г. Ржев); импортер в Республику Беларусь иностранное унитарное предприятие «КДВ БЕЛ» (г. Минск) (предписание о прекращении действия документов об оценке соответствия от 14.09.2020 № 06-18-2/1524).
02.10.2020
Главным государственным инспектором Республики Беларусь по надзору за соблюдением технических регламентов запрещен ввоз и обращение и прекращены действия документов об оценке соответствия на территории Республики Беларусь с 26 сентября 2020 г. пищевой продукции:
Карамель леденцовая торговой марки «LENCO» - «Кролик» со вкусом клубники, масса нетто 32 г, «Спираль радужная» со вкусом бабл-гам, масса нетто 30 г, «Кисло-шок» со вкусом бразильского лайма масса нетто 15 г, в упаковках из полимерного материала, дата изготовления 15.01.2020, срок хранения 2 года; изготовитель: ООО «Свитпро», Российская Федерация, г. Санкт-Петербург (импортер в Республику Беларусь: ЧП «ЕвроСмокТрейд», г. Витебск) - не соответствует TP ТС 021/2011, TP ТС 022/2011, TP ТС 029/2012, по маркировке и превышению максимального уровня содержания синтетических красителей (предписание о запрете ввоза и обращения опасной продукции от 17.09.2020 № 06-18-1/1539).
Кумкват сушеный весовой, упакован в картонный короб, дата изготовления март 2020 года, срок годности 12 месяцев, изготовитель: ООО «GCF INTERNATIONAL CO., LTD», Таиланд (поставщик в Республику Беларусь: ИП Турок А.И.) - не соответствует TP ТС 021/2011, TP ТС 022/2011 по безопасности и маркировке (предписание о запрете ввоза и обращения опасной продукции от 17.09.2020 № 06-18-1/1540; предписание о прекращении действия документов об оценке соответствия от 17.09.2020 № 06-18-2/1541). 
Печенье «Сэндвич» весовое, масса нетто 2,0 кг, дата изготовления 12.07.2020, срок годности 25 суток, изготовитель: ООО «Солнечная долина», Российская Федерация, Московская область (поставщик в Республику Беларусь: частное предприятие «Содбест», г. Витебск) - не соответствует TP ТС 021/2011, TP ТС 022/2011, TP ТС 029/2012 по безопасности и маркировке (предписание о запрете ввоза и обращения опасной продукции от 17.09.2020 № 06-18-1/1544).
Прекращено действие с 23 сентября 2020 г. на территории Республики Беларусь декларации о соответствии:
ЕАЭС N RU Д-RU.НА88.В.03145/19, сопровождающая фрукты сушеные фасованные чернослив без косточки с товарным знаком «Фермер Сухов», масса нетто 200 г, дата изготовления и упаковывания 27.02.2020, годен до 27.10.2021; абрикос сушеный без косточки фасованный курага с товарным знаком «Фермер Сухов», масса нетто 200 г, дата изготовления 27.02.2020, срок годности 10 месяцев, изготовитель: ООО «Торговая компания «Зард», Российская Федерация, г. Санкт-Петербург (импортер в Республику Беларусь: ОДО «ОРБИУС», г. Минск) (предписание о прекращении действия документов об оценке соответствия от 17.09.2020 № 06-18-2/1538).
ЕАЭС N RU Д-RU.ПТ87.В.09067/20, сопровождающая зефир, ароматизированный «DONI ZEFIRONI», ассорти, дата изготовления 18.06.2020, срок годности 5 месяцев, изготовитель: ООО «Кондитерская фабрика «Нева», Российская Федерация, г. Санкт-Петербург (поставщик в Республику Беларусь: ООО «Сладавита», Минская область, г. Смолевичи) (предписание о прекращении действия документов об оценке соответствия от 17.09.2020 №06-18-2/1542).
ЕАЭС N RU Д-CN.ПТ87.В.01901/19, сопровождающая папайю (цукаты) весовые дата изготовления февраль 2020, срок годности 12 месяцев, изготовитель: «JINAN HAPPY FOREST FOOD CO., LTD», Китай (поставщик в Республику Беларусь: ИП Турок А.И.) (предписание о прекращении действия документов об оценке соответствия от 17.09.2020 № 06-18-2/1542).
ЕАЭС N RU Д-RU.ТР06.В.04666/19, сопровождающая блинчики с вареной сгущенкой торговой марки «Царское подворье», блинчики с творожной начинкой торговой марки «Масленица», дата изготовления 22.06.2020, годен до 19.12.2020, изготовитель: ООО «Морозко», Российская Федерация, Ленинградская область (поставщик в Республику Беларусь: ОДО «Виталюр», Минский район) (предписание о прекращении действия документов об оценке соответствия от 17.09.2020 № 06-18-2/1543).
ЕАЭС N RU Д-RU.АД37.В.00402/19, сопровождающая напиток в фильтр-пакетах «Каркаде, имбирь и пряности», с маркировкой «polezzno®», упакованный в индивидуальную картонную коробку, масса нетто 30 г (20 штук х 1,5г), дата изготовления 22.07.2020, срок годности 24 месяца, изготовитель: ООО «ПОЛЕЗЗНО», Российская Федерация, г. Москва (поставщик в Республику Беларусь: ООО «Ритейл Рокет», г. Минск) (предписание о прекращении действия документов об оценке соответствия от 17.09.2020 № 06-18-2/1545).
02.10.2020

Главным государственным инспектором Республики Беларусь по надзору за соблюдением технических регламентов запрещен ввоз и обращение и прекращены действия документов об оценке соответствия на территории Республики Беларусь с 26 сентября 2020 г. пищевой продукции:
Арахис жареный в хрустящей оболочке со вкусом «Морской коктейль», товарного знака «Chipka», в упаковках из полимерного материала, масса нетто 1 кг, дата изготовления 09.03.2020, годен до 08.11.2020; изготовитель: ООО «Спрут», Российская Федерация, г. Москва (поставщик в Республику Беларусь: ООО «РольфТрейд», г. Могилев) - не соответствует TP ТС 021/2011, TP ТС 022/2011 по маркировке (предписание о запрете ввоза и обращения опасной продукции от 21.09.2020 № 06-18-1/1546; предписание о прекращении действия документов об оценке соответствия от 21.09.2020 № 06-18-2/1547).
Перец красный молотый торговой марки «7 блюд», сушеный весовой, масса нетто 10 г, дата изготовления и упаковывания 05.2020, срок годности 24 месяца; перец черный молотый торговой марки «Остров специй», сушеный весовой, масса нетто 50 г, дата изготовления и упаковывания 02.2020, срок годности 24 месяца; изготовитель: ООО «ПродЛогистика», Российская Федерация, г. Москва (импортеры в Республику Беларусь: ООО «Евроторг», ООО «Юмабел», ЧП «Просперыти», г. Минск) - не соответствуют TP ТС 021/2011 по показателям безопасности.
Прекращено действие с 26 сентября 2020 г. на территории Республики Беларусь декларации о соответствии:
ЕАЭС N RU Д-1Ш.СП28.В.06738/19, сопровождающая печенье песочное «Улетайка» с начинкой в кокосовой стружке весовое, масса нетто 2,0 кг, дата изготовления 16.08.2020, срок годности 30 суток, изготовитель: ООО «Компания «Реал», Российская Федерация, г. Санкт-Петербург (поставщик в Республику Беларусь: ИП Иванов С.А., г.Могилев).
01.10.2020
С целью проведения информационно-консультационных мероприятий по разъяснению норм действующего законодательства, в том числе Декрета Президента Республики Беларусь от 23 ноября 2017 г. № 7 «О развитии предпринимательства», 17 сентября 2020 года с 14.00 до 16.00 в г.Ошмяны, по ул.Советской,89 («Дом культуры») будет проводиться мероприятие «Открытая приемная для бизнеса» для представителей бизнеса (далее - мероприятие). В рамках планируемого мероприятия в формате «тет-а-тет» всем заинтересованным будет предоставлена возможность получить индивидуальную консультацию у специалистов служб и ведомств области по вопросам, относящимся к их компетенции.
В указанном мероприятии будет участвовать член рабочей группы Гродненского областного исполнительного комитета по разъяснению норм Декрета Президента Республики Беларусь от 23 ноября 2017 г. № 7 «О развитии предпринимательства» врач-гигиенист высшей квалификационной категории, заведующий отделением гигиены питания Гродненского областного центра гигиены, эпидемиологии и общественного здоровья Руфкина М.М.
16.09.2020

Постановлением Заместителя Главного государственного санитарного врача Республики Беларусь «О прекращении действия свидетельства о государственной регистрации» от 14.08.2020 № 18-01/1023 прекращено действие свидетельства о государственной регистрации от 30.04.2020 BY.70.06.01.001.R.001587.04.20 на продукцию: Всесезонный энзимный пилинг серии «Pure Balance» товарного знака «MASSTIGE», ГОСТ 31695-2012, изготовитель: ООО «Рекиш Косметикс», Республика Беларусь, адрес: 223036, Минская область, Минский район, г. Заславль, ул. Замковая, д. 2а (по заказу ООО «МАСТИЖ ГРУПП», УНП 691844424, Республика Беларусь, Минская область, Минский район, д. Боровляны, ул. 40 лет Победы, д. 23а, пом. 54) в связи с прекращением изготовления продукции.
27.08.2020

Постановлением Заместителя Главного государственного санитарного врача Республики Беларусь «О прекращении действия свидетельства о государственной регистрации» от 14.08.2020 № 18-01/1122 прекращено действие свидетельства о государственной регистрации от 02.07.2014 BY.70.06.01.007.Е.003614.07.14 на специализированную пищевую продукцию для диетического профилактического питания: «Гематоген кокосовый» (в составе ароматизатор ванилин), плитка 40г и 50г, TУ BY 200433278.020-2013, изм.№1, РЦ BY 200433278.053-2013, изготовитель ОАО «Экзон», Республика Беларусь, адрес: Брестская область, г. Дрогичин, ул. Ленина, 202 в связи с прекращением изготовления и обращения продукции.
27.08.2020
В целях защиты потребительского рынка от небезопасной и некачественной продукции, санитарно-эпидемиологической службой республики проводятся мероприятия технического (технологического, поверочного) характера по отбору проб и образцов пищевой продукции, находящейся в реализации.
По результатам лабораторных испытаний выявлена продукция, несоответствующая санитарно-эпидемиологическим требованиям:
Смесь из сухофруктов (компотная смесь) 1 сорт
- дата изготовления 25.03.2020, дата упаковывания 25.03.2020, срок годности 12 месяцев с даты изготовления;
- изготовитель: ООО «ChelakTomorgaXizmati» 141500, Республика Узбекистан, Самаркандская область, Паярикский район, Бунёдкор МФЙ, ул.Зарбдор-7;
- не соответствует требованиям санитарных норм и правил «Требования к продовольственному сырью и пищевым продуктам», ГН «Показатели безопасности и безвредности для человека продовольственного сырья и пищевых продуктов», утвержденных постановлением Министерства здравоохранения Республики Беларусь от 21.06.2013 №52, TP ТС 021/2011 «О безопасности пищевой продукции», утвержденному Решением комиссии Таможенного союза от 09 декабря 2011 г. № 880 по органолептическим показателям:имеются плоды и ягоды, поврежденные вредителями хлебных запасов, подгорелые, обнаружены минеральные посторонние примеси.

Дыня свежая
- урожай 2020 года, дата упаковывания 24.07.2020; срок годности от даты упаковывания: при температуре воздуха от +3 до +60С - 3 месяца; срок годности при температуре воздуха +18± 5°С - 15 дней;
- изготовитель: ТОО «Федерация Футбола Сарыагашского района» (адрес: ул. Майлыкожа, 160900 г.Сарыагаш, Южно-Казахстанская область, Казахстан);
- не соответствует требованиям ТР ТС 021/2011«О безопасности пищевой продукции», утвержденному Решением комиссии Таможенного союза от 09 декабря 2011 г. № 880 (статья 7 п.1, п.2; п.6 приложения3) по содержанию нитратов – фактическое значение 116 мг/кг, при нормированном значении не более 90 мг/кг

19.08.2020
В целях защиты потребительского рынка от небезопасной и некачественной продукции, санитарно-эпидемиологической службой республики проводятся мероприятия технического (технологического, поверочного) характера по отбору проб и образцов пищевой продукции, находящейся в реализации.
По результатам лабораторных испытаний выявлена продукция, несоответствующая санитарно-эпидемиологическим требованиям:
Виноград сушеный желтый Golden 2 сорт сабза
-
штриховой код 4813991000128, в полиэтиленовой потребительской упаковке массой 0,5 кг;
-
дата изготовления 19.12.2019, срок годности 12 месяцев с даты изготовления;
-
изготовитель: ООО «ChelakTomorgaXizmati» 141500, Республика Узбекистан, Самаркандская область, Паярикский район, Бунёдкор МФЙ, ул.Зарбдор-7;
-
не соответствует требованиям санитарных норм и правил «Требования к продовольственному сырью и пищевым продуктам», ГН «Показатели безопасности и безвредности для человека продовольственного сырья и пищевых продуктов», утвержденных постановлением Министерства здравоохранения Республики Беларусь от 21.06.2013 №52, TP ТС 021/2011 «О безопасности пищевой продукции», утвержденному Решением комиссии Таможенного союза от 09 декабря 2011 г. № 880 по микробиологическому показателям: дрожжи сплошной рост при норме 5*102 КОЕ/г, плесени сплошной рост при норме 5*102 КОЕ/г
Смесь из сухофруктов (компотная смесь) 1 сорт

-
штриховой код 4813991000135;
-
дата изготовления 23.04.2020, срок годности 12 месяцев с даты изготовления;
-
изготовитель: ООО «ChelakTomorgaXizmati» 141500, Республика Узбекистан, Самаркандская область, Паярикский район, Бунёдкор МФЙ, ул.Зарбдор-7;
-
не соответствует требованиям санитарных норм и правил «Требования к продовольственному сырью и пищевым продуктам», ГН «Показатели безопасности и безвредности для человека продовольственного сырья и пищевых продуктов», утвержденных постановлением Министерства здравоохранения Республики Беларусь от 21.06.2013 №52, TP ТС 021/2011 «О безопасности пищевой продукции», утвержденному Решением комиссии Таможенного союза от 09 декабря 2011 г. № 880 по микробиологическому показателям: фактический показатель дрожжи 3,7*103 КОЕ/г при допустимом количестве 5*102 КОЕ/г, плесени - 3,0*103 КОЕ/г, при допустимом количестве не более 5*102 КОЕ/г
Дыня свежая

-
урожай 2020 года, срок годности с даты упаковывания 30 суток;
-
изготовитель: Товарищество с ограниченной ответственностью «АгроФрутАльянс », ул. Майлыкожа, д. 93,160900 г. Сарыагаш, Сарыагашский район, Туркестанская область, Казахстан;
-
не соответствует требованиям ТР ТС 021/2011«О безопасности пищевой продукции», утвержденному Решением комиссии Таможенного союза от 09 декабря 2011 г. № 880 (сатья 7 п.1, п.2; п.6 приложения3) по содержанию нитратов – фактическое значение 231 ± 50 мг/кг, при нормированном значении не более 90 мг/кг
17.08.2020
В целях защиты потребительского рынка от небезопасной и некачественной продукции, санитарно-эпидемиологической службой республики проводятся мероприятия технического (технологического, поверочного) характера по отбору проб и образцов непродовольственной группы товаров, находящейся в реализации.
По результатам лабораторных испытаний выявлена продукция, несоответствующая санитарно-эпидемиологическим требованиям:
Салфетки бумажные, двухслойные, тисненые (оранжевые, желтые)

-
ТУ BY 290744482.001-2009, размер 330х330 мм, номинальное количество – 20 штук в упаковке;
-
состав: 100% целлюлоза;
-
дата изготовления – февраль 2019, срок годности не ограничен;
-
изготовитель: ЧТПУП «Сто процентов», УНП 290744482 (адрес: 225306, Брестская область, Кобринский район, Киселевецкий с/с 28В, юго-восточнее д.Борисово);
-
не соответствуют Единым санитарно-эпидемиологическим и гигиеническим требованиям к продукции (товарам), подлежащей санитарно-эпидемиологическому надзору (контролю), утвержденным Решением Комиссии Таможенного союза от 28.05.2010 №299, глава II, раздел 12 по органолептическим показателям: водная вытяжка–окрашена в желтый цвет; при нормированном значении - прозрачная жидкость без мути, осадка и окраски
Игрушка жвачка для рук, для детей от 5 лет

-
apT.BR-6450, штриховой код 2006311708138;
-
дата изготовления 07.2018 год;
-
изготовитель: «XIAMEN YUKEXIANG TRADE CO., LIMITED)), Шидай Билдинг Б-1102 Иу, Китай, импортер в РБ: ООО «ЮниПрессМаркет», 22034, г.Минск, ул.Платонова, 1Б, пом.20;
-
не соответствует требованиям TP ТС 008/2011 «О безопасности игрушек»,утвержденного Решением Комиссии Таможенного союза от 23.09.2011 №798, Санитарных норм и правил «Требования к производству и реализации отдельных видов продукции для детей», Гигиеническому нормативу «Показатели безопасности отдельных видов продукции для детей», утвержденного постановлением Министерства здравоохранения Республики Беларусь от 20.12.2012 №200, по миграции в водную среду формальдегида -фактическое значение составило 3,91 мг/дм3, при нормируемом - не более 0,1 мг/дм3
30.07.2020
Санитарно-эпидемиологической службой осуществляется надзор за выполнением на торговых объектах санитарно-противоэпидемических мероприятий, направленных на предупреждение распространения инфекции COVID-19.
Так, за период с 01.07.2020 по 24.07.2020 по профилактике коронавирусной инфекции проведены обследования 33 объектов, из них 2 торговые объекта, расположенные на рынках, 6 объектов общественного питания, 7 торговых объекта расположенный на АЗС.
На 17 объектах (51,5%) объектах не выполнялись в полном объеме санитарно-противоэпидемические мероприятия.
Основными нарушениями стали:
не проведение влажной уборки помещений, торгового, холодильного оборудования с использованием средств дезинфекции

отсутствие локтевых (бесконтактных) дозаторов с антисептиками в общедоступных;

не проведение протирания ячеек для хранения личных вещей покупателей, не проведение протирания покупательских корзин

не использование работниками, имеющими непосредственный контакт средств индивидуальной защиты органов дыхания (маски);
содержание и эксплуатация оборудования не соответствует инструкции

хранение и реализация пищевой продукции, осуществляется в условиях, не в полной мере обеспечивающих ее защиту от загрязняющих веществ
Уважаемые субъекты хозяйствования!!!!
Для минимизации распространения инфекции COVID-19, выполняйте рекомендации санитарно-эпидемиологической службы!
29.07.2020
В целях защиты потребительского рынка от небезопасной и некачественной продукции, санитарно-эпидемиологической службой республики проводятся мероприятия технического (технологического, поверочного) характера по отбору проб и образцов пищевой продукции, находящейся в реализации.
По результатам лабораторных испытаний выявлена продукция, несоответствующая санитарно-эпидемиологическим требованиям:
Бисквит «Фирменный» коктейль малина со сливками
• штриховой код 4820002304014, в упаковке массой 0,33кг;
• дата изготовления 20.03.2020, годен до 20.12.2020;
• изготовитель: ЧАО «Харьковская бисквитная фабрика» (адрес: ул. Лозовская, 8, 610017 г. Харьков, Украина);
• не соответствует требованиям TP ТС 021/2011 «О безопасности пищевой продукции», утвержденному Решением комиссии Таможенного союза от 09 декабря 2011 г. № 880 по микробиологическому показателю КМАФАнМ фактическое значение 2,0*104 КОЕ/г, при нормируемом значении не более 1*104 КОЕ/г
Чай черный байховый цейлонский ТЕСС САНРАЙЗ крупнолистовой

• ТУ 9191-001-39420178-97, штриховой код 4605246005879;
• дата изготовления 04.20209, срок годности 03.2023;
• изготовитель: ООО «ОРИМИ», 188682, Россия, Ленинградская область, Всеволожский район, пос. им. Свердлова, 1 мкр., участок 15/4;
• не соответствует требованиям ТР ТС 021/2011«О безопасности пищевой продукции», утвержденному Решением комиссии Таможенного союза от 09 декабря 2011 г. № 880 по микробиологическому показателю «плесени»: фактическое значение 1х105КОЕ/г, при нормируемом значении не более 1х103 КОЕ/г.
Вафли неглазированные с жировыми начинками с шоколадным кремом «Ретро-Сладонеж»

• штриховой код 4650062771453, в упаковке массой 0,3кг;
• дата изготовления 16.02.2020, годен до 16.10.2020;
• изготовитель: «Сладонеж», Россия, адрес: 644105, г. Омск, ул. 22 Партсъезда, д. 51;
• не соответствует требованиям ТР ТС 021/2011«О безопасности пищевой продукции», утвержденному Решением комиссии Таможенного союза от 09 декабря 2011 г. № 880 по микробиологическому показателю (КМАФАнМ – фактическое значение 2,1*104 КОЕ/г, при нормированном значении не более 5*10³ КОЕ/г)
28.07.2020
За май текущего года специалистами Ошмянского районного ЦГЭ по профилактике инфекции COVID-19 проведены обследования 91 объект надзора, из них 76 объектов торговли, 7 объектов общественного питания, 4 торговых места на рынке, 7 пунктов питания и торговли, расположенных: на АЗС.
Основными нарушениями стали:
- отсутствие бесконтактных (локтевых) дозаторов с антисептиками в общедоступных местах;
- отсутствие разметки для соблюдения дистанции между покупателями;
- не использование работниками, имеющими непосредственный контакт с посетителями, средств индивидуальной защиты органов дыхания (масок);
- осуществление реализации неупакованной пищевой продукции (кондитерских изделий);
- отсутствие запаса средств дезинфекции;
- отсутствие информации для посетителей о порядке проведения обработки рук антисептиком.
01.06.2020
В необходимости перекуса нет ничего ужасного. Единственное, что не желательно делать во время перекусов, это употреблять жирную и сладкую пищу, например: фастфуд, сдобную выпечку, чипсы или соленые сухарики. Но если отнестись к перекусыванию правильно, то тогда этот процесс будет положительно отражаться на здоровье.
Здоровый перекус — это продукты с высоким содержанием белка и сложных углеводов. Калорийность их относительно невысока, тем не менее они дают долговременную энергетическую подпитку, улучшают пищеварение, способствуют росту мышечной ткани. К таким продуктам можно отнести:
- фитнес-батончики, как их часто называют, бывают двух типов: одни состоят из злаковых хлопьев (иногда с добавлением сушеных ягод, сухофруктов, орехов или черного шоколада), основа других — фрукты и орехи. Фруктово-ореховые батончики — оптимальный выбор для проголодавшихся офисных работников, но особенно они рекомендованы тем, кто испытывает физические нагрузки, — спортсменам, постоянным посетителям фитнес-клубов, людям, работающим на свежем воздухе.
- мюсли - хороший здоровый перекус. В натуральных мюсли много клетчатки, улучшающей работу кишечника, они прекрасно насыщают и содержат витамины. Однако не путайте мюсли с кукурузными хлопьями — это разные продукты, и хлопья далеко не так полезны, поскольку зачастую содержат много растительных масел и сахара.
- орехи - это настоящий суперфуд. Практически все разновидности орехов содержат высокую дозу витаминов Е и В3, много калия, фосфора и магния, они улучшают память, способность к концентрации внимания и работоспособность. Кроме того, орехи понижают уровень холестерина, снижают риск инфаркта.
- фрукты, ягоды. Конечно, все фрукты и ягоды полезны, богаты клетчаткой, витаминами и минералами. Однако в некоторых из них, например, в винограде, бананах, инжире, манго, хурме и вишне, очень много сахара. Если вы следите за фигурой, увлекаться ими не стоит. Обратите внимание на фрукты с низким содержанием сахара: грейпфруты, арбуз, клубнику, клюкву. Яблоки, которые давно стали символом диетического питания, также спорный продукт: в них много витаминов, они богаты железом и клетчаткой, но при этом обладают свойством усиливать аппетит.
- овощи. Стебли сельдерея или овощной салат — практически оптимальный здоровый перекус. В овощах, как сырых, так и термически обработанных, много клетчатки, витаминов и антиоксидантов, они продлевают молодость, помогают сохранить фигуру и улучшают общее состояние здоровья. К самым полезным овощам — то есть тем, в которых высокое содержание витаминов сочетается с низкой калорийностью — относятся брокколи, редис, морковь, баклажаны, сладкий перец, капуста, сельдерей. Если вам скучно есть овощной салат, заранее запеките овощи на гриле (перец, кабачки, баклажаны, морковь, свекла, тыква, помидоры подходят для этого очень хорошо) и сделайте вегетарианский сэндвич на цельнозерновом хлебе.
- цельнозерновые хлебцы. Их изготавливают не из муки, а из размоченных, измельченных и спрессованных злаков. Это тяжелый, слегка влажный хлеб с грубой текстурой. В нем огромное количество клетчатки, он улучшает обменные процессы и состояние сосудов, понижает уровень холестерина, содержит витамины группы В, необходимые, в частности, для работы нервной системы. Но не заблуждайтесь, это не диетический продукт: 100 граммов такого хлеба содержат 300–350 калорий, а если в хлеб добавлены орехи, семечки и сухофрукты, то и больше. Однако он все равно полезнее белого хлеба и выпечки, так как содержит больше витаминов и клетчатки.
- кисломолочные продукты: натуральный йогурт, кефир, ряженка и прочие кисломолочные продукты — это приятный легкий перекус. Бонус — высокое содержание кальция, строительного материала зубов и костей. Лактобактерии, которые содержатся в «живом» кефире, помогают поддерживать нормальную микрофлору кишечника, но рассчитывать только на них в борьбе с диагностированным дисбактериозом не стоит. Все-таки кефир — это еда, а не лекарство.
- хлопья. Кукурузные хлопья и каши быстрого приготовления могут быть полезным перекусом — или довольно вредным. Сами по себе эти продукты вполне соответствуют принципам здорового питания, в них есть и клетчатка, и витамины — в основном А, Е и В6, а также цинк, магний и железо. Но ради улучшения вкуса производители зачастую добавляют в них огромное количество сахара (например, в виде глазури), а также разнообразные ароматизаторы, красители и консерванты. Порция таких хлопьев нередко содержит столько же калорий, сколько и кремовое пирожное — около 500. Так что для легкого перекуса нужно выбирать хлопья и каши без добавок. Если хотите, добавьте в них ложку меда.
- смузи. Немногие любят грызть сырую морковь, а вот в виде пюре она идет гораздо лучше. В сущности, и детское питание — это те же смузи. Смузи — хороший вариант для тех, кто не особенно любит овощные и фруктовые салаты: он позволяет ввести в рацион такие продукты, какие мало кто стал бы есть просто так, например, свеклу или сельдерей. Главное — не добавляйте в смузи сиропы, сладкий йогурт или мороженое. А также не забывайте о том, что нашим зубам и деснам для здоровья требуется постоянная нагрузка, которая отсутствует, если питаться жидкостями постоянно.
- чашка цикория с долькой шоколада. Жареный молотый цикорий очень похож на кофе. Однако у этого напитка есть масса преимуществ: он не содержит кофеин и не повышает давление. Любители кофе нередко испытывают проблемы с давлением, передозировка кофе (да, такое вполне возможно) часто приводит к тошноте, перепадам настроения, тремору, снижению когнитивных функций и бессоннице. Если без кофе жизнь вам не мила, пейте бодрящий напиток с утра, а после обеда заменяйте его цикорием. Чашка цикория и маленький кусочек темного шоколада — это доза антиоксидантов, минералов и витаминов. А еще цикорий содержит инулин — вещество, помогающее лучше усваивать кальций, поддерживать здоровую кишечную микрофлору и нормальный вес.
17.02.2020
Горький шоколад несомненно приносит пользу для организма, но его переедание может привести к нежелательным последствиям.
- антиоксидант, имеет способность улучшать усвоение сахара в организме. Повышенное содержание антиокислителей – флавоноидов улучшает кровообращение, препятствуя образованию тромбов. Эти вещества эффективно нейтрализуют свободные радикалы, очищая организм и защищая его от возможных заболеваний.
- снижает выработку кортизола – гормона стресса. Он заметно улучшает настроение и повышает общий тонус. Это просто эликсир радости для организма. Кроме этого он еще и повышает иммунитет.
- снижает уровень реактивного белка и стопорит его, тем самым не давая распространяться воспалительным процессам в организме. Так что при любых заболеваниях, которые имеют воспалительный характер, шоколад будет как нельзя полезен. Регулярное употребление шоколада послужит профилактикой многих вирусных и простудных болезней.
- содержит танины, которые отлично уничтожают бактерии. Благодаря им шоколад предотвращает образование зубного налета и устраняет неприятный запах изо рта. Фтор, кальций и фосфор, которые тоже содержатся в продукте, укрепляют зубы, ногти и костную ткань.
- полезен для здоровья сердечно-сосудистой системы. Его стеариновая кислота чистит сосуды, а фенолы не дают им сужаться. Такое воздействие шоколада на организм предотвращает развитие инсультов, инфарктов и многих других сердечно-сосудистых заболеваний. Продукт также заметно повышает умственную активность и улучшает память.
- полезен для женского организма при разумном употреблении (примерно 25 граммов в день) - избавит от ПМС, улучшит состояние кожи, волос, ногтей и зубов, взбодрит и улучшит настроение.
- афродизиак для мужчин. Он улучшает не только настроение, но и мужскую потенцию. Полезные свойства шоколада делают мужчин бодрыми, сильными и уверенными в себе, а также улучшают работу сердца и сосудов головного мозга. Однако мужчинам тоже стоит опасаться калорийного продукта и не переусердствовать с количеством съеденного, чтобы не увеличить свой вес.
17.02.2020
На основании Закона о Республики Беларусь от 07 января 2012 №340-З «О санитарно-эпидемиологическом благополучии населения», Указа Президента Республики Беларусь от 16 октября 2009 года №510 «О совершенствовании контрольной (надзорной) деятельности в Республике Беларусь» санитарно-эпидемиологической службой района осуществляется мониторинг за предприятиями, осуществляющими производство молока.
Результаты надзорных мероприятий показали, что в сельскохозяйственных организациях не принимаются исчерпывающие меры по приведению в надлежащее состояние сельскохозяйственных объектов, также отсутствует действенная система производственного контроля, что является основной причиной несоблюдения санитарно-эпидемиологических требований на МТФ и МТК. Основными нарушениями по-прежнему являются:
- не содержание в чистоте доильных установок;
- отсутствие условий для соблюдения правил личной гигиены: умывальные раковины не оснащены жидким мылом, антисептиком для обработки рук, одноразовыми полотенцами;
- недостаточное количество промаркированного уборочного инвентаря для уборки производственных и санитарно-бытовых помещений;
- не содержание прилегающей территории в чистоте;
- неудовлетворительное санитарное состояние производственных и санитарно-бытовых помещений;
- наличие плесени на потолке/стенах;
- наличие дефектов поверхностей пола и стен;
- несвоевременное проведение ремонтов молочных блоков, доильных залов, санитарно-бытовых помещений;
- не содержались в чистоте и исправном состоянии осветительные; приборы
- недостаточное количество уборочного инвентаря, не выделено отдельное хранения уборочного инвентаря.
11.02.2020
В течении 2019 года приоритетной направленностью работы санитарно-эпидемиологической службы района являлась профилактика правонарушений, а не только привлечение к ответственности за совершенные субъектами хозяйствования нарушений. Специалистами Ошмянского районного ЦГЭ надзорными мероприятиями в течении 2019 года были охвачены все субъекты хозяйствования – 80 субъектов, на 76 установлены нарушения санитарно-эпидемиологического законодательства, что составило 95%.
Самый высокий удельный вес выявляемых на торговых объектах нарушений имели реализация (предложение к реализации) продукции с истекшим сроком годности (29 случаев), без наличия маркировки (18 случаев). Помимо указанных нарушений устанавливались случаи реализации пищевой продукции с признаками недоброкачественности, порчи, обращения товара без документов, обеспечивающих прослеживаемость и подтверждающих качество и безопасность.
Кроме реализации недоброкачественного продовольственного сырья и пищевых продуктов участились факты не содержания в чистоте помещений объектов, неудовлетворительное состояние торгового, технологического, холодильного оборудования – 23 случая.
По результатам профилактических и надзорных мероприятий за 2019 год:
составлено 9 протоколов об административном правонарушении на юридических лиц и 14 протокол на физических лиц;
направлено 106 рекомендаций об устранении нарушений в адрес субъектов хозяйствования и 15 предписаний по устранению нарушений;
вынесено 58 предписаний о приостановлении (запрете) реализации товаров общим весом 221,326 кг и объемом 15,467 л.
Данные нарушения свидетельствуют об отсутствии на торговых объектах должного уровня производственного контроля за исполнением установленных требований, как со стороны работников, так и со стороны администрации.
В целях наведения порядка на торговых объектах и выполнения санитарно-эпидемиологического законодательства специалистами Ошмянского районного ЦГЭ будет продолжена работа по выявлению нарушений требований санитарного законодательства и принятия мер по их устранению.
10.02.2020
В связи с установившейся жаркой погодой в целях обеспечения санитарно-эпидемиологического благополучия населения при реализации пищевой продукции субъектам хозяйствования необходимо уделить особое внимание:
- бесперебойному обеспечению объектов проточной холодной и горячей водой, исправной работе канализационных систем;
- содержанию и эксплуатации холодильного и торгово-технологического оборудования в соответствии с инструкцией по его эксплуатации (руководству, паспорту изготовителя оборудования), соответствию мощности холодильного оборудования объему продовольственного сырья и пищевых продуктов;
- соблюдению температурных условий хранения, сроков годности, товарного соседства реализуемой пищевой продукции;
- соблюдению требований к производству (технологии приготовления пищи), последовательности и поточности технологического процесса;
- соблюдению санитарно-эпидемиологических требований на этапах транспортировки пищевых про выполнение внутренней поверхности грузовых отделений транспортных средств и контейнеров материалами, предназначенными для контакта с пищевой продукцией и обеспечивающими возможность проведения очистки и мойки, содержание грузовых отделений в чистоте;
- наличию условий для транспортировки пищевой продукции исключающей контакт сырой и готовой к употреблению пищевой продукции, загрязнения ее при погрузке и выгрузке из транспортного средства;
- соблюдению условий хранения перевозимой пищевой продукции;
- соблюдению требований к санитарному содержанию помещений, мытью и обработке оборудования, инвентаря и посуды, своевременной замене губок, мочалок и иного инвентаря для мытья столовой посуды;
- обеспечению чистой сухой столовой посуды, приборами и инвентарем для раздачи блюд;
- использованию одноразовых перчаток для приготовления холодных закусок и салатов, порционирования готовых блюд;
- обеспечению условий и соблюдению персоналом правил личной гигиены;
- наличию документов, удостоверяющих качество и безопасность поступающих и реализуемых продовольственного сырья и пищевых продуктов.
13.06.2019
В связи с подготовкой к проведению II Европейских игр 2019 года в республике Беларусь и в целях пресечения нарушений требований санитарно-эпидемиологического законодательства специалистами Ошмянского районного ЦГЭ усилен надзор за объектами придорожного сервиса и площадками для отдыха у дорог международного значения.
Так, по состоянию на 20.05.2019 неоднократно посещены все объекты, в том числе и при участии специалистов отделов экономики, спорта и туризма Ошмянского районного исполнительного комитета. По результатам надзорных мероприятий факты неудовлетворительного санитарного состояния устанавливались на 2 объектах придорожного сервиса и 4 площадках для отдыха, реализации пищевой продукции без документов, подтверждающих качество и безопасность на 4 объектах, предложения к реализации пищевой продукции с истекшим сроком годности на 1 объекте.
По фактам выявленных нарушений направлено 29 рекомендаций об устранении нарушений, 2 предложения о приостановлении деятельности, вынесено 4 предписания об изъятии из обращения небезопасной продукции общим весом 3,852 кг, к административной ответственности привлечено 2 виновных и 1 юридическое лицо.
Надзор за содержанием объектов придорожного сервиса будет продолжен.
21.05.2019
Ежегодно 15 марта в Республике Беларусь на государственном уровне отмечается День потребителя. В 2019 году Всемирный день прав потребителей пройдет под девизом «Защита потребителей в эпоху умных технологий».
Впервые всемирный День защиты прав потребителей отметили 15 марта 1983 года – через двадцать два года после исторической речи президента США Джона Ф.Кеннеди, в которой он провозгласил четыре основных права потребителей – на безопасность, на информацию, на выбор и право быть услышанным. Позднее к этим базовым правам были добавлены еще четыре: право на возмещение ущерба, на потребительское образование, на удовлетворение базовых потребностей и право на здоровую окружающую среду.
9 января 2002 года был принят Закон Республики Беларусь «О защите прав потребителей». В соответствии с настоящим Законом любой потребитель имеет право на просвещение в области защиты прав потребителей; информацию о товарах (работах, услугах), а также об их изготовителях (исполнителях, продавцах); безопасность товаров (работ, услуг); свободный выбор товаров (работ, услуг); надлежащее качество товаров (работ, услуг); возмещение в полном объеме убытков (вреда), причиненных вследствие недостатков товара (работы, услуги); государственную защиту своих прав; общественную защиту своих прав; обращение в суд и другие уполномоченные государственные органы за защитой нарушенных прав или интересов.
Что нужно знать при приобретении пищевой продукции в магазине?
В обязательном порядке должна быть указана информация о:
- наименовании пищевой продукции;
- дате изготовления и сроке годности пищевой продукции;
- условия хранения пищевой продукции;
Иные сведения доводятся до потребителя любым способом, обеспечивающим возможность обоснованного выбора этой пищевой продукции (в том числе путем нанесения на потребительскую упаковку и (или) этикетку, и (или) на листок-вкладыш, помещенный в каждую упаковочную единицу или прилагаемый к каждой упаковочной единице продукции).
Информация для потребителя указывается на русском языке или белорусском языках, должна быть однозначно понимаемой, полной и достоверной, чтобы потребитель не мог быть обманут или введен в заблуждение.
20.03.2019
С целью не допущения в оборот недоброкачественной пищевой продукции и профилактики нарушений требований санитарно-эпидемиологического законодательства специалистами Ошмянского районного центра гигиены и эпидемиологии проводятся надзорные мероприятия за торговыми объектами, объектами общественного питания и придорожного сервиса.
За январь-февраль 2019 года надзорными мероприятиями охвачено 36 объектов, нарушения требований санитарных норм и правил устанавливались в 75% случаев.
Так, основными нарушениями являлись: реализация пищевой продукции с истекшим сроком годности (29,6% от всех выявленных), реализация пищевой продукции без наличия маркировки (7,4% от всех выявленных), реализация и хранение пищевой продукции в отсутствие необходимых температурных условий (7,4 % от всех выявленных), неудовлетворительное санитарное состояние холодильного оборудования (3,7 % от всех выявленных).
В адрес руководителей субъектов хозяйствования направлено 22 рекомендаций об устранении нарушений, вынесено 3 предписаний по причине реализации продуктов питания в отсутствии необходимых температурных условий. При выявлении недоброкачественной пищевой продукции вынесено 10 предписаний о приостановлении (запрещении) реализации товаров общим весом 29,168 кг.
По фактам выявленных нарушений к административной ответственности привлечены 1 индивидуальный предприниматель и 1 юридическое лицо, к дисциплинарной ответственности – 2 физических лица.
В целях защиты себя и своих близких от недоброкачественной продукции обращайте внимание на внешний вид, сроки годности и условия реализации пищевой продукции!
01.03.2019
В целях обеспечения санитарно-эпидемиологического благополучия населения, создания комфортных условий гражданам за 11 месяцев 2018 году в ходе мониторингов охвачено 100% объектов придорожного сервиса Ошмянского района. Нарушения требований санитарных норм и правил установлено на 100% объектов.
Основными нарушениями являлись: обращение продукции с истекшим сроком годности; нарушение температурного режима и условий хранения; неудовлетворительное содержание территорий объектов.
По фактам выявленных нарушений в адрес руководителей субъектов хозяйствования субъектам хозяйствования направлено 12 рекомендаций об устранении нарушений, 1 предписание о приостановлении (запрете) производства и (или) реализации работ, услуг; 1 предписание о приостановлении (запрещении) реализации товаров.
06.12.2018
Взглянув на этикетку любого продукта, зачастую мы можем увидеть длинный перечень дополнительных ингредиентов, которые, в общем-то, и не собирались покупать. Порой трудно поверить, что розовое или фисташкового цвета мороженое – натуральный продукт, ведь не могут же молоко или сливки, из которых его сделали, быть розовыми или зелеными. Нетрудно догадаться, что в состав продукта для придания ему окраски было добавлено нечто специальное.
Пищевые добавки — это природные или искусственные вещества, которые добавляют в продукты с целью придать последним определенные свойства и сохранить их качества.
Все пищевые добавки разделены на 23 функциональных класса по технологическому назначению. Число пищевых добавок, разрешенных к применению в нашей стране – 399. Запрещенными в Республике Беларусь пищевыми добавками являются: Е103, Е106, Е111, Е121, Е123, Е126, Е 130, Е181, Е216, Е217, Е240, Е924, Е924а.
Буквенные коды «Е» (первая буква в слове «Europe») – это система кодификации, разработанная в Европе. Пищевые добавки часто встречаются под торговыми или длинными, трудно произносимыми химическими наименованиями. Надпись типа Е101 выглядит одинаково на всех языках и информирует о составе продукта. Да и уместить ее на маленькой этикетке гораздо проще. Такой код – своего рода печать одобрения. Раз он есть, значит, данная добавка входит в перечень официально разрешенных в европейских странах.
Самыми опасными пищевыми добавками являются: глутаминовая кислота (E620) и ее соли (глутамат натрия Е621, глутамат калия Е622, диглутамат кальция Е623, глутамат аммония Е624, глутамат магния Е625), бензойная кислота (Е210 – Е219).
Глутаминовую кислоту добавляют для усиления вкусовых ощущений и, несмотря на то, что эта кислота является естественной для нашего организма аминокислотой, использовать ее нужно ограниченно. При высоких концентрациях глутамата может возникать чувство жара, покраснение лица, тошнота, рвота, колебания артериального давления, повышение температуры тела, бессонница, учащенное сердцебиение. Такое состояние может быть опасно для больных сердечно-сосудистыми заболеваниями.
Бензойную кислоту добавляют в рыбные консервы и газированные напитки. Эта добавка может вызывать аллергические реакции: крапивницу, астму и даже анафилактический шок. Поэтому продукты с бензойной кислотой лучше не употреблять больным бронхиальной астмой и при склонности к аллергии.
Однако существуют пищевые добавки, благодаря которым продукты не только не теряют в своем качестве, но и, из-за особых свойств этих добавок, становятся полезными. Большинство из этих добавок допустимы в продуктах детского питания.
06.12.2018
С целью не допущения в оборот недоброкачественной пищевой продукции и профилактики нарушений требований санитарно-эпидемиологического законодательства специалистами Ошмянского районного центра гигиены и эпидемиологии проводятся надзорные мероприятия за торговыми объектами, объектами общественного питания и придорожного сервиса.
04.12.2018
За истекший период 2018 года надзорными мероприятиями охвачено 138 объектов, нарушения требований санитарных норм и правил устанавливались в 97% случаев.
Так, основными нарушениями являлись: реализация пищевой продукции с истекшим сроком годности (43% от всех выявленных), реализация пищевой продукции без наличия маркировки (25,2 % от всех выявленных), реализация и хранение пищевой продукции в отсутствие необходимых температурных условий (21,5 % от всех выявленных), без документов, подтверждающих качество и безопасность (11,1 % от всех выявленных), неудовлетворительное санитарное состояние помещений, торгового, технологического, холодильного оборудования (7,1 % от всех выявленных).
В адрес руководителей субъектов хозяйствования направлено 119 рекомендаций об устранении нарушений, вынесено 30 предписаний по причине реализации продуктов питания в отсутствии необходимых температурных условий, из них 10 - в связи с неудовлетворительным содержанием торгового и холодильного оборудования, 6 о приостановлении (запрете) производства и (или) реализации работ, услуг. При выявлении недоброкачественной пищевой продукции вынесено 108 предписаний о приостановлении (запрещении) реализации товаров общим весом 338,14 кг.
По фактам выявленных нарушений за истекший период к административной ответственности привлечено 16 виновных и 9 юридических лиц, дисциплинарной – 14, на внеочередное обучение направлено 14 человек.
В целях защиты себя и своих близких от недоброкачественной продукции обращайте внимание на внешний вид, сроки годности и условия реализации пищевой продукции!
Требования к помещениям торговых объектов изложены в Общих санитарно-эпидемиологических требованиях к содержанию и эксплуатации капитальных строений (зданий, сооружений), изолированных помещений и иных объектов, принадлежащих субъектам хозяйствования, утвержденных Декретом Президента Республики Беларусь от 23.11.2017 №7 (далее – ОСЭТ).
29.11.2018
В соответствии с требованиями ОСЭТ помещения объекта, производственная мощность производственная мощность, планировочные решения должны соответствовать:
- формам и методам обслуживания;
- организации производственного процесса: приготовлению, отпуску продукции;
- исходным продуктам, используемым в работе.
В торговых помещениях объектов необходимо выделить отдельные торговые зоны (отделы, места) для реализации сырья и готовой пищевой продукции, непродовольственных товаров, кормов для животных.
Помещения объекта, предназначенные для хранения пищевой продукции и непродовольственных товаров, должны быть раздельными.
Размещение помещений торгового объекта, предназначенных для хранения и подготовки пищевой продукции к реализации, в том числе охлаждаемых камер, под душевыми, туалетами и моечными запрещается.
При хранении и реализации пищевой продукции должны соблюдаться условия ее хранения (реализации) и срок годности, установленные изготовителем.
Хранение и реализация пищевой продукции должны осуществляться в условиях, обеспечивающих предотвращение ее порчи и защиту от загрязняющих веществ. Не допускается совместное хранение доброкачественной продукции с продукцией испорченной, с истекшим сроком годности, изъятой из обращения. Продукция, имеющая специфический запах, должна храниться отдельно от пищевой продукции, воспринимающей посторонние запахи. Хранение пищевой продукции непосредственно на полу запрещается.
На торговых объектах, на которых осуществляется фасовка пищевой продукции, необходимо предусматривать специально оборудованные и оснащенные фасовочные помещения или зоны для различных групп пищевой продукции (готовых к употреблению и сырых).
Реализация сырой пищевой продукции и полуфабрикатов из нее должна производиться отдельно от реализации готовой к употреблению пищевой продукции.
Реализация биологически активных добавок к пище осуществляется в торговых объектах в специально отведенных местах, оборудованных стеллажами (шкафами) с учетом условий их хранения.
В ОСЭТ также изложены требования к системам водоснабжения, водоотведения, вентиляции, освещения и отопления.
29.11.2018
В современном, ускоренном ритме жизни мы все меньше времени тратим на полноценное питание. И особенно это касается правильного завтрака. Пища, перехваченная на скорую руку утром, в основном, составляет наш рацион на весь рабочий день. Между тем принцип «Завтракать надо, как король, обедать, — как принц, а ужинать, — как нищий» никто не отменял.
Очень важно именно утром зарядить свой организм необходимым количеством полезных веществ, потому что утро — самая главная часть дня для подпитки организма, ведь впереди целый день активности, за который можно израсходовать большую часть калорий. Кроме того, если за завтраком вы не получите положенное число калорий и питательных веществ, считайте, что полдня ваш организм продолжит «спать». Поэтому именно утром рекомендовано употребить не менее трети своей нормы калорий. Правильный завтрак — это отличный способ улучшить работу мозга в течение дня.
Сбалансированный, полезный, правильный завтрак запустит ваш организм на дальнейшую работу в течение целого дня, разгонит метаболизм, придаст энергии, а также поможет:
- быстрее похудеть тем, кто следит за весом. Исследования показали, что те, кто не пропускает правильный завтрак, имеют больший успех в похудении и поддержании веса в сравнении с теми, кто не завтракает;
- прояснить ум. Те, кто на завтрак употребляет большое количество клетчатки, в течение дня дольше остаются внимательными, в сравнении с теми, кто начинает свой день с чрезмерно жирной пищи;
- защитить сердечно-сосудистую систему. Ученые доказали: те, кто предпочитает цельнозерновые, а не каши из обработанного зерна, имеют меньший риск развития сердечных заболеваний;
- укрепить иммунную систему. Правильный завтрак поможет начать день с укрепляющих иммунитет витаминов и минералов.
Каким же должен быть завтрак? Он должен сочетать в себе углеводы и белки и, конечно, содержать витамины. Свой выбор ты можешь остановить на различные фритаттах, кашах, граноле, смузи, свежем соке, натуральном йогурте, твороге, овощном салате с мясом или рыбой, брускетте, нежирных сортах сыра, яйцах и еще много чем. Первый прием пищи должен быть сытным, но это не значит, что ты должна встать из-за стола так, словно тебя покормила бабушка, не пожалев для тебя месячного запаса продуктов. Слишком сытный завтрак не взбодрит тебя. Наоборот, вызовет сонливость и понизит работоспособность.
Медленные и сложные углеводы в каше или тостах надолго обеспечат тебя энергией, горсть орехов заставит мозг качественно работать, благодаря сладости фруктов поднимешь настроение, а яйца или творог принесут тебе душевное равновесие.
Подойди к завтраку творчески. Как утро встретишь, так день и проведешь. Если ты в спешке запихиваешь в себя бутерброд, делаешь два глотка кофе и бежишь, то и день пройдет в суматохе. А вот спокойный вкусный завтрак даст заряд позитивных эмоций и повысит твою производительность. Красивая сервировка, качественные продукты — у самых успешных людей этого мира завтрак считается ритуалом.
Начинай день правильно!
22.11.2018
Здоровое питание – это хорошее самочувствие, энергичность, молодость организма и сияющий внешний вид. Зная основные правила питания, каждый человек может самостоятельно составить сбалансированный рацион, подобрать правильные продукты питания, разработать здоровое меню для своей семьи.
Пища - это одна из главных потребностей человека. Качественные продукты питания являются основой удовлетворения физиологических потребностей людей.
Правильное питание не приводит к излишнему набору веса, дает организму необходимые компоненты, в том числе витамины, макро и микроэлементы. Здоровое питание должно рассматриваться только в связи со здоровым образом жизни, наличием физической активности, отказом от курения и злоупотребления алкоголем.
Несколько основных правил здорового питания:
Суточный рацион должен содержать достаточное количество белков, жиров, углеводов, витаминов, минеральных веществ. Количество белка в рационе должно соответствовать физиологической норме – 1-1,5 г на 1кг веса. Животный белок должен составлять не менее 60% от суточного количества белка (обязательно присутствие в рационе постного мяса, рыбы, яиц, молока и кисломолочных продуктов).
Оптимальное количество жиров – 0,8-1,0 г на 1 кг веса в сутки. В рационе от общего количества жиров должно быть 30-35% растительных масел для приготовления пищи и добавления в салаты.
Желательно ограничить количество углеводов до 3-3,5 г на 1 кг веса в сутки, прежде всего за счет простых: сахар, сладости.
Количество приемов пищи в течение дня не менее 4-5 раз (3 основных приема пищи и 2 дополнительные, представленные свежими фруктами и овощами, лучше в сыром виде). Основная калорийность рациона должна приходиться на первую половину дня.
Интервалы между приемами пищи не должны превышать 3,5-4 часа.
Количество свободной жидкости не менее 1,5л в сутки (при отсутствии противопоказаний). Для питья можно использовать минеральную негазированную воду с наименьшей степенью минерализации, свежеотжатые соки, чай, кофе.
Интервал между последним приемом жидкости и едой должен быть 20-30 минут, между едой и последующим приемом жидкости не менее 30 минут. Последний прием жидкости – за 1-1,5 часа до сна.
Последний прием пищи - за 2,5-3 часа до сна.
Есть не спеша, тщательно пережевывая пищу, вставать из-за стола, как только почувствуете чувство насыщения.
Предпочтительно ограничить потребление соли до 5-7 г в сутки.
Питание должно быть максимально разнообразным. Особенно полезны овощи, содержащие пектин и клетчатку. Они создают чувство насыщения, регулируют функцию кишечника, выводят шлаки (капуста, кабачок, редис, томаты, огурцы, тыква, листовая зелень). Овощи можно употреблять сырыми, тушеными, вареными, приготовленными на пару и на гриле. Свежие овощи предпочтительнее употреблять с растительным маслом (подсолнечное, оливковое, льняное).
Мясо, птицу, рыбу можно запекать, готовить на пару, гриле. Употреблять данные продукты лучше с растительным гарниром. Кожицу птицы и рыбы желательно в пищу не употреблять.
Хлеб обязательно должен присутствовать в рационе, лучше всего зерновой, с отрубями.
Соблюдение этих простых рекомендаций в скором времени обернется повышенным уровнем физической активности, более качественным ночным сном и улучшением качества жизни в целом.
19.11.2018
Питание является одним из наиболее активных и важных факторов внешней среды, которое оказывает разнообразное влияние на организм человека, обеспечивает его рост, развитие, сохранение здоровья, трудоспособности и оптимальной продолжительности жизни. Все это обеспечивается ежедневным, регулируемым приемом пищи с определенным набором пищевых продуктов. Рассмотрим такой образ питания как вегетарианство. Так что же представляет собой данный образ питания? Какую пользу или вред может принести человеку? Вегетарианство – питание растительной и молочной пищей с отказом от мясной пищи животного происхождения (включая мясо птицы, рыбу и морепродукты). Существуют различные варианты вегетарианства, которые могут включать в рацион яйца или исключать молочные продукты. Это может быть полный отказ от потребления продуктов животного происхождения (рыбы, птицы, морепродуктов), лактовегетарианство (основу которого составляют молочные продукты), ово-вегетарианство (допускается употребление животного белка, в частности, яичного), фрукторианство (потребление фруктов в большем количестве, чем овощей), сыроедение и другие. Существует множество сторонников и противников вегетарианства, которые на протяжении многих лет спорят о плюсах и минусах такого питания. Главным плюсом вегетарианства является то, что растительная пища (овощи, фрукты, бобовые, зерновые) – кладезь витаминов, минеральных веществ и клетчатки. Витамины и минеральные вещества являются незаменимыми компонентами для нормальной жизнедеятельность организма, а клетчатка обеспечивает комфортное пищеварение и здоровье желудочно-кишечного тракта в целом. Вместе с тем существует ряд отрицательных моментов, например: - Рацион вегетарианца является несбалансированным по основным питательным веществам (преобладание углеводистой пищи, «неполноценный» белок и отсутствие жиров животного происхождения) - Белки являются главным «строительным» материалом организма. Клетки и ткани, гормоны и ферменты – всё это заслуга белков. Они состоят из аминокислот, которые делятся на заменимые и незаменимые. Именно белки животного происхождения обладают всем набором необходимых организму аминокислот. - Дефицит ряда витаминов и микроэлементов – всё это может стать причиной развития тяжёлых заболеваний нервной системы, костно-мышечной и др. Например, опасность развития железодефицитной анемии, так как железо, содержащееся в растительной пище, плохо усваивается. Принимая для себя решение стать вегетарианцем, следует помнить о возможных негативных последствиях такого питания. Важно помнить о том, что питание должно быть рациональным, разнообразным и сбалансированным, которое обеспечит нормальную жизнедеятельность человека, способствует улучшению его здоровья и предупреждает заболевания. Только в этом случае оно принесёт пользу организму, а не навредит ему. 19.11.2018
Пожалуй, самая большая опасность, которая подстерегает любителей домашних заготовок — риск заразиться ботулизмом. В прошлом году на Гродненщине было зафиксировано 7 случаев заболевания ботулизмом. Пострадало 8 человек, двое из них дети. В Ошмянском районе в 2017 году зафиксирован 1 случай ботулизма, за 9 месяцев текущего года – случаев ботулизма не регистрировалось.
Ботулизмом называется отравление, наступающее при употреблении пищи, содержащей токсин бактерий клостридиум ботулинум (Clostridium botulinum). Возбудители ботулизма широко распространены в почве и воде открытых водоёмов, что неизбежно ведёт к попаданию их на овощи и фрукты, в кишечник домашних животных, к заражению рыбы.
Попадая в пищевые продукты, бациллы размножаются и выделяют токсин, который является самым сильным из известных микробных ядов. Причём идеальной средой для появления токсина являются герметично закрытые банки: яд выделяется лишь в анаэробных условиях, то есть без доступа воздуха. Соль и кислоты препятствуют выделению токсина, однако наличие уксуса и соли в заготовках не может на 100% гарантировать их безопасность для здоровья человека. Зачастую токсин в банке никак себя не проявляет — внешний вид продукта не изменён, запах и вкус обычные, приятные, крышка, как правило, не вздута.
Первые симптомы ботулизма — тошнота, рвота, боль в животе, жидкий стул. Затем развивается чувство распирания в желудке, запоры. Позже появляются расстройство зрения, сухость во рту и мышечная слабость. Голова свисает, и больные вынуждены поддерживать её руками. Дыхание становится поверхностным, едва заметным.
В целях профилактики ботулизма не рекомендуется в домашних условиях консервировать грибы, мясо, рыбу, зелень, вялить или коптить мясную и рыбную продукцию.
Если Вы все же решили законсервировать какие-либо продукты необходимо соблюдать элементарные правила: перед тем, как приступить к консервированию чего-либо, необходимо тщательно промыть продукты, банки, в которых вы намерены консервировать, столовые приборы, которые будете использовать; банки после мытья обязательно следует стерилизовать, а крышки, будь то полиэтиленовые или металлические, кипятить. То есть необходимо применить все меры, направленные на исключение загрязнения консервации.
Если среди законсервированных банок Вы заметили бомбажные (вздутые), немедленно выбросьте их содержимое.
Если же Вы сами не занимаетесь консервацией, но любите полакомиться такой продукцией, не рискуйте и не покупайте подобные продукты у незнакомых людей с рук. Всегда отдавайте предпочтение консервированной продукции промышленного производства.
В завершение следует отметить, что если после употребления каких-либо консервов Вы заметили ухудшение своего самочувствия, необходимо немедленно обратиться за медицинской помощью. Промедление при этом заболевании крайне опасно. Единственное специальное лекарственное средство от ботулизма - антитоксическая сыворотка, вводимая больному только в стационарном медицинском учреждении. Это единственный препарат, который может спасти. Будьте внимательны к своему самочувствию и здоровью своих близких!!!
19.10.2018
Специалистами государственного учреждения «Ошмянский районный центр гигиены и эпидемиологии» проводятся надзорные мероприятия торговых объектов за соблюдением требований санитарных правил при хранении и реализации пищевой продукции.
В ходе надзорных мероприятий имеют место случаи реализации пищевой продукции, не соответствующей требованиям законодательства Республики Беларусь по маркировке (полная и достоверная информации о товаре), таковых за истекший период 2018 года зарегистрировано 30 случаев, общим весом забраковки 116,288 кг. Зачастую она нечитаемая, стерта, замазана, заклеена ценником на месте указания срока годности.
В связи с этим хотим дать несколько советов покупателям.
СОВЕТ 1: не покупайте такую продукцию; укажите продавцу на наличие такой продукции; отсутствие маркировки на товаре может привести к покупке товара с истекшим сроком годности. Указание на маркировке продукта срока годности (хранения) является обязательным как для предприятий, изготавливающих пищевые продукты, так и для фасовщиков пищевых продуктов. Если какой-либо продукт расфасовывается в торговом объекте (при наличии специальных условий), будь то печенье или крупа, на фасованном продукте должно быть указано: наименование пищевой продукции, указанное на маркировке изготовителя и в товаросопроводительных документах; дата изготовления, срок годности, условия хранения, установленные изготовителем. Информация для потребителя указывается на русском языке или русском и белорусском языках, должна быть однозначно понимаемой, полной и достоверной, чтобы потребитель не мог быть обманут или введен в заблуждение.
СОВЕТ 2: Всегда проверяйте наличие на маркировке продукта, который хотите приобрести, температурных режимов хранения. Несоблюдение температурных режимов при хранении и реализации пищевых продуктов специалисты государственного санитарного надзора выявляют в любую пору года. Скоропортящиеся продукты, такие как молочные продукты, вареные колбасы, кондитерские изделия с кремом, а также охлажденные мясные продукты должны находиться на весь период реализации только в холодильном оборудовании при температуре, указанной на маркировке, чаще всего не выше плюс 6 градусов.
Нередки случаи, когда замороженные продукты выложены для продажи в холодильные витрины, где температура не понижается ниже 0 градусов.
СОВЕТ 3: не покупайте продукцию, имеющую вид повторно замороженной, она небезопасна;
СОВЕТ 4: обращайте внимание на соблюдение правил товарного соседства продуктов при их хранении и реализации, ведь знает каждая хозяйка: рядом с сырой птицей неупакованный хлеб ложить не стоит.
СОВЕТ 5: обращайте внимание на отпуск Вам пищевых продуктов. Имеют место случаи, когда продавец одними руками отпускает неупакованные пищевые продукты и принимает деньги за товар. Это опасно, так как происходит загрязнение неупакованных пищевых продуктов.
Следование этим простым правилам позволит покупателю приобрести качественный товар и не быть обманутым недобросовестным продавцом.
18.10.2018
В осенний сезон возрастает заболеваемость острыми кишечными инфекциями, что связано с обилием овощей и фруктов, нарушением водного режима.
При всех инфекционных кишечных заболеваниях бактерии или вирусы проникают в организм человека через рот (оральный механизм заражения). Факторами передачи заразного начала могут быть самые разнообразные предметы внешней среды, загрязненные испражнениями больных: различные предметы обихода, дверные ручки, игрушки, книги, газеты, а также вода и пищевые продукты. В зависимости от того, какие факторы приобретают решающее значение в передаче возбудителя, различают следующие пути распространения инфекции: контактно-бытовой (предметы обиходы), пищевой (продукты питания) и водный. Восприимчивость людей к кишечным инфекциям довольно высокая. Особенно им подвержены дети, что объясняется более слабыми защитными приспособлениями детского организма.
При кишечных инфекциях отмечается преимущественное поражение желудочно-кишечного тракта больного. Нередко нарушению деятельности желудка и кишечника предшествуют симптомы общей интоксикации: небольшой озноб, повышение температуры, головная боль, слабость, ломота в суставах, отсутствие аппетита, нередко рвота. Эти явления больные обычно принимают за симптомы простуды и часто не обращаются за медицинской помощью. Больные с нераспознанными инфекциями являются источником заражения в семье и на производстве. Особенно они опасны для детских учреждений, предприятий пищевой промышленности, общественного питания. Поражение желудочно-кишечного тракта проявляется следующими симптомами: боли в животе, тошнота, рвота, изменение характера испражнений. Боли в животе сначала могут быть неопределенной локализации, затем они сосредотачиваются в подложечной области, вокруг пупка или в нижних отделах живота, чаще слева. Характер болей обычно схваткообразный. Стул в начале заболевания может быть не измененным, позже жидким. Нередко в испражнениях появляются слизь и прожилки крови.
Лечение острых кишечных инфекций должно проводиться под наблюдением врача. Самолечение недопустимо, т.к. требует индивидуального подхода к каждому больному, а у детей младшего возраста неадекватное и неправильное лечение угрожает жизни ребенка.
С выздоровлением организм больного обычно освобождается от возбудителя, однако часть переболевших длительно является бактерионосителями, чем представляют опасность для окружающих.
В целях профилактики кишечных инфекционных заболеваний нужно выполнять следующие правила: после посещения туалета, перед приготовлением и употреблением пищи в обязательном порядке необходимо тщательно вымыть руки с мылом; перед употреблением в пищу фруктов, ягод необходимо тщательно обмыть их водой и после этого ошпарить кипятком; необходимо строго соблюдать сроки хранения и реализации пищевых продуктов; не употреблять в пищу продукты сомнительного качества; очень важно содержать в чистоте и порядке территории дворов и улиц, надворные уборные, выгребные ямы, шахтные колодцы. Не употреблять для удобрения огорода, где выращиваются овощи и ягоды, содержимое надворных уборных.
Кишечные инфекции можно победить! Будьте бдительны и не забывайте, что Ваша жизнь в Ваших руках!
17.10.2018
Постановлением заместителя Министра – Главного государственного санитарного врача Республики Беларусь от 17.09.2018 № 76 утвержден перечень требований контрольного списка вопросов (чек-листа), предъявляемых к субъектам, осуществляющим обращение пищевой продукции.
Данный чек-лист содержит перечень санитарно-эпидемиологических, гигиенических требований и процедур, необходимых для выполнения субъектом хозяйствования, установленных в Общих санитарно-эпидемиологических требованиях к содержанию и эксплуатации капитальных строений (зданий, сооружений), изолированных помещений и иных объектов, принадлежащих субъектам хозяйствования, утвержденных Декретом Президента Республики Беларусь от 23.11.2017 № 7 «О развитии предпринимательства».

- Пища должна быть разнообразной, а вовсе не суперкалорийной, и предпочтение стоит отдавать прежде всего продуктам растительного происхождения (а в жаркую летнюю погоду вообще стоит отдавать предпочтение вегетарианскому типу питания, ибо белок увеличивает обмен веществ на 40 процентов, а это сильно разогревает организм, который в жару и без этого нуждается в охлаждении. Если уж организм очень нуждается в белке, можно включить в рацион яйца
- Сложные углеводы крайне полезны и необходимы, поэтому ежедневно следует употреблять в пищу цельнозерновой хлеб, каши из цельных круп, бобовые
- Ежедневный рацион непременно должен включать в себя 400 и более граммов свежих, или термически обработанных, соответствующих сезону и желательно местного происхождения фруктов
- Индекс массы тела необходимо поддерживать в пределах ИМТ*18,5 — 25 (индекс массы тела — это показатель соответствия массы человека и его роста, позволяющий оценить нормальна ли масса тела). Поддерживать ИМТ на должном уровне поможет ежедневные физические упражнения и нагрузка.
- Жизненно важен и необходим контроль, употребляемых в пищу жиров. Для здорового питания показаны ненасыщенные жиры, которые должны составлять менее 30% от дневного рациона, употребляемого в пищу
- Эксперты ВОЗ рекомендуют значительно уменьшить употребление мясных продуктов с высоким процентным содержанием жира, заменив их нежирным мясом, рыбой, бобовыми
- Если вы предпочитаете молочные продукты, то следует выбирать молоко, кефир, йогурт, сыр с низким содержанием жиров
- Необходимо значительно уменьшить потребление сахара, поэтому продукты с низким его содержанием более предпочтительны и безопасны для вашего здоровья. Особенно рекомендуется ограничить употребление сладостей и сладких газированных напитков
- Количество соли, употребляемой вами в течение дня, не должно превышать 5 граммов, что примерно составляет одну чайную ложку
- Алкоголь — неполезный для здоровья человека продукт. Поэтому в идеале его не употреблять вообще, ну или, по возможности, значительно уменьшить его количество. 11. Для того чтобы уменьшить содержание жиров в пище, эксперты советуют готовить ее безопасно, то есть пищу следует запекать, проваривать и готовить на пару, а не жарить.
- И еще, грудное вскармливание детей до 6 месяцев, а в возрасте от 6 месяцев до 2 лет — грудное вскармливание в сочетании с правильным дополнительным питанием, обезопасит вашего ребенка от ожирения и развития неинфекционных заболеваний у него в будущем (детское ожирение считается одной из самых серьезных проблем в сфере здравоохранения в XXI веке).
Ежегодно в летне-осенний период в районе регистрируются отравления грибами, в том числе с летальным исходом. Связано это с употреблением в пищу несъедобных, ядовитых и неправильно приготовленных условно-съедобных грибов.
Токсическим началом отравления несъедобными грибами являются сильнодействующие яды, которые не разрушаются при кулинарной обработке. Заболевание, как правило, начинается внезапно, через 3-12 часов после употребления грибов. Клиническая картина: на начальных стадиях заболевания отмечается резкая боль в животе, неукротимая рвота, понос, слабость, головная боль. В дальнейшем могут присоединяться судороги, галлюцинации, бред. Смертельный исход при отравлениях несъедобными грибами достигает 25-50% случаев.
Следует отметить, что отравление может наступать не только от употребления ядовитых по своей природе грибов, но и от так называемых условно-съедобных.
Как их готовить?
Даже соблюдая меры предосторожности при сборе грибов, грибники зачастую совершают непоправимые ошибки при их приготовлении. Чаще всего речь идет о неправильной готовке, так называемых условно съедобных грибов, растущих на нашей территории.
Среди разнообразия условно съедобной грибной флоры у белорусских грибников очень популярны сморчки, строчки, свинушки, чернушки, волнушки и некоторые виды сыроежек. Они содержат гиромитрин, гелвеловую кислоту и другие яды, которые при неправильном приготовлении грибов вызывают отравления, часто со смертельным исходов. Но коль Вы решились на их приготовление, нелишним будет соблюсти некоторые правила. В первую очередь, после сбора необходимо отсортировать эти грибы, от съедобных. (Кстати, старые грибы, даже съедобные, при сортировке рекомендуют выбрасывать, так как в них также полно ядовитых веществ).
Перед приготовлением обязательно очистите их, тщательно промойте и нарежьте на кусочки, затем прокипятите в воде не менее двух раз по 15 минут. После каждого раза обязательно сливать отвар, не пробуя, так как именно в него уходят ядовитые вещества. После окончания варки, такие грибы необходимо тщательно промыть и отжать и уже после этого можно использовать для приготовления блюд.
Неправильно заготовленные или испорченые сушеные и консервированные грибы также становятся причиной серьезных отравлений. Неправильная консервация – самая распространенная из них. Так широко известный ботулизм – это в 95% неправильная консервация и, прежде всего, отсутствие надлежащей термической обработки грибов. Ядовитое вещество ботулотоксин вызывает «отключение» мышц во всем организме больного и может привести к смертельному исходу из-за паралича дыхательной мускулатуры.
Мариновать рекомендуется съедобные грибы без едкого вкуса мякоти – трубчатые (боровики, подберезовики, маслята и т.д.), и пластинчатые (шампиньоны, толстушки, лисички, опята, зеленки). В засол допускаются все съедобные грибы. Пластинчатые грибы – только после предварительной обработки, замачивания и двухкратного отваривания не менее 20 минут. Нельзя покупать консервированные грибы в герметически укупоренных банках.
Что делать при отравлении?
Необходимо незамедлительно обратиться за медицинской помощью. Первая помощь при отравлении грибами нередко играет решающую роль в спасении больного. Надо немедленно начать промывание желудка водой, лучше с помощью зонда слабым раствором (розового цвета) перманганата калия или методом искусственной рвоты. Полезно в раствор добавлять активированный уголь (карболен). Затем дают слабительное (касторовое масло и солевое), несколько раз ставят очистительные клизмы. После этого больного тепло укрывают и обкладывают грелками, дают пить горячий сладкий чай, кофе.
Человеку, отравившемуся грибами, ни в коем случае нельзя употреблять спиртные напитки, так как алкоголь содействует быстрому всасыванию в организм грибных ядов. Остатки грибов, которые привели к отравлению, необходимо передать врачу для исследования – это облегчит последующее лечение.
- В связи с этим хочется предупредить и напомнить:
- Идя в лес, необходимо знать видовой состав грибов и собирать заведомо съедобные грибы, не вызывающие сомнения.
- Грибы – продукт скоропортящийся, поэтому их нужно перебирать и сортировать сразу.
- Сортировкой и приготовлением грибов должны заниматься только взрослые.
- Не рекомендуется покупать грибы все рынков, и не рассортированные по видовому составу.
- Перебирая грибы необходимо выбрасывать старые, так как при старении гриба в их тканях происходят сложные химические процессы с образованием ядовитых веществ. В старых грибах, даже таких как белые, подосиновики, подберезовики, в процессе старения образуются высокотоксичные соединения.
- Грибы обладают способностью поглощать из окружающей среды и накапливать токсичные вещества в концентрациях, несколько раз превышающих содержание в почве, воде, растениях. Поэтому все грибы необходимо отваривать, а отвар обязательно сливать.
- Пластинчатые грибы необходимо покупать только с ножками. Именно ножка является основным отличительным признаком съедобных пластинчатых от самого ядовитого пластинчатого гриба - бледной поганки. У нее возле шляпки имеется клубневидное утолщение ножки и «воротничок». Родители должны помнить, что грибы должны быть исключены из рациона детей до 3-х лет.
Будьте бдительны и не забывайте, что Ваша жизнь в Ваших руках!
10.08.2018
С целью не допущения в оборот недоброкачественной пищевой продукции и профилактики нарушений требований санитарно-эпидемиологического законодательства специалистами Ошмянского районного центра гигиены и эпидемиологии проводятся надзорные мероприятия за торговыми объектами, объектами общественного питания и придорожного сервиса.
За истекший период 2018 года надзорными мероприятиями охвачено 127 объектов, нарушения требований санитарных норм и правил устанавливались в 87% случаев.
Так, основными нарушениями являлись: реализация пищевой продукции с истекшим сроком годности (43% от всех выявленных), реализация и хранение пищевой продукции в отсутствие необходимых температурных условий (29,2% от всех выявленных), реализация пищевой продукции без наличия маркировки (29,2 % от всех выявленных), неудовлетворительное санитарное состояние помещений, торгового, технологического, холодильного оборудования (7,4 % от всех выявленных), без документов, подтверждающих качество и безопасность (7,3% от всех выявленных).
В адрес руководителей субъектов хозяйствования направлено 79 рекомендаций об устранении нарушений; вынесено 26 предписаний о приостановлении (запрете) производства и (или) реализации работ, услуг, из них 24 – по причине реализации продуктов питания в отсутствии необходимых температурных условий, 2 - в связи с неудовлетворительным содержанием торгового и холодильного оборудования. При выявлении недоброкачественной пищевой продукции вынесено 67 предписаний о приостановлении (запрещении) реализации товаров общим весом 205,29 кг.
По фактам выявленных нарушений за истекший период к административной ответственности привлечено 6 виновных и 4 юридических лиц, дисциплинарной – 7, на внеочередное обучение направлено 12 человек.
В целях защиты себя и своих близких от недоброкачественной продукции обращайте внимание на внешний вид, сроки годности и условия реализации пищевой продукции!
03.08.2018
В связи с высокими требованиями к качеству питьевого молока, как на территории Республики Беларусь, так и на пространствах Евразийского экономического союза на высоком уровне остается контроль за предприятиями, осуществляющими производства сырого молока, т.е. за молочно-товарными фермами и молочно-товарными комплексами. По состоянию на 01.06.2018 на территории Ошмянского района расположено 26 ферм и комплексов, из них 9 работает по новым технологиям.
Специалистами Ошмянского районного ЦГЭ в целях оценки фактического состояния молочно-товарных ферм и молочно-товарных комплексов на предмет соответствия требованиям законодательства в области обеспечения санитарно-эпидемиологического благополучия населения проведен мониторинг 12 молочно-товарных ферм (комплексов), что составляет 46,2%. Типовыми нарушениями требований Общих санитарно-эпидемиологических требований к содержанию и эксплуатации капитальных строений (зданий, сооружений), изолированных помещений и иных объектов, принадлежащих субъектам хозяйствования, утвержденных Декретом Президента Республики Беларусь от 23.11.2017 №7, Санитарных норм и правил «Санитарно-эпидемиологические требования для организаций, осуществляющих производство молока», утвержденных Постановлением Министерства здравоохранения Республики Беларусь от 31.07.2012 №119 являлись: своевременность проведения ремонтов, наличие в достаточном количестве промаркированного уборочного инвентаря, оборудование умывальных раковин жидким мылом и антисептиком для обработки рук.
Совместная работа специалистов Ошмянского районного ЦГЭ, управления сельского хозяйства Ошмянского районного исполнительного комитета и Ошмянской районной ветеринарной станции по контролю за санитарным состоянием молочных блоков и качеством вырабатываемого молока на молочно-товарных фермах и молочно-товарных комплексах Ошмянского района будет продолжена.
20.06.2018
Знаменитый древнегреческий врач, «отец медицины», Гиппократ, сказал: Я есть то, что я ем. Эта фраза особо актуальна для человека 21 века, так как современный ритм жизни отнимает, порой, у нас много времени и сил, поэтому мы часто отказываемся от приготовления полноценной еды и выбираем полуфабрикаты и «фаст-фуд».
Актуальность проблемы питания связана с тем, что многие нарушения питания оказывают неблагоприятное воздействие на организм человека, увеличивая риск развития основных социально-значимых заболеваний. С неправильным питанием связывают не менее 50% случаев сердечно-сосудистых заболеваний, около 40% случаев рака легких, ободочной и прямой кишки, почек, предстательной железы, мочевого пузыря у мужчин и около 60% случая рака молочной железы, матки, почек, кишечника у женщин. Кроме того, результатом неправильного питания является ожирение и высокий риск развития на этом фоне сахарного диабета 2 типа. По данным статистики, он встречается у 35%-50% лиц с повышенной массой тела.
Поэтому очень важно питаться правильно и полноценно, так как правильное питание является залогом здоровья, красоты, хорошего самочувствия и долголетия. Именно здоровое питание (а не какие-то волшебные косметические кремы и маски) определяет состояние наших кожи, волос и ногтей, нашу фигуру, общее самочувствие и жизненный тонус. Поэтому, чтобы наше здоровье и физическое состояние оставалось в норме или пришло в норму, необходимо придерживаться следующих правил.
Правила здорового питания:
- Рацион питания должен быть максимально разнообразным и состоять из всех групп продуктов. Это дает организму все необходимые для жизни вещества, в которых он нуждается.
- Сбалансированность питания: рацион должен быть сбалансирован по набору жизненно важных элементов – белков, углеводов, жиров, витаминов, минеральных веществ и микроэлементов
- Энергетическое равновесие: в день организм должен потреблять столько энергии, сколько расходует.
- Соблюдение режима питания: регулярность (в одно и то же время), дробность (от 3 до 5 раз в день) и равномерность приемов пищи. Этот поможет нормализовать работу ЖКТ и обмен веществ. Причем основная калорийность рациона должна приходиться на первую половину дня. Не стоит есть за 1,5−2 часа перед сном, так как во сне организм должен отдыхать, а не заниматься перевариванием ужина.
- Свести к минимуму или вовсе отказаться от употребления соли и сахара. Если без соли вы не «воспринимаете» пищу, то замените ее йодированной. В отличие от обычной, она сохраняет в своем составе множество минеральных веществ. Ограничьте себя в употреблении сахара, заменяя его медом, содержащим витамины и минералы, которые предотвращают простуду и повышают иммунитет.
- Количество свободной жидкости не менее 1,5-2 литров в день. Чистая вода выводит токсины и вредные вещества из организма, благотворно влияет на состояние кожи – увлажняет и наполняет её энергией, предотвращает шелушение и сухость. Чтобы избежать отеков, старайтесь не пить большие объемы воды на ночь.
- Не перекусывайте «на лету». Тщательно и не спеша пережевывайте пищу, наслаждаясь ее вкусом. Ешьте медленно и с удовольствием – это главное для правильного питания, так как торопливый едок обычно ест слишком много, и, соответственно, набирает лишний вес.
- Следите за тем, чтобы в пищу использовались только свежие и качественные продукты, а еда была свежеприготовленной. Огромная кастрюля супа на неделю — это плохая экономия времени, которая, кстати, и здоровью принесёт только вред.
Соблюдаете эти несложные правила здорового питания и будьте здоровы!
Технический регламент Евразийского экономического союза "О безопасности рыбы и рыбной продукции" (ТР ЕАЭС 040/2016) (вступил в силу с 1 сентября 2017 года, за исключением пункта 15 технического регламента). Технический регламент ![]()